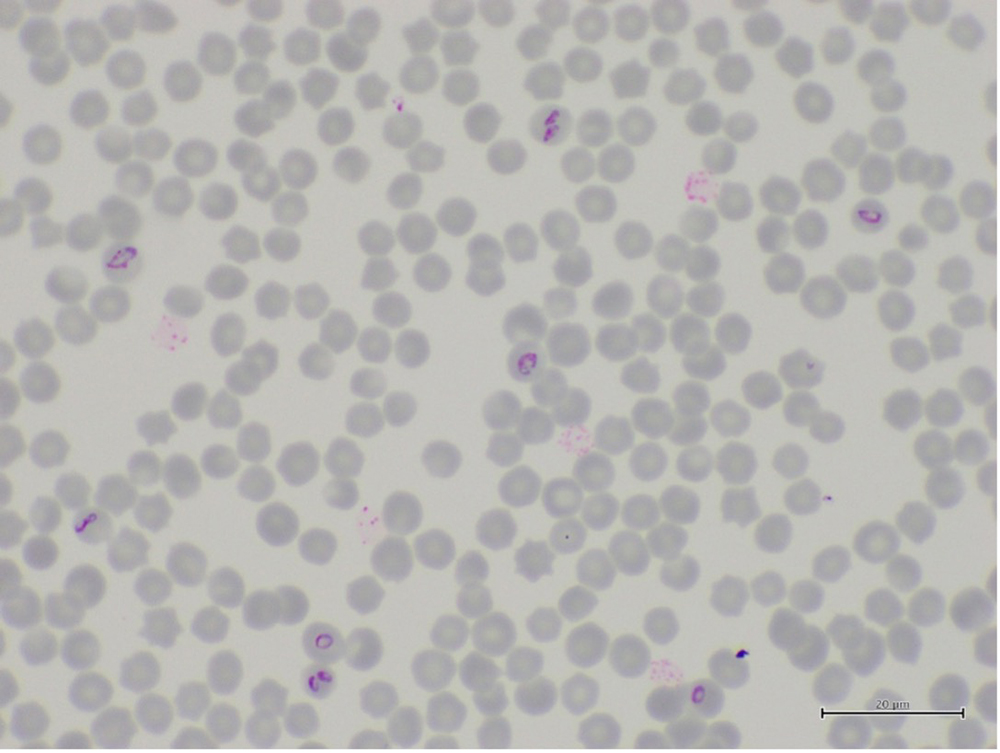
Microscopic images of Babesia caballi within erythrocytes
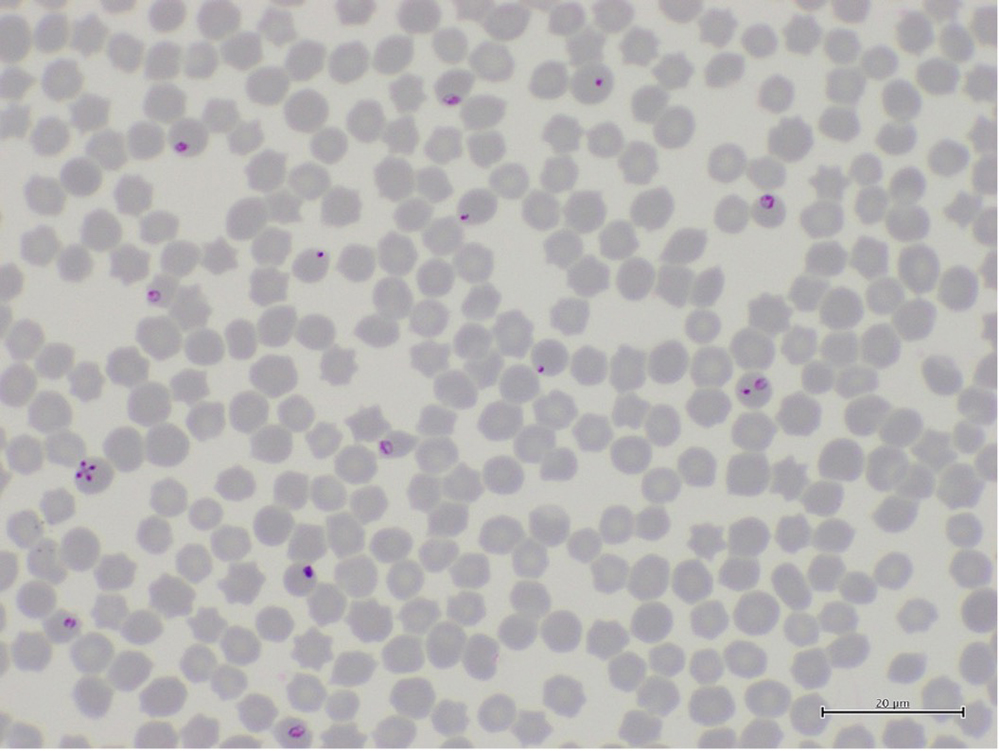
Microscopic images of Theileria equi within erythrocytes

Foreword
Animal production in Australia is a significant contributor to the economy and a major employer of rural and regional Australians.
We are fortunate to be free from most major diseases of livestock that impede production, affect trade and cause serious animal welfare concerns. Historically, this can be attributed in part to the distance and limited movements of animals, animal products and people from other major livestock producing regions.
As international movement of passengers, mail and cargo are increasing so is the risk of an incursion. In 2023-2024, 21.6 million international travellers and 124 million cargo consignments came into the country.
Freedom from emergency animal diseases offers a market advantage for exports of Australian animals and animal products. For example, in 2022, ABARES updated the economic impact of a foot-and-mouth disease (FMD) incursion. They estimated $80 billion export revenue would be lost across the pork, beef, dairy, sheep meat and wool industries.
The original chapters in this book were written by some of the foremost experts in their field. They help veterinarians with early detection, diagnosis and control of exotic and emerging infectious diseases in livestock.
This edition contains 12 new chapters on diseases and syndromes that have emerged or increased in importance since the previous edition.
Dr Beth Cookson
Australian Chief Veterinary Officer
Department of Agriculture, Fisheries and Forestry
Dr Debbie Eagles
Director, Australian Centre for Disease Preparedness
CSIRO
Acknowledgements
This publication would not be possible without the support of many dedicated individuals.
Organisational support was provided by Kelly Maher and editorial support by Rhyll Vallis of the Department of Agriculture, Forestry and Fisheries. See the full list of contributors.
Funding was provided by Australian Government’s Agricultural Competitiveness White Paper.
We acknowledge Ausvet’s contribution to the new chapters for the 2025 update. Their work was commissioned under the Ag2030 Budget Measure: Better understanding how pests and diseases could enter Australia. This measure aims to improve field tools and diagnostic capabilities.
Many of the images were sourced courtesy of the Center for Food Security and Public Health.
Download a PDF copy of this field guide
If you have difficulty accessing these files, contact us for help.
Preface
Outbreaks of emergency animal diseases (EADs) in Australia have the potential to cause significant socio-economic impacts, and affect animal, human and environmental health. Many of these diseases are exotic to Australia.
New diseases of animals continue to emerge and with this trend likely to continue it is important that veterinarians are prepared to investigate any unusual outbreaks of disease in domestic animals.
This field guide provides field veterinarians with readily accessible information on EADs. It will help those in the field include appropriate EADs in their differential diagnoses, and take appropriate action if presented with signs of an unusual disease.
Early and accurate diagnosis of any case of an EAD is essential for effective control, since controlling localised disease is more effective than managing widespread disease.
Exclusion testing of EADs conducted on suspect case investigations increases the likelihood of early detection of any EAD events in Australia. All negative laboratory test results generated through this process provide data that support Australia’s claims of freedom from EADs for international market access purposes.
This field guide does not provide exhaustive information on each disease, focusing instead on information that veterinarians need when confronted with disease situations in the field. It is not a textbook, and we refer readers to more comprehensive sources at the end of each disease chapter. Likewise, the discussion of laboratory procedures is limited to information that helps with collecting and submitting useful diagnostic samples.
This field guide covers high priority syndromes and diseases of domestic terrestrial animals. It is intended that further syndromes and disease chapters will be added over time. It complements the Australian Veterinary Emergency Plan (AUSVETPLAN), Australia’s coordinated national response plan for controlling and eradicating EADs.
Other materials are available to assist disease recognition and investigation in aquatic animals, and in wildlife. The Australian Government Department of Agriculture, Forestry and Fisheries has published Aquatic Animal Diseases Significant to Australia: Identification Field Guide 4th Edition. The Wildlife Health Australia website also includes resources to support investigation of wildlife diseases.
Acronyms and abbreviations
| Term | Definition |
|---|---|
| ACDP | Australian Centre for Disease Preparedness |
| AFIP | Armed Forces Institute of Pathology |
| AHS | African horse sickness |
| AI | Avian influenza |
| ASF | African swine fever |
| BSE | Bovine spongiform encephalopathy |
| CFSPH | The Center for Food Security and Public Health |
| CSF | Classical swine fever |
| EAD | Emergency animal disease |
| EuFMD | European commission for the control of foot-and-mouth disease |
| FMD | Foot-and-mouth disease |
| EHD | Epizootic haemorrhagic disease |
| EI | Equine influenza |
| HPAI | Highly pathogenic avian influenza |
| LPAI | Low pathogenic avian influenza |
| LSD | Lumpy skin disease |
| PED | Porcine epidemic diarrhoea |
| PIADC | Plum Island Animal Disease Center |
| PPR | Peste des petits ruminants |
| PrP | Protease resistant protein |
| PRRS | Porcine reproductive and respiratory syndrome |
| RVF | Rift Valley fever |
| SVD | Swine vesicular disease |
| TGE | Transmissible gastroenteritis |
| USDA | United States Department of Agriculture, Forestry and Fisheries |
| vCJD | variant Creutzfeldt-Jakob disease |
| VS | Vesicular stomatitis |
| WAHIS | World Animal Health Information System |
| WOAH | World Organisation for Animal Health |
1. General information
1.1 Roles and responsibilities of field veterinarians in emergency animal disease detection and reporting
Australia’s animal health system relies on veterinarians reporting any suspicion of an emergency animal disease (EAD).
EADs are diseases that have been agreed by governments and industry in Australia as capable of having severe effects on trade, production, the environment, and/or human health. Most are diseases exotic to Australia but some are endemic diseases such as Hendra virus infection and anthrax. Others are described as ‘emerging diseases’ because increasing incidence and/or an expanding geographic or host range would result in them having greater trade or public health effects.
It is important that veterinarians know about EADs for several reasons.
- Early detection and reporting helps prevent the establishment of exotic diseases, or the spread of serious endemic diseases, some with human health implications.
- Investigating any suspected EAD generates evidence that helps support Australia’s animal health status claims.
- Veterinarians have legal and professional requirements to report any suspected EAD.
When to suspect an emergency animal disease
There is a large list of (in some cases, unfamiliar) notifiable animal diseases that veterinarians must report to the government authorities in each state and territory of Australia. All EADs are notifiable animal diseases in all states and territories nationally.
Broadly, you might suspect EADs in cases where:
- there are abnormal mortality rates (in any species, including birds)
- there are abnormal morbidity rates in animals (including birds)
- there is rapid spread of disease through a herd or flock
- the disease event affects multiple species
- cloven-hooved animals have ulcers, erosions or blisters around the feet, muzzle, udder or teats and/or in the mouth
- cloven-hooved animals are lame and drooling or salivating excessively
- affected animals display unusual nervous signs (or progressing nervous signs)
- there are multiple, deep, fly-struck wounds (particularly if this occurs in northern Australia)
- there is a sudden, sharp and inexplicable fall in production
- there are unusual and concerning clinical signs of disease in animals or birds
- the clinical presentation suggests signs of a particular EAD, including those listed in Section 3.
How to report an emergency animal disease
If you suspect an EAD, phone government animal health authorities immediately from the affected property.
This is the most important step, because effective disease control relies on early detection.
Call the Emergency Animal Disease Hotline on 1800 675 888 to report the suspected EAD. Government duty veterinarians monitor the hotline and are available to advise you 24 hours a day, 7 days a week.
Alternatively, notify a state or territory government veterinary officer of the suspected EAD directly.
Leaving messages is inadequate. Avoid relying on other people to make the notification.
If you are unable to make a telephone call from the affected property, you should disinfect yourself and your vehicle (as thoroughly as possible in the circumstances) and travel to the nearest site where you can make the call. Ensure you do not enter premises with susceptible animals.
What information to include in a report
You will need to include this basic information in the initial telephone notification:
- the types and approximate numbers of animals on the property (including feral animals) and which species are affected
- a brief description of clinical signs of disease and gross lesions observed
- the disease or diseases suspected
- the name of the owner and/or farm manager
- the full address and telephone number for the property
- the date when the disease was first noticed, approximate numbers of sick and dead animals
- whether any susceptible animals have recently left or been brought onto the property
This information allows animal health authorities to make the initial disease control and epidemiological tracing to begin.
You should remain on the property until a government veterinary officer arrives unless otherwise advised. Use this time to implement biosecurity measures to prevent further spread of infection, gather a comprehensive clinical history and epidemiological data on the outbreak from the livestock owner or workers.
Who should take samples and conduct a disease investigation?
Although this book provides general guidance, you should seek advice before sampling and conducting a disease investigation.
This is the decision of the state or territory Chief Veterinary Officer (CVO) or their delegate. It will depend on the circumstances. For example, in cases where there is a high suspicion of an EAD, the CVO would be expected to send a diagnostic team to investigate the outbreak and collect diagnostic samples.
This will ensure that risks to human and animal health of highly infectious diseases are managed appropriately, and investigations are undertaken effectively.
1.2 Safety, personal protection and containment of infection
Biosecurity for personal protection and infection containment
When you suspect an EAD, you need to use routine biosecurity procedures to:
- contain infection to prevent the spread of infectious animal diseases between groups of animals on the property and to animals on other properties
- prevent exposure of veterinarians and other people (including clients, clinic staff, couriers and laboratory staff) to potential zoonotic agents. Each state and territory identifies the prevention of exposure in occupational health and safety legal requirements.
Containment of infection
Containing the infection is of prime concern and you should gain the property owner’s cooperation to:
- secure potentially-infected animals in well-fenced paddocks, yards, buildings, pens or cages, and prevent contact with unaffected herds or flocks of animals
- confine animals as well as potentially-infected livestock products and fomites to the property
- move livestock away from farm borders, particularly in the case of suspected diseases for which the causal organism can be airborne over considerable distances (e.g. foot-and-mouth disease)
- avoid actions that would encourage the dispersal of feral animals from the property
- dissuade people who have had recent contact with livestock from leaving the property
- discourage unnecessary visitors from entering the property.
Advise any persons on the property to contact a government veterinary officer for instructions on personal disinfection (for containment purposes) before leaving the property.
Investigating a suspected zoonosis
Several animal diseases have serious public health implications. Examples are Hendra virus infection, rabies and Rift Valley fever. In investigating such diseases, you may need extra precautions to prevent infection of personnel by ingestion, inhalation of infected aerosols, or contamination of mucous membranes or abraded skin.
You may need to wear face masks, eye protection and standard protective clothing depending on the suspected disease. This is discussed in the appropriate chapter on each disease.
Adequate restraint and safe handling of live animals and carcasses is of critical importance, especially where diseases such as rabies are suspected as animals may become aggressive or unpredictable. In addition, when investigating a suspected zoonosis, personal hygiene and disinfection, as well as decontamination of post-mortem sites, must be of the highest standard.
Advise the client, the farm owner or manager and in-contact family members, farm employees and visitors of the steps they need to take to avoid infection. This should include advice on the safety of consumption of farm products.
1.3 General principles of disease investigation
The material in this section only provides general information on conducting a disease investigation. Seek advice from government veterinary services when you suspect an EAD.
A routine process for disease investigation involves assembling evidence and should include (click on the links for relevant sections):
- implementing biosecurity procedures
- taking a thorough history
- determining a case definition for the health problem
- conducting overall clinical assessment of various groups or classes of animals
- performing a thorough clinical examination of affected individual animals
- performing a thorough post-mortem examination(s)
- submitting laboratory samples to help make or confirm a diagnosis
- following up disease events to monitor progress.
Routine disease investigation biosecurity procedures
Routine disease investigation biosecurity procedures include:
- pre-visit preparation
- entry and exit procedures (which include hygiene practices and the use of personal protective equipment)
- safe transport of diagnostic specimens
- follow-up.
Pre-visit preparation
Equip your vehicle with (in easily accessible containers with fitted lids):
- personal protective equipment
- extra clothing (boots and overalls)
- cleaning (disinfection and decontamination) gear (including plastic bags)
- equipment for restraint and humane destruction of animals
- post-mortem instruments
- instruments, containers and media for collection and transport of diagnostic specimens
- telephone numbers and stationery.
The level of zoonotic disease risk and disease transmission risk presented by different animal disease investigation situations varies considerably. Therefore, it is fitting that you take a risk-based approach to manage the likelihood and consequences of either exposure to potential zoonotic infectious agents or the spread of infectious agents between sites.
Ensure risk management is commensurate to the level of risk posed. Veterinarians should:
- use the minimum standard of personal protective equipment and biosecurity practices for any disease investigation
- use an enhanced level of personal protective equipment and biosecurity practices where there is greater risk, such as when
- exposure to a zoonotic pathogen during a disease investigation is plausible
- the situation suggests that the disease agent may be highly transferable via fomites
- use the highest level of personal protective equipment and biosecurity practices when the risk is highest, that is, potentially life-threatening zoonoses are involved. Examples would be suspected cases of Hendra virus infection, Australian bat lyssavirus infection or highly pathogenic avian influenza. Veterinarians need to keep abreast of the current guidelines and procedures for handling such cases.
It is suggested that veterinarians use a checklist (see an example in Appendix B) of equipment for disease investigation. Veterinary vehicles should carry supplies for both high- and low-risk activities.
Entry and exit procedures
In line with the principles of the perceived level of risk, practitioners should determine for each visit what entry and exit procedures are required.
Low biosecurity risk sites
For routine, low biosecurity risk site visits, standard procedures might include:
- wearing clean overalls (regular or disposable)
- wearing new, clean boots and/or washing footwear before entry
- using clean instruments and equipment (in clean containers)
- wearing gloves prior to handling animals or carcasses
- wearing coverall clothing and protective footwear
- maintaining hygienic processes when handling biological samples
- safely packing biological samples
- removing, bagging and disposing of used gloves, disposable overalls and other wastes before exiting the property
- cleaning instruments in soapy water
- cleaning boots thoroughly (grooves in the soles and the outside) prior to exiting the property
- removing and bagging any dirty garments (such as overalls) prior to exiting the property
- washing hands prior to exiting the property
- cleaning and disinfecting clothes and equipment, replacing materials and disposing of contaminated waste in a biosecure way.
Higher biosecurity risk sites
For higher risk visits where there is a greater suspicion of (or likelihood of) disease spread, veterinarians should follow more thorough entry and exit procedures, and adopt more stringent personal hygiene and PPE measures. It is the practitioner’s responsibility to align these to disease specific procedures and the situation presented.
It is useful to have these processes detailed in clinic standard operating procedures that are carried in the vehicle. Ensure the equipment needed to follow these steps is packed in the vehicle at all times, as you will not always receive warning of when you will require them.

When attending cases where the zoonotic and/or infectious risk has been assessed as high, veterinarians must wear full personal protective equipment during clinical examination and post-mortem examination. This may include the use of P2 or P3 masks, eye protection, double disposable gloves and involve strict protocols.
This includes situations where there is a suspicion of a significant zoonotic agent (e.g. Hendra virus infection, highly pathogenic avian influenza, anthrax, rabies lyssavirus infection, bat lyssavirus infection, Rift Valley fever, Nipah virus infection and transmissible spongiform encephalopathies).
When attending sites with a high biosecurity risk, follow a checklist (see Table 1.3.1 for an example) to implement high-level biosecurity protection.
Table 1.3.1 and Table 1.3.2 provide checklists for biosecurity entry and exit procedures.
High biosecurity risk site visit checklist
Park your vehicle at a distance from livestock handling areas. to minimise the possibility that your vehicle will become contaminated. Leave your watch and all jewellery items in the vehicle. Retrieve all items required for the disease investigation from the car so you do not have to return. Identify clean, dirty and transition zones between your vehicle and the livestock handling area (Figure 1.3.1). |
Set up decontamination equipment in the transition zone and lay out a ground sheet. In the transition zone, place:
In the clean zone, place:
|
Put on personal protective equipment while in clean zone, being sure to:
The outer packing of specimen transport containers should not be taken into the dirty zone. |
Enter the dirty zone. While on the property, select suitable areas for ante-mortem and post-mortem examination of animals. Conduct examination, sampling or post-mortem, and:
|
At the completion of examinations (clinical or post-mortem) and collection of diagnostic specimens:
|
While still in the dirty zone:
|
Return to the transition zone and:
Once in the clean zone:
|
Assembling the evidence for diagnosis
Taking a case history
Taking a careful history of the events that have occurred, formulating a case definition to clarify precisely what is being investigated, and doing some basic epidemiology are important components of a disease investigation.
Taking a history requires the collection of accurate, quality information. Preparing a standard history collection template can help with gathering evidence (see an example in Appendix A).
Clinical investigation
Several specific guidelines for veterinarians performing clinical livestock disease investigations are to:
- use personal protective equipment appropriate to the situation
- begin investigation with the least affected groups of animals
- clinically examine representative numbers of clinically affected and unaffected animals
- determine a working case definition
- take samples from an the appropriate number of animals for laboratory testing, based on advice from government veterinary officers
- consider taking samples from affected and unaffected animals where pertinent
- take an appropriate range of samples
- always take body temperatures (remember that pyrexia is a key finding in many EADs)
- ensure the proper restraint of animals, which is necessary both for personal safety and to ensure that a comprehensive examination of individuals can be done.
Selection of animals for clinical examination
It is important to select animals that are fully representative of the disease syndrome in the affected herd or flock. Where possible:
- collect diagnostic samples from several animals
- collect samples from animals early in the clinical course (not only are the causal organisms usually found in greatest concentration in tissues at this time, but secondary infections, which may mask the underlying cause, are less likely to be present)
- collect specimens from animals that are freshly dead (most viruses and bacteria are quickly inactivated after the death of the host as autolysis of tissues occurs, particularly in hot weather) or slaughter sick animals for the purpose.
In some cases it may be desirable to deliver live sick animals to the laboratory (e.g. poultry). However, this must only be done after advice from the government veterinary officer and/or laboratory, who will take into account the microbiological security of such action and the physical security of the animals while being transported.
Case definitions
You can develop a working case definition following the history taking process and clinical examination. The benefit of having a case definition is that it helps to define whether there is a single disease or multiple problems occurring at the same time.
A case definition may need to be flexible to prevent excluding cases that are related, and can be altered over time if more information comes to light. This is helpful in providing clarity in determining the nature of unfolding disease events.
Basic epidemiological analysis
A distribution map, which shows the location and distribution of the livestock affected on a property (in relation to the location of all the livestock), plus paddocks and water bodies, may help suggest a possible cause of the problem. This may be hand drawn.
In addition, it is good practice in field investigations for veterinarians to use basic epidemiological measurements to determine fundamental event descriptors such as prevalence, incidence and mortality rates.
Prevalence is the proportion of a population affected by a disease at a given point in time. The prevalence is the number of affected animals divided by the total number of animals at risk.
Incidence is a measure of new cases of disease in a population within a defined time period. The cumulative incidence is the number of animals developing disease over the period in question divided by the number of non-diseased animals at the start of the period.
Mortality is the number of dead animals divided by the total number of animals in the population at the start of the period.
Other factors may also influence the expression of disease, including species, age, sex, reproductive status or other management activities. Comparing the prevalence, incidence or mortality in particular classes of animals can indicate factors associated with expression of disease.
It may also be useful to draw a timeline which shows the number of cases occurring over time and events considered potentially related to the problem. Similarly, a plotted graph of number of cases over time (an epidemic curve) is useful to visualise the timeframe of the outbreak or disease event. The pattern of the graph can indicate whether cases have the appearance of a ‘point source’ problem (such as a single access to a toxin) or a ‘propagating epidemic’ (indicating a possible infectious disease occurrence).
Post-mortem examination
Undertake post-mortems only where it is safe to do so. You should not conduct post-mortems for sudden death of livestock in the field due to the possibility of anthrax.
Post-mortem examinations should be carried out in a systematic way to ensure nothing is missed. This routine approach also leads to the most efficient use of time.
In conducting post-mortems, personal safety is paramount—both from the risk of exposure to animal pathogens and the physical risks involved with using sharp equipment. Post-mortems are sometimes carried out in less than ideal situations and under time pressures. However, it is essential for veterinarians to ensure their personal safety and follow standard procedures to reduce the risk of accidents.
There are many detailed guides on post-mortem procedures. In general, it is important for veterinarians to:
- have a standardised procedure that you follow routinely. It is important not to deviate based on initial findings or a narrow differential diagnosis list
- work safely for the benefit of themselves and others nearby
- examine all organs and tissue systems in a systematic way, even if lesions appear to be confined to one system
- record gross lesions in a report to give the reader a clear understanding of the lesions seen. Consider using a waterproof camera to record lesions that can be disinfected following the post-mortem
- collect a comprehensive range of diagnostic specimens for consideration in the differential diagnosis
- maintain and use sharp equipment
- have all equipment available in an organised way
- have a pre-arranged sample collection system (i.e. mark containers clearly (and ideally pre-label them)
- place samples into appropriate collection containers
- have and use a routine to maintain cleanliness
- conduct more than one post-mortem
- where possible, post-mortem freshly dead animals and consider sacrificing sick animals (since only limited information can be obtained from decomposed carcasses)
- dispose of carcasses appropriately.
Samples for laboratory diagnosis
In the routine investigation of endemic diseases field diagnosis based on clinical, pathological and epidemiological evidence are adequate on many occasions. However, when faced with an outbreak of an unusual disease, possibly an EAD, it is crucial that an accurate confirmatory laboratory diagnosis is obtained as rapidly as possible. Failure to do so may compromise the success of any attempted eradication campaign.
Collecting and submitting a variety of samples allows for open-ended testing and increases the likelihood of accurate diagnosis. Multiple fixed tissues and sera allow for non-specific testing, and veterinary laboratories can hold extra samples pending the initial testing results.
You should contact the veterinary laboratories you use for their specific requirements and guidelines. Some diseases (e.g. bovine spongiform encephalopathy and scrapie) require specific samples. Details of special requirements are provided in the appropriate disease chapter in this guide. Later chapters will describe specific samples to submit by syndrome; however, a general description of samples to collect is shown in Table 1.3.3.
| Sample type | Examples of samples to take | Storage/transport conditions |
|---|---|---|
| Ante-mortem samples | Blood samples (samples from at least 10 animals are recommended):
Swab (ensure the swab fully absorbs sample fluid) e.g. oral, nasal, rectal | Blood samples:
Sterile swab in PBGS |
| Fresh tissue (in separate individual sterile containers) | Tissue samples (samples from at least five animals are recommended) from organs relevant to clinical signs/gross necropsy findings, as well as:
| Fresh samples:
|
| Fixed samples (pooled in formalin – 10:1 formalin: tissue) | Tissues from lesions and representative samples from each organ system | Fixed tissues:
|
Labelling of samples
Note that:
- each specimen container should be clearly labelled with the property and animal identification, date of collection and the tissue enclosed
- waterproof labels/labelling used should stay attached and writing remain legible if the outside of the containers become wet.
Documentation to accompany samples
When you are outside of the infected area complete the relevant state laboratory submission form/specimen advice note. This specimen advice note is included inside the outer packaging (see section on sample packaging).
The specimen advice note should include:
Location and contact information
- owner’s name and address of property, with appropriate contact information
- name, address and contact information of the sender.
Case information
- disease agents suspected and tests requested
- species, breed, sex, age and identity of the animals sampled
- date when samples were collected and submitted
- list and type of samples submitted with transport media used
- case history, including
- list of animals examined and findings
- clinical signs and their duration
- length of time the sick animals have been on the premise and, if recent arrivals, where they originated from
- date of first case and subsequent cases.
Epidemiological information
- a description of the spread of infection in the herd or flock, for example, the number of sick or dead animals/number of exposed animals
- different species on the property and numbers of each
- type and standard of animal husbandry on the property, including the type of feed available, biosecurity measures and other relevant factors potentially associated with the occurrence of cases
- history of foreign travel by owner or of introduction of animals from other countries or regions
- any medication given to the animals, and when given
- vaccination history describing the type of vaccines used and dates of application
- other observations about the disease, husbandry practices and other disease conditions present.
Sample packaging
Package and transport all biological materials in accordance with local, national and international regulations. The minimum requirements for transporting specimens follow the principle of triple packaging, which consists of three layers—a primary receptacle (such as a blood tube or specimen container), secondary packaging (for example a plastic container), and an outer packaging.
In addition:
- a primary container is packed into the secondary container on the infected property, along with absorbent material
- the secondary container must have its surface disinfected and be removed from the infected area prior to packaging in the outer transport container
- label the outer packaging with the name, address and 24-hour telephone number of the sender, the delivery address, orientation labels and any other relevant regulatory requirements
- contact government veterinary laboratories regarding supplies of suitable packing containers
- store suitable gel packs (‘cold bricks’) frozen at –20°C, ready for use
- use dry ice if the journey is expected to take several days. Seal the sample containers to ensure that CO2 does not reach the samples, which could affect sample pH
- seek advice from the appropriate government veterinary authority when carcasses or other specimens to be submitted are too large to be packed into a specimen transport container.
Transport of laboratory samples
Australia has strict regulations governing the road, rail and air shipment of clinical material and specimens. Specimens that are incorrectly packaged and labelled can be refused for transport or laboratory processing, and may put the safety of those receiving the specimens at unnecessary risk. For example leaking containers, blood in syringes, with or without needles, are unacceptable.
Veterinarians and clinic staff must ensure that packages containing biological material meet the requirements outlined in the current Australian Code for the Transport of Dangerous Goods by Road or Rail. It is recommended that commercial packaging and printed labels be used.
Consignments of specimens suspected of containing pathogens are considered to be dangerous goods (infectious substances). A person holding a current certification for dangerous goods must pack dangerous goods consignments for air transport. Mark the appropriate shipping name and number for the dangerous goods on the package. In most cases this will be UN 2900 (infectious substances, affecting animals only, in solid or liquid form) or UN 2814 (infectious substances, affecting humans, in solid or liquid form) or air or by post transport.
In either case, the actual name of the infectious agent (known or suspected) should be added in parentheses. Complete two copies of the shipper’s Declaration/or Dangerous Goods form for transport by air or by post. These must accompany the package, in the plastic envelope for shipping documents, attached on the side of the box.
The Animal Health Committee has developed protocols for the submission of likely EAD specimens to the Australian Centre for Disease Preparedness (ACDP). These are contained in the AUSVETPLAN management manual Laboratory Preparedness (pdf 284kb).
Follow-up
An important disease investigation principle is to follow-up with owners to determine if there are any ongoing concerns. Follow-up allows veterinarians to see if the situation has escalated or otherwise changed. You should not only rely on owners keeping you up to date with the clinical progression of the incident. Rather, actively make contact to monitor the situation, as this is a proactive way to ensure that an escalating situation does not go unnoticed. It can be beneficial to routinely schedule follow-up calls to producers after you have made livestock disease visits.
2. Guide to investigation of disease syndromes
2.1 Vesicular diseases
The term ‘vesicular diseases’ refers to a group of highly infectious viral diseases of cloven-hooved animals.
Due to the animal production and international trade ramifications of vesicular diseases, particularly foot-and-mouth disease (FMD), early detection of vesicular diseases is crucial. Vesicular diseases can cause high morbidity, but typically present with very low to no mortality.
Clinical signs
Clinical signs of vesicular diseases are similar. They include:
- excessive salivation
- lameness
- reluctance to move, huddling together
- vesicles and ulcers on the feet, mouth, and teats
- hoof lesions including separation of corium
- pyrexia and depression
- unwillingness to eat.
In addition, secondary bacterial infections may lead to other clinical signs such as mastitis and reduced milk production in dairy cows.
Potential causes
A range of endemic and exotic infectious diseases present with vesicles and ulcerations, as well as several non-infectious diseases. Because of this, in addition to vesicles, you will need to consider other clinical signs present when determining a differential diagnosis list.
FMD is the most economically important vesicular disease for Australia and it affects multiple species (goats, sheep, cows and pigs). Because FMD is extremely contagious and an outbreak would have a significant economic impact to Australia, we must properly investigate and diagnose all vesicular diseases. Table 2.1.1 presents a list of vesicular diseases and the livestock species affected.
| Disease | Cattle | Goats and sheep | Deer | Pigs | Horses |
|---|---|---|---|---|---|
| Foot-and-mouth disease | Yes | Yes | Yes | Yes | No |
| Senecavirus A (Seneca Valley virus) infection | (antibodies only; no disease to date) | No | No | Yes | No |
| Swine vesicular disease | No | No | No | Yes | No |
| Vesicular exanthema of swine (not seen globally since 1956) | No | No | No | Yes | No |
| Vesicular stomatitis | Yes | No | No | Yes | Yes |
A number of other exotic diseases have similar clinical signs to viral vesicular diseases, particularly during their more advanced clinical stages. These include:
- bluetongue disease (affects cattle, deer, goats and sheep)
- peste des petits ruminants (affects goats and sheep)
- rinderpest (now recognised as globally eradicated by the World Organisation for Animal Health (WOAH) (affects cattle, goats and sheep).
Endemic diseases, which may cause similar clinical signs to viral vesicular diseases include, but are not limited to:
- bovine papular stomatitis (affects cattle)
- foot rot (affects cattle and sheep)
- Glässers disease (Haemophilus parasuis) (affects pigs)
- infectious bovine rhinotracheitis (affects cattle)
- malignant catarrhal fever (only sheep-associated malignant catarrhal fever is endemic) (affects cattle)
- mucosal disease caused by bovine viral diarrhoea (BVD). Only BVD virus 1 is endemic in Australia (affects cattle).
Non-infectious causes of similar clinical signs to viral vesicular diseases include but are not limited to:
- chemical irritants and scalding (affects cattle, deer, goats, horses, pigs and sheep)
- dermatophilus and other types of mycotic stomatitis (affects cattle, deer, goats, horses, pigs and sheep)
- idiopathic vesicular disease in pigs (affects pigs)
- insect bite hypersensitivity (affects cattle, deer, goats, horses, pigs and sheep)
- lesions of the mouth and feet due to trauma (affects cattle, deer, goats, horses, pigs and sheep)
- lameness due to bad or hard floors (affects cattle, deer, goats, pigs and sheep)
- phototoxic dermatitis with vesicle formations from contact with the leaves of plants of the family Umbelliferae (parsley, parsnips and celery) (affects cattle, deer, goats, horses, pigs and sheep).
Some differential diagnoses may be eliminated by taking a thorough history including environmental observations (such as possible trauma or exposure to parsnips or celery) and a thorough clinical examination (such as for chemical burn). Also important is information about the clinical picture of the herd (i.e. are single or multiple animals affected?).
Reporting requirements
If you suspect an emergency animal disease, report it immediately. Call the Emergency Animal Disease Hotline on 1800 675 888, wherever you are in Australia. Alternatively, contact a government veterinarian in your state or territory.
Government duty veterinarians monitor the hotline and are available to advise you 24 hours a day, 7 days a week.
Investigation and sampling guidelines
Undertake a thorough physical examination of sick animals, including taking rectal temperatures. Speaking to the farmer and people who have cared for the animals will help establish the history for these cases. Conduct a post-mortem on any dead animals (but note that the vesicular diseases do not typically cause death). Animals may present with lameness and inappetence.
Investigate and sample of a range of animals, including at least 10 clinically healthy animals, to help identify new cases and determine the level of morbidity in the herd or flock.
Some differential diagnoses may be zoonotic and have public health implications. Take extra precautions investigating such diseases, including using appropriate personal protective equipment, to prevent infecting personnel by ingesting, inhaling infected aerosols, or contaminating mucous membranes or abraded skin.
Samples required
Take samples from at least five affected animals in the herd, flock or group. These can be taken from lesions in the mouth or the feet, or at other sites with suitable lesions.
The best samples for all vesicular disease exclusions are:
- vesicular fluid
- epithelium from unruptured vesicles (1–2 cm)
- epithelial tags from freshly ruptured vesicles (1–2 cm)
- nasal, oral and tonsillar swabs
- oropharyngeal fluid, collected with a probang or swabs if unavailable
- serum from affected, recovered and a selection of unaffected animals (minimum 7–10 ml; at least 10 animals per group).
Epithelium and granulation tissue from healing lesions that is difficult to detach and fibrin covered lesions are generally unsuitable for isolation of virus. If only older lesions are present, include samples from foot lesions as these tend to have higher concentrations of virus for longer periods than do lesions at other sites. To avoid bacterial contamination, you may need to wash animals’ feet and you may rinse epithelial samples from the foot in phosphate buffer before placing in sample vials.
In addition to samples from oral, foot and teat lesions, you should also collect fresh and formalin-fixed samples from several tissues (lymph nodes, thyroid and adrenal glands, kidney, spleen and heart) from dead animals.
Sample collection
The laboratory will be able to test for the presence of all vesicular viruses in samples. Refer to Table 2.1.2.
It is important to note that FMD virus is very sensitive to both acid and alkaline conditions and inappropriate buffer conditions can inactivate the virus making virus isolation difficult or impossible. To maximise chances of virus isolation:
- use phosphate buffered saline or virus transport media with a pH of 7.6.
- if a sample is to be submitted after 24 hours or more, glycerol should be added to the phosphate buffered saline
- oropharyngeal fluid collected with a probang should be diluted in an equal volume of phosphate buffered saline pH 7.6, and mixed vigorously for 1 minute.
Note that collection of samples in these buffers is optimal (for the growth of FMD virus) but not essential for RNA or antigen detection assays.
Collect:
- serum, 7–10 ml/animal in plain tubes
- vesicular fluid, carefully use a syringe and needle to aspirate the vesicular fluid from unruptured vesicles, and place in a sterile container. Alternatively, collect fluid from small vesicles onto a swab and place the swab in 500 μl of buffer, such as phosphate buffered saline or virus transport medium
- fresh tissue, epithelium, epithelial tags, oral, nasal and tonsillar swabs and oropharyngeal fluid and submit in phosphate buffered saline or virus transport medium, if available
- fixed tissue, a range of tissues (lymph nodes, thyroid and adrenal glands, kidney, spleen and heart) from dead animals.
| Collection container | Sample |
|---|---|
| Sterile tube (with viral transport media or phosphate buffered saline if available) | Vesicle fluid, vesicle epithelium, nasal and oral swabs, oropharyngeal fluid collected with a probang or tonsillar swab |
| Plain tube | Blood for serology |
| Fresh and formalin-fixed samples | Several tissues (lymph nodes, thyroid and adrenal glands, kidney, spleen and heart) collected from dead animals |
Transport of samples
For transport:
- chill blood samples and unpreserved tissue samples at either 4 °C, or with frozen gel packs
- DO NOT FREEZE SAMPLES at -20 °C; it reduces the sensitivity when used for virus isolation and molecular diagnostic tests
- send samples with dry ice if the journey is expected to take several days
- formalin-fixed samples can be sent at room temperature.
Sample submission
The relevant state or territory laboratory should coordinate sample packaging and consignment for delivery to the Australian Centre for Disease Preparedness.
2.2 Sudden death in pigs
Sudden death in pigs may be associated with a wide range of infectious diseases or non-infectious causes. Some of these infectious diseases are exotic to Australia and need to be excluded from the disease investigation.
Clinical signs
Sudden death can be defined as death occurring with little or no observed clinical signs. In most cases pigs will be found dead, often in good body condition. As such, there is increased importance placed on post-mortem evaluation and diagnostic testing as part of the disease investigation process. In addition, close observation of remaining animals may be useful in attempting to detect peracute clinical signs. Clinical signs (if observed) will depend on the aetiological agent involved and the age of the animals affected.
The epidemiological picture may also help to determine whether an exotic disease is involved with a sudden death incident. In most cases, an exotic disease will affect multiple animals and spread rapidly throughout the herd.
Potential causes
Exotic diseases that may cause sudden death in pigs include:
Note that while classical swine fever and Aujeszky’s disease are not typically associated with sudden death, the acute form of these diseases may cause sudden death in young piglets. Some strains of FMD virus can also cause peracute disease leading to sudden death in very young piglets.
Endemic diseases that may cause sudden death in pigs include:
- Actinobacillus suis in piglets
- bacterial endocarditis in piglets, weaners, growers and finishers
- Bungowannah virus in piglets
- colibacillosis (Escherichia coli) in piglets and weaners
- erysipelas (Erysipelothrix rhusiopathiae) in growers and finishers
- encephalomyocarditis (Encephalomyocarditis virus) in piglets
- Glässers disease (Haemophilus parasuis) in weaners, growers and finishers
- oedema disease (E. coli) in weaners, growers and finishers
- pleuropneumonia (Actinobacillus pleuropneumoniae) in weaners, growers and finishers
- streptococcal septicaemia in weaners, growers and finishers.
Non-infectious causes of sudden death in pigs include:
- electrocution
- endotoxic shock (e.g. from vaccines)
- gastric ulceration
- intestinal torsion
- mulberry heart disease (in weaners)
- overlay (in piglets)
- porcine stress syndrome (in growers and finishers)
- trauma.
Reporting requirements
If you suspect an emergency animal disease, report it immediately. Call the Emergency Animal Disease Hotline on 1800 675 888, wherever you are in Australia. Alternatively, contact a government veterinarian in your state or territory.
Government duty veterinarians monitor the hotline and are available to advise you 24 hours a day, 7 days a week.
Investigation and sampling guidelines
Examine live pigs to detect early clinical signs. In cases of sudden death, undertake a thorough post-mortem examination of multiple pigs to narrow the diagnostic pathway and collect appropriate samples for diagnostic testing. Information about the housing environment, stocking rates, production flow and other rearing details can also help narrow the investigation.
Investigate and sample a range of animals, including at least 10 clinically healthy animals, to help identify new cases and determine the level of morbidity in the herd.
Some differential diagnoses may be zoonotic and have serious public health implications. Take extra precautions investigating such diseases, including using appropriate personal protective equipment, to prevent infecting personnel by ingesting, inhaling infected aerosols, or contaminating mucous membranes or abraded skin.
Samples required
Take samples from multiple dead pigs (at least five if possible) at post-mortem. Collect blood from at least 10 animals (if possible) that have clinical signs. Euthanise some animals for post-mortem examination and sample collection.
Sample collection
Table 2.2.1 details the sample collection required for sudden death in pigs.
| Collection container | Collect from live pigs | Collect from dead pigs |
|---|---|---|
| EDTA tube | Blood | Blood (if possible to collect from recently dead animals) |
| Plain tube | Blood for serology | – |
| Swabs in virus transport medium | Vesicular lesions (if present); nasal, oral cavity, tonsils | Vesicular lesions (if present); nasal and oral cavity |
| Sterile tube | Vesicular fluid (if vesicles present); faeces (if enteric disease suspected) | Vesicular fluid (if vesicles present); faeces (if enteric disease suspected) |
| Sterile collection container (no media) | – | Tonsil, spleen, lymph nodes, lung, brain, kidney, ileum |
| 10% neutral buffered formalin | – | Tonsil, spleen, lymph nodes, lung, brain, kidney, ileum |
Transport of samples
For transport:
- chill blood samples and unpreserved tissue samples at either 4 °C, or with frozen gel packs
- DO NOT FREEZE SAMPLES at -20 °C; it reduces the sensitivity when used for virus isolation and molecular diagnostic tests
- send samples with dry ice if the journey is expected to take several days
- formalin fixed tissue can be sent at room temperature.
Sample submission
The relevant state or territory laboratory should coordinate sample packaging and consignment for delivery to the Australian Centre for Disease Preparedness.
2.3 Respiratory diseases in pigs
Respiratory pathogens are an important cause of morbidity, mortality and production losses in intensively reared pig herds. Multiple infectious diseases often occur concurrently or as a complex within a herd (known as the Porcine Respiratory Disease Complex), and diagnostic approaches should take this into consideration. Complex bacterial pneumonia is often the cause of death in cases of a porcine respiratory disease.
However, diseases such as pneumonia often result from the confluence of multiple host, environmental, management and pathogen factors.
Clinical signs
In many cases, the clinical manifestations of infection and severity of disease is age-dependent (e.g. porcine reproductive and respiratory syndrome). General clinical signs associated with respiratory pathogens may include:
- anorexia/weight loss
- coughing and nasal discharge
- cyanosis, particularly the skin on the nose and ears
- pyrexia
- lethargy
- sudden death
- tachypnoea, dyspnoea, respiratory distress (increased respiratory effort/heaves, open mouth breathing).
Other body systems may be implicated:
- encephalitis (associated with Aujeszky’s disease and Nipah virus infection)
- lymphadenopathy (associated with porcine circovirus type 2 viruses)
- polyserositis (associated with Haemophilus parasuis)
- reproductive loss (associated with porcine reproductive and respiratory syndrome)
- seizures and neurological signs associated with meningitis (e.g. Strepococcus suis).
Potential causes
The presence of multiple concurrent pathogens often complicates investigation of porcine respiratory disease. Although clinical and pathology findings may be most consistent with a bacterial aetiology, you should also consider viral and mycoplasmal pathogens. Carefully consider both infectious and non-infectious causes.
Exotic diseases that may cause porcine respiratory disease include:
- Aujeszky’s disease
- influenza A viruses in pigs (exotic strains)
- Nipah virus infection
- porcine reproductive and respiratory syndrome.
Endemic diseases that may cause porcine respiratory disease include:
- Actinobacillus pleuropneumoniae
- atrophic rhinitis (Bordatella bronchiseptica)
- inclusion body rhinitis (porcine cytomegalovirus)
- miscellaneous opportunistic bacterial infections (Haemophilus parasuis, Pasteurella
- multocida, Streptococcus suis)
- mycoplasmal pneumonia (Mycoplasma hyopneumoniae, Mycoplasma hyorhinis)
- porcine circovirus type 2 associated diseases
- influenza A viruses (human-origin strains, subtypes H1N1, H1N2 and H3N2).
A non-infectious contributing factor to the development of porcine respiratory disease complex is poor air quality, such as high levels of dust and ammonia. In addition, pneumonia associated with ingested toxins (e.g. pyrrolizidine alkaloids, paraquat) is an uncommon cause of respiratory disease in pigs.
Reporting requirements
If you suspect an emergency animal disease, report it immediately. Call the Emergency Animal Disease Hotline on 1800 675 888, wherever you are in Australia. Alternatively, contact a government veterinarian in your state or territory.
Government duty veterinarians monitor the hotline and are available to advise you 24 hours a day, 7 days a week.
Investigation and sampling guidelines
Undertake a thorough physical examination of sick animals, including taking rectal temperatures. Speaking to the farmer and people who have cared for the animals will help establish the history for these cases. Information concerning housing, environment, stocking rates, production flow and other rearing details can also help narrow the investigation. Conduct a post-mortem on any dead animals.
Some differential diagnoses may be zoonotic and have serious public health implications. Take extra precautions investigating such diseases, including using appropriate personal protective equipment, to prevent infecting personnel by ingesting, inhaling infected aerosols, or contaminating mucous membranes or abraded skin.
Samples required
Collect samples from multiple animals, particularly when multiple pathogens are suspected. Aim to collect blood from at least 10 animals and other samples from at least five animals.
Sample collection
Table 2.3.1 details the sample collection required for respiratory diseases in pigs.
| Collection container | Collect from live pigs | Collect from dead pigs |
|---|---|---|
| EDTA tube | Blood | Blood (if possible to collect from recently dead animals) |
| Plain tube | Blood for serology | – |
| Swabs in virus transport media | Vesicular lesions (if present); nasal, oral cavity, tonsils | Nasal and oral cavity, tonsils, trachea |
| Sterile swabs for bacterial culture | Vesicular fluid (if vesicles present); faeces (if enteric disease suspected) | Pleural cavity, lung, pericardial fluid, brain |
| Sterile collection container (no media) | – | Tonsil, trachea, lymph nodes (bronchial), heart, lung, brain, kidney, ileum |
| 10% neutral buffered formalin | – | Tonsil, trachea, spleen, lymph nodes (bronchial), heart, lung (representative sections of all lobes, any lesions), brain, kidney, ileum |
Transport of samples
For transport:
- chill blood samples and unpreserved tissue samples at either 4 °C, or with frozen gel packs
- DO NOT FREEZE SAMPLES at -20 °C; it reduces the sensitivity when used for virus isolation and molecular diagnostic tests
- send samples with dry ice if the journey is expected to take several days
- formalin fixed tissue can be sent at room temperature.
Sample submission
The relevant state or territory laboratory should coordinate sample packaging and consignment for delivery to the Australian Centre for Disease Preparedness.
2.4 Neurological diseases in pigs
A large number of conditions affect the porcine nervous system, and many of these can cause sudden onset or acute outbreaks. The presenting signs of many of these conditions do not allow clinical differentiation, and diagnostic gross changes are infrequently found in the brain and spinal cord. Several emergency animal diseases can cause neurological disease in pigs so careful workup of these conditions is necessary.
Clinical signs
It is difficult to undertake all but the simplest neurological examination of a pig, and few diseases of the nervous system have localising signs. Clinical signs of neurological disorders in pigs include:
- ataxia
- blindness
- circling
- convulsions
- hyperaesthesia
- nystagmus
- paralysis/paresis
- recumbency
- tremor.
Potential causes
Consider other clinical signs present when determining a differential diagnosis as many emergency animal diseases of pigs cause neurological disease.
Exotic diseases that may cause neurological disorders in pigs include:
- African swine fever
- Aujeszky’s disease
- blue eye disease (paramyxovirus)
- classical swine fever (hog cholera)
- eastern equine encephalomyelitis
- enteroviral encephalomyelitis
- Japanese encephalitis
- porcine reproductive and respiratory syndrome
- rabies
- Teschen/Talfan disease.
Endemic diseases that may cause neurological disorders in pigs include but are not limited to:
- congenital tremors (exact cause yet to be determined)
- encephalomyocarditis virus (EMC)
- enteroviral encephalomyelitis
- Glässer’s disease (Haemophilus parasuis)
- haemagglutinating encephalomyelitis virus (HEV)
- Menangle virus
- oedema disease
- streptococcal meningitis
- tetanus.
Non-infectious causes of neurological disorders in pigs include:
- congenital defects
- hypoglycaemia
- iron toxicity
- middle ear infection
- nutritional deficiencies (e.g. pantothenic acid)
- poisons such as arsenic, mercury, monensin and organophosphorus compounds
- porcine stress syndrome
- water deprivation or salt poisoning.
Reporting requirements
If you suspect an emergency animal disease, report it immediately. Call the Emergency Animal Disease Hotline on 1800 675 888, wherever you are in Australia. Alternatively, contact a government veterinarian in your state or territory.
Government duty veterinarians monitor the hotline and are available to advise you 24 hours a day, 7 days a week.
Investigation and sampling guidelines
Undertake a thorough physical examination of sick animals. Speak to the farmer and people who have cared for the animals to establish the case history. Information about housing, environment, stocking rates, production flow and other rearing factors could be particularly useful. Conduct a post-mortem on any dead animals.
Some differential diagnoses may be zoonotic and have serious public health implications. Take extra precautions investigating such diseases, including using appropriate personal protective equipment, to prevent infecting personnel by ingesting, inhaling infected aerosols, or contaminating mucous membranes or abraded skin.
Samples required
Take samples from several pigs. Aim to collect blood samples from at least 10 pigs and other samples from at least five pigs. Investigate and sample a range of animals, including clinically healthy or suspicious animals.
Take a complete set of tissue samples for histopathology from recently deceased or euthanased untreated animals.
Sample collection
Table 2.4.1 details the sample collection required for neurological pigs.
| Collection container | Collect from live pigs | Collect from dead pigs |
|---|---|---|
| EDTA tube | Blood | Blood (if possible to collect from recently dead animals) |
| Plain tube | Blood for serology | – |
| Sterile collection container (no media) | – | Tonsil, spleen, lymph nodes, lung, brain, spinal cord, kidney, ileum |
| 10% neutral buffered formalin | – | Tonsil, spleen, lymph nodes, lung, brain, spinal cord, kidney, ileum |
Transport of samples
For transport:
- chill blood samples and unpreserved tissue samples at either 4 °C, or with frozen gel packs
- DO NOT FREEZE SAMPLES at -20 °C; it reduces the sensitivity when used for virus isolation and molecular diagnostic tests
- send samples with dry ice if the journey is expected to take several days
- formalin fixed tissue can be sent at room temperature.
Sample submission
The relevant state or territory laboratory should coordinate sample packaging and consignment for delivery to the Australian Centre for Disease Preparedness.
2.5 Diarrhoea in pigs
Pigs of all ages are susceptible to enteric diseases, and diarrhoea is a clinical sign common to nearly all enteric disorders. Of all the diseases in the sucking piglet, diarrhoea is the most common and probably the most important. In some outbreaks it is responsible for high morbidity and mortality. In a well-run herd there should be less than 3 per cent of litters at any one time requiring treatment and piglet mortality from diarrhoea should be less than 0.5 per cent.
Clinical signs
Diarrhoea in pigs may occur with little or no other signs or it may be a striking clinical sign of a specific disease. In addition to diarrhoea, clinical signs can include:
- pyrexia (rectal temperature recorded at >39.5°C)
- lethargy
- reduced food intake
- reluctance to move, huddle together
- sunken eyes
- sudden death in young pigs
- wetness and discoloration of skin around the anus and tail.
Potential causes
Diarrhoea in a herd may be due to a single agent but concurrent infections are common and less than ideal environmental conditions can exacerbate these.
Exotic diseases that may cause diarrhoea in pigs include:
- African swine fever
- classical swine fever (hog cholera)
- porcine epidemic diarrhoea
- post-weaning multisystemic wasting syndrome
- transmissible gastroenteritis.
Endemic diseases that may cause diarrhoea in pigs include but are not limited to:
- clostridium
- coccidiosis
- colibacillosis
- internal parasites
- porcine circovirus 2 infection
- proliferative enteropathy (ileitis)
- rotavirus infection
- salmonellosis
- swine dysentery
- yersiniosis.
Non-infectious causes of diarrhoea in pigs include:
- copper poisoning
- fluoride toxicity
- fungal/toxic mould poisoning
- iron toxicity in piglets
- lead poisoning
- mercury toxicity
- organochlorine toxicity
- organophosphate toxicity
- overfeeding
- pantothenic acid deficiency
- paraquat poisoning
- phosphorus toxicity
- salt poisoning
- zinc deficiency.
Reporting requirements
If you suspect an emergency animal disease, report it immediately. Call the Emergency Animal Disease Hotline on 1800 675 888, wherever you are in Australia. Alternatively, contact a government veterinarian in your state or territory.
Government duty veterinarians monitor the hotline and are available to advise you 24 hours a day, 7 days a week.
Investigation and sampling guidelines
A thorough physical examination of sick animals, including taking rectal temperatures, is advised. Speaking to the farmer and people who have cared for the animals will help establish the history for these cases. Conduct post-mortems on dead animals.
Some differential diagnoses may be zoonotic and have serious public health implications. Take extra precautions investigating such diseases, including using appropriate personal protective equipment, to prevent infecting personnel by ingesting, inhaling infected aerosols, or contaminating mucous membranes or abraded skin.
Samples required
Take samples from several pigs. Aim to collect blood samples from at least 10 pigs and other samples from at least five pigs. Investigate and sample a range of animals, including clinically healthy or suspicious animals.
Take a complete set of tissue samples for histopathology from recently deceased or euthanased untreated animals.
Sample collection
Table 2.5.1 details the sample collection required for pigs with diarrhoea.
| Collection container | Collect from live pigs | Collect from dead pigs |
|---|---|---|
| EDTA tube | Blood | Blood (if possible to collect from recently dead animals) |
| Plain tube | Blood for serology | – |
| Sterile tube | Faeces | Faeces |
| Sterile collection container (no media) | – | Tonsil, spleen, lymph nodes, lung, brain, kidney, ileum |
| 10% neutral buffered formalin | – | Tonsil, spleen, lymph nodes, lung, brain, kidney, ileum |
Transport of samples
For transport:
- chill blood samples and unpreserved tissue samples at either 4°C, or with frozen gel packs
- DO NOT FREEZE SAMPLES at -20°C; it reduces the sensitivity when used for virus isolation and molecular diagnostic tests
- send samples with dry ice if the journey is expected to take several days
- formalin fixed tissue can be sent at room temperature.
Sample submission
The relevant state or territory laboratory should coordinate sample packaging and consignment for delivery to the Australian Centre for Disease Preparedness.
2.6 Acute lameness in ruminants and pigs
Acute lameness is a condition with a wide variety of potential causes which can be accompanied by many other clinical signs. It is important to differentiate between lameness and neurological weakness, or ataxia, since the main differential diagnoses of each vary widely. Due to the significance of some of the infectious causes, in particular the vesicular diseases, it is essential for them to be ruled out early.
Clinical signs
Acute lameness conditions can manifest in numerous different ways. Clinical signs that may be evident include:
- abnormal posture and/or conformation
- abnormal limb position
- abrasions, lacerations, puncture wounds
- areas of swelling, heat, erythema, pain, haemorrhage, ecchymosis
- drop in milk production
- drop in conception rates
- hoof lesions including, but not limited to, interdigital dermatitis, ulcers, abscesses, vesicles, cracks
- isolation from the herd
- increased time in sternal and/or lateral recumbency
- odour of the hoof
- reluctance to move
- swollen joints
- sudden onset of mild to severe abnormal gait (affecting one or more limbs)
- weight loss and/or dehydration.
If acute lameness is secondary to a systemic condition, signs that may be evident include (but are not limited to):
- diarrhoea
- drooling
- generalised lesions present elsewhere on the body
- pyrexia
- systemic bacterial infections including acidosis, mastitis and metritis.
Potential causes
Acute lameness is associated with a range of infectious (both endemic and exotic) and non-infectious conditions. The systems most often associated with acute lameness are the musculoskeletal and nervous systems. In addition to acute lameness, consider other clinical signs when determining a differential diagnosis list.
Exotic diseases that may cause lameness in pigs and/or ruminants are:
- bluetongue disease (affects cattle, deer, goats and sheep)
- foot-and-mouth disease (affects cattle, goats, pigs and sheep)
- goat pox (affects goats)
- lumpy skin disease ( affects cattle)
- Senecavirus A (Seneca Valley virus) infection (affects pigs
- sheep pox (affects sheep)
- swine vesicular disease (affects pigs)
- vesicular exanthema of swine (not seen since 1956) (affects pigs)
- vesicular stomatitis (affects cattle and pigs).
Endemic diseases that may cause lameness in pigs and/or ruminants include but are not limited to:
- bacterial infections causing acute arthritis, such as Erysipelothrix rhusiopathiae, Haemophilus parasuis, Streptococcus spp, Actinobacillus suis, Mycoplasma hyosynoviae, Mycoplasma hyorhinis, Arcanobacterium pyogenes, Chlamydia psittaci, Streptococcus suis (affects pigs)
- botulism (affects cattle, goats, pigs and sheep)
- bovine cysticercosis (beef measles) (affects cattle)
- bovine ephemeral fever(affects cattle)
- bovine papular stomatitis(affects cattle)
- Brucella suis (affects pigs)
- caprine arthritis encephalitis (affects goats)
- clostridial myositis/blackleg (Clostridium chauvoei) (affects cattle and sheep)
- contagious pustular dermatitis (orf) (affects sheep)
- digital dermatitis (affects cattle and sheep)
- flavivirus infection (affects cattle, goats, pigs and sheep)
- footrot (affects cattle and sheep)
- Glässers disease (Haemophilus parasuis) (affects pigs)
- malignant catarrhal fever (affects cattle)
- osteomyelitis (affects cattle, goats, pigs and sheep)
- tetanus (affects cattle, goats, pigs and sheep).
Non-infectious causes of lameness in pigs and/or ruminants include:
- bad/hard floors (affects cattle, goats, pigs and sheep)
- degenerative causes—degenerative joint disease, arthritis, osteochondrosis, cervical spondylopathy (affects cattle, goats, pigs and sheep)
- inflammatory causes—laminitis, septic arthritis (affects cattle, goats, pigs and sheep)
- nutritional causes—white muscle disease (selenium deficiency), acidosis (laminitis), vitamin and mineral excesses and deficiencies leading to metabolic bone disease which predisposes fractures (osteomalacia, osteoporosis). Deficiency in vitamin D, biotin, manganese or zinc, as well as mineral excesses, may all lead to metabolic bone disease (affects cattle, goats, pigs and sheep)
- overgrown claws (affects cattle, goats, pigs and sheep)
- traumatic causes—hoof lesions (such as cracks, erosions, ulcers, abscesses), fractures, luxations and subluxations, nerve damage due to trauma or toxicity, soft tissue injuries (affects cattle, goats, pigs and sheep).
Some of the differential diagnoses may be eliminated by taking a good history (e.g. possible trauma, nutrition) and by undertaking a thorough clinical examination. Information about the clinical picture in the herd (i.e. single or multiple animals affected) is also important.
Reporting requirements
If you suspect an emergency animal disease, report it immediately. Call the Emergency Animal Disease Hotline on 1800 675 888, wherever you are in Australia. Alternatively, contact a government veterinarian in your state or territory.
Government duty veterinarians monitor the hotline and are available to advise you 24 hours a day, 7 days a week.
Bluetongue, malignant catarrhal fever, Brucella suis, virulent footrot and the vesicular diseases are all notifiable diseases in Australia.
If you suspect the presence of any of these diseases in any livestock you are required to report it to your relevant state department. Virulent footrot must be reported within 48 hours.
Investigation and sampling guidelines
Undertake a thorough physical examination of sick animals, including taking rectal temperatures, as many conditions present as acute lameness. Speaking to the farmer and people who have cared for the animals will help establish the history for these cases. Conduct a post-mortem on any dead animals (but note that lameness does not typically cause death).
Some differential diagnoses may be zoonotic and have public health implications. Take extra precautions investigating such diseases, including using appropriate personal protective equipment, to prevent infecting personnel by ingesting, inhaling infected aerosols, or contaminating mucous membranes or abraded skin.
Samples required
You will only need samples from animals with acute lameness if you suspect infectious, inflammatory or nutritional causes. Physical examination alone will generally diagnose traumatic causes (such as a fracture or sole abscess). Sample collection depends on the clinical signs present and your physical examination findings.
Take samples from several affected animals in the herd, flock or group. Aim for blood samples from at least 10 animals and other samples from at least five animals.
Sample collection
Carefully aspirate the vesicular fluid from unruptured vesicles by syringe and needle, and place in a sterile container. Alternatively, collect fluid from small vesicles on a swab and place the swab in 500 μl of buffer, such as phosphate buffered saline or virus transport medium.
Submit epithelium, epithelial tags, oral, nasal and tonsillar swabs, and oropharyngeal fluid in phosphate buffered saline or virus transport medium, if available. Table 2.6.1 details the samples to collect for acute lameness in pigs and ruminants.
| Additional clinical signs | Sample | Collection container |
|---|---|---|
| Vesicles | Vesicle fluid, vesicle epithelium, nasal and oral swabs, oropharyngeal fluid collected with a probang or tonsillar swab blood for serology | Sterile tube (with viral transport medium or phosphate buffered saline if available) plain tube |
| Pyrexia, acidosis, mastitis, metritis, generalised lesions, drooling, diarrhoea | Blood for serology whole blood | Plain tube EDTA tube |
| Lesions (non-vesicular) | Tissue material/epithelium | Swab or scrape using scalpel if infectious aetiology is included in the differential diagnosis, use viral transport media |
| Joint effusion, localised swelling, or effusion | Fluid aspirate from affected joint or area paired serology | Sterile container plain tube |
| Interdigital dermatitis | Epithelium from affected skin or advancing underrun lesions | 2–3 mm, modified Stuart transport medium |
Transport of samples
For transport:
- chill blood samples and unpreserved tissue samples at either 4 °C, or with frozen gel packs
- DO NOT FREEZE SAMPLES at -20 °C; it reduces the sensitivity when used for virus isolation and molecular diagnostic tests
- send samples with dry ice if the journey is expected to take several days
- formalin fixed tissue can be sent at room temperature.
Sample submission
The relevant state or territory laboratory should coordinate sample packaging and consignment for delivery to the Australian Centre for Disease Preparedness.
2.7 Reproductive problems in pigs
Viral infections are the most common infectious cause of reproductive problems in pigs. Porcine reproductive and respiratory syndrome currently accounts for nearly 60 per cent of infectious abortions in the United States. Infection of the foetus is common, although maternal illness can be a primary or contributing cause of abortion with a number of viruses.
Clinical signs
Reproductive problems in pigs can present in many different ways, but can include:
- abortions
- congenital abnormalities
- embryonic death
- embryonic death and resorption
- foetal malformations
- foetal mummification
- increased neonatal mortality
- poor conception rates
- small litters and decreased litter size
- stillbirths
- weak pigs.
Potential causes
Exotic diseases that may cause reproductive problems in pigs include:
- Aujeszky’s disease
- classical swine fever (hog cholera)
- influenza A viruses in pigs (exotic strains)
- Japanese encephalitis
- Nipah virus infection
- porcine reproductive and respiratory syndrome.
Endemic diseases that may cause reproductive problems in pigs include:
- bovine viral diarrhoea (BVD) or border disease
- Brucella suis
- chlamydiosis
- encephalomyocarditis virus infection
- influenza A viruses in pigs (human-origin strains, subtypes H1N1, H1N2 and H3N2)
- Menangle virus infection
- porcine parvovirus infection
- porcine cytomegalovirus infection
- porcine rubulavirus (blue-eye disease)
- Teschen/Talfan disease.
Non-infectious causes of reproductive problems in pigs include:
- carbon monoxide poisoning
- poor management
- poor nutrition
- zearalenone poisoning.
Reporting requirements
If you suspect an emergency animal disease, report it immediately. Call the Emergency Animal Disease Hotline on 1800 675 888, wherever you are in Australia. Alternatively, contact a government veterinarian in your state or territory.
Government duty veterinarians monitor the hotline and are available to advise you 24 hours a day, 7 days a week.
Investigation and sampling guidelines
Conduct a thorough physical examination of sick animals (including taking rectal temperatures). Speak to the farmer and people who have cared for the animals to establish the history for these cases. Consider conducting post-mortems on any available dead animals.
Some differential diagnoses may be zoonotic and have serious public health implications. Take extra precautions investigating such diseases, including using appropriate personal protective equipment, to prevent infecting personnel by ingesting, inhaling infected aerosols, or contaminating mucous membranes or abraded skin.
Samples required
Since most infectious abortions are the result of foetal infections that occur more than 14 days after the sow became infected, sows may have antibodies at the time of the abortion. However, seroconversion in a sow aborting due to acute illness will not yet have occurred at the time of abortion.
Collect samples from several pigs (at least 10 animals for blood samples and at least five animals for other samples). Investigating and sampling a range of animals, including clinically healthy animals, can assist to identify new cases and determine the level of morbidity in the herd.
Sample collection
Table 2.7.1 details the sample collection required for pigs with reproductive problems.
| Collection container | Collect from live pigs | Collect from dead pigs |
|---|---|---|
| EDTA tube | Blood | Blood (if possible to collect from recently dead animals) |
| Plain tube | Blood for serology | – |
| Swabs in virus transport media | Nasal and oral cavity, tonsils | Nasal and oral cavity, tonsils, trachea |
| Sterile swabs for bacterial culture | – | Abdominal cavity, uterus peritoneal fluid |
| Sterile collection container (no media) | – | Foetus, tonsil, spleen, lymph nodes, lung, brain, kidney, ileum |
| 10% neutral buffered formalin | – | Tonsil, spleen, lymph nodes, lung, brain, kidney, ileum |
Transport of samples
For transport:
- chill blood samples and unpreserved tissue samples at either 4 °C, or with frozen gel packs
- DO NOT FREEZE SAMPLES at -20 °C; it reduces the sensitivity when used for virus isolation and molecular diagnostic tests
- send samples with dry ice if the journey is expected to take several days
- formalin fixed tissue can be sent at room temperature.
Sample submission
The relevant state or territory laboratory should coordinate sample packaging and consignment for delivery to the Australian Centre for Disease Preparedness.
2.8 Increased mortality in poultry
Increased mortality in poultry may arise from a wide range of infectious and non-infectious causes. Some infectious causes of increased mortality are exotic to Australia and must be ruled out during disease investigations. In this chapter, poultry refers to chickens, ducks and turkeys.
Clinical signs
An increased mortality rate may be the only indication of an infectious disease in a flock. Any increase in mortalities above the threshold mortality rate for the production system should be investigated. The mortality threshold will vary based on species, flock age and enterprise (e.g. cage versus non-cage).
Mortality in poultry may also be associated with sub-optimal husbandry and welfare and can have multifactorial causes. Failures in control systems, equipment or operational procedures can expose birds to unfavourable environmental conditions, causing an increased mortality rate.
Clinical signs prior to death vary based on the aetiological cause, the species and the age of the flock, and may be non-specific. Ante-mortem examination, post-mortem evaluation, environmental assessment and diagnostic testing are crucial when investigating increased mortality in poultry.
Ante-mortem clinical signs in the poultry can include:
- mortality rates above the mortality threshold for the production system, with timeframes ranging from sudden to slow onset depending on the cause
- depression
- inappetence
- decreased water intake
- ruffled feathers
- diarrhoea
- respiratory signs
- reduced egg production (for layer species).
The epidemiological picture may also help to determine whether an exotic disease is involved in increased mortality. For example, a disease that spreads rapidly through the flock with a high mortality rate increases the index of suspicion for an exotic disease outbreak.
Potential causes
Exotic diseases that may cause increased mortality in poultry include:
- avian influenza
- duck viral enteritis (anatid herpesvirus-1)
- duck virus hepatitis
- infectious bursal disease (very virulent and exotic antigenic variant forms)
- fowl typhoid (Salmonella Gallinarum)
- Newcastle disease (virulent)
- pullorum disease (Salmonella Pullorum)1
- turkey rhinotracheitis (avian metapneumovirus).
Endemic diseases that may cause increased mortality in poultry include:
- chicken anaemia virus
- coccidiosis (Eimeria spp.)
- colibacillosis (Escherichia coli)
- endoparasites
- erysipelas (Erysipelothrix rhusiopathiae)
- fowl cholera
- haemorrhagic enteritis in turkeys
- hepatitis hydropericardium (fowl adenovirus)
- inclusion body hepatitis (fowl adenovirus)
- infectious bronchitis virus (IB)
- infectious coryza
- infectious laryngotracheitis (ILT)
- Marek’s disease
- mycoplasmosis
- necrotic enteritis
- intestinal parasitism
- poult enteritis and mortality syndrome (PEMS) in turkeys
- psittacosis (Chlamydia psittaci)
- systemic staphylococcal infection.
Non-infectious causes of increased mortality in poultry include:
- ascites (water belly, pulmonary hypertension)
- behavioural problems—feather pecking, cannibalism
- genetic strains selected for faster growth rate
- heat stress
- management/ infrastructure failure
- power, temperature control or ventilation failure
- water and feed quality and access
- inadequate housing
- inadequate preparation for photo-stimulation
- nutritional deficiencies and metabolic disorders
- sudden death syndrome (SDS)
- malabsorption syndrome
- predation
- toxicities
- heavy metals
- rodenticides
- botulism
- mycotoxins.
1Last reported in 1992; Salmonella Pullorum is not present in commercial chicken flocks (Animal Health Australia 2024).
Reporting requirements
If you suspect an emergency animal disease, report it immediately by phoning the Emergency Animal Disease Hotline on 1800 675 888 anywhere in Australia. Alternatively, contact a government veterinarian in your state or territory.
Investigation and sampling guidelines
Prior to entering the flock housing, speak to the manager and staff to establish a history and timeline of cases. At this time, information about housing environment, stocking densities, production flow, any management/infrastructure failures and other management details can be collected to help narrow down the investigation.
Observe all flocks on site, starting with any groups that appear healthy and moving on to cohorts with suspect cases. Flocks exhibiting reduced activity, inappetence and reduced productivity are causes for concern.
In the affected flocks, target individual birds for clinical examination if they are displaying clinical signs such as depression, swellings, haemorrhages on skin and mucosae, abnormal respiration, nasal exudates, diarrhoea or ruffled feathers. At this time, samples can be taken from live birds (Table 2.8.1).
Euthanise a sample of sick birds for post-mortem examination, prioritising moribund animals, and conduct a thorough post-mortem examination to narrow the diagnostic pathway and collect appropriate samples for diagnostic testing (Table 2.8.1).
Some differential diagnoses may be zoonotic and have serious public health implications. Take extra precautions when investigating increased mortality, including using appropriate personal protective equipment and reducing exposure of non-essential personnel during the investigation. Possible transmission routes include ingestion, inhalation of infected aerosols and direct contact via mucous membranes or broken skin.
If you suspect a zoonotic disease, refer to the relevant chapter in this field guide for information on public health risks, biocontainment and personal protective equipment.
Samples required
For disease diagnosis in chickens, turkeys and ducks, the number of samples from clinically affected birds will depend on the disease presentation, differential diagnoses, disease prevalence and the number of birds available for post-mortem sampling. In acute disease outbreaks, between 10–30 clinically affected animals should be targeted for sampling in large flocks.
Target birds for sample collection should include:
- live, clinically affected birds
- birds that have been euthanised for postmortem examination
- recently deceased, non-decomposed birds.
Sample collection
Table 2.8.1 details the sample collection required for increased mortality in poultry.
| Collection container | Collect from live birds | Collect from dead birds (euthanised and naturally deceased) |
|---|---|---|
| EDTA tube | blood | – |
| Plain tube | blood for serology (2 ml per bird if possible) | – |
| Swabs in viral transport medium (VTM)* | cloacal; choanal/tracheal | cloacal; choanal/tracheal |
| Swabs in Amies transport medium* | gross lesions (if present) | gross lesions (if present) |
| Sterile tube | faeces (fresh) | gut content (faeces or cloacal/colon) |
| Sterile collection container (no media) | – | brain, proventriculus, pancreas, intestine, liver, caecal tonsil, trachea, lungs, cloaca, bursa, spleen, kidney and any gross lesions (also collect feed and water samples) |
| 10% neutral buffered formalin | – | brain, proventriculus, pancreas, intestine, liver, caecal tonsil, trachea, lungs, cloaca, bursa, spleen, kidney and any gross lesions |
*Swabs can be placed into sterile saline if transport media is unavailable
Transport of samples
For transport:
- place swab samples in both Amies transport media and VTM (containing antibiotics and antifungals), or sterile saline if unavailable
- chill blood samples and unpreserved tissue samples at 4°C or with frozen gel packs
- DO NOT FREEZE SAMPLES at −20°C; it reduces the sensitivity when used for virus isolation and virus molecular diagnostic tests
- send samples with dry ice if the journey is expected to take several days
- formalin-fixed tissue can be sent at room temperature.
Sample submission
The relevant state or territory laboratory should coordinate sample packaging and consignment for delivery to the Australian Centre for Disease Preparedness.
3. Emergency animal diseases
3.1 African horse sickness
Fast facts
African horse sickness (AHS) is an exotic arthropod-borne viral disease of Equidae transmitted by certain species of Culicoides.
Organism
AHS virus (AHSV):
- has nine different serotypes
- multiplies in regional lymph nodes and is followed by primary viraemia, with subsequent dissemination to target organs.
Susceptible species
AHS affects:
- all species of Equidae (although not all show clinical signs)
- dogs and camels (dead-end hosts).
Economic impact
There is potential for significant economic loss associated with high mortality in horses, as well as restrictions on animal movements and international trade.
Epidemiology
AHS:
- distribution is determined by the presence of competent vectors
- morbidity depends on species, previous immunity and the form of disease
- can cause mortalities, with horses particularly susceptible (up to 95 per cent).
Transmission
Transmission occurs primarily through Culicoides vectors.
Clinical signs
The disease may present as a peracute (pulmonary) form, subacute oedematous (cardiac) form, and acute mixed form or as horse sickness fever. Clinical signs may include:
- pyrexia
- laboured breathing and coughing
- pulmonary oedema
- oedema of the head, conjunctiva, neck, brisket, ventral thorax and abdomen
- death (which is common and can occur suddenly).
Post-mortem
Gross lesions vary depending on the form of the disease, and lesions are not pathognomonic. These may be found:
- subpleural and interlobular oedema
- subcutaneous and intermuscular connective tissue oedema.
Samples
Collect:
- blood samples (EDTA and plain tubes)
- lymph nodes (especially mesenteric and bronchial), lungs, spleen from dead horses.
Actions to take
If you suspect a case of AHS:
- call the Emergency Animal Disease Hotline on 1800 675 888 immediately or contact a government veterinarian in your state or territory
- isolate suspected cases and implement biocontainment protocols (including movement controls and protection of animals from vectors) until advised by government veterinary authorities.
Introduction
African horse sickness (AHS) is an arthropod-borne infectious (but non-contagious) viral disease affecting all species of Equidae.
Disease agent and susceptible species
African horse sickness virus (AHSV):
- is a double-stranded RNA virus belonging to the genus Orbivirus and family Reoviridae
- has nine different serotypes and some serotypes are cross protective
- mainly affects equids, with horses, mules, donkeys and zebras the primary hosts
- causes the most serious infections in horses (mortality up to 95 per cent)
- is also known to affect dogs, usually (but not exclusively) following ingestion of virus-infected meat. However, dogs are considered dead-end hosts
- is thought to be maintained in the environment in most regions of Africa by zebras which are often subclinically infected natural reservoir hosts
- antibodies have been reported in camels and African elephants but these species are not considered significant in the epidemiology.
Distribution
AHS:
- geographical distribution and seasonal occurrence are dependent on competent vectors,
- and studying the dynamics and behaviour of Culicoides spp. is therefore essential to understanding the disease
- appears to be seasonal in endemic areas, where it is preceded by seasons of heavy rain alternating with hot and dry climatic conditions
- occurs in eastern and southern Africa (all serotypes of AHSV)
- virus serotypes 2, 4 and 9 have been found in North and West Africa, from where they occasionally spread into countries surrounding the Mediterranean.
For the latest information on the distribution of AHS, refer to the WAHIS information database website of the World Organisation for Animal Health (WOAH).
Occurrences in Australia
None reported.
Epidemiology
Modes of transmission
AHS is not contagious and does not spread by direct contact between horses.
Transmission occurs via:
- vectors, during blood-feeding by Culicoides species—Culicoides imicola is the principal vector in Africa but is not present in Australia. However, other Australian Culicoides species could be involved. The virus has also been isolated from Rhipicephalus sanguineus (a dog tick) and Hyalomma dromedarii (a camel tick) and has been experimentally transmitted by mosquitoes, including Aedes aegypti and Culex pyriens, both of which are present in Australia.
- wind, which was implicated in the dispersal of infected Culicoides in some epidemics
- mechanical transmission by other biting flies, but these are unlikely to play a significant role
- parenteral injection of infectious blood.
Disease dynamics
Following ingestion by a competent female Culicoides vector, the virus replicates in the insect gut then translocates and replicates in the salivary glands before infection of the next mammalian host. Following infection of a mammalian host:
- multiplication of AHSV occurs in regional lymph node and is followed by primary viraemia, with subsequent dissemination to endothelial cells of target organs
- the incubation period lasts 2–10 days, depending on viral load, viral virulence and host factors
- the viraemic phase typically lasts only 2–8 days (for horses) but reservoir mammalian host species (such as zebra) have a longer infectious period
- lifelong immunity following recovery is rare as different serotypes are not necessarily cross-protective
- animals that survive infection do not become carriers of the virus
- morbidity and mortality can be as low as 30 per cent and 10 per cent respectively in endemic areas
- high morbidity and high case mortality (of up to 100 per cent) may occur in naïve horses.
Persistence of the agent
AHSV:
- is inactivated in the laboratory with formalin, Virkon® S or radiation
- is destroyed at a pH less than 6, or pH 12 or greater. Acidic disinfectants such as acetic or citric acid have been recommended for decontamination when warranted. Alkaline disinfectants such as sodium hypochlorite are also recommended
- can survive in frozen meat, but is inactivated at temperatures greater than 60 °C
- is rapidly destroyed in carcasses that have undergone rigor mortis due to pH fluctuations.
Diagnosis and pathology
Clinical signs
The disease may present as a peracute (pulmonary) form, subacute oedematous (cardiac) form, an acute mixed form, or as horse sickness fever.
Signs of the peracute pulmonary form (‘Dunkop’) include:
- acute pyrexia, followed within a day or two by the sudden onset of severe respiratory distress
- short incubation period, usually 3–4 days
- tachypnoea, forced expiration, profuse sweating, spasmodic coughing and a frothy serofibrinous nasal exudate
- forelegs spread apart stance, extended head and dilated nostrils dyspnoea, which usually progresses rapidly and causes death within a few hours after respiratory signs appear
- pyrexia which subsides gradually while the breathing remains laboured for several days (in recovering animals).
Signs of the subacute oedematous cardiac form (‘Dikkop’) include:
- a more protracted and milder incubation than the pulmonary form
- pyrexia lasting less than a week
- oedematous swellings appear in the supraorbital fossae and eyelids, spreading to involve the face, tongue, intermandibular space, laryngeal region, and sometimes the neck, shoulders and chest
- absence of oedema of the ventral side and lower legs
- severe depression, colic, petechiae or ecchymoses on the ventral surface of the tongue, and petechiae in the conjunctivae (all are usually seen in the terminal stages of the disease)
- death from cardiac failure (which often occurs within 1 week of the onset of pyrexic reaction).
The acute mixed form is most commonly seen in outbreak cases, where the disease may cause mortality of up to 80 per cent. Signs include:
- a mix of clinical signs from the pulmonary and cardiac forms of the disease
- pyrexia
- mild pulmonary or subclinical cardiac disease followed by oedema, cardiac failure or respiratory failure
- death, usually occurring 3–6 days after the onset of pyrexic reaction.
A combination of pathologies (often not clinically apparent) are usually found at post-mortem.
Horse sickness fever is:
- the mildest form of the disease
- frequently not clinically diagnosed as mild pyrexia in animals may be subclinical
- usually observed in donkeys, reservoir species (zebras) and partially immune horses infected with heterologous serotypes of the virus.
Pathology
Gross lesions are quite variable and depend on the form of the disease. In the respiratory forms of the disease, the followintg may be found:
- interlobular oedema of the lungs
- hydropericardium, pleural effusion
- oedema of the thoracic lymph nodes
- petechial haemorrhages of the pericardium.
In the cardiac forms of the disease, the following may be found:
- subcutaneous and intramuscular gelatinous oedema
- epicardial and endocardial ecchymosis, myocarditis
- haemorrhagic gastritis.
Differential diagnosis
Consider in the differential diagnosis:
- exotic diseases
- dourine
- equine encephalosis
- equine piroplasmosis
- equine viral arteritis (avirulent strains of the virus circulate in Australia)
- Nipah virus infection
- surra.
- endemic diseases
- anthrax
- equine infectious anaemia
- Hendra virus infection
- purpura haemorrhagica (a complication of strangles).
- non-infectious causes
- acute poisoning (plant or chemical)
- heat stress.
Samples required
Sample collection
Collect these samples from clinically affected animals:
- serum, preferably paired sera
- EDTA blood from live animals (at least 10 if possible), preferably at early pyrexic stages (7–10 ml per animal)
- fresh tissue from lymph nodes (especially the mesenteric and bronchial nodes), lungs, spleen.
Transport of samples
For transport:
- chill blood samples and unpreserved tissue samples either at 4 °C, or with frozen gel packs
- DO NOT FREEZE SAMPLES at -20 °C; it reduces the sensitivity when used for virus isolation and molecular diagnostic tests
- send samples with dry ice if the journey is expected to take several days.
Sample submission
The relevant state or territory laboratory should coordinate sample packaging and consignment for delivery to the Australian Centre for Disease Preparedness.
Diagnostic tests
For AHS diagnosis:
- serological tests available include complement fixation test (CFT), competitive blocking ELISA (which is serogroup specific based on VP7) and viral neutralisation
- nucleic acid detection includes real-time reverse transcription polymerase chain reaction (real-time RT-PCR)
- viral isolates can be detected in blood during the early pyrexic stage.
Reporting requirements
AHS is an WOAH-listed disease and Australia has an international obligation to report cases.
If you suspect AHS, report it immediately. Call the Emergency Animal Disease Hotline on 1800 675 888, wherever you are in Australia. Alternatively, contact a government veterinarian in your state or territory.
Government duty veterinarians monitor the hotline and are available to advise you 24 hours a day, 7 days a week.
Biocontainment and personal protective equipment
There are no public health implications for AHS, but you should implement biocontainment protocols until advised by government veterinary authorities. This includes isolating suspected cases (and protecting from vectors, if possible) and using and appropriately disposing of personal protective equipment such as gloves, coveralls and rubber boots (or disposable boots). You need to thoroughly disinfect and decontaminate clothing, vehicle and equipment before leaving the property.


Further information
Carpenter S., Mellor PS., Fall AG., Garros C., Venter GJ. (2017) African Horse Sickness Virus: History, Transmission, and Current Status. Annu Rev Entomol. 62:343-58.
Center for Food Security & Public Health (2015). African Horse Sickness. Iowa: Iowa State University.
Robin M., Page P., Archer D., Baylis M. (2016) African horse sickness: The potential for an outbreak in disease-free regions and current disease control and elimination techniques. Equine Vet J. 48(5):659-69.
Scacchia M, Molini U, Marruchella G, Maseke A, Bortone G, Cosseddu GM, Monacoo F, Savini G, Pini A. (2015) African horse sickness outbreaks in Namibia from 2006 to 2013: clinical, pathological and molecular findings. Veterinaria Italiana. 51(2):123-30.
3.2 African swine fever
Fast facts
African swine fever (ASF) is an exotic highly contagious viral disease of swine clinically indistinguishable from classical swine fever.
Organism
ASF virus:
- replicates in Ornithodoros ticks
- is found in all tissues and body fluids
- can survive >30 days in pig pens and >140 days in some pork products
- strains vary greatly in virulence.
Susceptible species
Only pigs and other suid species are susceptible.
Economic impact
There is potential for significant economic loss associated with high mortality and morbidity in pigs, as well as restrictions on animal movements and international trade.
Epidemiology
ASF:
- may cause morbidity approaching 100 per cent in naïve herds
- mortality varies with strain virulence and ranges from 0–100 per cent
- may be asymptomatic in wild pigs
- incubation usually lasts 4–20 days.
Transmission
Transmission occurs via:
- direct contact, usually oronasal
- ingestion of contaminated swill
- contact with infected carcasses
- indirectly by breeding and fomites
- insect vectors including Orthinodoros ticks (biological) and stable flies (mechanical).
Clinical signs
ASF clinical signs:
- vary according to the disease form (peracute, acute, subacute or chronic) as influenced by the virus strain, route and dose of infection
- include marked pyrexia, reduced food intake, erythema, cyanosis, recumbency, diarrhoea, abortion and death
- in the chronic form, include transient recurring pyrexia, stunting, emaciation, multi-focal erythema, raised or necrotic areas, coughing and painless joint swelling.
Post-mortem
The most common lesions are:
- haemorrhagic spleen (enlarged, friable, dark red or black)
- haemorrhagic lymph nodes, kidney and heart
- focal skin necrosis
- fibrinous pericarditis
- generalised lymphadenopathy
- swollen joints
- consolidated lobules in lung.
Samples
Also refer to the detailed section on sampling for sudden death in pigs.
Collect:
- blood (EDTA and plain tubes) from living animals
- fresh tissue from spleen, lymph nodes, kidney, lung and ileum on post-mortem.
Actions to take
If you suspect a case of ASF:
- call the Emergency Animal Disease Hotline on 1800 675 888 immediately or contact a government veterinarian in your state or territory
- isolate suspected cases and implement biocontainment protocols (including farm movement controls) until advised by government veterinary authorities.
Introduction
African swine fever (ASF) is a highly contagious disease of pigs. It is clinically indistinguishable from classical swine fever (CSF), and similar lesions seen at post-mortem examination. ASF and CSF can only be distinguished by laboratory testing.
Disease agent and susceptible species
ASF virus:
- is an enveloped DNA virus, genus Asfivirus, family Asfarviridae
- replicates in Ornithodoros ticks
- is found in all tissues and body fluids
- is highly resistant to inactivation
- strains vary greatly in their virulence. Domestic and feral pigs (Sus scrofa) are the only susceptible mammalian species in Australia outside zoos. European wild boar are also susceptible to ASF and present similar clinical signs and disease dynamics to domestic pigs. In Africa, the warthog, giant forest hog, and bushpigs serve as wild suid reservoirs, and have an inapparent infection.
Distribution
ASF:
- is present in most of sub-Saharan Africa
- was first detected outside Africa in 1957 in Portugal, and then in Belgium, Brazil, Cuba, the Dominican Republic, France, Haiti, Italy, Malta, the Netherlands, Portugal and Spain from the 60s to 90s. The disease has since been eradicated from most of these countries, but is endemic in feral pigs in Sardinia, Italy
- outbreaks have been reported since June 2007 in many countries—most notably in a number of countries in central Europe where the disease had not previously been reported, including Georgia and Russia
- A major outbreak of ASF occurred in China in 2018 and subsequently spread throughout South-East Asia.
For the latest information on the distribution of ASF, refer to the WAHIS information database website of the World Organisation for Animal Health (WOAH).
Occurrences in Australia
None reported.
Epidemiology
Modes of transmission
Transmission occurs via:
- contact with infected carcasses—the carcasses of pigs that die during acute ASF contain more virus than carcasses of chronic carriers of ASF and are therefore more infective to other pigs. Carcasses of chronic carriers have also been linked to the spread of ASF
- direct contact with infected pigs—the virus is shed in high concentrations in all secretions and excretions that contain blood. Oral and respiratory infection can also occur between pigs in close contact. Moving infected pigs is the most important way to spread disease between piggeries. Feral pigs could become an important reservoir of the virus in Australia
- vectors—soft ticks belonging to the Ornithodorus spp. are important vectors of ASFV in parts of Africa. ASFV replicates in Ornithodoros ticks and infection can persist over long periods, allowing the virus to be transmitted during blood meals. Other haematophagous insects such as stable flies (Stomoxys calcitrans) feeding on viraemic pigs have been experimentally implicated in the mechanical spread of ASF. Two native species of Ornithodoros ticks are found in Australia—Ornithodoros capensis (penguin tick) and Ornithodoros gurneyi (inornate kangaroo tick). Although O. capensis only parasitises sea birds, O. gurneyi may feed on dogs, cattle, humans, horses, mice, rats, rabbits and kangaroos (its natural host)
- contact with infected faeces and urine
- semen and embryos—the virus is present in semen and artificial insemination can transmit the virus. The International Embryo Transfer Society has indicated that there is not enough information to reach a conclusion regarding the transmission risk of ASF virus via embryos, but you should assume transmission via embryo transfer until proven otherwise
- ingesting contaminated swill—ASF virus has the ability to survive for many months in raw, unprocessed, frozen meat as well as meat stored at fridge temperatures and in some processed hams. Ingesting pig meat or products infected with the virus is an important means of spread, and is commonly the way it is introduced into a country. Australia has strict import conditions to address the risk of an ASF incursion and swill feeding is illegal
- fomites—because of the stability of ASF virus in the environment, indirect contact by means of contaminated pig pens, vehicles and other fomites (such as hypodermic needles) is a very important means of spread of the disease
- airborne spread—ASF virus is not transmitted in the air from one piggery to another, but it does spread via aerosols within a piggery. Respiratory infection can occur between pigs in close contact.
Disease dynamics
- following infection via the upper respiratory tract, the virus replicates in the tonsils and lymph nodes draining the head and neck, followed by generalised infection via the blood stream
- incubation period is usually between 4–20 days
- clinical disease may be peracute, acute, subacute or chronic
- in the acute form, has a duration of 1–19 days and case mortality rate of up to 100 per cent
- in the subacute form, persists for longer (3–4 weeks) and the case mortality rate is lower, with deaths more likely in younger pigs
- pigs that survive the acute disease or are infected by mild strains of the virus usually become chronically infected for at least several months. However, such pigs do not readily excrete the virus for more than about 5 or 6 weeks after their initial infection and their role in the spread of the disease after that is unclear.
- it is reported that most recovered pigs are virus carriers for long periods, perhaps for life
- transmission to other pigs through direct contact can occur for up to 1 month after recovery from infection.
Persistence of the agent
ASFV:
- can survive at least 30 days in pens and up to 300 days in some pork products
- is highly resistant to inactivation but can be killed by high temperatures and some disinfectants—potassium peroxymonosulfate, hypochlorites, and phenols and related compounds (cresols).
Diagnosis and pathology
Clinical signs
Signs vary according to whether disease is peracute, acute, subacute or chronic.
In the peracute form, pigs are usually found dead with no prior clinical signs and if seen before death have marked pyrexia and are moribund.
In the acute form signs are:
- pyrexia up to 42°C
- hyperaemia or cyanosis of extremities, particularly ears and snout
- loss of appetite or irregular appetite
- inability or unwillingness to stand up
- convulsions
- incoordination or stiff gait
- huddling together or piling one on top of another
- laboured breathing or coughing
- dysentery or diarrhoea (often bloody)
- conjunctivitis
- mucopurulent nasal discharge
- vomiting
- abortion.
In the subacute form clinical signs are:
- as for the acute form but generally milder and persisting longer (3–4 weeks)
- pyrexia, which may fluctuate irregularly and may exceed 40.5°C
- occasionally, a purple colour over the pig’s body
- bleeding from injection sites
- abortion.
In the chronic form (generally seen in pigs surviving the subacute form) signs are:
- recurrent transient pyrexia
- ill-thrift, stunting and emaciation
- pneumonia
- arthritis
- cutaneous ulcers
- poor body condition.
Pathology
In the peracute form pigs may show no gross lesions. In the acute form, findings include:
- enlarged and haemorrhagic lymph nodes, often resembling blood clots
- the gastrohepatic, renal, mesenteric and submandibular lymph nodes are most often affected
- enlarged spleen (2–3 times its normal size), which may be necrotic, dark, friable or pulpy
- haemorrhages in almost any organ which are most commonly seen on serosal membranes and in kidneys (as subcapsular petechiae), heart, urinary bladder, lung and gall bladder
- septal oedema of lungs, resulting in prominent interlobular septa
- fluid in body cavities.
In the subacute form findings are more variable than for the acute form and include:
- lymph node and renal haemorrhage
- enlarged but not congested spleen
- lobular consolidation of cranial lung lobes
- haemorrhage of the intestinal lining, lymph nodes and kidney.
In the chronic form findings include:
- enlarged lymph nodes
- fibrinous pericarditis and pleurisy
- lobular consolidation of lungs, which may progress to lobular necrosis
- small, hard, nodular white masses in lungs
- arthritis
- cutaneous ulcers
- poor body condition
- less commonly seen are haemorrhages in additional organs (petechiae, ecchymoses) and oedema in the lungs and gall bladder.
Differential diagnosis
Many other viral and bacterial pathogens of pigs that are often confused with ASF may cause concurrent infections. It is important to take into consideration that isolation of other pathogens does not exclude an underlying ASF virus infection. Consider in the differential diagnosis:
- exotic diseases
- Aujeszky’s disease (respiratory signs)
- classical swine fever (do not attempt clinical differentiation of classical swine fever and ASF)
- porcine deltacoronavirus
- porcine respiratory disease complex
- porcine reproductive and respiratory syndrome
- post-weaning multi-systemic wasting syndrome
- swine enteric coronavirus diseases such as those caused by porcine epidemic diarrhoea virus
- transmissible gastroenteritis.
- endemic diseases
- acute salmonellosis (diarrhoea)
- acute septicaemia due to Streptococcus suis or Haemophilus parasuis (Glässer’s disease)
- infection with other pestiviruses such as border disease virus and bovine viral diarrhoea virus (mucosal disease)
- pasteurellosis (pneumonia)
- porcine circovirus 2-associated diseases such as those seen in porcine dermatitis and nephropathy syndrome
- erysipelas (haemorrhagic skin lesions).
- non-infectious causes
- heavy metal poisoning
- salt poisoning with water deprivation
- thrombocytopaenia purpura (haemorrhages, especially in pigs 2–3 weeks old)
- warfarin poisoning (causing death with haemorrhages, generally sporadic)
- any cause of chronic ill-thrift in pigs.
Samples required
Submit several pigs (at least five if possible) for post-mortem examination, as individual animals may present with great variability in lesions. Record a composite picture of all lesions seen.
Sample collection
Collect samples from affected, especially pyrexic, pigs killed immediately before a post-mortem examination and from pigs that have recently died (including stillborn piglets and aborted foetuses). Collect:
- serum, 30 samples from suspected chronically infected animals
- EDTA blood (7–10 ml/animal) from live, clinically affected animals
- fresh tissue from the spleen, lymph nodes (gastro-hepatic, mesenteric and sub-mandibular) tonsils, lung, kidney and ileum (2 g of each tissue); bone marrow may also be useful from dead wild animals that have been dead for some time, as it is likely to be relatively well preserved
- fixed tissue, a full range of tissues (including the brain) in neutral-buffered formalin.
Transport of samples
For transport:
- chill blood samples and unpreserved tissue samples either at 4 °C, or with frozen gel packs
- DO NOT FREEZE SAMPLES at -20 °C; it reduces the sensitivity when used for virus isolation and molecular diagnostic tests
- send samples with dry ice if the journey is expected to take several days.
- formalin fixed tissue can be sent at room temperature.
Sample submission
The relevant state or territory laboratory should coordinate sample packaging and consignment for delivery to the Australian Centre for Disease Preparedness.
Diagnostic tests
- You must confirm the diagnosis by laboratory testing because there is considerable overlap in the clinical and pathological signs seen in ASF with those of a number of other diseases. For ASF diagnosis:
- the initial approach is screening by real-time PCR (qPCR). An antigen ELISA is also available if required and virus isolation will be attempted. Further characterisation and genotyping by sequence analysis can be carried out on primary samples or on isolates
- serological tests are available but are generally more important in defining the nature and extent of any outbreak, and in the proof-of-freedom phase
- histopathology and immunohistochemical staining are also useful diagnostic tests.
Reporting requirements
ASF is an WOAH-listed disease and Australia has an international obligation to report cases.
If you suspect ASF, report it immediately. Call the Emergency Animal Disease Hotline on 1800 675 888, wherever you are in Australia. Alternatively, contact a government veterinarian in your state or territory.
Government duty veterinarians monitor the hotline and are available to advise you 24 hours a day, 7 days a week.
Biocontainment and personal protective equipment
There are no public health implications for ASF, but you should implement biocontainment protocols until advised by government veterinary authorities. This includes isolating suspected cases and using and appropriately disposing of personal protective equipment such as gloves, coveralls and rubber boots (or disposable boots). You need to thoroughly disinfect and decontaminate clothing, vehicle and equipment before leaving the property.




Further information
Penrith, M.L., Vosloo, W. (2009) Review of African swine fever: transmission, spread and control. J S Afr Vet Assoc. 80(2):58-62.
Penrith, M.L., Vosloo, W., Jori, F., Bastos, A.D. (2013) African swine fever virus eradication in Africa. Virus Res. 173(1):228-46.
Sánchez-Vizcaíno, J.M. (2010). Early detection and contingency plans for African swine fever. 24th Conference of the WOAH Regional Commission for Europe, World Organisation for Animal Health, Astana, Kazakhstan.
3.3 Aujeszky’s disease
Fast facts
Aujeszky’s disease, also called pseudorabies, is an important exotic viral disease of pigs which affects the nervous, respiratory and reproductive systems.
Organism
Aujeszky’s disease is caused by Suid alphaherpesvirus 1. The virus:
- is inactivated by drying, exposure to sunlight and high temperatures
- strain virulence varies from mild to severe.
Susceptible species
Pigs are the only reservoir host but the virus can infect cattle, sheep, cats, dogs, goats and wildlife.
Economic impact
There is potential for significant economic loss associated with production losses, as well as restrictions on animal movement and international trade.
Epidemiology
Aujeszky’s disease is characterised by:
- morbidity varying from 0–100 per cent
- mortality which may approach 100 per cent in newborn pigs, 5–10 per cent in weaners and 1–2 per cent in growers and finishers
- slow spread between farms but rapid within-farm spread
- often mild or inapparent infection in adult pigs
- high mortality in non-porcine species.
Transmission
Aujesky’s disease virus is transmitted by:
- direct contact
- ingestion of milk or meat
- fomites
Clinical signs
Clinical signs are not pathognomonic but Aujeszky’s disease should be suspected in:
- pig herds with high mortality
- young piglets with central nervous system (CNS) signs
- older animals with lower mortality and respiratory signs
- non-porcine species which present with intense pruritis (‘mad itch’) and CNS signs.
Post-mortem
At post-mortem, gross lesions are often minimal or absent.
Samples
Also refer to the detailed section on sampling for neurological diseases in pigs.
Collect:
- unpreserved spleen, tonsils, lymph nodes, distal ileum and brain
- sera from animals (30) suspected of having chronic disease (or of giving birth to piglets with chronic disease)
- a full range of tissues (including brain and spinal cord) in neutral buffered formalin.
Actions to take
If you suspect a case of Aujeszky’s disease:
- call the Emergency Animal Disease Hotline on 1800 675 888 immediately or contact a government veterinarian in your state or territory
- isolate suspected cases and implement biocontainment protocols (including farm movement controls) until advised by government veterinary authorities.
Introduction
Aujeszky’s disease, also called pseudorabies, is an acute, potentially fatal porcine disease which causes significant production losses.
Disease agent and susceptible species
Aujeszky’s disease is caused by:
- an enveloped, double stranded DNA virus called suid alphaherpesvirus 1 (SuHV-1) in the family Herpesviridae
- there is only one serotype but strains vary in virulence (from mild to severe), minimum infective dose and tissue tropism.
Pigs are the only natural host for Aujeszky’s disease virus and the only latent carrier; however:
- the virus can infect nearly all domesticated and wild mammals (including cattle, sheep, cats, dogs and goats) but infections in horses are rare
- other species may be infected when they come in contact with infected pigs, resulting in a fatal central nervous system (CNS) disease
- infection of incidental hosts is often characterised by intense pruritus
- sporadic infection of incidental hosts results in acute neurological disease and death.
Distribution
- occurs in most countries of Europe and Asia
- in parts of the United States (feral pigs only)
- occurs in Central and South America
- was eradicated from the United Kingdom during the 1980s
- New Zealand declared itself free from Aujeszky’s disease in 2000, following an eradication campaign in the 1990s.
For the latest information on the distribution of Aujeszky’s disease, refer to the WAHIS information database website of the World Organisation for Animal Health (WOAH).
Occurrences in Australia
None reported.
Epidemiology
Modes of transmission
Transmission occurs via:
- direct contact with oronasal secretions (between pigs); the virus is spread principally by nose-to-nose contact
- ingestion of contaminated pig meat (including head or offal tissue) by other susceptible carnivores
- transplacental infection, or infective semen or vaginal secretions
- ingestion of infectious colostrum or milk
- ingestion of infectious animal products—Aujeszky’s disease virus can survive in offal (head and neck tissues, and thoracic and abdominal viscera). However, though you can isolate the virus from meat products, it is easily inactivated. Movements of live animals or infected genetic material are generally the way it is introduced to disease-free countries, rather than importing carcass meat (excluding offal and heads)
- fomites—in addition to people, vehicles and equipment, contaminated pig pens, bedding and water can also spread the disease
- airborne spread—under certain favourable conditions in densely populated pig-farming areas, windborne spread of the virus between farms can occur over distances of more than 2 km.
Disease dynamics
The virus is maintained in wild and domestic pigs, in which the virus can establish latent infections like other herpes viruses. In addition:
- in general, pigs excrete virus oronasally during the 2–4 week period following the primary infection
- animals other than pigs are generally regarded as dead‑end hosts, as infection is usually short and self-limiting (most die after an illness of short duration, usually 2–3 days after clinical signs appear)
- the incubation period can be as short as 2–4 days in sucking pigs and 3–6 days in finishers
- virus excretion begins 2–5 days after infection and can continue for at least 14 days (this may precede the onset of clinical signs)
- a very high percentage of recovered pigs become latent carriers for 1 year or longer, with intermittent virus excretion at times when the animal is stressed, such as at parturition.
Persistence of the agent
Aujeszky’s disease virus is a large virus with a lipid envelope which is sensitive to many disinfectants, including detergents. The virus:
- is rapidly inactivated at 37 °C in sunlight and in dry conditions
- has fairly stable infectivity at pH 5–9, but extreme acidity and alkalinity have a rapid inactivating effect
- survives for extended periods under cold conditions (below 4 °C)
- survives in contaminated straw and feeding troughs for 10–30 days at 24 °C or for up to 46 days at 20 °C, and on other fomites for 2–7 days at 25°C
- survives in faeces and urine for up to 3 days
- survives in well water and green pasture for up to 7 days.
Diagnosis and pathology
Clinical signs
The most striking feature of infection in species other than pigs is intense pruritus of a localised area or areas of skin, often leading to self-mutilation. Neurological signs vary and include excitement, salivation, spasms and paralysis. Death usually occurs about 2 days after the onset of signs. Some animals may die suddenly before other clinical signs develop.
In pigs:
- disease affects the nervous, respiratory and reproductive systems
- clinical signs can vary considerably according to the strain, dose of virus and the age of the pig
- neurological signs are more commonly seen in younger animals, whereas respiratory signs are usually observed in older animals
- clinical signs in pigs are highly variable and largely age-dependent
- pigs less than 2 weeks old—prostration is often the only clinical sign but pyrexia, altered appetite, vomiting, depression, central nervous system and respiratory involvement may also be seen. Death occurs within hours of the onset of clinical signs
- weaners—respiratory signs are usually more prominent than neurological signs. These include coughing, sneezing, laboured breathing and conjunctivitis. The case mortality rate is generally 5–10 per cent
- growers/finishers—respiratory disease is most common and may be mild. Morbidity may reach 100 per cent, with mortality in uncomplicated cases low (1–2 per cent)
- adults—infection is usually mild or inapparent, with respiratory signs most common. However, severe outbreaks have been reported with severe respiratory signs, and sporadic cases of neurologic disease.
- pregnant sows—may reabsorb infected foetuses, abort or give birth to weak, trembling neonates. Often retrospective analysis of reproductive parameters may give an indication of the time of infection.
Pathology
In species other than pigs, gross lesions are often minimal and may consistent of spinal cord oedema, congestion and haemorrhage. Gross lesions are often minimal or absent in pigs and, when present, are typically seen in young animals. This may be seen:
- multifocal, pinpoint areas of acute necrosis and haemorrhage in the tonsils, liver, spleen, lung, gastrointestinal tract and adrenal glands
- oedematous and congested lungs
- foetal resorption, mummification, abortion, stillbirths and placental necrosis.
Differential diagnosis
Consider in the differential diagnosis:
- exotic diseases
- African swine fever
- classical swine fever
- haemagglutinating encephalomyelitis virus
- influenza A viruses in pigs (exotic strains)
- porcine reproductive and respiratory syndrome
- post-weaning multi-systemic wasting syndrome
- porcine enterovirus
- rabies
- endemic diseases
- bacterial meningitis (Streptococcus suis, Haemophilus parasuis)
- bacterial pneumonia including Mycoplasma hyopneumoniae
- porcine circovirus 2-associated diseases such as those seen in porcine dermatitis and nephropathy syndrome
- influenza A viruses in pigs (human-origin strains, subtypes H1N1, H1N2 and H3N2)
- non-infectious causes
- congenital defects
- iron toxicity
- middle ear infection
- nutritional deficiencies (e.g. pantothenic acid)
- poisons such as arsenic, mercury, monensin and organophosphorus compounds
- porcine stress syndrome
- splay leg
- water deprivation or salt poisoning.
Samples required
Sample collection
For pigs, collect:
- a full range of tissues (including the brain) in neutral-buffered formalin
- 30 serum samples from suspected chronically infected animals (serum antibodies are detected 7–10 days after infection)
- EDTA blood (7–10 ml/animal) from at least 10 live, clinically affected animals
- sera from sows suspected to have had piglets with chronic disease
- nasal swabs from live clinically affected animals, and place in viral transport medium
- fresh tissue (collected aseptically at post-mortem) including spleen, tonsils, pharyngeal mucosa, lymph nodes and distal ileum (2 g of each tissue). Lung, kidney and liver may be included principally for differential diagnostic workup. One half of the brain should be collected aseptically (the trigeminal nerve ganglia should be included if latent infection is suspected).
For other species, also collect the skin and subcutaneous tissue at the site of the itching.
Transport of samples
For transport:
- chill blood samples and unpreserved tissue samples either at 4 °C, or with frozen gel packs
- place swab samples in virus transport media containing antibiotics and antifungals (or saline if other media is unavailable)
- DO NOT FREEZE SAMPLES at -20 °C; it reduces the sensitivity when used for virus isolation and molecular diagnostic tests
- send samples with dry ice if the journey is expected to take several days
- formalin fixed tissue can be sent at room temperature.
Sample submission
The relevant state or territory laboratory should coordinate sample packaging and consignment for delivery to the Australian Centre for Disease Preparedness.
Diagnostic tests
Since clinical signs are relatively non-specific, a presumptive diagnosis of Aujeszky’s disease may be based initially on histopathology and confirmed by positive serology, or virus or antigen detection in tissue or serum. In addition:
- Aujeszky’s disease can be diagnosed by virus isolation, detection of viral DNA, antigens and serology. ELISAs and virus neutralisation tests are the prescribed tests for international trade
- if vaccination is to be used in any eradication program, certain vaccines permit the serologic discrimination of natural versus vaccine-derived antibody (DIVA)
- serology may not be helpful in species other than pigs as these animals often die before mounting an antibody response.
Reporting requirements
Aujeszky’s disease is an WOAH-listed disease and Australia has an international obligation to report cases.
If you suspect an emergency animal disease, report it immediately. Call the Emergency Animal Disease Hotline on 1800 675 888, wherever you are in Australia. Alternatively, contact a government veterinarian in your state or territory.
Government duty veterinarians monitor the hotline and are available to advise you 24 hours a day, 7 days a week.
Biocontainment and personal protective equipment
There are no public health implications for Aujeszky’s disease, but you should implement biocontainment protocols until advised by government veterinary authorities. This includes isolating suspected cases and using and appropriately disposing of personal protective equipment such as gloves, coveralls and rubber boots (or disposable boots). Thoroughly disinfect and decontaminate clothing, vehicle and equipment before leaving the property.

Further information
Center for Food Security & Public Health (2024). Aujeszky’s Disease. Iowa: Iowa State University.
Maxie MG, Youssef S: Nervous system. In: Jubb, Kennedy, and Palmer’s Pathology of Domestic Animals, ed. Maxie MG, 5th ed., vol. 1, pp.416-417. Elsevier Saunders, Philadelphia, PA, 2007.
3.4 Avian influenza
Fast facts
Avian influenza (AI) is a zoonotic, highly contagious viral disease of birds causing two types of disease—highly pathogenic avian influenza (HPAI) and low pathogenic avian influenza (LPAI).
Organism
AI virus:
- varies in virulence between subtypes and species
- replicates in respiratory and intestinal epithelial cells (LPAI) or replicates in many cell types, including heart and brain (HPAI)
- inactivated by most disinfectants.
Susceptible species
AI affects all bird species, with a spillover infection in mammals, including humans.
Economic impact
There is potential for significant economic loss associated with control and eradication, and restrictions on international trade.
Epidemiology
In infected flocks:
- infection with LPAI viruses is usually subclinical
- mortality can reach 100 per cent in the acute form of HPAI
- the incubation period varies depending on the strain, and can range from hours up to 16 days.
Transmission
Transmission occurs:
- via the faecal oral route from wild waterfowl into commercial poultry
- via aerosol and direct and indirect contact within flocks
- between flocks primarily via contaminated fomites.
Clinical signs
Signs vary with virus virulence, and species, and can include:
- mortality
- subcutaneous oedema and cyanosis of the comb and wattles
- mild respiratory disease
- huddling, decreased feed and water consumption and diarrhoea
- reduced egg production
- waterfowl (including ducks) typically resistant to disease but some HPAI viruses may cause significant mortality.
Post-mortem
This may be found:
- gross lesions of internal organs with multifocal pinpoint haemorrhages, particularly in the trachea, coronary fat, and surfaces of the gastrointestinal tract
- catarrhal air sacculitis and peritonitis, usually associated with secondary infection.
Samples
Collect:
- tracheal and cloacal swabs in virus transport media
- blood samples (EDTA and plain tubes)
- proventriculus, pancreas, intestine, liver, caecal tonsil, trachea, lung and cloaca tissue.
Actions to take
If you suspect a case of AI:
- call the Emergency Animal Disease Hotline (1800 675 888) immediately or contact a government veterinarian in your state or territory
- isolate suspected cases and implement biocontainment protocols (including farm movement controls) until advised by government veterinary authorities.
Public health considerations
- AI is a zoonotic disease
- people may become infected after close contact with infected birds, excreta or litter. There is also a risk of infection from aerosol droplet and air contamination, though this is more rare
- consult with the relevant state or territory health authorities as soon as AI is strongly suspected or confirmed.
Introduction
Avian influenza (AI) is a highly contagious viral disease of birds which may take the form of highly pathogenic avian influenza (HPAI) or low pathogenic avian influenza (LPAI).
Disease agent and susceptible species
AI is caused by the Influenza A virus, which is an enveloped, single stranded negative sense RNA virus in the family Orthomyxoviridae, genus Influenza A. In addition:
- viruses have two surface antigens haemagglutinin and neuraminidase. Avian viruses have 16 types of haemagglutinin antigen (H1-16) and 9 types of neuraminidase antigen (N1-9)
- wild waterfowl and shorebirds (which rarely show disease) are the reservoir hosts for all influenza A virus subtypes
- influenza A affects all bird species but the domestic poultry species most susceptible to disease are chickens, turkey, guinea fowl, quail and pheasants. Waterfowl (including ducks) are typically resistant to disease, but HPAI viruses may still cause mortalities
- HPAI and LPAI are distinguishable by lethality in chickens as well as a molecular sequence in the haemagglutin protein of the virus. Only H5 and H7 viruses are known to cause HPAI, and H5 and H7 LPAI viruses may mutate spontaneously into HPAI especially following passage in poultry flocks
- LPAI viruses typically replicate in respiratory and intestinal epithelial cells while HPAI viruses replicate in many cell types, including heart and brain
- Both LPAI and HPAI virus can infect humans via close contact with infected birds. Most human infections have occurred in China, South-East Asia, Egypt and Indonesia. Mortality is especially reported in young children, older people, and immunosuppressed people, though HPAI can cause death in healthy adults. The main subtypes that infect humans include H5N1, H5N6, H7N9 and H9N2; however, subtypes H6N1, H7N4, H7N7 and H10N8 have also been reported to infect people.
Public health considerations
- people may become infected after close contact with infected birds, excreta or litter
- people in close contact with infected poultry and poultry facilities should use personal protective equipment such as gloves, disposable coveralls, rubber boots (or disposable boots), safety glasses and powered air purifying respirators
- it is important that personnel seek medical advice if they develop influenza-like symptoms or otherwise become unwell. Usually, symptoms of AI infection appear 2–8 days after infection (for more information see the Department of Health)
- consult the relevant state or territory health authorities in the case of an AI outbreak.
Distribution
LPAI and HPAI viruses of all H and N subtypes are endemic in wild waterfowl and shorebirds globally. LPAI outbreaks (clinical and subclinical) and HPAI outbreaks occur in poultry flocks globally, linked to the circulation of viruses in wild migratory birds and live poultry markets.
For the latest information on the distribution of AI, refer to the WAHIS information database website of the World Organisation for Animal Health (WOAH) or the FAO EMPRESi Global Animal Disease Information System.
Occurrences in Australia
In Australia, all seven outbreaks of HPAI were eradicated and involved H7 subtype viruses causing clinical disease in commercial poultry in:
- Victoria—1976, 1985 and 1992
- Queensland—1994
- New South Wales—1997, 2012 and 2013.
In Australian poultry several LPAI viruses, including H5, H7 and H9 subtypes, have been detected.
There was evidence of contact with waterfowl in many cases, and indications that LPAI viruses were initially involved in the outbreaks. These then evolved to HPAI with multiple passages in the flocks.
Epidemiology
Modes of transmission
Transmission occurs via:
- fomites such as water, food supplies, clothing, bird cages, pallets, egg filler flats, manure, feedstuff, people, equipment and vehicles that are contaminated with infected faeces or respiratory secretions. Water or food supplies contaminated by wildfowl faeces can introduce AI to caged poultry, and the movement of infected birds and fomites is the primary way to spread HPAI virus between flocks
- eggs may be a source of AI infection through shell contamination. While LPAI virus shedding in eggs has not been detected to date, HPAI viruses have been found in the yolk and albumen of eggs from chickens, turkeys and quail, suggesting the potential for vertical transmission exists
- direct contact between birds—LPAI and HPAI are likely to be introduced through direct contact with waterfowl (in the case of free range farms). Contact with faeces and respiratory secretions is important for AI transmission between birds, and aerosol transmission is possible within the poultry flock due to the close proximity of birds.
Disease dynamics
Wild aquatic birds (which rarely show disease) are the reservoir host for all influenza A virus subtypes, particularly members of the orders Anseriformes (ducks and geese) and Charadriiformes (gulls and shorebirds). Migratory birds are considered to be one of the ways the disease travels across and between continents.
In domestic poultry:
- the incubation period of AI can vary from hours to up to 2–3 days in individual birds depending on the strain
- LPAI virus infections in the flock may not be evident for 2 weeks
- infected birds can spread virus via respiratory and faecal secretions from as early at 24 hours after infection (spread is therefore possible during the incubation period and before the onset of clinical signs)
- most chickens excrete LPAI viruses for 1–2 weeks in contrast to water birds which may shed some LPAI or HPAI viruses for 3–4 weeks
- uncontrolled H5 or H7 LPAI infections have been known to mutate into virulent HPAI infections.
Persistence of the agent
AI viruses:
- can survive in aerosols, faeces and litter and survival is prolonged by high relative humidity and low temperature (the virus can survive within the poultry house environment for up to 5 weeks)
- remain infective in lake water for up to 4 days at 22 °C and for more than 30 days at 0 °C
- can be inactivated by heat of 60 °C for 60 minutes, or extremes of pH (pH<3 or >10)
- are highly susceptible to disinfectants, including detergents, but only if organic matter is removed from surfaces before disinfection.
Diagnosis and pathology
Clinical signs
LPAI viruses usually cause:
- subclinical infections or mild respiratory disease in poultry
- high morbidity (>50 per cent) and low mortality (<5 per cent), but mortality can be high in young birds or when AI is accompanied by secondary pathogens
- respiratory signs of varying severity, including coughing, sneezing, rales, rattles, nasal discharge and excessive lacrimation
- general clinical signs such as huddling, ruffled feathers, listlessness, decreased feed and water consumption and diarrhoea
- reduced egg production (in layers and breeders).
While there are no clinical signs pathognomonic for HPAI, signs in chickens may include:
- sudden onset of disease and rapid death (in very severe, peracute forms)
- profuse watery diarrhoea, oedema and cyanosis of the unfeathered skin and combs, ecchymoses on the shanks and feet, swelling of the face, coughing and neurological signs
- depressed birds with reduced egg production and egg quality that is more pronounced than with LPAI
- clinical signs in other gallinaceous birds (such as turkeys and quail) are similar to chickens. However, there are cases where H5 or H7 AI viruses have caused only mild illness in chickens and turkeys despite being classified as HPAI virus by molecular pathotyping.
- ducks and other waterfowl are typically resistant to disease caused by HPAI viruses, but some virus strains, including Asian-lineage H5 HPAI viruses, may cause acute mortality in these species.
Pathology
With LPAI:
- gross lesions are variable depending on the virus strain, host species and presence of secondary infection
- the infraorbital sinuses may be swollen, especially in turkeys, with accompanying mucoid nasal discharge
- the most frequent lesions are rhinitis and sinusitis of varying severity
- tracheal mucosa may be oedematous and congested, with occasional haemorrhages or exudate
- catarrhal air sacculitis and peritonitis may also be present, usually associated with secondary infection rather than LPAI
- swollen kidneys may occur in laying hens, as well as regression or haemorrhage of ovaries and ruptured ova (‘egg yolk peritonitis’)
- enteritis may be observed, especially in turkeys, and turkeys may have a pale and mottled pancreas.
With HPAI:
- gross lesions vary with the stage of infection
- in the peracute phase (when death occurs 1–2 days post-infection) there may be no gross lesions evident
- from 2–5 days post-infection, necrosis and cyanosis of the comb and wattles are common (subcutaneous oedema is also evident around the head, legs and feet, along with ecchymotic subcutaneous haemorrhages)
- internal organs most consistently have focal haemorrhages, particularly in the trachea, coronary fat, epicardium, proventriculus, Peyer’s patches and caecal tonsils
- severe oedema and haemorrhage in the lungs can occur.
Differential diagnosis
Note that many other viral and bacterial pathogens of chickens can present with similar clinical signs, or cause concomitant infections with AI. It is important for you to take into consideration that isolation of other pathogens may mask an underlying AI virus infection, and AI should be tested for if the clinical signs and pathology are present. This is especially important to remember considering the spectrum of signs that can be seen with LPAI.
Consider in the differential diagnosis:
- exotic diseases
- duck plague (duck viral enteritis)
- velogenic Newcastle disease
- endemic diseases
- avian chlamydiosis
- avirulent Newcastle disease
- bacterial septicaemia (enterococcosis, staphylococcosis, streptococcosis, colibacillosis, pasteurellosis, erysipelas)
- cellulitis of the comb and wattles (Escherichia coli and other bacteria)
- fowl cholera (Pasteurella multocida)
- infectious bronchitis
- infectious coryza
- infectious laryngotracheitis
- mycoplasmosis
- non-infectious causes
- acute poisoning
- dehydration
- heat stress
- smothering.
Samples required
Sample collection
Where AI is suspected, collect:
- tracheal, cloacal and faecal swabs from live, clinically affected birds
- serum from birds suspected to have been clinically affected for a number of days (at least seven birds) or recovered birds
- fresh tissue samples and whole blood (EDTA tube, 2 ml/bird) from clinically affected birds (killed immediately before a post-mortem examination) and from any recently dead birds. Fresh tissue should include samples from the brain, proventriculus, pancreas, intestine, liver, caecal tonsil, trachea, lungs and cloaca
- impression smears of the bursa of Fabricius, pancreas, brain, and spleen
- a full range of tissues (including the brain, proventriculus, pancreas, intestine, liver, caecal tonsil, trachea, lung, bursa, kidney and cloaca) in neutral-buffered formalin
- several whole birds (at least 5 birds) for post-mortem examination, as there may be great variability in lesions presented in individual animals. A composite picture of all lesions seen should be recorded.
Transport of samples
For transport:
- place swab samples in virus transport media containing antibiotics and antifungals (or saline if other media is unavailable)
- chill blood samples and unpreserved tissue samples (including whole carcasses) at 4 °C, or with frozen gel packs
- DO NOT freeze samples at -20 °C; it reduces the sensitivity when used for virus isolation and molecular diagnostic tests
- send samples with dry ice if the journey is expected to take several days
- formalin fixed tissue can be shipped at room temperature.
Sample submission
The relevant state or territory laboratory should coordinate sample packaging and consignment for delivery to the Australian Centre for Disease Preparedness.
Diagnostic tests
For AI:
- the most rapid, sensitive and specific diagnostic procedure is the detection of viral nucleic acid in whole blood and/or tissues by PCR (a positive result can be obtained within 1 day of pyrexia first developing in an animal)
- in order to quickly determine whether the virus is highly pathogenic, molecular pathotyping is carried out by sequencing the gene encoding the haemagglutination protein; this relies on adequate PCR detection
- commercial ELISA kits are available for detection of AI virus antigen and antibody but are comparatively less sensitive than molecular techniques, and antibodies against the AI virus will not be present in acutely affected birds
- viral antigen can also be detected in frozen sections of bursa of Fabricius, pancreas, brain, and spleen using direct immunofluorescence, and may yield a result in a matter of hours
- isolation of the virus is attempted by inoculation of tissue suspensions into embryonated chicken eggs. This takes 1–10 days and may be needed to improve genetic detection.
Reporting requirements
Cases of AI in commercial poultry flocks are nationally notifiable, and Australia has an international obligation to report cases with HPAI and H5/H7 LPAI viruses.
If you suspect AI, report it immediately. Call the Emergency Animal Disease Hotline on 1800 675 888, wherever you are in Australia. Alternatively, contact a government veterinarian in your state or territory.
Government duty veterinarians monitor the hotline and are available to advise you 24 hours a day, 7 days a week.
Biocontainment and personal protective equipment
AI is a public health risk. Human infections are often due to close contact with infected birds; however, influenza A viruses are generally transmissible by fomites and aerosol droplets. You must take this zoonotic risk into consideration when investigating an outbreak of sudden deaths, gastrointestinal or respiratory disease in poultry. Therefore, it is important to seek advice from government veterinary authorities, noting:
- biocontainment requires training in the use and appropriate disposal of personal protective equipment such as gloves, disposable coveralls, rubber boots (or disposable boots) and powered air purifying respirators
- personal decontamination is required when leaving infected premises. Thoroughly clean and then disinfect vehicles and equipment before leaving the property
- you need to avoid the spread of infection from premises by contaminated fomites such as personnel clothing, poultry litter, equipment and manure
- any people participating in the biocontainment of a HPAI outbreak must be vaccinated against seasonal influenza.


Further information
Abolnik C. 2014. A current review of avian influenza in pigeons and doves (Columbidae). Veterinary Microbiology. 170(3-4):181-96.
Pantin-Jackwood MJ, Swayne DE. 2009. Pathogenesis and pathobiology of avian influenza virus infection in birds. Rev Sci Tech. 28(1):113-36.
Spickler AR, Trampel DW, Roth JA. 2008. The onset of virus shedding and clinical signs in chickens infected with high-pathogenicity and low-pathogenicity avian influenza viruses. Avian Pathology. 37(6):555-77.
3.5 Bluetongue disease
Fast facts
Bluetongue is an arthropod-borne viral disease of ruminants transmitted by certain species of Culicoides midges.
Organism
Bluetongue virus (BTV):
- virulence may vary between serotypes and (in some cases) within serotypes
- is present in Australia (several serotypes) but clinical disease has not been reported in commercial Australian livestock.
Susceptible species
BTV affects all ruminant species, including goats, sheep, cattle, buffaloes, antelopes and deer (not all will develop clinical signs).
Economic impact
There is potential for significant economic loss associated with sheep production losses, as well as potential restrictions on international trade.
Epidemiology
- BTV distribution is determined by the presence of competent Culicoides vectors
- causes up to 100 per cent morbidity and 30–70 per cent mortality in sheep
- causes very low morbidity and mortality in cattle
- commonly causes subclinical infection in cattle and other species (for certain strains)
- has an incubation period of generally 2–8 days (but which may last as long as 20 days)
- viraemia is considered prolonged but not persistent
- has no recorded carrier state.
Transmission
Transmission occurs primarily through Culicoides vectors.
Clinical signs
Clinical signs of bluetongue disease vary in severity and are characterised by inflammation of mucous membranes, widespread haemorrhages and oedema. They include respiratory disease, lameness, oral lesions and nasal/ocular/oral discharges.
Post-mortem
Haemorrhages in the tunica media at the base of the pulmonary artery are regarded as being very characteristic of bluetongue.
Diagnosis and samples
Collect:
- serum and EDTA blood from affected and in contact live animals
- fresh spleen, heart and mesenteric lymph nodes from deceased animals.
Actions to take
If you suspect a case of bluetongue disease:
- call the Emergency Animal Disease Hotline (1800 675 888) immediately or contact a government veterinarian in your state or territory
- isolate suspected cases and implement biocontainment protocols (including movement controls and protection of animals from vectors) until advised by government veterinary authorities.
Introduction
Bluetongue disease is an arthropod-borne viral disease (arbovirus) of ruminants, which is characterised by inflammation of mucous membranes, widespread haemorrhages and oedema.
Disease agent and susceptible species
Bluetongue virus (BTV):
- is a non-enveloped double stranded RNA virus belonging to the Orbivirus genus of the Reoviridae family
- targets the epithelial cells of blood vessels and mucous membranes
- as of 2019 at least 27 serotypes have been identified worldwide of which 12 have been isolated in Australia
- affects all ruminant species, including sheep, goats, cattle, buffaloes, antelopes and deer
- affects sheep most severely whereas infection in cattle is generally subclinical, although this varies with the virus strain with which they are infected. However, cattle are of epidemiological importance as an amplifier of virus that can spill over into sheep.
Distribution
Bluetongue virus (BTV):
- occurs on all continents except Antarctica (New Zealand, Iceland and the Hawaiian Islands do not have Culicoides midges and are therefore free of BTV)
- caused outbreaks of disease across Europe and the United Kingdom (primarily associated with BTV-8) involving cattle, which reached as far north as Scandinavia in 2007.
For the latest information on the distribution of bluetongue, refer to the WAHIS information database website of the World Organisation for Animal Health (WOAH).
Occurrences in Australia
As of 2018, 12 serotypes of the virus (BTV-1, 2, 3, 5, 7, 9, 12, 15, 16, 20, 21 and 23) have been detected in Australia. Experimental infections of a number of these serotypes show variable virulence in sheep, but clinical disease has not been reported in commercial livestock.
Only two serotypes, BTV-1 and BTV-21, are routinely detected along the east coast, with most serotypes geographically limited to the northern parts of the Northern Territory and Western Australia. This limitation in geographical distribution is thought to be due to vector-virus interactions.
Changes to the epidemiology of bluetongue in Australia can occur with the introduction of new bluetongue viruses or insect vectors into northern Australia, and/or spread of viruses capable of causing disease into sheep-raising districts in eastern/southern Australia (which would have significant implications for trade of livestock and livestock products).
Bluetongue virus (BTV):
- is present in northern and eastern parts of Australia, but is associated with subclinical infection due to the limited geographical distribution of virulent strains capable of causing disease in sheep
- has not been detected in Victoria, South Australia or Tasmania
- distribution and prevalence varies from year to year according to climate and distribution and density of vector species
- Distribution of viral transmission is monitored through the National Arbovirus Monitoring Program (NAMP).
Epidemiology
Modes of transmission
BTV is not contagious and does not spread by direct contact between animals.
Transmission occurs via:
- vectors—certain species of Culicoides midges (of which there are over 1,400 species worldwide). Less than 1 per cent of species are capable of transmitting BTV. The primary vector species varies between regions.
- wind, implicated in the dispersal of infected Culicoides in some outbreaks
- transplacental transmission and transmission via ingesting placentas from infected cows are possible, but not considered important in the epidemiology of the virus (BTV is not contagious)
- semen, but sexual transmission does not appear to be a major route of infection.
- Transmission of BTV-26 (and infection) through direct contact under experimental conditions is also documented.
Disease dynamics
BTV:
- incubation is generally 2–8 days (but incubation may last as long as 20 days)
- viraemia is prolonged but not persistent
- incubation and viraemia are both dependent on the strain of infecting virus
- immunity is prolonged but normally serotype specific, with animals exposed to one serotype generally remaining susceptible to others (limited cross-protection between specific serotypes can occur)
- vaccines are available but are serotype specific
- serotype is not itself a determinant for virulence, which varies not only between serotypes but also between strains within a given serotype, particularly those from different geographical locations.
Persistence of the agent
BTV does not persist in the environment, nor in animal carcasses or products. However, infected Culicoides vectors remain infected for life and can be carried over long distances by wind, enabling dispersal of virus to susceptible hosts. A carrier state is not observed in ruminants.
Diagnosis and pathology
Clinical signs
Disease results from extensive virus-mediated vascular injury that produces oedema, hyperaemia, haemorrhage and tissue infarction.
Morbidity and mortality are highly variable and dependent on the infecting virus strain and breed of sheep. In sheep, subacute and mild disease may be seen with varying combinations of clinical signs, including:
- acute reddening and petechial haemorrhages on the coronary band (animals may stand with arched backs and be reluctant to move due to pain associated with the coronary band)
- pyrexia
- general weakness and lethargy
- laboured breathing
- lameness due to coronitis
- hyperaemic mucous membranes
- nasal discharge (initially clear, later mucopurulent)
- oedema and cyanosis of the tongue (in severe cases) which give rise to the name ‘bluetongue’
- oral erosions and ulcers
- petechial haemorrhages on the oral, nasal and conjunctival mucosae
- profuse haemorrhagic diarrhoea (in severe cases).
In the European outbreak of BTV-8 (2006–2007) clinical signs in cattle were marked and similar to those in sheep, although generally milder and with very low mortality.
However, in cattle:
- most infections are subclinical
- dermatitis, oral and nasal lesions predominate
- a drop in milk production may be noted.
Infection in goats is usually subclinical. Disease presentation amongst wild ungulates varies between species but white-tailed deer appear to be the most susceptible of this group, with peracute, acute and chronic clinical disease described.
Pathology
Haemorrhages of 2–15 mm in diameter located in the tunica media at the base of the pulmonary artery are highly characteristic of bluetongue and:
- hyperaemia, oedema and haemorrhages may be widespread
- the most prominent gross lesions are found in and around the mouth
- gastrointestinal mucosa may be oedematous, hyperaemic and possibly cyanotic, and
- petechial or ecchymotic haemorrhages may be present
- excoriations, which may be covered by grey necrotic material, may be found on the lips,
- dental pad, tongue and cheeks
- hyperaemia of the ruminal pillars and reticular folds is commonly found
- congestion, catarrhal inflammation and petechial haemorrhages maybe present in
- the small and large intestines
- lymph nodes and spleen may be moderately enlarged and haemorrhagic
- petechiae and pale areas of necrosis may be scattered through the skeletal musculature and myocardium
- catarrhal inflammation of the upper respiratory tract and oedema of the lungs may be present
- large quantities of plasma-like fluid may be seen in the thoracic cavity and pericardial sac.
Differential diagnosis
Consider in the differential diagnosis, depending on the species and predominant clinical signs:
- exotic diseases
- epizootic haemorrhagic disease (virus is present in Australia but no clinical disease has been reported) (affects cattle and deer)
- foot-and-mouth disease (affects cattle, deer, goats and sheep)
- peste des petits ruminants (affects goats and sheep)
- sheep pox and goat pox (affects sheep and goats)
- vesicular stomatitis (affects cattle)
- endemic diseases
- acute haemonchosis (with depression and submandibular oedema) (affects sheep)
- bovine parainfluenza 3 infection (affects cattle)
- bovine viral diarrhoea (BVDV1) (affects cattle)
- contagious pustular dermatitis (ecthyma, orf, scabby mouth) (affects sheep)
- footrot (affects cattle and sheep)
- infectious bovine rhinotracheitis (affects cattle)
- malignant catarrhal fever (bovine herpesvirus 2 is present in sheep Australia but clinical disease in cattle is rare) (affects cattle and deer)
- pneumonia (affects cattle, deer, goats and sheep)
- Oestrus ovis infestation (affects sheep)
- non-infectious diseases
- photosensitisation (affects cattle, deer, goats and sheep)
- plant poisoning (affects cattle, deer, goats and sheep)
- other causes of lameness (affects cattle, deer, goats and sheep).
Samples required
Sample collection
Collect:
- serum from at least 10 live, clinically affected animals, and from exposed animals (particularly those that are convalescent)
- EDTA blood (7–10 ml/animal) from live, clinically affected animals
- fresh tissue, spleen, heart, mesenteric lymph node (2 g of each tissue) from recently dead affected animals.
Transport of samples
For transport:
- chill blood samples and unpreserved tissue samples to 4 °C, or with frozen gel packs
- DO NOT FREEZE SAMPLES at -20 °C; it reduces the sensitivity when used for virus isolation and molecular diagnostic tests
- send samples with dry ice if the journey is expected to take several days.
Sample submission
The relevant state or territory laboratory should coordinate sample packaging and consignment for delivery to the Australian Centre for Disease Preparedness.
Diagnostic tests
Confirm the diagnosis of bluetongue disease by laboratory testing, noting that:
- tests are available for detection of bluetongue include PCR assays that exploit the nucleic acid specificity of the viral genome and virus isolation
- the sequencing of segments of the genome can also be used to confirm serotype and regional genotypes
- serological assays include a group specific ELISA and virus neutralisation tests.
Reporting requirements
Infection with BTV is notifiable to the WOAH and Australia has an international obligation to report cases.
If you suspect BTV, report it immediately. Call the Emergency Animal Disease Hotline on 1800 675 888, wherever you are in Australia. Alternatively, contact a government veterinarian in your state or territory.
Government duty veterinarians monitor the hotline and are available to advise you 24 hours a day, 7 days a week.
Biocontainment and personal protective equipment
There are no public health implications for bluetongue disease, but you should implement biocontainment protocols until advised by government veterinary authorities. This includes isolating suspected cases (and protecting from vectors, if possible) and using and appropriately disposing of personal protective equipment such as gloves, coveralls and rubber boots (or disposable boots). Thoroughly disinfect and decontaminate clothing, vehicle and equipment before leaving the property.





Further information
Batten C, Darpel K, Henstock M, Fay P, Veronesi E, et al. (2014) Evidence for Transmission of Bluetongue Virus Serotype 26 through Direct Contact. PLoS ONE 9(5): e96049. doi: 10.1371/journal.pone.0096049.
Kessell A, Finnie J, Windsor P. (2011) Neurological diseases of ruminant livestock in Australia. IV: viral infections. Australian Veterinary Journal. 89(9):331-7.
Maclachlan NJ, Mayo CE, Daniels PW, Savini G, Zientara S, Gibbs EP. (2015) Bluetongue. Rev Sci Tech. 34(2):329-40.
3.6 Bovine brucellosis
Fast facts
Bovine brucellosis is a chronic infectious bacterial disease of cattle that is zoonotic and poses a significant public health threat. It was successfully eradicated from Australia in 1989.
Organism
- Bovine brucellosis is primarily caused by a Gram-negative coccobacillus, Brucella abortus.
- B. abortus typically concentrates in reproductive tissues, such as the uterus, mammary glands and testes.
- B. abortus remains viable in milk and blood for extended periods and has prolonged environmental survival.
Susceptible species
Cattle are the primary host for B. abortus. However, a number of other species are also susceptible, including buffalo, bison, camel and elk. B. abortus is a serious zoonotic pathogen that can causes disease in humans.
Economic impact
There is potential for significant economic impact associated with production losses, and restrictions on animal movements and international trade.
Epidemiology
- Cattle are a natural reservoir of B. abortus, along with other species including water buffalo and bison.
- Naïve herds are highly susceptible and infection spreads rapidly.
- In endemic areas, cows may abort following their first exposure to the organism but are unlikely to abort in subsequent pregnancies. Nonetheless, they may remain persistently infected and continue to shed the organism.
Transmission
Bovine brucellosis can be transmitted by:
- direct contact with infected animals, their bodily fluids or products of abortion
- ingestion of contaminated milk, feed or water
- inhalation of aerosolised infection
- venereal transmission—rare following natural cover, but the organism can be transmitted by artificial insemination if semen is deposited into the uterus.
Clinical signs
Bovine brucellosis is most likely to present as herd-level reproductive failure. Clinical signs may include:
- abortion (typically late-term); often presents as abortion storms in susceptible herds
- reduced fertility
- retention of foetal membranes
- stillbirth or birth of weak calves that die shortly after birth
- reduced milk production
- orchitis and epididymitis
- arthritis and hygromas, particularly in long-term infections
- pathology in the seminal vesicles or testicles
- cervical bursitis.
Post-mortem
Gross lesions are predominantly granulomatous inflammation in the lymphoid system and reproductive tract and associated tissues. Lesions include:
- necrotic placentitis
- congested or swollen cotyledons
- discoloured inter-cotyledonary areas
- epididymitis and orchitis
- in chronic infections, hygromas.
Samples
As bovine brucellosis is a highly contagious zoonotic disease, appropriate personal protective equipment must be worn when collecting and handling samples for investigation.
Collect samples from clinically affected animals. Samples should include:
- milk
- serum from recently aborted or calved animals
- vaginal swabs collected in the 6-week period following calving or abortion
- aborted foetal tissue (including whole aborted foetus, foetal membrane cotyledons, foetal spleen, lung and stomach contents)
- fresh tissue (including head, mammary and genital lymph nodes, spleen, pregnant or post-parturient uterus and udder)
- semen
- synovial fluid from arthritis affected joints or hygroma fluid, if present.
Actions to take
If you suspect a case of bovine brucellosis:
- wear PPE and take precautions to protect yourself from zoonotic disease; do not allow other people to come into contact with the affected cattle while the disease investigation is underway
- call the Emergency Animal Disease Hotline (1800 675 888) immediately or contact a government veterinarian in your state or territory
- isolate suspected cases and implement biocontainment protocols (including farm movement controls) until advised by government veterinary authorities.
Public health considerations
- Bovine brucellosis is a zoonotic disease that can cause severe illness. It poses a particular threat to pregnant women as it can affect the unborn baby.
- People may become infected after close contact with infected tissues or body fluids or consuming undercooked meat or unpasteurised milk and milk products from an infected animal.
- Consult with the relevant state or territory health authorities as soon as bovine brucellosis is strongly suspected or confirmed.
Introduction
Bovine brucellosis is a highly contagious zoonotic bacterial disease, primarily presenting as reproductive loss.
Disease agent and susceptible species
- Bovine brucellosis in cattle and other Bovinae is primarily caused by Brucella abortus, a Gram-negative, aerobic coccobacilli of the family Brucellacea.
- There are eight B. abortus biovars recognised.
- Other Brucella species may be detected in cattle, including B. melitensis where cattle are kept in close contact with sheep or goats, which can cause a similar reproductive syndrome. Rarely, B. suis and B. canis are detected in cattle, but without evidence of clinical illness or transmission between cattle.
- B. abortus has been associated with reproductive loss in other species including camels, water buffalo, sheep and goats, and through experimental infection in llamas and other ungulates.
- Wild Bovinae are susceptible and can act as reservoirs of infection.
Public health considerations
- People may become infected after direct contact with tissues or body fluids from an infected animal, or through consuming undercooked meat or unpasteurised milk or milk products.
- Bovine brucellosis is typically considered an occupational disease, with those working directly with infected animals and/or their tissues at relatively high risk of infection (e.g. dairy farmers, feedlots, veterinarians, abattoir workers, meat inspectors and laboratory workers).
- Abortion, stillbirth and birth defects can occur if women become infected when pregnant.
- Vaccination for Brucella also poses a risk to humans, primarily through needlestick injury during administration of live attenuated vaccines.
- People in close contact with infected animals should use personal protective equipment such as gloves, disposable coveralls, rubber boots (or disposable boots) and safety glasses.
- Consult the relevant state or territory health authorities in the case of a bovine brucellosis diagnosis.
Distribution
- B. abortus has a wide distribution across the globe including Latin America, North and East Africa, the Middle East, South and Central Asia.
- Successful eradication programs in domesticated animal populations have been implemented in Australia, New Zealand, Japan, Canada, Israel and a number of European countries.
For the latest information on the distribution of bovine brucellosis, refer to the WAHIS information database website of the World Organisation for Animal Health (WOAH) or the FAO EMPRESi Global Animal Disease Information System.
Occurrences in Australia
Australia declared freedom from bovine brucellosis in domestic and wild animals in 1989 after a structured eradication campaign that began in 1970.
Epidemiology
Modes of transmission
- direct contact with infected animals and animal tissues such as aborted foetuses (including uterine and amniotic fluids), placental membranes, vaginal discharge and urine. B. abortus typically enters through ingestion, inhalation, via conjunctiva or through abrasions or wounds in the skin
- ingestion of infected milk—may transmit infection to newborn animals
- ingestion of contaminated feed or water
- Intrauterine insemination—may transmit the infection, but transmission from natural service by infected bulls appears rare.
Disease dynamics
- Cattle are a natural reservoir of B. abortus, along with other species including water buffalo and bison.
- Naïve herds are highly susceptible and infection spreads rapidly.
- The incubation period ranges from 2 weeks to several months, depending on the animal’s sexual maturity, state and stage of pregnancy at time of infection, dose and previous exposure.
- Large numbers of bacteria are shed at the time of abortion or calving.
- An infected cow typically becomes a chronic shedder, intermittently excreting bacteria in milk and reproductive secretions for years.
- Bulls can become infected following exposure during abortions in the herd. Bacteria concentrates in the testes and is typically shed in semen or can be excreted in faeces and urine.
- Calves can be infected early in life, often following consumption of infected milk, but clinical signs are typically not observed until they reach maturity. Calves infected in utero may be stillborn or born weak and die shortly after birth.
Persistence of the agent
- B. abortus is susceptible to heat and direct sunlight, but relatively resistant to desiccation. It can survive in the environment for up to 8 months under ideal conditions (low temperature, high humidity and limited to no sunlight).
- B. abortus can survive freezing and thawing.
- Pasteurisation of milk is effective at killing Brucella spp.
- B. abortus can be readily inactivated by many commonly available disinfectants, including hypochlorite, sodium hydroxide, 70% ethanol, isopropanol, iodophors and phenolic disinfectants.
Diagnosis and pathology
Clinical signs
In non-pregnant or chronically infected animals, infection may be subclinical. Clinical signs can be varied but typically relate to reproductive failure:
- abortion (typically late-term; abortion rate varies from 30 to 80% in susceptible herds); often seen as abortion storms in susceptible herds. Note that in endemic areas, cows may abort following their first exposure to the organism but are unlikely to abort in subsequent pregnancies (though may remain persistently infected and continue to shed the organism).
- poor conception rates and reduced fertility in females
- birth of weak calves or perinatal mortality
- retention of foetal membranes
- endometritis
- reduced milk production
- orchitis, epididymitis and hygroma
- pathology in the seminal vesicles or testicles
- cervical bursitis.
Pathology
Lesions are predominantly seen in the reproductive tract and associated tissues and include:
- necrotic placentitis
- congested or swollen cotyledons covered with yellowish or sticky brown exudates
- thick, opaque and discoloured inter-cotyledonary areas
- epididymitis and orchitis.
Granulomatous inflammatory lesions can be seen elsewhere throughout the body, particularly in the lymph nodes, liver, spleen, mammary glands, joints, tendon sheaths and bones.
Differential diagnosis
Differential diagnosis should consider all diseases that induce abortion in cattle, particularly multiple late-term abortions across the herd, and diseases that result in epididymitis and orchitis in bulls. These may include:
- exotic diseases
- Rift Valley fever
- Schmallenberg virus
- bovine viral diarrhoea (Type 2)
- contagious bovine pleuropneumonia (CBPP)
- endemic diseases
- infectious bovine rhinotracheitis
- bovine viral diarrhoea (Type 1)
- Q fever
- Akabane virus
- leptospirosis
- listeriosis
- vibriosis (campylobacteriosis)
- neosporosis
- trichomoniasis
- mycotic abortion
- salmonellosis
- infections causing high fever; for example, bovine ephemeral fever.
Samples required
As bovine brucellosis is a highly contagious zoonotic disease, appropriate personal protective equipment must be worn when collecting and handling samples for investigation.
Sample collection
Collect these samples from clinically affected animals, taking care to collect samples aseptically where possible:
- milk (10–20 mL from each quarter of the udder after washing, drying and disinfecting the teats; discard the first few streams)
- serum from recently aborted or calved animals
- vaginal swabs collected in the 6-week period following calving or abortion
- aborted foetal tissue, including whole aborted foetus, foetal membrane cotyledons, foetal spleen, lung and stomach contents
- fresh tissue including lymph nodes (head, mammary, genital), spleen, pregnant or post-parturient uterus and udder
- semen
- synovial fluid from arthritis affected joints or hygroma fluid if present.
Transport of samples
For transport, ensure appropriate sample packaging guidelines are met, with triple packaging and clear labelling of the zoonotic potential external to the secondary layer.
- Chill blood samples, milk and unpreserved tissue samples at 4°C or with frozen gel packs.
- Tests on milk samples must be performed within 48 hours of collection for valid results.
- For longer periods of storage prior to submission, samples should be frozen at or below −20°C.
- Send the samples with dry ice if the journey is expected to take several days.
Sample submission
The relevant state or territory laboratory should coordinate sample packaging and consignment for delivery to the Australian Centre for Disease Preparedness.
Diagnostic tests
For bovine brucellosis diagnosis, recommended tests are:
- serological tests—available tests include the Rose Bengal test (RBT), complement fixation test (CFT) and indirect ELISA
- milk ring test (MRT) or ELISA for bulk milk samples
- nucleic acid detection by real-time reverse transcription polymerase chain reaction (real-time RT-PCR)
- bacterial culture.
Reporting requirements
Bovine brucellosis is reportable in Australia. Bovine brucellosis is a WOAH-listed disease, and Australia has an international obligation to report cases. If you suspect bovine brucellosis, report it immediately by phoning the Emergency Animal Disease Hotline on 1800 675 888, wherever you are in Australia. Alternatively, contact a government veterinarian in your state or territory.
Biocontainment and personal protective equipment
Bovine brucellosis is a public health risk causing severe disease in people and posing an especially high risk to pregnant women. Human infections occur as a result of direct contact with tissues or body fluid of an infected animal, eating undercooked meat from an infected animal or from consuming unpasteurised dairy products from an infected animal. The organism may also be inhaled in an abattoir or laboratory setting, although this is rare. You must take this zoonotic risk into consideration when investigating an outbreak of abortions in cattle. It is important to seek advice from government veterinary authorities, noting:
- Biocontainment requires the appropriate use and disposal of personal protective equipment such as gloves, disposable coveralls, rubber boots (or disposable boots) and masks.
- Personal decontamination is required when leaving infected premises. Thoroughly clean and then disinfect vehicles and equipment before leaving the property.
- Use suitable hand protection such as armoured or cut-resistant gloves, especially during examination of aborted foetuses.
- Consumption of unpasteurised dairy products should be avoided.

Image credit: WOAH Brucella Reference Lab, National Institute of Animal Health, Department of Livestock Development

Image credits: AFIP and CFSPH

Image credit: WOAH Brucella Reference Lab, National Institute of Animal Health, Department of Livestock Development
Further information
Khurana, S.K., Sehrawat, A., Tiwari, R., Prasad, M., Gulati, B., Shabbir, M.Z., Chhabra, R., Karthik, K., Patel, S.K., Pathak, M., Iqbal Yatoo, Mohd., Gupta, V.K., Dhama, K., Sah, R., Chaicumpa, W. (2021) Bovine brucellosis – a comprehensive review, Veterinary Quarterly, 41(1):61–88, doi: 10.1080/01652176.2020.1868616
Kiros, A., Asgedom, H., Abdi, R.D., 2016. A review on bovine brucellosis: Epidemiology, diagnosis and control options. ARC Journal of Animal and Veterinary Sciences, 2(3): 8–21, doi: 10.20431/2455-2518.0203002.
Kaden, R., Ferrari, S., Jinnerot, T., Lingberg, M., Wahab, T., Lavander, M (2018) Brucella abortus: determination of survival times and evaluation of methods for detection in several matrices, BMC Infectious Diseases, 18(1): 259, doi: 10.1186/s12879-018-3134-5.
3.7 Bovine spongiform encephalopathy
Fast facts
Bovine spongiform encephalopathy (BSE) is due to a prion that results in a fatal neurodegenerative disease.
Agent
- BSE is caused by the accumulation of structurally-altered, stable and protease-resistant forms of prion protein (known as PrPTSE)
- atypical BSE is caused by prions with either higher (H-type) or lower (L-type) molecular mass fragments than classical BSE
- prions are highly resistant to physical and chemical inactivation procedures.
Susceptible species
BSE affects:
- cattle
- humans (variant Creutzfeldt-Jacob disease, also known as vCJD).
Economic impact
There is potential for significant economic loss associated with restrictions on animal movements and international trade.
Epidemiology
- the incubation period is protracted, typically 2–8 years
- the disease therefore manifests in adult animals
- disease is always fatal.
Transmission
- natural transmission has not been observed with atypical forms of BSE
- consumption of BSE-infected central nervous system tissue has been implicated in vCJD in people, so a case of BSE has food safety implications.
Clinical signs
Clinical signs in ruminants include:
- changes in mentation, behaviour and posture or gait
- neurological disease accompanied by weight loss and emaciation.
Post-mortem
No gross lesions are detectable on post-mortem examination.
Samples
If safe to do so, and while wearing personal protective equipment, conduct a post-mortem and collect:
- whole brain fixed in 10 per cent neutral buffered formalin (obex, caudal cerebellar peduncles and midbrain samples)
- a 1–2 cm segment of fresh cervical spinal cord or caudal medulla
Actions to take
If you suspect a case of BSE:
- call the Emergency Animal Disease Hotline (1800 675 888) immediately or contact a government veterinarian in your state or territory
- isolate suspected cases and implement biocontainment protocols (including farm movement controls) until advised by government veterinary authorities.
Public health considerations
BSE is a zoonotic disease and people may become infected after close contact with infected tissues.
- Consult the relevant state or territory health authorities as soon as BSE is strongly suspected or confirmed.
Introduction
Bovine spongiform encephalopathy (BSE) is a progressive neurodegenerative disease of adult cattle. The three strains identified in cattle include classical BSE and two strains of atypical BSE (H-type and L-type).
Disease agent and susceptible species
BSE is caused by the accumulation of structurally-altered, stable and protease-resistant forms (known as PrPTSE) of prion protein in the CNS. In addition:
- classical BSE is caused by transmission of the BSE prion, whereas atypical BSE is thought to be a spontaneously occurring, non-contagious disease
- the two atypical strains—H-type BSE and L-type BSE—are caused by prions with either higher (H-type) or lower (L-type) molecular mass fragments than classical BSE
- BSE is principally a disease of domestic cattle, but other bovids including buffalo may be affected
- experimental infection has been induced in other ruminants (sheep and goats), mice, mink and non-human primates
- spongiform encephalopathies of various captive exotic species (wild ungulates and felids) are associated with ingestion of bovine carcasses or dietary supplementation of prion-contaminated meat-and-bone meal
- a spike in the incidence of acquired or variant Creutzfeldt-Jakob disease (vCJD) in humans occurred following the BSE epidemic in the United Kingdom. The consumption of food containing CNS tissue from BSE-affected cattle causes vCJD, a fatal neurodegenerative disease.
Public health considerations
- people may become infected after close contact with infected tissues
- if undertaking post-mortem examinations, wear personal protective equipment such as gloves and coveralls, rubber boots (or disposable boots), safety glasses and mask
- consult the relevant state or territory health authorities in the case of a BSE outbreak.
Distribution
BSE has been reported in the United Kingdom, Europe, Canada, Japan and Israel. For the latest information on the distribution of BSE, refer to the WAHIS information database website of the World Organisation for Animal Health (WOAH).
Occurrences in Australia
Classical and atypical BSE have not been detected in cattle in Australia.
Epidemiology
Modes of transmission
Infection requires exposure to CNS tissue from affected cattle. Transmission occurs via:
- feeding of contaminated material—the primary risk factor for BSE transmission is ingesting prion-contaminated feed. These products include: tonsils, distal ileum, brain, eyes, spinal cord, skull and vertebral column (which may be found in ruminant-derived meat-and-bone meal products, gelatin and tallow). For this reason, the feeding of ruminant-derived meat-and-bone meal to cattle is banned.
Disease dynamics
In countries other than the United Kingdom, BSE cases have originated from imported cattle or feeding young animals contaminated meat-and-bone meal. In addition:
- due to the protracted incubation of prion diseases, most cases of BSE in cattle occur in 3–8 year old animals
- the BSE in the United Kingdom was fundamentally a food-borne epidemic with BSE transmitted to young animals via feed contaminated with infectious prion. During the epidemic, most cattle were infected within the first 6 months of life and developed disease at 5–7 years of age.
Persistence of the agent
Prion strains are typically highly resistant to inactivation. In addition:
- PrPTSE is resistant to physical and chemical inactivation procedures, including freezing, desiccation, ultraviolet radiation, degradation by various proteolytic enzymes, burial, and common methods of chemical and heat disinfection that destroy bacteria and viruses
- some organic acids can inactivate infectious prion proteins
- prions can adhere very strongly to stainless steel which may require special chemical disinfection.
Diagnosis and pathology
Clinical signs
The clinical course of BSE is protracted and slowly progressive over a period of weeks to months. Clinical signs of atypical and classical BSE are similar and:
- animals may have changes in mentation (fear, apprehension, aggression), sensation (hyperaesthesia), and posture and gait (ataxia, tremor, recumbency)
- non-specific signs such as weight loss and reduced milk yield may be present.
Pathology
No gross CNS lesions are present in cases of BSE.
Differential diagnosis
Consider BSE in cattle over 30 months of age presenting with neurological signs. Differential diagnoses include disorders that affect the neurological function and locomotion, which includes:
- exotic diseases
- endemic diseases
- botulism
- brain or spinal cord abscess
- bovine herpesvirus
- Clostridium perfringens type D (focal symmetrical encephalomalacia)
- Histophilus somni encephalitis
- Listeria monocytogenes
- malignant catarrhal fever (sheep-associated malignant catarrhal fever is endemic)
- non-infectious causes
- brain or spinal cord trauma
- lead or plant toxicosis
- metabolic disease (hypomagnesemia, hypocalcaemia, polioencephalomalacia)
- neoplasia
- nutritional myopathy (white muscle disease).
Samples required
Sample collection
There is currently no validated diagnostic test available to detect BSE in live animals. Diagnostic tests require brain and spinal cord obtained at post-mortem examination.
Note that you should:
- take stringent precautions during sampling, including wearing full personal protective equipment; where BSE is strongly suspected, direct efforts at collecting the brain and cervical spinal cord samples with minimal damage
- take care when disposing of or decontaminating equipment used for the post-mortem removal of brain tissue from suspected BSE cases
- be able to recover diagnostic material following mechanical injury to the brain (e.g. euthanasia by captive bolt).
For suspected cases of BSE, collect whole brain fixed in 10% neutral buffered formalin, and a 1–2 cm segment of unfixed (fresh) cervical spinal cord or caudal medulla.
Transport of samples
For transport:
- chill blood samples and unpreserved tissue samples at either 4 °C, or with frozen gel packs
- DO NOT FREEZE SAMPLES at -20 °C; it reduces the sensitivity when used for virus isolation and molecular diagnostic tests
- send samples with dry ice if the journey is expected to take several days
- formalin fixed tissue can be sent at room temperature.
Sample submission
The relevant state or territory laboratory should coordinate sample packaging and consignment for delivery to the Australian Centre for Disease Preparedness.
Diagnostic tests
Histologic examination is required to identify characteristic lesions within significant areas of the CNS, and to exclude differential diagnoses. In addition:
- immunohistochemistry (IHC) detects PrPTSE aggregates in formalin-fixed brain sections and can be evaluated in conjunction with histological changes
- detection by Western blotting of PrPTSE in unfixed tissue homogenates has similar diagnostic sensitivity to IHC
- rapid ELISAs are typically used as a screening strategy in surveillance programs.
Reporting requirements
BSE is an WOAH-listed disease and Australia has an international obligation to report cases.
If you suspect BSE, report it immediately. Call the Emergency Animal Disease Hotline on 1800 675 888, wherever you are in Australia. Alternatively, contact a government veterinarian in your state or territory.
Government duty veterinarians monitor the hotline and are available to advise you 24 hours a day, 7 days a week.
Biocontainment and personal protective equipment
BSE is a public health risk. Live cattle do not pose a risk, but human infections may result from contact with tissues of infected animals (as well as aerosols generated during slaughter or post-mortem examination). Post-mortem examinations of animals that have died from BSE pose a risk for animal-to-human transmission. Therefore, keep suspected cases of BSE isolated and on the property until advised by government veterinary authorities, noting you should:
- wear appropriate personal protective equipment (coveralls and boots, gloves, safety glasses or full face visor and protective respirator) when examining animals, performing post-mortem examinations, or handling tissue
- minimise the use of sharps and where possible use single-use disposable items (e.g. scalpels)
- use suitable hand protection such as armoured or cut resistant gloves, especially during collection of the brain or spinal cord
- extract central nervous system tissue using hacksaws and bone forceps to reduce the risk of exposure to bone dust contaminated with neural tissue (as would occur with oscillating saws)
- undertake personal decontamination when leaving infected premises. Thoroughly clean and then disinfect vehicles and equipment before leaving the property.

Further information
Australian and New Zealand Standard Diagnostic Procedure. Transmissible spongiform encephalopathies (pdf 2.29MB). 2010.
Cantile C & Youssef S: Nervous System. In: Jubb, Kennedy, and Palmer’s Pathology of Domestic Animals, ed. Maxie MG, 6th, vol. 1, pp. 347-350. Elsevier Saunders. Philadelphia, PA, 2016. Accessed 30 October 2017.
3.8 Brucella melitensis infection
Fast facts
Brucella melitensis is a zoonotic bacterial disease that is the major cause of brucellosis in sheep and goats.
Organism
B. melitensis:
- is a non-encapsulated Gram-negative coccobacillus in the genus Brucella
- has three biovars that are not known to differ in virulence
- grows well at 37oC in normal atmospheric conditions and in the presence of carbon dioxide
- is very sensitive to sunlight and is destroyed by pasteurisation.
Susceptible species
Sheep and goats are the most common natural hosts. Cattle may have subclinical infection in endemic areas. Dogs and rats are susceptible but not thought to play a role in the epidemiology. Humans may be clinically infected.
Economic impact
There is potential for significant economic loss associated with production losses such as reduced milk yield and reproduction failures, as well as potential restrictions on international trade. Further economic losses may be incurred directly by farmers if they become infected and are unable to work due to illness.
Epidemiology
In infected flocks or herds:
- the disease is usually subclinical in non-pregnant animals
- abortion in late pregnancy, stillbirths or weakly young are often observed
- pregnant animals will abort at least once, but will shed bacteria during subsequent pregnancies
- males may have reduced fertility.
Transmission
Transmission occurs via:
- ingestion (oral) or direct contact with the bacteria through mucous membranes or breaks in skin
- fomites contaminated with aborted products and infected bodily fluids
- sexual transmission from infected males.
Clinical signs
B. melitensis primarily affects the reproductive system of infected animals.
Clinical signs may include:
- abortions (commonly during last trimester), stillbirths and weak offspring
- reduced milk yield
- fever, anorexia, lameness or stiffness
- mastitis
- swelling/inflammation of the male and female reproductive organs.
Post-mortem
Gross lesions are generally absent in non-pregnant female animals. In infected pregnant animals, gross lesions may be visible in the gravid reproductive tract. These may include:
- foetid yellow to brown exudate in the uterus
- placenta appearance ranging from oedematous and thickened to inflammatory necrotic lesions
- placentomes that appear normal, necrotic or haemorrhagic.
Aborted foetuses may appear normal or autolysed with abdominal and thoracic organ abnormalities.
Samples
Collect:
- serum and milk from living animals
- vaginal swabs or semen
- fresh tissues—a full range, including reproductive organs
- fresh tissue from aborted foetuses
- synovial fluid from arthritis-affected joints or hygroma fluid if present.
Actions to take
If you suspect a case of B. melitensis:
- call the Emergency Animal Disease Hotline (1800 675 888) immediately or contact a government veterinarian in your state or territory
- isolate suspected cases and implement biocontainment protocols (including farm movement controls) until advised by government veterinary authorities.
Public health considerations
- B. melitensis is a zoonotic disease.
- People may become infected after exposure to contaminated parturition products, blood, milk or other reproductive fluids. There is also a risk of infection from needlestick injuries when vaccinating animals against B. melitensis.
- Consult with relevant state or territory health authorities as soon as B. melitensis is strongly suspected or confirmed.
Introduction
Brucella melitensis is a highly contagious bacterial infection of small ruminants and other animals; there are three known biovars with different geographical ranges. B. melitensis is the most virulent Brucella species for humans. Brucellosis in cattle, pigs or dogs is generally caused by other Brucella species.
Disease agent and susceptible species
B. melitensis:
- is a small, non-motile, non-sporing, non-encapsulated Gram-negative coccobacillus in the genus Brucella, family Brucellacea
- is a facultative intracellular pathogen of the reticuloendothelial system
- has three biovars (1–3) that are not known to differ in virulence
- is primarily a pathogen of goats and sheep, but in endemic areas or when ruminant species are kept in close contact may cause disease in cattle, buffalo and camels. Other species, such as horses and pigs, may be susceptible under similar conditions.
Goats are more susceptible than sheep, and dairy sheep breeds are more susceptible than meat breeds.
Males are more resistant than females to infection. Sexually mature animals are more susceptible than immature animals—young animals generally do not show clinical signs.
Public health considerations
- B. melitensis is the most virulent Brucella species for humans and is one of the most predominant zoonotic pathogens globally.
- People typically become infected by ingesting the organism via mucous membrane contact (including conjunctiva and respiratory tract) with contaminated materials or through broken skin.
- Pathogen sources can include direct contact with infected animals, contaminated dust and airborne particles, contaminated parturition products, blood, unpasteurised milk and milk products, other reproductive fluids and undercooked meat.
- Needlestick exposure during vaccination administration with live attenuated strains also poses an infection risk to humans.
- Consult with relevant state or territory health authorities if B. melitensis is strongly suspected or confirmed.
Distribution
- B. melitensis is found in European countries bordering the Mediterranean Sea, the Middle East, sub-Saharan Africa, China, India, Peru and Mexico, and central, southwest and South-East Asia. The disease is underreported in both human and animal populations and data is missing from many countries.
- Australia, New Zealand, western and northern Europe, Canada, the United States of America and Japan are considered free.
For the latest information on the distribution of B. melitensis, refer to the WAHIS information database website of the World Organisation for Animal Health (WOAH) or the FAO EMPRESi Global Animal Disease Information System.
Occurrences in Australia
B. melitensis has never been detected in sheep or goats in Australia. Annually, Australia reports a small number of human cases diagnosed from migrants and tourists returning from B. melitensis endemic countries.
Epidemiology
Modes of transmission
B. melitensis is contagious and transmission can be horizontal or vertical, direct or indirect between susceptible animals.
Transmission occurs via:
- direct contact via the oronasal route—animals become infected via mucous membranes in the oropharynx, upper respiratory tract and the conjunctiva
- animal movement of infected pregnant animals into a new herd or flock
- environmental contamination from aborted products (placenta foetal fluids and vaginal discharges)
- oral means through consumption of contaminated colostrum or milk
- natural mating or artificial insemination when semen comes into contact with mucous membranes in the female reproductive tract.
Disease dynamics
Brucella species are generally species specific, with B. melitensis primarily infecting sheep and goats. However, in endemic areas or where ruminant species are kept in close contact, cattle, buffalo and camels may become infected. There are reports of infection in wild ruminants including Alpine ibex (Capra ibex) and Iberian wild goat (Capra pyrenaica) in Italy and the French Alps. However, they are considered dead-end carriers and do not play a reservoir role for domestic sheep and goats.
- Different breeds of sheep vary in susceptibility, with dairy breeds being more susceptible.
- The incubation period following infection varies in length from 2 weeks to several months and depends on the infectious dose, virulence of the strain and immunological and physiological status of the host.
- Abortion in late pregnancy, stillbirths or weakly young often occur following infection. Abortion storms may be observed.
- After the initial abortion, the ewe/doe will generally carry subsequent pregnancies to term but will continue to shed the bacteria during parturition, contaminating the environment. Neonates may be infected through the consumption of contaminated colostrum or milk
- Goats can continue to shed bacteria for up to 2–3 months after an abortion. Sheep will shed for up to 3 weeks after an abortion.
- Infected males can have reduced fertility due to chronic inflammation of reproductive organs.
Persistence of the agent
B. melitensis:
- can survive outside an animal host for several months in organic material under suitable environmental conditions such as dust and soil with pH >4, high humidity, low temperature and protection from sunlight
- can survive in necrotic foetal and placental material for up to 6 months and in soil protected from sunlight for up to 3 months
- is destroyed by moist heat (121oC for at least 15 minutes) or dry heat (160–170oC for at least 1 hour)
- is destroyed by pasteurisation, disinfectants such as hypochlorite solutions, chlorhexidine, sodium hydroxide (may require prolonged contact time e.g. 1 hour), acid (pH< 3.5) and UV radiation.
Recovered animals may remain persistently infected, excreting bacteria intermittently throughout lactation and in vaginal discharges associated with parturition.
The udder and supra-mammary lymph nodes are predilection sites for the pathogen and persistent infections with intermittent shedding (usually immediately post parturition and in late lactation) are common, especially in goats.
Diagnosis and pathology
Clinical signs
B. melitensis primarily affects the reproductive system of infected animals. In naïve herds, a widespread abortion storm can occur. Other clinical signs include:
- swelling/ inflammation of the male reproductive organs, abortion (middle to late gestation)
- weak newborns or stillbirths
- mastitis
- retained foetal membranes
- vaginal or vulvular purulent discharge
- fever
- anorexia
- lameness or joint stiffness
- lymphadenopathy.
Pathology
Gross lesions are generally absent in non-pregnant female animals. In infected pregnant animals, gross lesions may be visible in the gravid reproductive tract. These may include:
- necrotising placentitis, or the placenta appearance may range from oedematous and thickened with slightly viscous exudate to inflammatory necrotic lesions with sticky exudate
- foetid yellow to brown exudate in the uterus.
Appearance of placentomes may range from normal to extensively necrotic to haemorrhagic.
Aborted foetuses may:
- appear normal or autolysed, or have generalised oedema with blood staining in the thoracic and abdominal cavities
- have hepatomegaly, pleuropneumonia and/or turbid and flaky stomach contents.
In males, gross lesions may include:
- evidence of inflammation of the reproductive organs such as epididymitis, orchitis or seminal vesiculitis
- abscesses or calcified foci, and fibrotic or thickened tunica vaginalis.
Abscesses or granulomas may also be found on other organs.
Differential diagnosis
In the differential diagnosis in sheep and goats, consider:
- exotic diseases
- Rift Valley fever
- Wesselsbron disease
- endemic diseases
- chlamydiosis
- ovine vibriosis
- salmonellosis
- coxiellosis
- toxoplasmosis
- listeriosis
- leptospirosis
- Border disease
- B. ovis infection
- non-infectious causes
- metabolic disease (e.g. pregnancy toxaemia)
- trace mineral deficiencies (e.g. copper and selenium)
- plant toxicosis (e.g. annual ryegrass toxicity).
Abortion storms are a non-specific sign of several exotic and endemic diseases. Samples should be obtained and tested to determine the cause.
Samples required
Sample collection
Collect these samples from clinically affected animals, taking care to collect samples aseptically where possible:
- milk (collect 10–20mL from each quarter of the udder after washing, drying and disinfecting the teats. Discard the first few streams.)
- serum
- vaginal swabs
- aborted foetal tissue, including whole aborted foetus, placenta, foetal spleen, lung and stomach contents
- fresh tissue including lymph nodes (head, mammary, genital), spleen, pregnant or post-parturient uterus, udder or male reproductive organs
- semen
- synovial fluid from arthritis affected joints or hygroma fluid if present.
Transport of samples
Considerations when transporting samples include:
- Chill blood, milk and unpreserved tissue samples at 4°C or with frozen gel packs.
- Tests on milk samples must be performed within 48 hours of collection for valid results.
- For longer periods of storage prior to submission, samples should be frozen at or below −20°C.
- Send the samples with dry ice if the journey is expected to take several days.
Sample submission
The relevant state or territory diagnostic laboratory should coordinate sample packaging and consignment for delivery to the Australian Centre for Disease Preparedness.
Diagnostic tests
For B. melitensis diagnosis use:
- serological tests—available tests include the Rose Bengal test (RBT), complement fixation test (CFT) and indirect ELISA
- nucleic acid detection by real-time reverse transcription polymerase chain reaction (real-time RT-PCR)
- bacterial culture.
Reporting requirements
Infection with B. melitensis is reportable in Australia. B. melitensis is a WOAH-listed disease, and Australia has an international obligation to report cases. If you suspect B. melitensis, report the disease immediately by phoning the Emergency Animal Disease Hotline on 1800 675 888, wherever you are in Australia. Alternatively, contact a government veterinarian in your state or territory.
Biocontainment and personal protective equipment
B. melitensis is a public health risk. Human infections may occur through: exposure of skin wounds or mucous membranes; aerosol transmission via the respiratory tract or conjunctiva; or ingestion of contaminated unpasteurised dairy products. There is increased risk of exposure when assisting with lambing or kidding or investigating abortions due to contact with highly infectious tissues and fluids. You must take this zoonotic risk into consideration when investigating an outbreak of sudden abortions in sheep and goat flocks. Therefore, it is important to seek advice from government veterinary authorities, noting:
- Biocontainment requires training in the use and appropriate disposal of personal protective equipment such as gloves, disposable coveralls, rubber boots (or disposable boots) and powered air purifying respirators.
- Personal decontamination is required when leaving infected premises. Thoroughly clean and then disinfect vehicles and equipment before leaving the property.
- You need to avoid the spread of infection from premises by contaminated fomites such as personnel clothing, aborted foetuses and associated products, equipment and manure.

Image credits: WOAH-Bru Lab-NIAH-DLD

Image credits: WOAH-Bru Lab-NIAH-DLD

Image credits: WOAH-Bru Lab-NIAH-DLD

(orchitis and epididymitis) on one side,
normal to slightly enlarged testicle
on the other side
Image credits: WOAH-Bru Lab-NIAH-DLD
Further information
Godfroid, J. et al. (2014) ‘The quest for a true One Health perspective of brucellosis’, Revue Scientifique Et Technique (International Office of Epizootics), 33(2), pp. 521–538. Available at: https://doi.org/10.20506/rst.33.2.2290.
Rossetti, C.A., Arenas-Gamboa, A.M. and Maurizio, E. (2017) ‘Caprine brucellosis: A historically neglected disease with significant impact on public health’, PLOS Neglected Tropical Diseases, 11(8), p. e0005692. Available at: https://doi.org/10.1371/journal.pntd.0005692.
Rossetti, C.A., Maurizio, E. and Rossi, U.A. (2022) ‘Comparative review of brucellosis in small domestic ruminants’, Frontiers in Veterinary Science, 9, p. 887671. Available at: https://doi.org/10.3389/fvets.2022.887671.
3.9 Classical swine fever
Fast facts
Classical swine fever (CSF), also called hog cholera or swine fever, is a highly contagious, generalised exotic viral disease of pigs clinically indistinguishable from African swine fever.
Organism
CSF virus:
- replicates in blood and lymphatic tissues but is found in all tissues and body fluids
- has only one serotype
- is highly resistant to inactivation.
Susceptible species
Only pigs are susceptible to CSF.
Economic impact
There is potential for significant economic loss associated with high mortality and morbidity in pigs, as well as restrictions on animal movements and international trade.
Epidemiology
CSF:
- causes very high morbidity and up to 90 per cent mortality in the acute form
- has an incubation period of 2–6 days
- chronic or mild forms play a key role in disease spread through sub-clinically infected carriers
- piglets born to infected sows may also remain chronically infected, continuing to excrete the virus for several months before showing overt disease.
Transmission
Transmission occurs via:
- direct contact, usually oronasal
- contact with carcasses
- indirect transmission from ingestion, breeding (including artificial insemination) and fomites
- mechanical transmission by vectors.
Clinical signs
Affected animals may suffer from acute, chronic or subclinical disease and clinical signs vary according to the disease form (as influenced by the virus strain, route and dose of infection). Signs include:
- marked pyrexia, drowsiness, depression, anorexia and death (acute form)
- depression, anorexia, ill-thrift, fluctuating pyrexia and death after day 30 post-infection (chronic form).
Post-mortem
Pigs that die of acute disease may have few gross lesions, otherwise:
- lymph nodes are swollen, congested and haemorrhagic
- petechial or ecchymotic haemorrhages are found in many locations, including the renal cortex, larynx, trachea and small intestine.
Samples required
Also refer to the detailed section on sampling for sudden death in pigs.
Collect:
- blood samples (EDTA and plain tubes) from living animals
- fresh tissue from tonsils, spleen, lymph nodes, kidney, lung, liver, ileum and brain.
Actions to take
If you suspect a case of CSF:
- call the Emergency Animal Disease Hotline (1800 675 888) immediately or contact a government veterinarian in your state or territory
- isolate suspected cases and implement biocontainment protocols (including farm movement controls) until advised by government veterinary authorities.
Introduction
Classical swine fever (CSF), also known as hog cholera or swine fever, is a highly contagious viral disease of pigs. CSF is clinically similar to African swine fever (ASF) but is caused by a different virus. The variation in clinical signs makes clinical identification difficult and definitive diagnosis requires laboratory testing.
Disease agent and susceptible species
CSF virus:
- is an enveloped RNA virus in the family Flaviviridae, genus Pestivirus
- has only one serotype but strains vary considerably in virulence and antigenicity
- affects domestic and feral pigs (Sus scrofa), which are the only susceptible species in Australia outside zoos.
Distribution
CSF:
- occurs in much of Asia, and in Central and South America, and parts of Europe and Africa
- was identified in the southern part of West Papua, Indonesia, in 2004
- has been eradicated from most of western Europe but a foci of infection persists in eastern Europe.
For the latest information on the distribution of CSF, refer to the WAHIS information database website of the World Organisation for Animal Health (WOAH).
Occurrences in Australia
Outbreaks occurred in Australia in 1903, 1927–28, 1942–43 and in 1960–61. In each case the disease was eradicated and Australia has been free of CSF since 1961.
Epidemiology
Modes of transmission
Transmission occurs via:
- direct contact with infected pigs—pigs with acute disease shed virus in high concentrations in all secretions and excretions. Respiratory infection can also occur between pigs in close contact. Moving infected pigs is the most important means of spread between piggeries. Heavily infected pigs excrete virus until they die and recovered animals excrete virus for 30 days. Feral pigs could become an important reservoir of the virus
- ingesting contaminated swill—CSF virus can survive for many months in raw, unprocessed, frozen meat as well as meat stored at fridge temperatures and in some processed hams. Ingesting pig meat or products containing the virus is an important means of spread. In Australia, we have strict import conditions to address the risk of a CSF incursion and swill feeding is illegal
- fomites—because of the stability of CSF virus in the environment, indirect contact by means of contaminated pig pens, vehicles and other fomites (such as hypodermic needles) is a very important means of spread of the disease
- contact with infected carcasses of pigs
- contact with infected faeces
- vectors—less commonly, bloodsucking insects feeding on viraemic pigs have been implicated in the mechanical spread of CSF
- semen and embryos—the virus is present in semen and can be transferred through breeding. Sows infected with low-virulence strains may continue to carry the virus in their foetuses because the virus can cross the placenta.
Disease dynamics
CSF virus:
- spreads in the nasal, lachrymal and saliva secretions of pigs as soon as 1 day after infection
- spread is possible during the incubation period (usually 2–6 days) and before the onset of clinical signs. Onset of shedding in faeces and urine occurs a few days later
- replication is detectable in the blood after 15–24 hours post-infection, which is concurrent with the occurrence of leukopenia and thrombocytopenia
- if infection occurs late in gestation, live piglets are occasionally born that remain chronically infected and continue to excrete the virus for several months before showing clinical disease.
Pigs that survive the acute disease or are infected by mild strains of the virus usually become chronically infected for at least 3–4 weeks post-infection. However, such pigs do not readily excrete the virus for more than about 5–6 weeks after initial infection and their role in the spread of the disease after that is unclear.
The chronic and subclinical forms usually last three months and consist of three distinguished phases:
- the early phase (2–3 weeks post-infection) is similar to the acute form of CSF
- the second phase (3–6 weeks post-infection) is characterised by convalescence with an increased neutralising antibody response and decreased levels of virus in the blood. Virus shedding is not affected by these changes
- the third phase is characterised by the reappearance of clinical signs with increased viral replication and death.
Persistence of the agent
CSF virus:
- can persist in contaminated pig pens and on other fomites for up to 2 weeks, depending on environmental conditions and the amount of infectious virus present
- is susceptible to ether and other lipid solvents, and inactivated by chlorine-based disinfectant. Sodium hydroxide (2%) is considered suitable for disinfecting premises.
Diagnosis and pathology
Clinical signs
CSF is an extremely variable disease and you cannot diagnose it based on clinical signs and gross pathology alone. Disease may be acute, subclinical or chronic.
In the acute form most pigs die between 10–20 days post-infection. Clinical signs for the acute form include:
- pyrexia (above 39.5°C, and as high as 42 °C)
- hyperaemia or cyanosis of extremities, particularly ears and snout, which can present as red or purple skin blotching on the ears, snout limbs and abdomen
- loss of appetite or irregular appetite
- inability or unwillingness to stand up, convulsions
- incoordination, stiff gait
- huddling together, piling one on top of another
- laboured breathing, coughing
- dysentery or diarrhoea
- conjunctivitis
- nasal discharge
- vomiting
- abortion, mummifications, stillbirth and foetal abnormalities
- severe leucopoenia
- death (case fatality rate up to 100 per cent).
In the subclinical disease form, pigs may become chronic carriers without showing any of the clinical signs listed. This is most likely to occur when strains of low virulence infect older breeding animals or when piglets are infected in utero.
In the chronic disease form, clinical signs are as for the acute form but generally milder and persisting longer (3–4 weeks). They include:
- pyrexia which may fluctuate irregularly
- ill-thrift
- pneumonia
- loss of appetite
- diarrhoea
- alopecia and dermatitis
- death—often due to secondary bacterial infections
- lower case fatality rate than the acute form.
Pathology
With the acute disease form, findings are:
- enlarged and haemorrhagic lymph nodes, often resembling blood clots (the gastrohepatic, renal, mesenteric and submandibular lymph nodes are most often affected)
- pinpoint haemorrhages on the tonsils (tonsils are frequently enlarged, with necrotic foci and pustules)
- pyramidal splenic infarcts along the margin
- haemorrhages in almost any organ (most commonly on serosal membranes and in kidneys as subcapsular petechiae or ‘turkey egg’ appearance, heart, urinary bladder, epiglottis, lung and gall bladder)
- septal oedema of lungs
- fluid in body cavities.
Findings for the chronic form are more variable than for the acute form, as they are often complicated by secondary bacterial infections. They include:
- lymph node and renal haemorrhage
- mucosal intestinal haemorrhage
- enlarged lymph nodes
- thymic atrophy
- fibrinous pericarditis and pleurisy
- lobular consolidation of lungs which may progress to lobular necrosis and bronchopneumonia
- poor body condition
- ulceration of the large intestine
- button ulcers, particularly near the ileocaecal valve.
Differential diagnosis
Many other viral and bacterial pathogens of pigs often confused with CSF may cause concomitant infections. It is important that you take into consideration that detection of other pathogens may mask an underlying CSF virus infection.
Consider in the differential diagnosis:
- exotic diseases
- African swine fever (do not attempt clinical differentiation of CSF and ASF)
- Aujeszky’s disease (respiratory signs)
- porcine reproductive and respiratory syndrome
- porcine deltacoronavirus
- porcine respiratory disease complex
- post-weaning multi-systemic wasting syndrome
- swine enteric coronavirus diseases such as those caused by porcine epidemic diarrhoea virus
- transmissible gastroenteritis
- endemic diseases
- acute salmonellosis (diarrhoea)
- acute septicaemia due to Streptococcus suis or Haemophilus parasuis (Glässer’s disease)
- border disease virus infection
- bovine viral diarrhoea virus infection
- erysipelas (haemorrhagic skin lesions)
- pasteurellosis (pneumonia)
- porcine circovirus-associated diseases (such as those seen in porcine dermatitis and nephropathy syndrome)
- non-infectious causes
- heavy metal poisoning
- salt poisoning with water deprivation
- warfarin poisoning (causing death with haemorrhages, generally sporadic)
- thrombocytopaenia purpura (haemorrhages, especially in pigs 2–3 weeks old)
- any cause of chronic ill-thrift in pigs.
Samples required
Submit at least five pigs for post-mortem examination, as individual animals may present with great variability in lesions. Record a composite picture of all lesions seen.
Sample collection
Collect samples from affected, especially pyrexic, pigs killed immediately before a post-mortem examination and from pigs that have recently died (including stillborn piglets and aborted foetuses). Collect:
- serum, 30 samples from suspected chronically infected animals
- EDTA blood (7–10 ml/animal) from live, clinically affected animals
- fresh tissue from the spleen, gastro-hepatic lymph node, mesenteric lymph node, tonsils, lung, kidney and ileum (2 g of each tissue)
- fixed tissue, a full range of tissues (including the brain) in neutral-buffered formalin.
Transport of samples
- chill blood samples and unpreserved tissue samples either at 4 °C or with frozen gel packs
- DO NOT FREEZE SAMPLES at -20 °C; it reduces the sensitivity when used for virus isolation and molecular diagnostic tests
- send samples with dry ice if the journey is expected to take several days
- formalin fixed tissue can be sent at room temperature.
Sample submission
The relevant state or territory laboratory should coordinate sample packaging and consignment for delivery to the Australian Centre for Disease Preparedness.
Diagnostic tests
The most rapid, sensitive and specific diagnostic procedure is the detection of viral nucleic acid in blood or in lymphoid tissue by qRT-PCR. A positive result can be obtained within one day of pyrexia first developing in an animal. In addition:
- commercial ELISA kits are available for detection of CSF virus antigen and antibody but are comparatively less sensitive than molecular techniques
- specific antibodies against CSF virus may be slow to appear due to the immunosuppressive nature of the disease
- viral antigen can be detected in frozen sections of tonsil, spleen or lymph node using direct immunofluorescence, and may yield a result in a matter of hours
- isolation of the virus is attempted by inoculation of blood or tissue suspensions into porcine kidney cell cultures
- because most strains of CSF virus do not produce recognisable cytopathic effects, viral growth is identified by immunolabelling methods such as fluorescent antibody or immunoperoxidase tests, or by qRT-PCR
- antibodies to border disease virus or bovine viral diarrhoea virus in pigs may confuse serological surveys for CSF. Cross-neutralisation tests for these and other relevant circulating pestiviruses need to be carried out to confirm CSF antibody.
Reporting requirements
CSF is an WOAH-listed disease and Australia has an international obligation to report cases.
If you suspect CSF, report it immediately. Call the Emergency Animal Disease Hotline on 1800 675 888, wherever you are in Australia. Alternatively, contact a government veterinarian in your state or territory.
Government duty veterinarians monitor the hotline and are available to advise you 24 hours a day, 7 days a week.
Biocontainment and personal protective equipment
There are no public health implications for CSF, but you should implement biocontainment protocols until advised by government veterinary authorities. This includes isolating suspected cases and using and appropriately disposing of personal protective equipment such as gloves, coveralls and rubber boots (or disposable boots). Thoroughly disinfect and decontaminate clothing, vehicle and equipment before leaving the property.



Further information
Blome S, Staubach C, Henke J, Carlson J, Beer M. (2017) Classical Swine Fever-An Updated Review. Viruses. 9(4). pii: E86.
Elbers, A.R. Vos, J.H. Bouma, A., van Exsel, A.C., Stegeman A. (2003) Assessment of the use of gross lesions at post-mortem to detect outbreaks of classical swine fever. Veterinary Microbiology 96(4):345-356.
Schulz K, Staubach C, Blome S. (2017) African and classical swine fever: similarities, differences and epidemiological consequences. Veterinary Research. 48(1):84.
3.10 Contagious bovine pleuropneumonia
Fast facts
Contagious bovine pleuropneumonia (CBPP) is an exotic respiratory disease that primarily affects domestic cattle.
Organism
- CBPP is caused by the bacterium Mycoplasma mycoides subsp. mycoides, considered one of the most pathogenic Mycoplasma species.
- It is readily inactivated by common disinfectants, heat, and acid or alkali pH.
Susceptible species
- CBPP primarily affects domestic cattle (Bos taurus, Bos indicus).
- Other domestic and wild ruminants are susceptible to infection, including water buffalo (Bubalus bubalis), yak (Poephagus grunnien), sheep and goats.
Economic impact
There is potential for significant economic loss associated with high morbidity and mortality in cattle, as well as restrictions on animal movements and international trade.
Epidemiology
- The incubation period of CBPP can be between 3 weeks and 6 months. It is relatively short in intensive production systems.
- Mycoplasma mycoides subsp. mycoides can survive in pulmonary sequestra in chronically infected animals for up to 2 years.
- Vaccines are available for CBPP overseas, but successful use to control the disease depends on frequent revaccination.
Transmission
Transmission occurs by inhalation of aerosolised respiratory secretions from infected cattle.
Clinical signs
Clinical signs include:
- fever and sudden death (peracute form)
- non-specific signs including high fever, depression, anorexia and reduced milk yield, followed by severe respiratory distress (acute form)
- in infected calves, arthritis and joint effusions, while severely affected cattle often die, usually within 3 weeks (acute form)
- non-specific signs such as ill thrift and recurrent low-grade fever (subacute and chronic forms).
Post-mortem
- Peracute cases: abundant pleural and pericardial effusion
- Acute to subacute stages: severe fibrinous bronchopneumonia and pleural effusion
- Chronic stages: pulmonary sequestra and pleural adhesions.
Samples
Collect:
- nasal swabs
- fluid from nasal discharge, bronchoalveolar lavage (BAL), transtracheal wash or pleural fluid
- synovial fluid from animals with arthritis and swollen joints
- fresh tissue of lung lesions and regional lymph nodes of the respiratory tract
- serum (ideally paired samples collected 3–8 weeks apart).
Actions to take
If you suspect a case of CBPP:
- call the Emergency Animal Disease Hotline (1800 675 888) immediately or contact a government veterinarian in your state or territory
- isolate suspected cases and implement biocontainment protocols (including farm movement controls) until advised by government veterinary authorities.
Introduction
Contagious bovine pleuropneumonia (CBPP) is a contagious exotic respiratory disease of ruminants caused by Mycoplasma mycoides subsp. mycoides. The disease is characterised by severe fibrinous bronchopneumonia and pleural effusion.
Disease agent and susceptible species
- CBPP is caused by Mycoplasma mycoides subsp. mycoides, a bacterium lacking a cell wall.
- The pathogen colonises the bronchioles and alveoli and then invades blood and lymphatic vessels.
- CBPP is a disease of ruminants, primarily infecting domestic cattle (Bos taurus, B. indicus).
- Other domestic and wild ruminants are susceptible to infection, including water buffalo (Bubalus bubalis), yak (Poephagus grunnien), sheep and goats, although these are not considered significant in disease epidemiology.
Public health considerations
Mycoplasma mycoides subsp. mycoides is not considered a zoonotic disease risk. It is safe to eat meat and drink milk from infected cattle.
Distribution
- CBPP is endemic in many areas of sub-Saharan Africa, including countries in the West, South, East and Central regions of Africa.
- A number of other countries are informally recognised as free of the disease due to lack of observed cases over considerable periods of time—particularly across Europe and the UK.
- While the disease has not been reported from further countries and regions outside sub-Saharan Africa, surveillance data are not considered sufficient to be confident of the absence of CBPP.
For the latest information on the distribution of CBPP, refer to the WAHIS information database website of the World Organisation for Animal Health (WOAH) or the FAO EMPRESi Global Animal Disease Information System.
Occurrences in Australia
CBPP was introduced into Australia in 1858. After an eradication campaign, Australia declared freedom from the disease in 1973 and is officially recognised as free of the disease by WOAH.
Epidemiology
Modes of transmission
- Transmission occurs primarily by direct contact via inhalation of aerosolised respiratory secretions and inhalation of droplets.
- Mycoplasma mycoides subsp. mycoides can also be found in saliva, urine, serum, foetal membranes and milk, but these are not considered epidemiologically significant routes of disease transmission.
- Fomites (e.g. contaminated pasture and feed; equipment) are not considered an important mode of disease transmission given the fragility of Mycoplasma spp. in the environment.
- Vertical transmission has been demonstrated experimentally via the placenta, but is not considered a significant transmission route.
Disease dynamics
- Domestic cattle are the only species with a significant role in CBPP epidemiology.
- Transmission of infection occurs most efficiently with prolonged and direct contact—cattle movement, congregation and shipping are important factors in disease spread.
- Cattle in the acute phase of the infection are particularly infectious.
- Cattle can be subclinically infected.
- Mycoplasma mycoides subsp. mycoides can survive in pulmonary sequestra in chronically infected animals for up to two years. Cattle with pulmonary sequestra may start shedding infection during periods of stress or immunosuppression. However, the epidemiological importance of cattle with pulmonary sequestra transmission is not clear.
- CBPP transmission over distances up to a few hundred metres via aerosolised droplets is possible but rare.
- The incubation period can range from 3 weeks to 6 months. Severely affected cattle often die, usually within 3 weeks.
- Morbidity rates can be influenced by factors such as age, genetics, population density, climate and stressors such as transport and handling.
- Morbidity and mortality rates associated with the infection can be high (up to 90 percent) in naïve populations, those under poor husbandry and in cases of the more virulent strains. In endemic areas, mortality tends to be low (< 10 percent) among well-managed populations, though an important cause of a loss of productivity.
- Vaccines are available overseas for Mycoplasma mycoides subsp. mycoides. Vaccination has been used successfully in CBPP disease control strategies through mass vaccination campaigns with suitable administration frequency (at least once a year for current vaccinations).
- Vaccination is the primary method of disease control given increasing resistance to antimicrobial therapy; nonetheless, targeted antimicrobial therapy can be an important component.
Persistence of the agent
CBPP:
- can survive in the environment for up to 2 weeks under optimal conditions, with longer survival in temperate climates compared to tropical climates
- can survive for more than 10 years in frozen conditions
- is susceptible to heat and inactivated within 60 minutes at 56°C and 2 minutes at 60°C
- is readily inactivated by many common disinfectants including sodium hypochlorite (1%), ethanol (70%), iodophores, glutaraldehyde and peracetic acid
- is inactivated by acidic or alkaline pH.
Diagnosis and pathology
Clinical signs
CBPP has four syndromic presentations—peracute, acute, subacute and chronic.
In the peracute form, clinical signs are:
- fever and sudden death fever.
In the acute form, clinical signs are typically non-specific and can include:
- high fever (up to 42°C)
- depression
- anorexia
- reduced milk yield
- severe respiratory distress (which may include coughing, purulent or mucoid nasal discharges, tachypnoea and dyspnoea)
- epistaxis, diarrhoea, abortion and stillbirth
- infected calves also commonly present with arthritis and joint effusions.
In the subacute to chronic form, clinical signs are typically non-specific and can include:
- ill thrift
- recurrent low-grade fever that may be difficult to recognise as pneumonia. This is the most common presentation in endemic areas.
Pathology
In the peracute form, findings include:
- pleural and pericardial effusion.
In the acute to subacute forms, findings include:
- lung consolidation with a marbled appearance, often unilateral and affecting the caudal lobes, which may progress to severe fibrinous bronchopneumonia and pleural effusion
- mediastinal and tracheobronchial lymphadenopathy
- lesions in the kidney characterised by infarcts in the renal cortex
- serofibrinous tenosynovitis of the carpal and tarsal joins of calves.
In the chronic form, findings include:
- pulmonary sequestra (large, well demarcated and odourless foci of necrosis with a fibrous capsule, usually without caseous necrosis or calcification)
- pleural adhesions.
Differential diagnosis
Consider in the differential diagnosis:
- exotic diseases
- theileriosis (East Coast fever)
- bovine tuberculosis
- rinderpest
- endemic diseases
- acute bovine pasteurellosis (Pasteurella multocida)
- haemorrhagic septicaemia
- bovine ephemeral fever
- echinococcosis
- actinobacillosis
- Mycoplasma bovis infection
- bovine nocardiosis
- bovine respiratory disease (bovine rhinotracheitis; bovine viral diarrhoea virus; Mannheimia haemolytica)
- navel ill in calves
- Non-infectious causes
- traumatic pericarditis.
Samples required
Sample collection
Collect these samples from clinically affected animals, using aseptic technique where possible to minimise contamination:
- nasal swabs, collected using an appropriate transport medium such as Amies or Charcoal swabs
- fluid, collected from nasal discharge, bronchoalveolar lavage (BAL), transtracheal wash or pleural fluid
- synovial fluid from animals with arthritis and swollen joints
- fresh tissue of lung lesions and regional lymph nodes of the respiratory tract. Lung lesions collected should be at the interface between diseased and normal tissue.
- serum, ideally paired samples collected 3–8 weeks apart. Please note serological tests are generally used on a herd level basis, and not for individual diagnosis.
Transport of samples
Samples should be kept as cool as possible throughout transport, avoiding multiple freeze–thaw cycles, as increased temperatures can significantly affect mycoplasma viability.
- Chill serum, swabs, fluid and unpreserved tissue samples at 4°C, or with frozen gel packs, and send to the laboratory within 24 hours.
- For longer periods of storage prior to submission, samples should be frozen at or below −20°C.
- Send the samples with dry ice if the journey is expected to take several days.
Sample submission
Send samples to the relevant state or territory laboratory, which will coordinate sample packaging and consignment for delivery to the Australian Centre for Disease Preparedness.
Diagnostic tests
For CBPP diagnosis, use:
- bacterial culture
- nucleic acid detection by polymerase chain reaction (PCR)
- serological tests—available tests include the complement fixation test (CFT), ELISA and immunoblotting test.
Reporting requirements
CBPP is notifiable in Australia. CBPP is a WOAH-listed disease and Australia has an international obligation to report confirmed cases. If you suspect CBPP, report the disease immediately by phoning the Emergency Animal Disease Hotline on 1800 675 888, wherever you are in Australia. Alternatively, contact a government veterinarian in your state or territory.
Biocontainment and personal protective equipment
There are no public health implications for CBPP, but you should implement biocontainment protocols until advised by government veterinary authorities. This includes isolating suspected cases and using and appropriately disposing of personal protective equipment such as gloves, coveralls and rubber boots (or disposable boots). Thoroughly disinfect and decontaminate clothing, vehicle and equipment before leaving the property.

Image credits: PIADC and CFSPH

Image credits: PIADC and CFSPH

Image credits: PIADC and CFSPH

Image credits: PIADC and CFSPH

Image credits: PIADC and CFSPH

Image credits: PIADC and CFSPH
Further information
Alhaji NB, Ankeli PI, Ikpa LT, Babalobi OO, 2020. Contagious bovine pleuropneumonia: challenges and prospects regarding diagnosis and control strategies in Africa. Veterinary Medicine: Research and Reports, 11, 71–85.
Di Teodoro G, Marruchella G, Di Provvido A, D’Angelo AR, Orsini G, Di Giuseppe P, Sacchini F, Scacchia M, 2020. Contagious bovine pleuropneumonia: a comprehensive overview. Veterinary Pathology, 57, 476–89.
Dudek K, Szacawa E, Nicholas RA, 2021. Recent developments in vaccines for bovine mycoplasmosis caused by Mycoplasma bovis and Mycoplasma mycoides subsp. mycoides. Vaccines, 9, 549.
3.11 Contagious caprine pleuropneumonia
Fast facts
Contagious caprine pleuropneumonia (CCPP) is an infectious, bacterial respiratory disease of goats.
Organism
- CCPP is caused by the bacterium Mycoplasma capricolum subsp. Capripneumoniae.
- It is readily inactivated in the environment by common disinfectants and heat.
Susceptible species
- CCPP primarily affects goats.
- Sheep and wild ungulates are also susceptible to infection.
Economic impact
CCPP is one of the most severe and highly infectious diseases of goats. It is expected that it would cause high morbidity and mortality in naïve goat flocks in Australia. The presence of the organism in Australia could also have trade impacts for goat and sheep exports.
Epidemiology
- CCPP is moderately infectious.
- The disease can have a long incubation period and a carrier state may exist.
- Outbreaks tend to result in high morbidity and high mortality in naïve populations, but lower morbidity and mortality in endemic areas.
Transmission
Transmission is via the respiratory route through inhalation of infected aerosols.
The infectious organism is spread through direct contact with infected goats and potentially infected sheep and wild ungulates.
Clinical signs
Clinical signs are associated with severe respiratory disease including dyspnoea, sero-mucoid to purulent nasal discharge, pyrexia and weakness.
Post-mortem
Consolidation of the lungs is the main gross pathological finding, often unilateral. Alveolar exudation, pleural fluid accumulation and pleural adhesions are also common.
Samples
Collect:
- nasal swabs
- fluid from nasal discharges, bronchoalveolar lavage or pleural fluid
- fresh tissue from lung lesions and regional lymph nodes of the respiratory tract
- serum (ideally paired samples collected 3–8 weeks apart).
Actions to take
If you suspect a case of contagious caprine pleuropneumonia:
- call the Emergency Animal Disease Watch Hotline (1800 675 888) immediately or contact a government veterinarian in your state or territory
- isolate suspected cases and implement biocontainment protocols (including farm movement controls) until advised by government veterinary authorities.
Introduction
Contagious caprine pleuropneumonia (CCPP) is caused by a bacteria, Mycoplasma capricolum subsp. capripneumoniae. It leads to severe respiratory disease in goats and has been recorded as occasionally causing disease in sheep in contact with infected goats. It can also cause disease in a number of wild cloven-hoofed ungulate species.
Disease agent and susceptible species
- CCPP is caused by Mycoplasma capricolum subsp. capripneumoniae, a bacterium lacking a cell wall. There are 6 genotypes (A to F) grouped into two clusters.
- CCPP is primarily a disease of goats.
- Many species of wild cloven-hoofed ungulates can also be infected, including wild goats (Capra aegagrus), Nubian ibex (Capra ibex nubiana), Laristan mouflon (Ovis orientalis laristanica), gerenuk (Litocranius walleri) and sand gazelle (Gazella marica).
- It is hypothesised that sheep can become infected when in close contact with diseased goats (Bölske et al., 1996, 1995; Litamoi et al., 1990). However, observed pathology in sheep may be attributable to concurrent Mycoplasma ovipneumoniae infection, rather than CCPP infection. While an immune response can occur and the organism can multiply in sheep, it is unclear whether the organism can persist in sheep long term.
Public health considerations
Mycoplasma capricolum subs. capripneumoniae is not considered a zoonotic disease risk. It is safe to eat meat and drink milk from infected animals.
Distribution
CCPP is widespread across the Middle East, Africa and Asia. New outbreaks are associated with movement of infected animals.
A definitive distribution is unknown, but:
- CCPP is endemic in parts of the Middle East, Asia and Africa (especially central and eastern Africa)
- sporadic outbreaks can be seen elsewhere in the world, including in the European Union (e.g. Greece in 2006 and Serbia in 2009).
- it has caused outbreaks in Malaysia in the past (2009–2010) but is not reported in South-East Asia at the time of writing.
- Oceania, the Americas and Europe are free of infection.
For the latest information on the distribution of CCPP, refer to the WAHIS information database website of the World Organisation for Animal Health (WOAH) or the FAO EMPRESi Global Animal Disease Information System.
Occurrences in Australia
Australia has not had an outbreak of CCPP.
Note that in 1977, Australia reported suspected CCPP to the OIE (now WOAH) due to identification of Mycoplasma mycoides subspecies capri in Australian goats. However, later investigations clarified that Mycoplasma mycoides subspecies capri is not an aetiological agent of CCPP (which is caused by Mycoplasma capricolum subsp. capripneumoniae).
Epidemiology
Modes of transmission
- Transmission occurs primarily by direct contact via inhalation of aerosolised respiratory secretions and inhalation of droplets. Aerosols have been assumed to be able to infect animals for distances of 50 m.
- While there are few well described outbreaks of CCPP, its similarity to contagious bovine pleuropneumonia (CBPP) causative agent Mycoplasma mycoides subsp. mycoides can be used to infer that fomites, vectors, animal products and environmental contamination are not considered important in transmission.
Disease dynamics
CCPP is infectious with high morbidity and mortality in an outbreak situation.
- The WOAH Terrestrial Animal Health Code states the incubation period as 45 days, but this is conservative for management of trade risks. Others have estimated the incubation period to be between 2 days and 4 weeks, and most commonly 6–10 days.
- The infectious period has been estimated at 19 days during modelling.
- Studies on disease prevalence in goat herds/populations in areas where the disease is endemic have estimated a prevalence range of 5–64% with estimates of 20–40% common.
- Under an outbreak scenario in a naïve population, there is generally high morbidity in exposed goats (80–100%). In endemic populations, morbidity can be considerably lower. Morbidity is influenced by breed, stressors and environmental conditions.
- In a naïve population, mortality may be up to 90%; as disease becomes endemic, the mortality rate declines and may be as low as 10%. Mortality varies depending on risk factors including age, breed and stressors including harsh environmental conditions.
- Cold, moist and overcrowded conditions can lead to increased pathogen survival and may result in greater transmission and more severe outbreaks.
- It is believed that some animals that recover clinically are chronic, latent carriers of infection; and antibiotic treatment may not prevent this latent carrier state.
- Veterinary therapeutics such as antibiotics and vaccines can be used to treat or prevent disease in animals in an endemic situation, but eradication likely requires a herd testing and culling program.
Persistence of the agent
CCPP:
- can survive in the environment for up to 14 days in cold, moist and humid environments, or up to 3 days in the tropics
- is readily inactivated by UV radiation
- can survive for 10 years in frozen pleural fluid
- can be inactivated with wide variety of disinfectants including bleach (10%), alcohol (70–90%) and iodophores.
Diagnosis and pathology
Clinical signs
CCPP has three syndromic presentations—peracute, acute and chronic.
In the peracute form, clinical signs can include:
- sudden death
In the acute form, clinical signs can include:
- high fever
- dyspnoea and tachypnoea
- pleurodynia
- coughing
- sero-mucoid to purulent nasal discharge
- anorexia
- depression
In the chronic form, clinical signs are typically non-specific and can include:
- general malaise
- emaciation.
Pathology
Findings include:
- consolidation of the lungs, often unilateral
- alveolar exudate, pleural fluid accumulation and pleural adhesions.
Differential diagnosis
Consider in the differential diagnosis:
- exotic diseases
- peste des petits ruminants (PPR)
- tuberculosis (Mycobacterium bovis, Mycobacterium caprae)
- chlamydia infection/enzootic abortion of ewes (Chlamydia abortus)
- endemic diseases
- pasteurellosis (Mannheimia haemolytica, Pasteurella multocida, Bibersteinia trehalosi)
- caprine arthritis-encephalitis (CAE) (caused by a retrovirus belonging to the subfamily Lentivirus)
- enzootic pneumonia (Mycoplasma ovipneumoniae)
- caseous lymphadenitis (CLA) (Corynebacterium pseudotuberculosis)
- viral pneumonia (various viruses, e.g. parainfluenza, respiratory syncytial virus)
- toxoplasmosis (Toxoplasma gondii)
- bacterial bronchopneumonia
- parasitism: lungworms (e.g. Dictyocaulus filaria, Muellerius capillaris, Protostrongylus rufescens); Haemonchus contortus (barber’s pole worm); acute fascioliasis
- anthrax
- plant poisoning
- white muscle disease (selenium deficiency)
- metabolic conditions; for example, hypomagnesaemia or hypocalcaemia
- clostridial disease
- coccidiosis
- listeriosis
- septicaemia (for example, salmonellosis).
Samples required
Sample collection
Collect these samples from clinically affected animals, using aseptic technique where possible to minimise contamination:
- nasal swabs, collected after cleaning the external nares, using appropriate transport medium such as Amies or Charcoal swabs
- fluid, collected from nasal discharges, bronchoalveolar lavage (BAL) or pleural fluid (approximately 10 mL)
- fresh tissue from lung lesions and regional lymph nodes of the respiratory tract. Lung lesions collected should be at the interface between diseased and normal tissue.
- serum, ideally paired samples, collected 3–8 weeks apart. Please note serological tests are generally used on a herd-level basis, and not for individual diagnosis, and may be useful for testing cohorts after an initial suspect index case.
Transport of samples
Samples should be kept as cool as possible throughout transport, avoiding multiple freeze–thaw cycles, as increased temperatures can significantly affect mycoplasma viability.
- Chill serum, swabs, fluid and unpreserved tissue samples either at 4°C, or with frozen gel packs, and send to the laboratory within 24 hours.
- For longer periods of storage prior to submission, samples should be frozen at or below −20°C.
- Send the samples with dry ice if the journey is expected to take several days.
Sample submission
The relevant state or territory laboratory should coordinate sample packaging and consignment for delivery to the Australian Centre for Disease Preparedness.
Diagnostic tests
For contagious caprine pleuropneumonia diagnosis, use:
- bacterial culture
- nucleic acid detection by polymerase chain reaction (PCR)
- serological tests—available tests include the complement fixation test (CFT), latex agglutination test (LAT) and ELISA.
- Serological testing can be challenging as animals in early phases of disease may not develop antibodies, or antibodies may only be detectable for a few weeks after clinical signs have developed. Chronically affected animals may not have any detectable antibodies.
- Cross-reactivity with other mycoplasmas may also occur.
Reporting requirements
CCPP is notifiable in Australia. CBPP is a WOAH-listed disease and Australia has an international obligation to report confirmed cases. If you suspect CCPP, report the disease immediately by phoning the Emergency Animal Disease Hotline on 1800 675 888, wherever you are in Australia. Alternatively, contact a government veterinarian in your state or territory.
Biocontainment and personal protective equipment
There are no public health implications for CCPP but you should implement biocontainment protocols until advised by government veterinary authorities. This includes isolating suspected cases and using and appropriately disposing of personal protective equipment such as gloves, coveralls, rubber boots (or disposable boots) and a mask. Thoroughly disinfect and decontaminate clothing, vehicle and equipment before leaving the property.

Image credits: Dr L. Manso-Silvan, French Agricultural Research Centre for International Development (CIRAD). Description: R. Ploeg and A. Karawita, CSIRO ACDP.

Image credits: Dr L. Manso-Silvan, CIRAD. Description: R. Ploeg and A. Karawita, CSIRO ACDP.

Image credits: Dr L. Manso-Silvan, CIRAD. Description: R. Ploeg and A. Karawita, CSIRO ACDP.

Image credits: Dr L. Manso-Silvan, CIRAD. Description: R. Ploeg and A. Karawita, CSIRO ACDP.

Image credits: Dr L. Manso-Silvan, CIRAD. Description: R. Ploeg and A. Karawita, CSIRO ACDP.
Further information
Anonymous, 2024. Listed Disease: Contagious Caprine Pleuropneumonia. World Organisation for Animal Health. Accessed online: https://www.woah.org/en/disease/contagious-caprine-pleuropneumonia/#:~:text=Contagious%20caprine%20pleuropneumonia%20(CCPP)%20is,polypnea%2C%20cough%20and%20nasal%20discharges 30 July 2024.
EFSA AHAW Panel (EFSA Panel on Animal Health and Welfare), More S, Bøtner A, Butterworth A, Calistri P, Depner K, Edwards S, Garin-Bastuji B, Good M, Gortazar Schmidt C, Michel V, Miranda MA, Nielsen SS, Raj M, Sihvonen L, Spoolder H, Stegeman JA, Thulke H-H, Velarde A, Willeberg P, Winckler C, Baldinelli F, Broglia A, Candiani D, Beltran-Beck B, Kohnle L and Bicout D, 2017. Scientific Opinion on the assessment of listing and categorisation of animal diseases within the framework of the Animal Health Law (Regulation (EU) No 2016/429): contagious caprine pleuropneumonia. EFSA Journal 2017;15(10):4996, 27 pp. https://doi.org/10.2903/j.efsa.2017.4996 ISSN: 1831-4732
Iqbal Yatoo M, Raffiq Parray O, Tauseef Bashir S, Ahmed Bhat R, Gopalakrishnan A, Karthik K, Dhama K, Vir Singh S. Contagious caprine pleuropneumonia - a comprehensive review. Vet Q. 2019 Dec;39(1):1-25. doi: 10.1080/01652176.2019.1580826. PMID: 30929577; PMCID: PMC6830973.
3.12 Duck viral enteritis (duck plague)
Fast facts
Duck viral enteritis (DVE) is an acute, severe, highly contagious viral infection of ducks, geese and swans characterised by haemorrhagic lesions, enteritis and sudden death. DVE is one of the most lethal infections in waterfowl, causing large-scale outbreaks and deaths.
Organism
DVE virus (DVEV):
- is also known as duck plague, Anatid herpes, eendenpest, entenpest and peste du canard
- is a herpes virus and can undergo latency and reactivation in carrier waterfowl
- can retain infectivity for up to 30 days at room temperature (22°C).
Field strains differ in severity and virulence, but all seem to be immunologically similar.
Susceptible species
Ducks, geese and swans are susceptible.
Economic impact
The potential for economic loss is linked to high morbidity and mortality, decreased egg production and hatchability, and restrictions on movements and international trade. DVE also causes mass mortalities in wild birds.
Epidemiology
- Waterfowl of all ages are susceptible, with adult birds experiencing the most severe disease.
- Sudden death can be a feature of DVE in adult birds.
- Open water sources shared by infected wild waterfowl and susceptible flocks are an important risk factor in the establishment and spread of DVE.
Transmission
Natural transmission occurs through contaminated water, but spread can also occur through:
- direct contact with infected birds
- indirect contact with virus-contaminated environments
- migratory waterfowl, which play a critical role in transmission within and between continents.
Clinical signs
Signs vary with species, age and viral strain. Common signs may include:
- prostration or reluctance to move
- drooping or ruffled plumage
- conjunctivitis and photophobia
- nervous signs, including ataxia and tremors
- decreased feed consumption
- extreme thirst
- watery or bloody diarrhoea
- sudden death without clinical signs.
Specific signs in ducklings (from 2–7 weeks old) are:
- dehydration
- weight loss
- blue beak
- blood-stained vent.
Post-mortem
Gross lesions may include:
- generalised haemorrhages and necrosis of the gastrointestinal mucosa and liver
- fresh blood in body cavities, gut, spleen, liver, heart and pericardium
- mucosal eruptions in the oral cavity, oesophagus, caeca and rectum, and in the cloaca in acute cases
- enlarged, pale liver with pinpoint haemorrhages and white necrotic foci
- severe congestion or haemorrhaging of lymphoid organs.
Samples
Collect these samples from clinically affected animals:
- fresh tissue from a full range of organs, including the liver, spleen, thymus and bursa of Fabricius
- cloacal swabs
- serum and blood (EDTA) if no other samples are available.
Actions to take
If you suspect a case of DVE:
- call the Emergency Animal Disease Hotline (1800 675 888) immediately or contact a government veterinarian in your state or territory
- isolate suspected cases and implement biocontainment protocols (including farm movement controls) until advised by government veterinary authorities.
Introduction
Duck viral enteritis (DVE), or duck plague, is an acute, highly contagious disease that causes high mortality and reduced egg production in domestic and wild waterfowl. The disease is characterised by haemorrhagic lesions, enteritis and sudden death, with greater severity observed in adult birds.
Disease agent and susceptible species
Duck viral enteritis virus (DVEV), or Anatid alphaherpesvirus-1:
- is an enveloped, double-stranded DNA virus belonging to the genus Mardivirus, family Herpesviridae
- all strains are antigenically and immunologically similar but differ in virulence; thus, the severity of infection varies according to the strain
- is immunologically distinct from other avian viruses, including fowl plague, Newcastle disease, duck hepatitis and other herpes viruses
- replicates primarily in the mucosa of the digestive tract, especially the oesophagus, and spreads to the bursa of Fabricius, thymus, spleen and liver
- enters a latent phase in preferred sites such as the trigeminal ganglion, lymphoid tissues and peripheral blood lymphocytes, with the virus capable of reactivation and periodic shedding for up to 4 years
- has the potential for cross-species transmission in a mixed-poultry species farming environment
- susceptible species include members of the family Anatidae of the order Anseriformes, such as domestic and wild ducks, geese, swans and, less commonly, other waterfowl species.
Public health considerations
DVEV does not infect humans.
Distribution
- DVE has a global distribution due to the role of migratory waterfowl.
- Outbreaks have been reported in Europe, Asia, North America and Africa.
For the latest information on the distribution of DVE, refer to the WAHIS information database website of the World Organisation for Animal Health (WOAH).
Occurrences in Australia
DVE has never occurred in Australia. A herpesvirus was isolated from domestic geese in Australia in 1989, with post-mortem and histopathology signs similar to DVE. However, the virus is considered antigenically and genomically distinct from DVE.
Epidemiology
Modes of transmission
Transmission occurs via:
- direct contact with infected birds. The virus is shed in faeces, and transmission primarily occurs via the faecal-oral route. Migratory waterfowl play a critical role in disease transmission.
- indirect contact with virus-contaminated environment, particularly water bodies (as the primary source) and food. Contaminated soil from decomposing infected carcasses may also contribute to the spread of the virus in the environment. Most outbreaks in domestic ducks have occurred in proximity to open-water bodies shared by free-flying waterfowl.
- vertical transmission, or transovarial transmission through eggs has been reported, but its significance in the disease cycle is unclear.
Disease dynamics
- DVE can occur in all age groups (from as young as 7 days), with more severe clinical disease and mortality observed in adult waterfowl.
- The incubation period ranges from 3 to 7 days.
- The disease course is usually acute and highly fatal, with death occurring within 5 days of overt signs. The disease course may also be chronic, and death rarely occurs in chronically infected flocks as they become partially immune to the virus.
- Morbidity and mortality ranges from 5 to 100 percent, depending on the bird species and virus strain.
- Recovered birds become latent carriers for up to 4 years and periodically excrete the virus in faeces, with reactivation considered responsible for outbreaks in domestic and migrating waterfowl populations. European seroprevalence surveys suggest that DVE is widespread among asymptomatic waterfowl.
- Recovered birds are immunosuppressed and secondary bacterial infections are commonly reported.
- Outbreaks in domestic flocks typically occur in locations closely associated with aquatic environments co-habited by wild waterfowl.
Persistence of the agent
DVEV:
- can survive for weeks in the environment under suitable conditions, where it can retain infectivity for up to 30 days at 22°C
- is inactivated after heating for 10 minutes at 56°C or 90–120 minutes at 50°C
- is inactivated rapidly beyond pH 3–11
- is sensitive to lipid solvents, ether, chloroform, phenol disinfectants and chlorine bleach.
Diagnosis and pathology
Clinical signs
Signs vary with species, age and viral strain. Older ducks are the most affected, with higher mortalities. DVE is usually acute, with many birds found dead without overt clinical signs. DVE may exhibit chronicity or latency.
In susceptible flocks, the first signs are often sudden, high mortality, with a significant drop in egg production in laying flocks. As infection progresses within a flock, more clinical signs are typically observed. Common clinical signs of DVE include:
- non-specific signs such as prostration or reluctance to move, drooping or ruffled feathers, depression, decreased feed consumption, extreme thirst, watery or bloody diarrhoea
- photophobia and conjunctivitis
- nervous signs including ataxia and tremors
- respiratory signs may be present, with birds emitting a hoarse chirp
- prolapse of the penis may be seen in male birds
- sudden death, peaking 5 days after clinical signs appear. Mortality can range from 5 to 100 percent.
Signs in ducklings (2–7 weeks) may include:
- non-specific signs such as dehydration and weight loss, conjunctivitis, ocular or nasal discharge
- cyanosis (blue coloured) of the beak
- blood-stained vent.
Pathology
DVE is a vascular disease with gross lesions characterised by vascular damage and haemorrhage in multiple organs. At post-mortem, adult ducks are typically in good body condition with no clinical signs. Gross lesions from DVE may include:
- generalised haemorrhages and necrosis of the gastrointestinal mucosa and liver with fresh blood in body cavities, gut, spleen, liver, heart and pericardium
- mucosal eruptions in the oral cavity, oesophagus, caeca and rectum, and in the cloaca in acute cases
- elevated, yellowish, crusted plaques and green and superficial scabs—scabs may be present in the oesophagus, along with distinctive annular bands
- petechial (pinpoint) haemorrhages and white necrotic foci in the liver, which may be enlarged and pale. The pancreas may have similar lesions.
- lymphoid organs, the site for viral replication, are severely affected. The bursa of Fabricius and the spleen may be enlarged and darkened from congestion, while the thymic lobes may have petechiation and atrophy. In ducklings, DVE lesions in the lymphoid tissues are more evident than lesions in other visceral organs.
- annular bands, necrosis and haemorrhage of the gut-associated lymphoid tissue may be visible in different parts of the intestine.
- the ovarian follicles may be deformed, discoloured and have haemorrhages, and ruptured yolk may be found in the abdominal cavity.
- petechial or larger haemorrhages in the myocardium and epicardium, giving a red ‘paint-brush’ appearance, is a characteristic lesion often observed in adult ducks.
Differential diagnosis
Birds chronically infected with DVE are vulnerable to concurrent bacterial infections, which may mask detection. Given the varied and non-specific spectrum of signs associated with the disease, DVE should be considered if corresponding clinical signs and pathology are observed in affected chickens.
Consider the following in the differential diagnosis:
- exotic diseases
- avian influenza
- virulent Newcastle disease (not commonly reported in ducks)
- duck hepatitis B virus
- endemic diseases
- fowl cholera (not commonly reported in ducks)
- fowl pox (not commonly reported in ducks)
- necrotic enteritis
- haemorrhagic enteritis
- coccidiosis
- infectious serositis (Riemerella anatipestifer)
- non-infectious
- toxicoses.
Samples required
Sample collection
Collect from clinically affected birds:
- fresh tissue, including liver, spleen, kidney, bursa of Fabricius, thymus, oesophageal or small intestinal lesions
- cloacal swabs, noting that shedding may be intermittent in infected waterfowl
- EDTA blood, if no other samples are available
- serum.
Transport of samples
For transport:
- collect swabs into viral transport media (VTM) or saline if other media is unavailable
- chill blood samples and unpreserved tissue samples at 4°C or with frozen gel packs
- DO NOT FREEZE SAMPLES at −20°C; it reduces the sensitivity when used for virus isolation and molecular diagnostic tests
- send samples with dry ice if transportation takes several days.
Sample submission
The relevant state or territory laboratory should coordinate sample packaging and consignment for delivery to the Australian Centre for Disease Preparedness.
Diagnostic tests
For DVE diagnosis, use:
- nucleic acid detection by real-time reverse transcription polymerase chain reaction (real-time RT-PCR)
- viral isolation
- available serological tests include ELISA and virus neutralisation test (VNT).
Reporting requirements
Infection with DVE is reportable in Australia. DVE is a WOAH-listed disease and Australia has an international obligation to report cases. If you suspect DVE, immediately report the disease by phoning the Emergency Animal Disease Hotline on 1800 675 888, anywhere in Australia. Alternatively, contact a government veterinarian in your state or territory.
Biocontainment and personal protective equipment
When investigating an outbreak of sudden death and vascular disease in waterfowl, it is important to seek advice from government veterinary authorities, noting biocontainment requires:
- the use and appropriate disposal of personal protective equipment such as gloves, coveralls, rubber boots (or disposable boots), safety glasses and masks
- isolation of suspected cases and sick birds
- exclusion of wild birds from the premises
- thorough disinfection and decontamination of clothing, vehicles and equipment before leaving the property.

Image credits: Dr Alejandro Banda, Mississippi Veterinary Research and Diagnostic Laboratory (MVRDL)

Image credits: Dr Alejandro Banda, Mississippi Veterinary Research and Diagnostic Laboratory (MVRDL)

Image credits: Dr Alejandro Banda, Mississippi Veterinary Research and Diagnostic Laboratory (MVRDL)

Image credits: Dr Alejandro Banda, Mississippi Veterinary Research and Diagnostic Laboratory (MVRDL)

Image credits: Dr Alejandro Banda, Mississippi Veterinary Research and Diagnostic Laboratory (MVRDL)

Image credits: Dr Alejandro Banda, Mississippi Veterinary Research and Diagnostic Laboratory (MVRDL)
Further information
Abdullatif TM, Ghanem IA and El Bakrey RMM (2021) ‘Duck viral enteritis in Egypt: isolation and detection of the circulating virus during outbreaks from 2016-2018’, Slovenian Veterinary Research, 58 (Suppl 24):21–31, doi:10.26873/SVR-1424-2021
Dhama K, Kumar N, Saminathan M, Tiwari R, Karthik K, Kumar MA, Palanivelu M, Shabbir MZ, Malik YS and Singh RK (2017) ‘Duck virus enteritis (duck plague) – a comprehensive update’, Veterinary Quarterly, 37(1):57–80, doi:10.1080/01652176.2017.1298885.
Kong J, Feng K, Zhao Q, Chen Y, Wang J, Chen S, Shao G, Liao L, Li Y, Xie Z, Zhang X and Xie Q (2022) ‘Pathogenicity and transmissibility studies on live attenuated duck enteritis virus vaccine in non-target species’, Frontiers in Microbiology, 13, doi:10.3389/fmicb.2022.979368.
Li N, Hong T, Li R, Guo M, Wang Y, Zhang J, Liu J, Cai Y, Liu S, Chai T and Wei L (2016) ‘Pathogenicity of duck plague and innate immune responses of the Cherry Valley ducks to duck plague virus’, Scientific Reports, 6(1):32183, doi:10.1038/srep32183.
3.13 Epizootic haemorrhagic disease
Fast facts
Epizootic haemorrhagic disease (EHD) is a vector-borne viral disease. Historically a disease of wild ruminants, EHD has become an emerging disease in cattle.
Organism
EHD virus (EHDV):
- has 7 recognised serotypes (1–2 and 4–8) of which 6 occur in Australia (but no clinical disease has been reported)
- has a strain called Ibaraki virus, which causes the Ibaraki disease of cattle in eastern Asia.
Susceptible species
EHD affects:
- most cervids but clinical disease is not reported in deer species introduced to Australia
- various wild and domestic ruminant species, which are susceptible to sub-clinical infection.
Economic impact
There is potential for significant economic loss associated with production losses and mortality in cattle or farmed deer, and restrictions on animal movement and international trade.
Epidemiology
Infection is most common during peak activity periods of Culicoides vectors. Persistent ruminant infection does not occur.
Transmission
The non-contagious virus is transmitted between ruminant hosts by haematophagous species of Culicoides biting midges.
Clinical signs
Most infections in cattle are subclinical. Peracute to chronic illness occurs in deer and clinical signs may include: pyrexia, severe and rapid oedema of the head and neck, hypersalivation, erosive and ulcerative lesions of the oral and oesophageal mucosa, weakness and respiratory distress.
Post-mortem
Post-mortem lesions are characteristic of systemic haemorrhagic disease, with petechiae, ecchymoses and haemorrhages in various mucosal and serosal surfaces, organs and tissues.
Samples
Collect:
- whole blood in EDTA tubes
- fresh spleen, lung and lymph nodes samples
- paired serum samples.
Actions to take
If you suspect a case of EHD:
- call the Emergency Animal Disease Hotline (1800 675 888) immediately or contact a government veterinarian in your state or territory
- isolate suspected cases and implement biocontainment protocols (including movement controls and protection of animals from vectors) until advised by government veterinary authorities.
Introduction
Epizootic haemorrhagic disease (EHD) is a vector-borne, non-contagious viral disease transmitted by Culicoides spp (haematophagous Culicoides midges). EHD causes a severe haemorrhagic disease of wild cervids in North America but is also recognised as an emerging disease in cattle overseas.
Disease agent and susceptible species
The EHD virus (EHDV):
- is a non-encapsulated, double-stranded RNA virus and a member of the Orbivirus genus of the family Reoviridae
- serogroup contains 7 recognised serotypes (numbered 1–2 and 4–8), 6 of which occur in Australia (serotypes 1, 2, 5, 6, 7, 8) but no clinical disease has been reported
- shares morphologic and structural similarities to other members of the Orbivirus genus (there are also epidemiological parallels with bluetongue virus through shared patterns of Culicoides spp. transmission) and shows immunological cross reactivity with bluetongue virus
- various wild and domestic ruminant species (including water buffalo) are susceptible to sub-clinical infection. In addition:
- most cervids are susceptible to infection but clinical disease is not known to occur in deer species in Australia
- sheep can be infected experimentally but rarely develop clinical signs, whereas goats may be susceptible to EHDV infection but their role as a host is uncertain
- the Ibaraki strain of EHDV serotype 2 causes Ibaraki disease in cattle in eastern Asia. This is not present in Australia.
Distribution
EHDV is found in Australia, Africa, North and South America, Asia and the Middle East.
Outbreaks of EHD in cattle have been reported in Japan, South Korea, Taiwan (Ibaraki disease syndrome), the United States, North Africa and countries bordering the European Union. In addition:
- there were few descriptions of EHD in cattle outside Asia until 2004, when outbreaks were reported on Reunion Island (located near Madagascar), followed by outbreaks in the Middle East in 2006, the Caribbean in 2011, and the United States in 2012
- cattle were the only domesticated animals affected during the outbreaks in the Caribbean and the Middle East
- bison, yaks, elk and sheep developed clinical signs during the 2012 outbreaks in the United States. The case fatality rates in most species are unknown, but deaths were reported in bison and yaks.
For the latest information on the distribution of EHD, refer to the WAHIS information database website of the World Organisation for Animal Health (WOAH).
Occurrences in Australia
In Australia:
- naturally occurring disease has not been observed in cattle, deer or other susceptible species
- though there have been no reports of clinical disease, the virus is regularly isolated in the Northern Territory and Queensland under the National Arbovirus Monitoring Program (NAMP)
- the distribution of EHDV is presumed to mirror bluetongue virus (BTV), so regions in Western Australia, Northern Territory, Queensland and New South Wales defined as BTV transmission zones by NAMP are regarded as zones of potential transmission for EHDV. It is assumed that incursions from overseas may occur in northern Australia due to long distance movement of Culicoides vectors on the wind, as is demonstrated for BTV. This may explain the greater diversity of EHDV serotypes (1, 2, 5, 6, 7 and 8) detected in the Northern Territory, while only serotypes 2, 5, 6 and 7 have been detected in Queensland.
Epidemiology
Modes of transmission
EHD is not contagious and is not transmitted by direct contact between animals.
Transmission occurs via:
- vectors—haematophagous Culicoides spp midges transmit the virus between ruminant hosts and disease transmission patterns are typically seasonal, corresponding with vector distribution and abundance (cattle may serve as temporary reservoir hosts)
- wind—implicated in the dispersal of infected Culicoides in some outbreaks
- reproductive material—being closely related to bluetongue virus, it is likely that the semen of viraemic bulls may sometimes contain EHDV.
Disease dynamics
EHD:
- virus replicates in the endothelial cells of lymphatic vessels
- is characterised in deer by an acute haemorrhagic disorder with a progressive thrombocytopenia
- viral incubation period lasts 5–10 days in deer and 2–10 days in cattle
- clinical signs develop in white-tailed deer (Odocoileus virginianus) about 7 days after exposure
- viraemia duration differs for each Australian EHDV serotype but typically ranges from 2–4 weeks.
Persistence of the agent
The virus:
- is stable in blood and tissue samples but sensitive to pH <6.0 and >8.0
- can be readily inactivated by acids and alkalis, sodium hypochlorite, 2% weight per volume glutaraldehyde, acids, iodophores and phenolic compounds (but like other non-enveloped RNA virus it is resistant to lipid solvents such as ether and chloroform, and resistant to ultraviolet and gamma irradiation)
- can also be inactivated at temperatures of 50 °C for 3 hours, 60 °C for 15 minutes and 121 °C for 15 minutes.
Diagnosis and pathology
Clinical signs
In deer, peracute to chronic illness occurs and clinical signs may include:
- pyrexia, severe and rapid oedema of the head and neck, hypersalivation, erosive and ulcerative lesions of the oral and oesophageal mucosa, weakness and respiratory distress
- anorexia, muscle weakness, lameness, tachypnoea and tachycardia, and haemorrhagic nasal discharge.
Experimental infection of cattle with Australian EHDV strains has not resulted in clinical signs; however, these signs have been recorded overseas:
- pyrexia
- anorexia and hypersalivation
- dehydration and emaciation
- lameness associated with coronitis
- erosive and ulcerative lesions of the oral and oesophageal mucosa
- dysphagia is considered pathognomonic for Ibaraki disease (associated with striated muscle damage to the pharynx, larynx, tongue and oesophagus)
- abortions and stillbirths (foetal hydranencephaly).
Pathology
Post-mortem lesions are characteristic of systemic haemorrhagic disease, with petechiae, ecchymoses and haemorrhages in various mucosal and serosal surfaces, organs and tissues.
In deer, you may see:
- extensive haemorrhages on the serosal surfaces of the intestine and rumen
- erosions and ulcerations in the mouth, rumen, and omasum
- dry, grey-white necrotic lesions of the hard palate, tongue, dental pads, oesophagus, larynx, rumen, and abomasum
- sloughing of the tips or walls of the hooves
- lungs may be oedematous and cyanotic.
In cattle, you may see:
- degeneration of the striated muscles in the oesophagus, larynx, pharynx, tongue, and skeletal muscles (pathognomonic lesions for Ibaraki disease)
- marked oedema and haemorrhages in the mouth and lips, abomasum, and around the coronets
- erosions or ulcerations in the oral cavity, rumen and omasum
- emaciated and dehydrated carcass.
Differential diagnosis
Depending on the species and predominant clinical signs, consider in the differential diagnosis:
- exotic diseases
- bluetongue disease (infection present in Australia but without clinical disease) (affects cattle and deer)
- foot-and-mouth disease (affects cattle and deer)
- vesicular stomatitis (affects cattle and deer)
- endemic diseases
- bovine viral diarrhoea (BVDV-1) ) (affects cattle)
- bovine ephemeral fever (affects cattle)
- infectious bovine rhinotracheitis (affects cattle)
- malignant catarrhal fever (sheep-associated viruses are present in Australia but clinical disease in cattle is rare) (affects cattle)
- non-infectious diseases
- photosensitisation (affects cattle and deer)
- plant poisoning (affects cattle and deer)
- other causes of lameness (affects cattle and deer).
Samples required
Sample collection
Collect:
- serum from at least 10 live, clinically affected animals, and from exposed animals (particularly those that are convalescent)
- paired serum samples if possible
- EDTA blood (10 ml/animal) from live, clinically affected animals
- other samples, fresh spleen, lung, and lymph nodes (2 g of each tissue) from recently dead affected animals.
Transport of samples
For transport:
- chill blood samples at 4 °C with frozen gel packs
- DO NOT FREEZE SAMPLES at -20 °C; it reduces the sensitivity when used for virus isolation and molecular diagnostic tests
- send samples with dry ice if the journey is expected to take several days.
Sample submission
The relevant state or territory laboratory should coordinate sample packaging and consignment for delivery to the Australian Centre for Disease Preparedness.
Diagnostic tests
EHDV can readily be detected by direct detection of genome with molecular assays and isolation of virus or indirectly through the detection of group or type-specific antibodies. The diagnostic tests available in Australia include virus isolation, virus neutralisation, agarose gel immunodiffusion and ELISA.
Reporting requirements
EHD is an WOAH-listed disease and Australia has an international obligation to report cases.
If you suspect EHD, report it immediately. Call the Emergency Animal Disease Hotline on 1800 675 888, wherever you are in Australia. Alternatively, contact a government veterinarian in your state or territory.
Government duty veterinarians monitor the hotline and are available to advise you 24 hours a day, 7 days a week.
Biocontainment and personal protective equipment
There are no public health implications for EHD, but you should implement biocontainment protocols until advised by government veterinary authorities. This includes isolating suspected cases (and protecting from vectors, if possible) and using and appropriately disposing of personal protective equipment such as gloves, coveralls and rubber boots (or disposable boots). Thoroughly disinfect and decontaminate clothing, vehicle and equipment before leaving the property.

Further information
Maclachlan, N.J., Zientara S., Savini G., & Daniels P.W. (2015) Epizootic haemorrhagic disease. Revue Scientifique et Technique (O.I.E.). 34(2), 341-51.
Savini, G., Afonso, A., Mellor, P., Aradaib, I. A. O., Yadin, H., Sanaa, M., & Domingo, M. (2011). Epizootic heamorrhagic disease. Research in veterinary science, 91(1), 1-17.
Temizel, E., Yesilbag, K., Batten, C., Senturk, S., Maan, N.S., Mertens, P., Batmaz, H. (2009). Epizootic Hemorrhagic Disease in Cattle, Western Turkey. Emerging infectious diseases. 15. 317-9.
3.14 Equine influenza
Fast facts
Equine influenza (EI) is an acute, highly contagious exotic viral disease which can cause respiratory disease in horses and other equids.
Organism
EI virus:
- has two subtypes that infect horses—H3N8 and H7N7
- inactivated by ultraviolet light and most disinfectants.
Susceptible species
EI affects:
- horses and other equids
- dogs (this chapter will only address infection in horses).
Economic impact
There is potential for significant economic loss associated with high morbidity if the disease became established, as well as potential restrictions on international trade. The 2007 Australian outbreak cost an estimated AUD$1 billion.
Epidemiology
EI:
- has an incubation period of 18 hours to 5 days
- infected animals can shed virus for 7–10 days.
- causes very high morbidity but low mortality
Transmission
Transmission occurs via:
- direct contact with infected animals or fomites
- droplets (droplets >10 μm)
- aerosol (droplets <5 μm).
Clinical signs
Clinical signs include:
- pyrexia (up to 42 °C)
- serous nasal discharge
- dry cough.
Post-mortem
Since the disease causes very low mortality post-mortem is unlikely.
Samples
Collect:
- blood samples (EDTA and plain tubes)
- swabs (nasopharyngeal or nasal) or nasal wash samples in adults
- nasal swabs from foals.
Actions to take
If you suspect a case of EI:
- call the Emergency Animal Disease Hotline (1800 675 888) immediately or contact a government veterinarian in your state or territory
- isolate suspected cases and implement biocontainment protocols (including farm movement controls) until advised by government veterinary authorities.
Introduction
Equine influenza (EI) is a highly contagious disease equids causing upper respiratory tract infection.
Disease agent and susceptible species
Equine influenza virus (EIV):
- is a member of the Influenza virus type A genus, in the Orthomyxoviridae family
- is not known to infect humans
- infects horses and other equids and transmission to dogs has been reported (this chapter will only address infection in horses)
- is more stable than human influenza viruses; however, point mutations in the haemagglutinin and neuraminidase genes can cause significant changes in the antigenicity of the virus
- has two subtypes that infect horses—H3N8 and H7N7—and both are believed to have evolved from avian influenza virus ancestors. The H3N8 subtype circulates widely whereas the H7N7 subtype was last detected in 1979.
Distribution
EI:
- outbreaks have been reported all over the world with the exception of a small number of island nations including New Zealand and Iceland
- is endemic in Europe (except Iceland), North and South America, North Africa and Asia.
For the latest information on the distribution of EI, refer to the WAHIS information database website of the World Organisation for Animal Health (WOAH).
Occurrences in Australia
Australia had its first outbreak in 2007, but the disease was eradicated and Australia was declared free of EI in 2008.
Epidemiology
Modes of transmission
Transmission occurs via:
- direct contact with infected horses—respiratory infection can occur between horses in close contact, and outbreaks of disease occur most often when you congregate susceptible animals and house them in close contact with each other
- droplet transmission—droplets greater than 10 μm are projected over moderate distances by coughing and sneezing
- airborne transmission—droplet nuclei are greater than 5 μm and capable of wide dissemination, and reaching the lower respiratory tract. Windborne spread of several kilometres has been reported anecdotally; however, evidence supporting this is inconclusive and alternative transmission routes (such as by fomites) play a larger role in the epidemiology
- fomites—such as clothing, horse equipment, people, buildings that have recently housed sick horses, vehicles, floats, grooming and veterinary instruments. Depending on environmental conditions (humidity, temperature, exposure to sun light), the virus can remain infectious for days on contaminated surfaces and objects.
Disease dynamics
EI:
- may occur at any time of the year
- infects horses of all ages, though disease is generally mild in young foals
- incubation period can range from 18 hours to 5 days, dependent on level of exposure
- live virus shedding is variable and can persist for 7–10 days, and viral RNA is detectable by PCR for up to 15 days.
Persistence of the agent
EI virus:
- survival depends on environmental conditions and the amount of infectious virus present
- can persist for up to 48 hours on hard non-porous surfaces (such as stainless steel and plastic) and 12 hours on porous surfaces (such as clothing and paper)
- can survive in tap and canal water for up to 2 weeks
- is inactivated by exposure to ultraviolet light for 30 minutes, by heating at 50 °C for 30 minutes, by acid (pH 3) treatment and exposure to sunlight for 15 minutes at 15°C also inactivates the virus
- is inactivated by most disinfectants (including citric acid, and Virkon®) suitable for disinfecting surfaces and equipment (providing organic material has been first removed)
- In endemic countries, vaccinated horses can represent an important source of infection because of the occurrence of subclinical disease with viral shedding.
Diagnosis and pathology
Clinical signs
Signs include:
- rapid onset pyrexia (up to 42 °C)
- serous nasal discharge
- a persistent, harsh, dry cough
- mild swelling of the submandibular lymph nodes
- dull attitude
- loss of appetite
- fatigue
- myalgia
- limb oedema
- vaccination can reduce the incidence, severity and duration of clinical signs.
Pathology
Gross and microscopic lesions are not highly specific. There may be hyperaemia or inflammation of the mucosa of the upper respiratory tract.
Differential diagnosis
Consider in the differential diagnosis:
- endemic diseases
- equine adenovirus
- equine rhinitis
- equine rhinopneumonitis (equine herpesvirus 1 and 4 infection)
- equine viral arteritis (infection present with no clinical disease)
- Hendra virus infection
- infection with Streptococcus zooepidemicus, Streptococcus pneumoniae, Streptococcus zooepidemicus subspecies equi (strangles)
- parasitic infections, including ascarids and lungworms
- pasteurellosis
- non-infectious causes
- inflammatory airway disease due to exposure to environmental irritants and allergens.
Samples required
Sample collection
Collect:
- EDTA blood, from live, clinically affected animals (7–10 ml/animal)
- swab samples (nasopharyngeal or nasal swabs in adults; nasal swabs in foals under 6 months of age) or nasal washes containing both mucosal cells and nasopharyngeal secretions, as soon as possible after onset of clinical disease (preferably within 24–48 hours).
Transport of samples
For transport:
- swab samples should be placed in virus transport media containing antibiotics and antifungals (or saline if other media is unavailable)
- chill blood samples and unpreserved tissue samples at 4 °C, or with frozen gel packs
- DO NOT FREEZE SAMPLES at -20 °C; it reduces the sensitivity when used for virus isolation and molecular diagnostic tests
- send samples with dry ice if the journey is expected to take several days.
Sample submission
The relevant state or territory laboratory should coordinate sample packaging and consignment for delivery to the Australian Centre for Disease Preparedness.
Diagnostic tests
For EI:
- the most rapid, sensitive and specific diagnostic procedure is the detection of viral nucleic acid in blood or nasal secretions by qRT-PCR
- serology is available for the determination of acute and convalescent antibody titres using an ELISA and/or haemagglutination inhibition tests
- isolation of the virus is attempted by inoculation of nasal or nasopharyngeal swab samples into cell cultures (typically Madin-Darby canine kidney cells and embryonated chicken eggs).
Reporting requirements
EI is an WOAH-listed disease and Australia has an international obligation to report cases.
If you suspect EI, report it immediately. Call the Emergency Animal Disease Hotline on 1800 675 888, wherever you are in Australia. Alternatively, contact a government veterinarian in your state or territory.
Government duty veterinarians monitor the hotline and are available to advise you 24 hours a day, 7 days a week.
Biocontainment and personal protective equipment
There are no public health implications for EI, but you should implement biocontainment protocols until advised by government veterinary authorities. This includes isolating suspected cases and using and appropriately disposing of personal protective equipment such as gloves, coveralls and rubber boots (or disposable boots). Thoroughly disinfect and decontaminate clothing, vehicle and equipment before leaving the property.
Further information
Cullinane A, Newton JR. (2013) Equine influenza—A global perspective. Veterinary Microbiology. 167(1-2):205-14.
Landolt GA. (2014) Equine influenza virus. Veterinary Clinics of North America Equine Practice. 30(3):507-22.
Paillot, R. (2014). A Systematic Review of Recent Advances in Equine Influenza Vaccination. Vaccines, 2(4): 797–831.
3.15 Equine piroplasmosis
Fast facts
Equine piroplasmosis is a blood-borne protozoal disease that infects horses and other equids. It is primarily a tick-borne disease.
Organism
Equine piroplasmosis:
- is also referred to as equine malaria, horse tick fever, anthrax fever and equine biliary fever
- is caused by protozoan parasites belonging to the genera Babesia and Theileria. Both protozoa are obligate intracellular pathogens and cannot survive outside of the equid host or tick vector.
Susceptible species
Horses, mules, donkeys and zebras are susceptible.
Economic impact
There is potential for significant economic losses associated with restrictions on animal movements, control and eradication and international trade.
Epidemiology
Equine piroplasmosis:
- is commonly found in tropical and subtropical countries
- is maintained in the tick reservoir (B. caballi) and the horse reservoir (T. equi)
- has an incubation period of 12–19 days for T. equi and approximately 10–30 days for B. caballi
- carrier states can occur in susceptible equids
- is spread to new areas via the movement of infected equids or the introduction of infected ticks
- mortality rates in endemic areas are 5–10% and over 50% for non-endemic areas or naïve animals introduced to an endemic area.
Transmission
Transmission occurs via:
- tick vectors
- fomites contaminated with blood such as needles and veterinary equipment.
- transplacental transmission.
Clinical signs
Affected animals may present as non-clinical, peracute, acute, subacute or chronic. Clinical signs may vary depending on the presentation but are usually associated with the consequences of anaemia. Clinical signs may include:
- fever (40°C)—this may be intermittent
- icterus, anaemia, oedema of the limbs
- anorexia, weight loss, malaise, poor exercise tolerance
- colic with constipation or diarrhoea
- dehydration and emaciation
- splenomegaly, which is palpable per rectum.
Post-mortem
Gross lesions are generally associated with the effects of anaemia. These may include:
- icterus, oedema of subcutaneous and subserosal tissue, ascites, hydrothorax, hydropericardium
- catarrhal enteritis
- organomegaly
- epicardial and endocardial haemorrhages
- congestions and oedema of the lungs.
Samples
Collect:
- blood (EDTA and plain tubes)
- blood smears from superficial skin capillaries, or organ smears, during the acute phase of the disease.
Actions to take
If you suspect a case of equine piroplasmosis:
- call the Emergency Animal Disease Hotline (1800 675 888) immediately or contact a government veterinarian in your state or territory
- isolate suspected cases and implement biocontainment protocols, including farm movement controls and protection of animals from vectors until advised by government veterinary authorities.
Introduction
Equine piroplasmosis is a tick-borne protozoal disease affecting equids.
Disease agent and susceptible species
- Equine piroplasmosis is caused by Babesia caballi and Theileria equi and is primarily transmitted by ixodid ticks from the genera Dermacentor, Hyalomma, and Rhipicephalus.
- Horses, mules, donkeys and zebras are susceptible.
- B. caballi replicates exclusively in the erythrocytes of the mammalian host. T. equi initially develops in lymphocytes before entering erythrocytes.
- Reservoirs differ for the two species—B. caballi is maintained within ticks through different life stages and is capable of transstadial and transovarial transmission. Horses and zebras are the reservoir for T. equi, which can also undergo transstadial transmission.
- Nucleic acids of T. equi and B. caballi have also been detected in dromedary camels and dogs. Clinical disease in dogs is thought to occur sporadically, but the clinical significance in camels is still under investigation.
Public health considerations
There have been no confirmed human infections from B. caballi. T. equi has been implicated in rare human cases. Sero-reactive antibodies to both protozoal species have been detected in humans exposed to tick bites, including veterinarians. However, B. caballi and T. equi are not considered a public health risk.
Distribution
Equine piroplasmosis:
- is associated with the distribution of competent tick vectors
- is endemic in most tropical and subtropical countries, including in South America, Africa, and Asia
- is present in Portugal, Spain, France and Italy and endemic in the Balkan Peninsula, Hungary, Romania, southern Russia and the Caucasus region
- is currently not found in Australia, New Zealand, Canada, Japan, parts of Europe, and the United States of America.
For the latest information on the distribution of equine piroplasmosis, please refer to the WAHIS information database website of the World Organisation for Animal Health (WOAH) or the FAO EMPRESi Global Animal Disease Information System.
Occurrences in Australia
Equine piroplasmosis was detected in Australia between the 1950s and 1970s. It never became endemic and was thought to be transmitted via contaminated needles and surgical instruments. A competent vector, Rhipicephalus (formerly Boophilus) microplus, is present in Australia and could play a role in maintaining the disease if it were to enter. Rhipicephalus sanguineus is present in Australia and has been shown to be a competent vector in experimental settings.
Epidemiology
B. caballi can persist in tick populations in the absence of a suitable equid host. Equids infected with T. equi can be carriers for life, serving as a source of infection for tick vectors and facilitating the transmission and introduction of the disease into new areas and to naïve horses.
Modes of transmission
Transmission occurs via:
- biological vectors—by ticks from the Dermacentor, Hyalomma, and Rhipicephalus genera
- fomites through contaminated needles or surgical equipment
- blood transfusion with contaminated blood
- transplacental infection.
Disease dynamics
- Mortality rates differ between endemic and non-endemic areas. In endemic areas, it may be 5–10%. In non-endemic areas, or when naïve animals are introduced to an endemic area, mortality rates may exceed 50%.
- Both protozoa share the same tick hosts.
- Ticks are a reservoir for B. caballi—the protozoa persist throughout the different generations of the tick lifecycle, and transovarial transmission can occur in some species (Rothschild 2013).
- Horses infected with T. equi remain carriers for life and act as a disease reservoir.
- B. caballi infection may be self-limiting, although it can persist for several years.
- Non-clinical carriers (T. equi and B. caballi) are reservoirs for future transmission to ticks and other equids.
Persistence of the agent
- Neither B. caballi nor T. equi can survive outside the equid or tick host. Despite poor survivability outside of the host, equipment contaminated with blood should be sterilised or disposed of appropriately—new needles and hubs should be used between horses when taking blood samples.
- Infected equids can become carriers.
Diagnosis and pathology
Clinical signs
The clinical signs of equine piroplasmosis are non-specific and may present as peracute, acute, subacute or chronic. Some cases may also appear as non-clinical carriers.
Non-clinical carriers may have a low level of parasitaemia with no obvious clinical signs. Clinical signs may include:
- compromised athletic performance
- abortions, stillbirths or neonatal piroplasmosis.
Peracute cases are commonly seen in neonates infected in utero. Clinical signs may include:
- weak foal at birth
- rapid onset of listlessness and malaise
- fever
- anaemia, severe icterus and petechiae of mucous membranes
- difficulty standing and suckling
- haemoglobinuria.
In adult horses, peracute clinical signs are related to the organ systems affected by the damaged erythrocytes (B. caballi) or severe anaemia (T. equi), which can lead to death.
The acute form of the disease is most common. Clinical signs typically include:
- high fever (> 40°C)—intermittent in T. equi
- anorexia
- malaise and frequent recumbency
- dehydration and signs of colic with drier faecal balls
- congested mucous membranes
- tachypnoea, tachycardia
- sweating
- limb oedema, supraorbital oedema and lacrimation
- anaemia
- icterus, haemoglobinuria, bilirubinuria—less common with B. caballi
- death.
The subacute form of the disease is characterised by the following clinical signs:
- anorexia and weight loss
- malaise
- intermittent pyrexia
- anaemia
- limb oedema
- poor performance / reduced exercise tolerance
- tachycardia and tachypnoea
- mucous membranes may be pale pink, pale yellow or bright yellow. Petechial or ecchymotic haemorrhages may be present.
- intermittent colic with constipation followed by diarrhoea
- splenomegaly that may be palpable per rectum
- haemoglobinuria.
The chronic form of the disease is characterised by non-specific clinical signs that may be confused with equine infectious anaemia (caused by infection with a lentivirus of the same name). These may include the following:
- mild inappetence
- poor performance
- weight loss
- poor body condition
- malaise
- mild anaemia.
Pathology
Post-mortem findings may vary depending on the clinical course of the disease and key organ systems involved. The following may be found:
- thin, watery blood and effusions
- icterus
- oedema of subcutaneous and subserosal tissue
- catarrhal enteritis
- hepatomegaly
- splenomegaly
- renomegaly with discolouration (pale to red-brown)
- ascites, hydrothorax, hydropericardium
- epicardial and endocardial haemorrhages
- congestions and oedema of the lungs
- lymphadenopathy.
Clinical pathology may include:
- haematocrit of 20%, potentially 10%
- elevated unconjugated bilirubin
- thrombocytopaenia
- neutropaenia and lymphopaenia
- decreased plasma fibrinogen, serum iron and phosphorus
- prolonged clotting times.
Differential diagnosis
- exotic
- surra
- equine infectious anaemia
- dourine
- African horse sickness
- endemic
- purpura haemorrhagica
- non-infectious
- plant toxicity
- chemical toxicity.
Samples required
Sample collection
Collect these samples from clinically affected animals:
- serum
- EDTA blood
- blood smears prepared immediately after collection (thick and thin), ideally collected from superficial skin capillaries, or organ smears, during the acute phase of the disease.
Transport of samples
For transport:
- chill blood samples and unpreserved tissue samples at 4°C, or with frozen gel packs
- DO NOT FREEZE SAMPLES at −20°C; it reduces the sensitivity when used for molecular diagnostic tests
- send samples with dry ice if the journey is expected to take several days.
Sample submission
The relevant state or territory laboratory should coordinate sample packaging and consignment for delivery to the Australian Centre for Disease Preparedness.
Diagnostic tests
For equine piroplasmosis diagnosis:
- serological tests available include indirect fluorescent antibody test (IFAT) and various competitive ELISAs (C-ELISA)
- nucleic acid detection includes polymerase chain reaction (PCR)
- microscopic examination of blood smears may detect the presence of parasites in the acute phase of disease.
Reporting requirements
Equine piroplasmosis is reportable in Australia. Equine piroplasmosis is a WOAH-listed disease, and Australia has an international obligation to report cases. If you suspect equine piroplasmosis, report the disease immediately by phoning the Emergency Animal Disease Hotline on 1800 675 888, anywhere in Australia. Alternatively, contact a government veterinarian in your state or territory.
Biocontainment and personal protective equipment
There are no known public health implications for equine piroplasmosis, but you should implement biocontainment protocols until advised by government authorities. This includes isolating suspected cases and using and appropriately disposing of personal protective equipment such as gloves, coveralls and rubber boots (or disposable boots). All sharps and blood collecting equipment including vacutainer hubs should also be disposed of properly. Livestock managers should be advised to enact a vector management plan to protect any susceptible animals remaining on the property. Thoroughly disinfect and decontaminate clothing, vehicles and equipment before leaving the property.

Image credits: The Center for Food Security & Public Health

Image credits: The Center for Food Security & Public Health

Image credits: The Center for Food Security & Public Health
Image credits: National Research Center for Protozoan Diseases, Obihiro University of Agriculture and Veterinary Medicine
Image credits: National Research Center for Protozoan Diseases, Obihiro University of Agriculture and Veterinary Medicine
Further information
Onyiche TE, Suganuma K, Igarashi I, Yokoyama N, Xuan X and Thekisoe O (2019) ‘A review on equine piroplasmosis: Epidemiology, vector ecology, risk factors, host immunity, diagnosis and control', International Journal of Environmental Research and Public Health, 16(10): 1736-1759, 10.3390/ijerph16101736.
Rothschild CM (2013) ‘Equine piroplasmosis’, Journal of Equine Veterinary Science, 33(7): 497-508, doi: 10.1016/j.jevs.2013.03.189.
Wise LN, Kappmeye LS, Mealey RH and Knowles DP (2013) ‘Review of equine piroplasmosis’, Journal of Veterinary Internal Medicine, 27(6): 1334-1346, doi: 10.1111/jvim.12168.
3.16 Foot-and-mouth disease
Fast facts
Foot-and-mouth disease (FMD) is a highly contagious, exotic viral vesicular disease of cloven-hoofed animals.
Organism
FMD virus (FMDV):
- primarily replicates in epithelial cells in the pharynx and dorsal soft palate and then spreads via the blood to secondary sites
- can remain infective in the environment for several weeks and possibly longer in the presence of organic matter
- is inactivated by high and low pH and many disinfectants.
Susceptible species
All cloven-hoofed animals are susceptible, including cattle, sheep, pigs, goats and deer. Of domestic livestock, the disease is most severe in cattle and pigs.
Economic impact
There is potential for significant economic loss associated with eradication, production losses and restrictions on international trade.
Epidemiology
FMD:
- has an incubation period of 2–14 days, depending on the dose and route of exposure
- causes morbidity of up to 100 per cent in domestic livestock
- causes mortality in <5 per cent adult animals, higher in young animals
- virus can persistently infect a number of animals for varying periods.
Transmission
Transmission occurs via:
- aerosol transmission
- direct contact, usually oronasal
- swill feeding
- fomites
- artificial insemination.
Clinical signs
Clinical signs include:
- vesicles and ulcers in the mouth, feet and teats
- lameness
- pyrexia
- unwillingness to eat
- excessive salivation
- abortion
- drop in milk production
- sudden death in young animals.
Post-mortem
At post-mortem, vesicles may be present in ruminal pillars and ‘tiger heart’ striping of cardiac muscle in young animals.
Samples
Also refer to the detailed section on sampling for animals with vesicular disease.
- blood (EDTA and plain tubes)
- vesicular fluid, oropharyngeal fluid, oral, nasal and tonsillar swabs, epithelium, and epithelial tags (in buffer or virus transport medium).
Actions to take
If you suspect a case of FMD:
- call the Emergency Animal Disease Hotline (1800 675 888) immediately or contact a government veterinarian in your state or territory
- isolate suspected cases and implement biocontainment protocols (including farm movement controls) until advised by government veterinary authorities.
Introduction
Foot-and-mouth disease (FMD) is a highly contagious viral vesicular disease of cloven-hoofed animals. The most significant risk for entry of FMD into Australia is through illegal importation of meat and dairy products from infected animals fed to pigs as swill (swill feeding).
Disease agent and susceptible species
FMD virus (FMDV):
- is a member of the genus Aphthovirus within the family Picornaviridae
- is a single-stranded RNA virus with no envelope
- is differentiated into seven serotypes (A, O, C, Asia 1, SAT 1, SAT 2 and SAT 3) by various serological tests. There is no cross-protection between serotypes. Serotypes have been further classified into genotypes and topotypes based on genetic similarity and their geographical origin and occurrence
- has numerous antigenic variants and studies are required to assist with the selection of the most appropriate vaccine strains
- can infect all wild and domestic cloven-hoofed animals (of the domestic livestock species, cattle, buffalo, pigs, sheep, goats and deer are susceptible to FMD, with the disease most severe in cattle and pigs)
- has some strains which may affect Bactrian camels and camelids, and the Asian elephant
- infection of humans has been reported but is extremely rare, and infections were minor and self-limiting. FMD is not a public health concern.
Distribution
FMD:
- is endemic in the Middle East, South Asia, South-East Asia, China, central Asian countries and most parts of Africa (but the serotype distribution differs in these regions)
- was controlled or eradicated with the use of mass vaccination programs in South America, and most South American countries are free of the disease
- incursions into previously free countries have had severe economic impacts, for example, in the United Kingdom, Japan and the South Korea.
For the latest information on the distribution of FMD, please refer to the WAHIS information database website of the World Organisation for Animal Health (WOAH).
Occurrences in Australia
FMD has not occurred in Australia since the late 1800s when minor outbreaks are thought to have occurred in 1801, 1804, 1871 and 1872. The 1872 incident occurred in Victoria where the disease was introduced with an imported bull, and involved two farms before being eradicated.
Epidemiology
FMD is one of the most contagious viral animal diseases as virus is excreted in high quantities in expired air, in all secretions and excretions (including saliva, milk and semen), and from ruptured vesicles. Note that:
- pigs are regarded as important amplifying hosts for the disease, because of their capacity to excrete large quantities of virus in their exhaled breath
- cattle are regarded as indicator hosts because of their susceptibility to infection
- sheep and goats are considered silent or maintenance hosts, because the infection can spread through flocks with limited clinical disease.
Modes of transmission
Transmission occurs via:
- direct contact between infected and susceptible animals—the main route of infection is via the oronasal route; virus can also enter through breaks in the skin or mucosae. Stocking density is a determinant of the rate of spread of disease within an infected premises, with higher stocking densities seeing faster rate of spread. Movement of infected animals enables rapid dissemination of the virus over wide geographical areas
- mechanical spread by people, rodents, insects and birds
- contact with the carcasses of infected animals
- contact with secretions
- semen and embryos containing virus
- ingestion of infected swill—pigs have a higher relative susceptibility to infection through ingestion of contaminated feed, and swill feeding is illegal in Australia. Transmission occurs through the feeding of infected animal products including meat scraps and bones, or untreated raw milk and milk products from infected animals
- fomites—indirect contact by means of contaminated animal feed, straw, water, vehicles (including milk tankers) and other fomites (such as hypodermic needles) can spread the disease
- airborne spread—cattle and sheep are most susceptible to infection by inhalation of contaminated aerosols and extremely small doses of virus can initiate infection. Airborne spread can occur over long distances. The pattern of airborne spread has generally been from pigs as source to cattle downwind, and is likely to occur only when there are high concentrations of the appropriate livestock species at these locations. Long distance spread only occurs under very specific climatic conditions.
The transmission of FMD tends to be different in tropical and semitropical regions from that in temperate regions. In tropical areas, reasonably close contact is required between infected and susceptible animals for successful transmission, probably because of faster inactivation of the virus in hotter environments. The epidemiology of the disease in northern Australia could thus be expected to be different from that in southern Australia.
Healthy people can harbour FMDV subclinically in the nasal passages and throat for up to 28 hours, which means that during FMD outbreaks responders should avoid moving between premises for a directed amount of time (to avoid the possibility of transmitting FMDV to susceptible, uninfected animals).
Disease dynamics
FMDV is considered highly contagious, but mortality is low. In addition:
- the incubation period is variable depending on the virus strain, exposure dose, route of entry and species infected
- the incubation period for clinical signs is 1–14 days, but most commonly is 2–5 days
- excretion of FMDV can begin up to 4 days before clinical signs become apparent
- excretion of the virus decreases about 4–6 days after the appearance of vesicles, when circulating antibodies appear
- excretion of virus from foot lesions tends to last a day or two longer than from mouth lesions, so foot lesions may be a better source of virus for diagnostic purposes in older cases
- FMDV has been detected in the milk and semen of experimentally infected cattle for 23 and 56 days post-infection, respectively
- following infection with FMDV, it is possible for ruminants (but not pigs) to become persistently infected when virus persists in the pharynx in the presence of circulating antibody. Despite a number of anecdotal reports, as yet there is no evidence from the field that persistently infected animals (other than African buffalo) have been responsible for initiating new infections in susceptible animals
- vaccinated animals may become infected even when they are fully protected against clinical disease. Such animals are capable of excreting virus for about 1 week, though at lower levels. A proportion of vaccinated infected ruminants may also become persistently infected.
Persistence of the agent
FMDV:
- is most stable at pH 7.2–7.6 but will survive at pH 6.7–9.5 if the temperature is reduced to 4 °C or lower
- has a half-life of approximately 12 hours at pH 6.5, 1 minute at pH 6, and 1 second at pH 5 (although inactivation times depend on many factors)
- can be inactivated with acidic solutions (e.g. acetic acid, straight vinegar or citric acid solutions), alkaline solutions (sodium hydroxide or sodium carbonate) or the disinfectant Virkon®
- survival time is reduced by higher temperatures and most strains of FMDV are inactivated when placed at 56 ˚C for 60 minutes. The effect of temperature on viral infectivity is influenced by the presence of organic material
- remains stable for prolonged periods at temperatures below freezing
- is largely unaffected by sunlight
- can remain infective in the environment for several weeks, and possibly longer in the presence of organic matter (such as soil, manure and dried animal secretions) or on chemically inert materials such as straw, hair and leather.
Diagnosis and pathology
The classical signs and lesions of FMD are described in this section. Note that a wide range of clinical syndromes can occur, ranging from inapparent disease with minimal lesions to severe clinical disease.
Clinical signs
Morbidity is close to 100 per cent in fully susceptible cloven-hoofed domestic animals but variable in wildlife species. Mortality due to FMD virus infection is very low in adult animals (<5 per cent) but is higher in young calves, lambs and piglets (20 per cent or higher).
The course of FMD in cattle may last for 2–3 weeks, or longer if there are serious secondary bacterial infections. Long-term sequelae may include hoof deformities and permanent damage to the udder. Clinical signs in cattle include:
- pyrexia accompanied by severe depression, inappetence and (in milking animals) a sudden drop or cessation of milk production
- appearance (within 1–2 days) of vesicles, the predilection sites for which are the tongue, lips, gums, dental pad, interdigital skin of the feet, coronary bands, bulbs of the heels and teats. Note that vesicles can burst readily, within 24 hours, so it is more common to see ulcers
- vesicles and ulcers, which occasionally appear inside the nostrils or on the muzzle or vulva (see Table 3.16.1 for description of lesions)
- vesicles and ulcers in the mouth (these are particularly prominent on the tongue, dental pad and cheeks). In severe cases, most of the dorsal surface of the tongue may slough. In uncomplicated cases, mouth lesions heal fairly rapidly over a 7–10 day period and eating may resume within a few days of rupture of vesicles
- painful stomatitis (associated with unruptured and freshly ruptured vesicles), which causes excess salivation, lip smacking and cessation of eating, leading to rapid loss of body condition
- foot lesions, which are accompanied by acute lameness and reluctance to move (secondary infections may lead to severe involvement of the deeper structures of the foot)
- teat lesions, which may lead to secondary mastitis
- abortion
- infection of very young calves may cause sudden death due to cardiac involvement, without vesicular lesions (mortality can be as high as 50 per cent).
Clinical signs in pigs include:
- pyrexia (>40 ˚C) initially, and inappetence and lameness or reluctance to move
- vesicles and ulcers (within 1–2 days of disease onset)
- vesicles and ulcers are most pronounced on the feet and result in acute lameness, pain and recumbency, particularly if the pigs are housed on a hard floor (the disease may be difficult to detect when affected pigs are housed on soft bedding)
- vesicles and ulcers may occur on the coronets, interdigital skin, or bulbs of the heel, or other areas of friction
- vesicles and ulcers that encircle the coronet may lead to separation of the keratinised layers of the hoof from the corium—in severe cases there may be sloughing of the hoof, otherwise a line of separation between old and new horn moves steadily down the hoof at a rate of about 1 mm per week, starting a week after rupture of coronary band vesicles (the age of FMD lesions in pigs can often be estimated in this way)
- vesicles on the snout which rupture quickly
- vesicles and ulcers on the tongue (relatively uncommon in pigs, and when they do occur are small and heal rapidly)
- vesicles and ulcers on sow teats
- abortion (in some herds this is the first overt sign of the disease)
- high mortality in suckling pigs, with sudden deaths but no vesicular lesions (in some herds this is the first overt sign of the disease).
Clinical signs in sheep and goats include:
- lameness (often the only overt sign of disease in a flock)
- foot lesions (most pronounced on the coronary bands and interdigital skin) which are particularly prone to secondary bacterial infections, including footrot
- mouth lesions, although these are not prominent (vesicles and ulcers are most likely to occur on the dental pad and the posterior portion of the dorsal surface of the tongue, and they tend to be small and heal rapidly)
- abortion
- sudden death in young lambs as a result of cardiac lesions (the mortality rate may be as high as 90 per cent, but is more usually about 50 per cent).
FMD is generally much milder in small ruminants than in other species, and may escape detection. Therefore, careful individual examination of all individuals in a flock may be required to detect the disease.
Lesions usually progress in this manner:
- a small, blanched, whitish area develops in the epithelium
- fluid fills the area and a vesicle is formed
- vesicle enlarges and may coalesce with adjacent ones
- vesicle ruptures
- vesicular covering sloughs leaving an eroded red area
- grey fibrinous coating forms over the eroded area
- coating becomes yellow, brown or green
- epithelium is restored, but the line of demarcation remains (this gradually fades with time).
The Table 3.16.1 can be used as a guide for ageing FMD lesions in cattle and pigs. Lesions in sheep are too transient to be used for gauging the time of infection.
| Day of clinical disease | Appearance of lesion |
|---|---|
| Day 1 | blanching of epithelium, followed by formation of fluid-filled vesicles |
| Day 2 | freshly ruptured vesicles, characterised by raw epithelium, a clear edge to the lesion and no deposition of fibrin |
| Day 3 | lesions start to lose their sharp demarcation and bright red colour; deposition of fibrin starts to occur |
| Day 4 | considerable fibrin deposition has occurred, and regrowth of epithelium is evident at the periphery of the lesion |
| Day 7 | extensive scar tissue formation and healing have occurred; some fibrin deposition is usually still present |
Histological lesions are not specific. However, in addition to the external gross lesions already described, the following may be seen at post-mortem:
- vesicular lesions and ulcers on the ruminal pillars (ruminants)
- in young animals, focal necrosis of cardiac muscle. The lesions appear as small grey foci of irregular size and may give the myocardium a stripped appearance (‘tiger heart’) and similar lesions may also occur on skeletal muscles (all species).
Pathology
Gross lesions at post-mortem are generally restricted to vesicles described in the diagnosis and pathology section of Foot-and-mouth disease. Erosions may also be present on the ruminal pillars. There can also be ‘tiger heart’ striping of cardiac muscle in young animals.
Differential diagnosis
FMD is clinically undistinguishable from other exotic vesicular viral diseases of livestock, namely:
- Senecavirus A (Seneca Valley virus) infection (affects pigs)
- swine vesicular disease (affects pigs)
- vesicular exanthema of swine (not seen globally since 1956) (affects pigs)
- vesicular stomatitis (affects cattle and pigs).
Regard any cattle, pigs, sheep or goats exhibiting vesicular lesions and ulcers on their feet or teats as being infected with FMD until proven otherwise by laboratory testing.
A number of other diseases cause similar clinical signs to the viral vesicular diseases, particularly during their more advanced clinical stages. Although mouth and muzzle lesions in these diseases are not vesicular, they could be confused with FMD lesions.
These include:
- exotic diseases
- bluetongue disease (infection present in Australia but without clinical disease) (affects cattle, deer, goats and sheep)
- peste des petits ruminants (affects goats and sheep)
- rinderpest (now recognised by WOAH as eradicated from all countries with susceptible populations) (affects cattle, goats and sheep)
- endemic diseases
- bovine papular stomatitis (affects cattle)
- dermatophilus and other types of mycotic stomatitis (affects cattle, deer, goats and sheep)
- footrot (affects cattle and sheep)
- infectious bovine rhinotracheitis (affects cattle)
- mucosal disease (BVDV-1 only) (affects cattle
- non-infectious diseases that can also be confused with the viral vesicular diseases are:
- phototoxic dermatitis with vesicle formations from contact with the leaves of plants of the family Umbelliferae (parsley, parsnips and celery) (affects cattle, deer, goats and sheep)
- chemical irritants and scalding (affects cattle, deer, goats and sheep)
- traumatic lesions of the mouth and feet (affects cattle, deer, goats and sheep).
Samples required
Sample collection
FMD virus is very sensitive to both acid and alkaline conditions. Inappropriate buffer conditions can inactivate the virus making virus isolation difficult or impossible. To maximise chances of virus isolation:
- use phosphate buffered saline or virus transport media with a pH of 7.6.
- if a sample is to be submitted after 24 hours or more, add glycerol to the phosphate buffered saline
- dilute oropharyngeal fluid collected with a probang in an equal volume of phosphate buffered saline pH 7.6, and mixed vigorously for 1 minute.
Note that collection of samples in these buffers is optimal (for the growth of FMD virus) but not essential for RNA or antigen detection assays.
Take samples from at least 10 live, clinically affected animals. Collect:
- serum, 7–10 ml/animal in plain tubes
- vesicular fluid, carefully use a syringe and needle to aspirate the vesicular fluid from unruptured vesicles, and place in a sterile container. Alternatively, collect fluid from small vesicles onto a swab and place the swab in 500 μl of buffer, such as phosphate buffered saline or virus transport medium
- fresh tissue, epithelium, epithelial tags, oral, nasal and tonsillar swabs and oropharyngeal fluid and submit in phosphate buffered saline or virus transport medium, if available.
Transport of samples
- chill blood samples and unpreserved tissue samples at 4 °C, or with frozen gel packs
- DO NOT FREEZE SAMPLES at -20 °C, it reduces the sensitivity when used for virus isolation and molecular diagnostic tests
- send samples with dry ice if the journey is expected to take several days.
Sample submission
The relevant state or territory laboratory should coordinate sample packaging and consignment for delivery to the Australian Centre for Disease Preparedness.
Diagnostic tests
Laboratory tests currently available for primary FMD testing include PCR, antigen ELISA, virus isolation, and serological assays for the detection of antibodies. Testing strategies are based on samples submitted and clinical and epidemiological information provided.
Reporting requirements
FMD is an WOAH-listed disease and Australia has an international obligation to report cases.
If you suspect FMD, report it immediately. Call the Emergency Animal Disease Hotline on 1800 675 888, wherever you are in Australia. Alternatively, contact a government veterinarian in your state or territory.
Government duty veterinarians monitor the hotline and are available to advise you 24 hours a day, 7 days a week.
Biocontainment and personal protective equipment
There are no public health implications for FMD, but you should implement biocontainment protocols until advised by government veterinary authorities. This includes isolating suspected cases and using and appropriately disposing of personal protective equipment such as gloves, coveralls, rubber boots (or disposable boots) and a mask.
Thoroughly disinfect and decontaminate clothing, vehicle and equipment before leaving the property. Remember that people can harbour FMDV subclinically in the nasal passages and throat for up to 28 hours, which means that during FMD outbreaks responders should avoid moving between premises for a directed amount of time.









Further information
Weaver, G.V., Domenech, J., Thiermann, A.R., Karesh, W.B. (2013) Foot and mouth disease: a look from the wild side. Journal of Wildlife Diseases, 49:759-78.
Jamal SM, Belsham GJ. (2013) Foot-and-mouth disease: past, present and future. Veterinary Research, 44:116.
Paton DJ, Gubbins S, King DP. (2018) Understanding the transmission of foot-and-mouth disease virus at different scales. Current Opinions in Virology 28:85-91.
3.17 Glanders
Fast facts
Glanders is an infectious and often fatal zoonotic bacterial disease caused by Burkholderia mallei that primarily affects equids.
Organism
Glanders:
- is a bacterial disease caused by Burkholderia mallei and is closely related to B. pseudomallei, the causative agent of melioidosis
- B. mallei can be destroyed by heating, disinfectants and sunlight.
Susceptible species
The natural hosts are horses, mules and donkeys. Carnivores can become infected after eating contaminated meat. Small ruminants and camels may become infected if housed with or near infected equids. Humans can become clinically infected.
Economic impact
There is potential for significant economic losses associated with mortality of equids, as well as potential restrictions on domestic and international animal movements and trade.
Epidemiology
- Glanders typically spreads to new areas via the introduction of infected equids.
- Transmission can occur via direct or indirect contact.
- Incubation period can range from 6 days to several months.
Transmission
Transmission occurs via:
- ingestion of contaminated feed or water
- inhalation of aerosolised bacteria
- direct contact through breaks in the skin
- fomites such as husbandry equipment, breeding equipment and people.
Clinical signs
Glanders can present as acute or chronic forms of disease. Clinical signs commonly include:
- fever (> 40°C)
- malaise, depression, anorexia and weight loss
- lymphadenopathy and lymphangitis
- nodules which may erupt and develop ulcers with a purulent oily discharge
- unilateral nasal purulent epistaxis. Stellate scars may be seen on the nasal septum in chronic cases
- death.
Post-mortem
Gross lesions may include:
- granulomas and ulcers in different tissues
- fulminating ulcers on mucous membranes of the upper respiratory tract
- nodular foci under the surface of the pulmonary pleura with diffuse miliary granulomatous nodules with caseo-necrotic centres.
Samples
Collect:
- serum, preferably paired sera
- fresh tissue from lesions or lymph nodes
- swabs and smears from nasal or respiratory exudates (pus of open lesions or aspirated from unruptured nodules).
Actions to take
If you suspect a case of glanders:
- call the Emergency Animal Disease Hotline (1800 675 888) immediately or contact a government veterinarian in your state or territory
- isolate suspected cases and implement biocontainment protocols (including farm movement controls) until advised by government veterinary authorities.
Public health considerations
- Glanders is a zoonotic disease.
- People may become infected after close contact with infected animals.
- Infection risk is highest in individuals who work closely with live or deceased infected horses and their tissues.
- Consult the relevant state or territory health authorities as soon as glanders is strongly suspected or confirmed.
Introduction
Glanders is a zoonotic bacterial disease characterised by ulcerating nodules, primarily of the respiratory tract, skin and lymphatic system of Equidae. It can present as acute, chronic or latent and is invariably fatal.
Disease agent and susceptible species
- Glanders is caused by the obligate mammalian pathogen Burkholderia mallei, a Gram-negative, intracellular, non-motile, non-encapsulated and non-spore forming bacillus of the family Burkholderiaceae.
- The bacteria has a polysaccharide capsule which is considered a virulence factor and enhances survival.
- Equid species are the primary hosts, with donkeys most susceptible, followed by mules and horses.
- Carnivores, specifically species for the family Felidae, may also be susceptible if they ingest infected meat.
- Other species, such as pigs, cattle and birds are reported to be resistant.
- Infection in camels and small ruminants may occur if they are kept in close contact with infected equids.
- Experimental infection has been demonstrated in guinea pigs, hamsters and wild rodents (field mice and voles).
Public health considerations
- Infection in humans is rare, but is higher for those working directly with horses or with the organism in a laboratory.
- Humans can become infected with glanders via inhalation or cutaneous inoculation of B. mallei.
- Clinical signs may depend on the route of infection and can include fever, chills, myalgia, headaches, respiratory symptoms and skin lesions such as ulcers.
- Individuals that are immunosuppressed are at a higher risk of systemic spread of the disease.
- Mortality rates in human cases are high (up to 90%) if left untreated.
- In rare cases, human-to-human transmission can occur via infected bodily fluids.
- Consult with relevant state or territory health authorities as soon as B. mallei is strongly suspected or confirmed.
Distribution
Glanders:
- has been eradicated from North America, Canada, Western Europe and Japan. The disease has never been detected in New Zealand or Oceania.
- is endemic and/or re-emerging in Asia, the Middle East, the Indian subcontinent, Africa, South America and Eastern Europe.
For the latest information on the distribution of glanders, refer to the WAHIS information database website of the World Organisation for Animal Health (WOAH) or the FAO EMPRESi Global Animal Disease Information System.
Occurrences in Australia
Glanders was promptly detected in horses in quarantine that were imported from the United States in 1890. The affected animals were euthanased and in-contact horses were quarantined and subsequently euthanased.
Australia has strict import protocols and horses are required to spend 6 months in a glanders-free country before being imported into Australia.
Epidemiology
Modes of transmission
Transmission occurs via:
- ingestion of contaminated feed or water
- inhalation of aerosolised bacteria from infected discharges from the respiratory tract or ulcerated skin lesions
- inoculation of bacteria through breaks in the skin
- fomites such as contaminated husbandry equipment, breeding equipment and people
- mechanical transmission via flies has been suggested
- vertical and venereal transmission have been suggested, but not yet demonstrated.
Disease dynamics
- Glanders is caused by an obligate mammalian bacterium but can survive outside the host under specific environmental conditions.
- Mules and donkeys are most susceptible to the acute form and die a few days to a few weeks after the onset of clinical signs. Horses tend to develop the chronic form of the disease, which progresses over weeks to months.
- Infection is not influenced by age, breed and sex.
- Infected animals may suffer from chronic or subclinical disease, during which they can shed bacteria either continuously or intermittently. Some animals may appear to recover after months of illness, but the infection can remain subclinical for years, serving as a reservoir of the pathogen.
- The incubation period is dependent on the route of transmission and site of infection, species susceptibility and bacterial strain virulence. It can vary from 6 days to several months, with many cases emerging in 2 to 6 weeks.
- The disease spreads in unhygienic conditions such as overcrowded stables. Stress can make animals more susceptible to infection.
Persistence of the agent
- The bacteria are destroyed by heating for 10 minutes at 55oC or using disinfectants including iodine, benzalkonium chloride (1/2000), sodium hypochlorite (500ppm available chlorine), 70% ethanol or 2% glutaraldehyde.
- Exposure to direct sunlight and heat for 24 hours will destroy the bacteria.
- The bacteria has remained viable in contaminated stables for up to 6 weeks in humid or wet conditions.
- The bacteria can remain viable for up to 1 month in contaminated water (20–25oC) and over 6 weeks in areas such as stables.
Diagnosis and pathology
Clinical signs
Glanders has three clinical manifestations: pulmonary, cutaneous and nasal. Pulmonary and pulmo-cutaneous are the most common forms seen during outbreaks.
Donkeys and mules are more likely to experience acute glanders, which is often fatal within days to weeks.
Clinical signs may include:
- high fever (> 40°C)
- depression and malaise
- anorexia leading to emaciation
- coughing
- watery discharge from one nostril—rarely both
- nodules develop and progress to ulcers on the septum and within the turbinate bones
- copious thick, sticky, yellowish white mucopurulent to haemorrhagic nasal discharge
- dyspnoea
- uni- or bilateral submaxillary lymphadenitis, which may rupture
- glottis oedema
- death due to respiratory failure and/or septicaemia.
Horses are more likely to develop chronic glanders and may be infected subclinically for months to years. Clinical signs may include:
- signs associated with pulmonary involvement such as mild dyspnoea, fever and epistaxis
- wasting and general weakness
- intermittent cough
- lameness due to swelling of the hind limb joints
- haematuria
- swollen testes
- acute bronchopneumonia—may develop if pulmonary lesions erupt
- sticky yellow nasal discharge—may develop if nodules and ulcers have developed in the nasal septum and nasal turbinates. Stellate scars may be seen on the septum or the septum may perforate.
- submaxillary and submandibular lymphadenitis.
The cutaneous form most commonly appears on the inner thighs, legs and ventral surface of the abdomen. It can appear on the face, neck and chest. Common clinical signs include:
- lymphangitis, also called farcy cords/pipes
- lymphadenitis appearing as nodules or ulcers and also called farcy buds. These form in chains along the lymphatic vessels.
- ruptured nodules forming crater-like ulcers with a thick yellow to honey coloured purulent material also called farcy oil
- slow healing ulcers
- shifting lameness due to limb oedema.
Pathology
- Gross lesions found post-mortem may include
- granulomas and ulcers in different tissues
- fulminating ulcers on mucous membranes of the upper respiratory tract including the upper lip, nasal cavity and larynx.
- Healed lesions will appear as stellate scars.
- In pulmonary glanders there may be nodular foci under the surface of the pleura with diffuse miliary granulomatous nodules with caseo-necrotic centres.
- Lungs lobes may have oedema and evidence of bronchopneumonia.
- Para-nasal sinuses, trachea and nasal cavity may have sero-sanguinous fluid present.
Differential diagnosis
Consider in the differential diagnosis in equids:
- exotic
- epizootic lymphangitis (Histoplasma capsulatum var farciminosum)
- tuberculosis (Mycobacterium tuberculosis)
- screw worm fly (Cochliomyia hominivorax, Chrysomya bezziana—skin lesions)
- endemic
- strangles (Streptococcus equi equi)
- pneumonia
- melioidosis (Burkholderia pseudomallei, endemic in northern Australia)
- ulcerative lymphangitis (Corynebacterium pseudotuberculosis)
- fungal infections (e.g. Sporotrichosis, Botryomycosis)
- non-infectious
- trauma
- allergies.
Samples required
Sample collection
As glanders is a zoonotic disease, appropriate personal protective equipment must be worn when collecting and handling samples for investigation.
Preferred samples in the acute form are swabs from deep ulcerations of the nasal mucosa, and in the chronic form swabs from cutaneous lesions. In the latent form, lung lesions are common. Collect these samples from clinically affected animals:
- serum, preferably paired sera taken 2 to 4 weeks apart
- fresh tissue from lesions (uncontaminated, closed lesions ideal) or lymph nodes
- swabs and smears from nasal or other respiratory exudates (pus of open lesions or aspirated from unruptured nodules).
Field veterinarians and veterinary pathologists must take strict precaution to prevent human infections, via either the cutaneous or the respiratory route.
Uncoagulated whole blood samples are not recommended as this organism is uncommonly detected in blood.
Transport of samples
For transport:
- chill blood samples and unpreserved tissue samples at 4°C, or with frozen gel packs
- send samples with dry ice if the journey is expected to take several days.
Sample submission
The relevant state or territory laboratory should coordinate sample packaging and consignment for delivery to the Australian Centre for Disease Preparedness.
Diagnostic tests
For glanders diagnosis:
- serological tests available include complement fixation test (CFT) and ELISA
- bacterial culture
- nucleic acid detection includes real-time reverse transcription polymerase chain reaction (real-time RT-PCR).
Reporting requirements
Glanders is reportable in Australia. Glanders is a WOAH-listed disease and Australia has an international obligation to report confirmed cases. If you suspect glanders, report the disease immediately by phoning the Emergency Animal Disease Hotline on 1800 675 888, wherever you are in Australia. Alternatively, contact a government veterinarian in your state or territory.
Biocontainment and personal protective equipment
Glanders is a public health risk. Human infections are due to close contact with infected horses and infectious material. Activities where exudates are aerosolised are high risk for horse-to-human transmission. Therefore, it is important for you to seek advice from government veterinary authorities, noting:
- Biocontainment requires the appropriate use and disposal of personal protective equipment such as gloves, disposable coveralls, rubber boots (or disposable boots) and masks.
- Isolate sick/dead animals and limit contact with the sick/dead animals.
- Personal decontamination is required when leaving infected premises. Thoroughly clean and then disinfect vehicles and equipment before leaving the property.
- You need to avoid the spread of infection from premises by contaminated fomites such as husbandry equipment, breeding equipment and people.
- Any people who have had unplanned or accidental close contact with a suspect glanders case should wash with soap and water and seek medical advice as soon as possible.

Image credit: Dr Praveen Malik

Image credit: Dr Praveen Malik

Image credit: Dr Praveen Malik
Further information
Ellis, P (2020) ‘Glanders: re-emergence of an ancient zoonosis’, Microbiology Australia, 41(1):41-44, doi: 10.1071/MA20011.
Khan I, Wieler LH, Melzer F, Elschner MC, Muhammad G, Ali S, Sprague LD, Neubauer H and Saqib M (2013) ‘Glanders in animals: A review on epidemiology, clinical presentation, diagnosis and countermeasures’, Transboundary and Emerging Diseases, 60(3):204–221, doi: 10.1111/j.1865-1682.2012.01342.x.
Pal, M., Gutama, K.P. (2022) ‘Glanders: A potential bioterrorism weapon disease’, American Journal of Infectious Diseases and Microbiology, 10(3), pp. 98-101, doi: 10.12691/ajidm-10-3-2.
3.18 Hendra virus infection
Fast facts
Hendra virus (HeV) is a highly fatal zoonotic paramyxovirus primarily infecting horses which develop respiratory and neurological signs.
Organism
HeV:
- is susceptible to inactivation by desiccation, acidic conditions, heat and common disinfectants
- has an estimated maximum survival time in the environment of 5 days.
Susceptible species
- HeV affects dogs, flying foxes, horses and humans.
- HeV has infected pigs, cats, guinea pigs, hamsters, ferrets, and mice under experimental conditions.
Economic impact
There is potential for minor economic loss associated with disease control and fatalities.
Epidemiology
HeV causes high case fatality rates in horses and humans, and:
- flying foxes are the reservoir hosts
- outbreaks in horses (which may occur any time of year) have occurred annually since 2006
- incubation in horses lasts 4–16 days
- infection may occur anywhere horse and flying fox distributions overlap.
Transmission
Transmission occurs via:
- contact with pasture contaminated with infectious flying fox urine, saliva, faeces, and birthing fluids (flying fox to horse)
- direct or indirect transmission via contact with secretions and bodily fluids of affected horses (horse to horse, human, dog)
- fomite transmission possible (horse to horse, human, dog).
In addition:
- horses may transmit the virus before the onset of clinical signs
- endotracheal intubation, nasal lavage, endoscopy, and necropsy are high risk activities for vets
- transmission via respiratory droplets has not been evaluated and a 5-metre perimeter around infected horses is recommended.
Clinical signs
Clinical signs in horses include:
- acute-onset illness with rapid deterioration
- increased body temperature and heart rate
- pulmonary oedema and congestion, dyspnoea, nasal discharge
- ataxia, altered consciousness, head tilt, circling, muscle spasms, seizures, recumbency
- colic-like signs
- facial oedema.
Post-mortem
Only perform post-mortem if strict biosecurity measures can be achieved. Field post-mortems should not be attempted by untrained personnel.
Samples
Collect:
- blood samples (EDTA and plain tubes)
- nasal, oral and rectal swabs (in virus transport media)
- a blood clot from the jugular (if safe to do so) and a tissue sample from the mandibular lymph node from dead animals
- samples from in-contact horses and other susceptible animals.
Actions to take
If you suspect a case of HeV:
- call the Emergency Animal Disease Hotline (1800 675 888) immediately or contact a government veterinarian in your state or territory
- isolate suspected cases and implement biocontainment protocols (including farm movement controls) until advised by government veterinary authorities
- minimise contact with suspected cases and wear personal protective equipment.
Public health considerations
- HeV infection is a zoonotic disease
- people may become infected after close contact with infected horses
- consult the relevant state or territory health authorities as soon as HeV infection is strongly suspected or confirmed.
Introduction
Hendra virus (HeV), previously known as equine morbillivirus, is a lethal zoonotic disease in Australia which primarily affects horses and people. To date, the disease has only been seen in the eastern states of Queensland and New South Wales.
Disease agent and susceptible species
HeV:
- is an enveloped RNA virus belonging to the genus Henipavirus, family Paramyxoviridae
- affects horses, humans, dogs and flying foxes
- is known to have naturally infected two dogs without causing clinical signs of illness. This has been confirmed experimentally. In one case, HeV genome was detected in bodily fluids and tissues by qRT-PCR, and in the other case the dog had seroconverted to HeV
- has infected pigs, cats, guinea pigs, hamsters, ferrets, and mice (rats seroconvert without the development of clinical signs) under experimental conditions.
- A highly effective vaccine is available for use in horses.
Public health considerations
- people may become infected after close contact with infected horses
- use personal protective equipment such as gloves, disposable coveralls, rubber boots (or disposable boots), goggles or safety glasses, and P2 respirators or N95 masks when you are in close contact with infected horses
- consult the relevant state or territory health authorities in the case of a HeV outbreak.
Distribution
HeV has been found in flying fox populations in Australia and Papua New Guinea, and the closely related Nipah virus is found in flying fox populations in South-East Asia (please refer to the chapter on Nipah virus for more information).
Occurrences in Australia
HeV is endemic in most flying fox populations throughout Australia. To date we have seen more spillover events in northern New South Wales and South East Queensland. An observation is that spillover events have only occurred in regions where the spectacled flying fox and/or the black flying fox is present.
Epidemiology
Modes of transmission
No human-to-human transmission has been reported. However, human-to-human transmission has occurred with the closely related Nipah virus. Transmission occurs via:
- spillover from flying fox populations—infection in horses most likely occurs after close contact with bat urine, faeces and birthing fluids. This is thought to be due to contact with contaminated pasture, and transmission risk may be increased in horses fed under trees that bats roost in. It is also plausible that horses may become infected by inhaling droplets via the nasal route. Serological studies of bat carers suggest that bat-to-human direct transmission has not occurred.
- direct contact with the nasal secretions and excretions (urine, blood) of affected horses may cause horse-to-horse and horse-to-human spread of HeV. Horse-to-human transmission has only occurred with very close, prolonged contact during invasive procedures. HeV shedding, and therefore transmission, can occur before clinical signs are evident
- airborne spread—inhalating infected aerosols may be a method of transmission to horses and humans. No definitive studies have been performed to describe the distance over which respiratory droplets can spread from horses. For biosecurity measures, a distance of 5 metres is used to define an at-risk area
- fomites—HeV may survive on fomites for hours under mild climatic conditions and horse-to-horse transfer via fomites may occur.
Disease dynamics
There are no reports of relapsing disease in animals, but there has been one case of relapsing disease in humans. HeV infection in horses:
- is thought to occur through the naso-oral route, where a local replication in the nasal cavity or nasopharynx is followed by systemic spread of the virus
- has an incubation period of between 4–16 days. Horses may shed virus in nasal secretions before the onset of clinical signs, and are therefore a transmission risk
- causes damage to vascular endothelium, and subsequent vasculitis is thought to precipitate disease in the various organ systems (e.g. respiratory, neurologic, gastrointestinal).
- In addition:
- pyrexic and clinically affected horses shed virus from the nasal secretions and excretions such as urine and blood
- the case fatality rate is difficult to assess as it is likely that mild cases or cases of sudden death are not diagnosed.
- Humans have only been infected after exposure to HeV infected horses.
Persistence of the agent
The virus:
- has a lipid-envelope and outside the host is susceptible to desiccation and changes in temperature
- may survive from several hours to several days in the environment, depending on the environmental conditions (for disease control purposes, 5 days is presumed to be the maximum survival time under optimal environmental conditions)
- is inactivated by disinfectants, including soap and detergents, Virkon®, hypochlorites, iodophors/iodine, biguanidines (e.g. chlorhexidine), and quaternary ammonium compounds.
- A subunit vaccine is available for use in horses and is highly effective.
Diagnosis and pathology
Clinical signs
In humans, HeV infection causes an influenza-like illness and/or encephalitis.
In horses, the disease presents with a wide range of clinical signs and a definitive diagnosis requires laboratory testing. In fatally infected horses, illness typically lasts just over 48 hours from first clinical signs to death. An elevated body temperature or increased heart rate should be an early warning for possible HeV infection.
Common clinical signs in horses include:
- acute onset of illness with rapid deterioration, usually with respiratory and/or neurological signs
- pyrexia
- tachycardia
- discomfort/weight shifting between legs
- depression.
- Respiratory signs include:
- pulmonary oedema and congestion
- respiratory distress (tachypnoea)
- terminal nasal discharge which may be a stable white or blood-stained froth
- pulmonary disease leading to terminal weakness, ataxia and collapse.
Neurological disease signs include:
- ataxia
- abnormal behaviour (for example, loss of vision in one or both eyes, aimless walking)
- head tilting, circling
- muscle twitching
- urinary incontinence
- recumbency with inability to rise
- facial paralysis and/or locked jaw
- spasms of the jaw or involuntary chomping
- opisthotonus
- seizures.
Other clinical signs that may be seen include:
- previous unexplained horse deaths, or a high case fatality rate where there are multiple cases
- colic-like signs (rolling, thrashing, quiet abdominal sounds on auscultation of the abdomen, teeth grinding, straining to pass manure)
- facial oedema
- wide-based stance
- anorexia
- congestion of oral mucous membranes
- stranguria
- protruding penis.
Pathology
The following may be found:
- enlarged and oedematous submandibular, bronchial and/or sternal lymph nodes
- dilated pulmonary lymphatics
- pulmonary oedema and congestion with gelatinous distension of the subpleural lymphatics
- petechial haemorrhages on the pleural surfaces
- (less frequently) oedema of the mesentery, increased pleural and pericardial fluid and thick stable foam in the airways.
Differential diagnosis
There are no pathognomonic signs for horses with HeV infection. Affected horses display a large number of often vague clinical signs, resulting in a large number of differential diagnoses. Only a brief list is included here for reference. Consider in the differential diagnosis:
- exotic diseases
- African horse sickness
- equine influenza
- equine protozoal myeloencephalitis
- Japanese encephalitis
- rabies
- endemic diseases
- anthrax
- bacterial infection
- botulism
- equine herpesvirus EHV-1 (while the neuropathogenic strain of EHV-1 is considered exotic to Australia, the abortigenic strain is endemic in certain areas)
- inflammatory airway disease
- Australian bat lyssavirus infection
- tetanus
- West Nile virus infection (Kunjin virus)
- non-infectious causes
- snake bite
- toxicity
- trauma.
Samples required
Take stringent precautions during sampling. Wear full personal protective equipment with a P2 respirator for anyone in contact with the horse. Only perform post-mortem and tissue collection if you have appropriate workplace health and safety controls in place. Do not perform routinely.
Sample collection
Collect:
- serum, both plain and clotted whole blood
- EDTA blood, 7–10ml per animal
- swabs, nasal, oral, rectal and urogenital or urine
- fresh tissue in the form of a blood clot from a dead horse (collected by jugular cut-down, if safe to do so) and sample of mandibular lymph node.
Transport of samples
For transport:
- chill blood samples and unpreserved tissue samples at either 4 °C, or with frozen gel packs
- place swab samples in virus transport media containing antibiotics and antifungals (or saline if other media is unavailable)
- DO NOT FREEZE SAMPLES at -20 °C; it reduces the sensitivity when used for virus isolation and molecular diagnostic tests
- send samples with dry ice if the journey is expected to take several days.
Sample submission
The relevant state or territory laboratory should coordinate sample packaging and consignment for delivery to the Australian Centre for Disease Preparedness.
Diagnostic tests
For HeV:
- the most rapid, sensitive and specific diagnostic procedure is the detection of viral nucleic acid in blood or swabs by qRT-PCR
- virus isolation is also conducted but takes several days or more to complete
- serological tests, such as ELISA and virus neutralisation test, are available for the detection of antibodies which have been produced through natural infection or via vaccination.
Reporting requirements
HeV is an WOAH-listed disease and Australia has an international obligation to report cases.
If you suspect HeV, report it immediately. Call the Emergency Animal Disease Hotline on 1800 675 888, wherever you are in Australia. Alternatively, contact a government veterinarian in your state or territory.
Government duty veterinarians monitor the hotline and are available to advise you 24 hours a day, 7 days a week.
Biocontainment and personal protective equipment
HeV infection is a serious public health risk. Human infections are due to close contact with infected horses. Post-mortem examinations of horses that have died from acute HeV infection are high-risk for horse-to-human transmission. Therefore it is important for you to seek advice from government veterinary authorities, noting:
- stringent biosecurity procedures must be enforced to protect human health
- sick/dead horses should be isolated from people as soon as possible. Limit human and other susceptible animal (e.g. dog/cat) contact with the sick/dead horse and other horses on the property until HeV diagnostic testing has been performed
- establish ‘clean’ and ‘dirty’ areas to reduce transmission of disease throughout the property
- people in the dirty area must wear personal protective equipment, including impervious rubber boots, splash-proof overalls, disposable impermeable gloves, face shield or safety eyewear and a particulate respirator
- on leaving the dirty area, remove the personal protective equipment and double bag it in clinical waste bags with Virkon® disinfectant. You must disinfect all equipment thoroughly, and wash your hands and other exposed skin thoroughly. Ensure you shower and change clothes before coming into contact with other horses
- people who have had unplanned or accidental close contact with a suspect HeV case should wash with soap and water and seek medical advice as soon as possible
for more information see: Guidelines for veterinarians handling potential Hendra virus infection in horses V5.1.

Further information
Ball MC, Dewberry TD, Freeman PG, Kemsley PD, Poe I. (2014) Clinical review of Hendra virus infection in 11 horses in New South Wales, Australia. Australian Veterinary Journal. 92(6):213-8.
Glenn, A. M., Haining, J., Hancock, T. J., Robinson, R., Foord, A. J., Barr, J. A., Riddell, S., Heine, H. G., White, J. R., Crameri, G., Field, H. E., Wang, L., and Middleton, D. (2011) Experimental infection of horses with Hendra Virus/Australia/Horse/2008/Redlands. Emerging Infectious Diseases, 17(12), 2232-2238.
Middleton DJ, Riddell S, Klein R, Arkinstall R, Haining J, Frazer L, Mottley C, Evans R, Johnson D, Pallister J. (2017) Experimental Hendra virus infection of dogs: virus replication, shedding and potential for transmission. Australian Veterinary Journal. 95(1-2):10-18.
3.19 Hypervirulent infectious bursal disease of chickens
Fast facts
Infectious bursal disease (IBD), or Gumboro disease, is an acute, highly contagious viral infection causing immunosuppression and mortality in young chickens. Those aged 3–6 weeks are particularly susceptible, with hypervirulent IBD strains causing the most severe disease and mortality. While IBD is endemic in Australia, hypervirulent IBD strains are exotic and laboratory confirmation is needed to confirm strain type.
Organism
IBD virus (IBDV):
- varies in virulence between serotypes and strains
- replicates in lymphoid cells, primarily in the bursa of Fabricius
- is resistant to heat treatment and common disinfectants.
Hypervirulent IBD is also known as very virulent IBDV (vvIBDV).
Susceptible species
Hypervirulent IBD can infect domestic poultry, including chickens, turkeys, ducks, guinea fowl, ostriches and free-living wild bird species. However, it only causes clinical disease in young chickens.
Hypervirulent IBDV is not known to infect non-avian species and is not considered zoonotic.
Economic impact
There is potential for significant economic loss associated with production losses, control and eradication, and restrictions on animal movement and international trade.
Epidemiology
- Chicks 3–6 weeks old are most susceptible to clinical disease.
- Morbidity can reach up to 100 per cent, while mortality is variable depending on poultry type, age and health status.
- Virus excretion in faeces may occur up to 2 weeks post-infection.
- The virus is stable and can persist for up to 4 months in the environment.
Transmission
Transmission occurs via:
- direct contact, primarily via the faecal–oral route
- indirectly by mechanical vectors and fomites.
Clinical signs
Signs vary with age, breed, passive immunity and are mostly non-specific. In affected chicks, common signs include:
- prostration or reluctance to move
- decreased feed and water consumption
- watery diarrhoea
- dehydration
- sudden death.
Post-mortem
Gross lesions may include:
- severe carcass dehydration
- marked swelling, hyperaemia and pinpoint haemorrhages in the bursa of Fabricius, caecal tonsils, thymus and spleen. The bursa may have a yellow exudate on the surface.
- pinpoint haemorrhages on muscles and intestines
- pale and swollen kidneys containing urate crystals
- significantly atrophied bursa and thymus in the post-acute phase of infection.
Samples
Collect:
- fresh bursa, from at least 5 affected young birds aged 2–4 weeks of age or in early stages of disease in viral transport media (VTM) or sterile container
- serum from at least 20 birds, ideally early in the disease course and convalescent samples collected 3 weeks later.
Actions to take
If you suspect a case of hypervirulent IBD:
- call the Emergency Animal Disease Hotline (1800 675 888) immediately or contact a government veterinarian in your state or territory
- implement biocontainment protocols (including farm movement controls) until advised by government veterinary authorities.
Introduction
Infectious bursal disease (IBD), or Gumboro disease, is an acute, highly contagious viral infection primarily affecting young chickens aged 3–6 weeks. IBD is characterised by damage to the lymphoid organs, causing immunosuppression resulting in interference with vaccine efficacy and susceptibility to opportunistic pathogens. Hypervirulent strains of IBD are associated with severe clinical disease and mortality.
In Australia, IBD is endemic and vaccination of commercial flocks is common practice. However, hypervirulent virulent IBD (very virulent IBD) is exotic to Australia. It is important to distinguish IBD from vvIBD and other exotic variants of the disease, as vaccination may affect clinical presentation and complicate diagnosis. Laboratory confirmation, including sequencing, is required to accurately identify the strain associated with disease.
Disease agent and susceptible species
IBDV:
- is caused by a double-stranded, non-enveloped RNA virus belonging to the family Birnaviridae, genus Avibirnavirus
- infects chickens, turkeys, ducks, guinea fowl, ostriches and wild birds; however, clinical disease is only seen in young chickens
- layer breeds typically exhibit more severe clinical signs, higher mortality and greater viral load compared to broiler breeds
- has two IBDV serotypes: serotype 1 is considered virulent and causes clinical disease in chickens and serotype 2 can result in antibody production in the absence of clinical disease
- serotype 1 has four pathotypes: classical, antigenic variant, attenuated (vaccine-related) and very virulent strains. The very virulent IBD strain (vvIBDV) is also known as hypervirulent IBD.
- hypervirulent IBDV can be distinguished from other pathogenic strains by the more severe clinical signs and higher mortality observed in affected flocks.
Public health considerations
Hypervirulent IBDV is not considered a zoonotic disease risk. It is safe to eat chicken meat and eggs from infected birds.
Distribution
- Hypervirulent IBDV strains exist on most continents, including Asia, the Middle East, Africa, Latin America and Europe.
- Sporadic incursions of hypervirulent IBDV occur in the USA.
- Significant differences exist between the African, European and Asian vvIBDV strains, suggesting independent evolution. A novel pathogenic IBDV variant strain (nVarIBDV) that emerged in China in 2017 has spread to Japan, Korea and Malaysia.
For the latest information on the distribution of IBDV, refer to the WAHIS information database website of the World Organisation for Animal Health (WOAH) or the FAO EMPRESi Global Animal Disease Information System.
Occurrences in Australia
The classical and antigenic variant IBDV strains exist in Australia but are genetically different from strains found overseas. Australia is free of hypervirulent IBDV.
Epidemiology
Modes of transmission
Transmission occurs via:
- direct contact between birds via oral ingestion of faeces, or exposure of respiratory or conjunctival membranes to poultry dust aerosols
- indirect contact with fomites such as water, feed, litter, equipment, clothing, people and vehicles contaminated with faeces. Feathers and eggs can be contaminated with hypervirulent IBDV and act as a fomite when transported to another location.
- airborne spread can occur via the movement of contaminated dust or dried faeces, either on farms or by transporting infected birds
- mechanical vectors including rodents, mosquitoes (e.g. Aedes vexans) and mealworms are suspected of transmitting IBDV
- contamination of live poultry vaccines has been reported to be associated with the spread of IBDV
- the consumption of IBD-contaminated carcasses fed as kitchen scraps to backyard poultry is suggested as an important pathway for disease spread.
Wild birds are not thought to play a significant role in transmitting IBDV to naïve commercial flocks nor as reservoir hosts. However, commercial poultry has been reported to play a role in spreading IBDV to wild birds in the vicinity of poultry premises.
Disease dynamics
- In Australia, broiler and layer breeder flocks are commonly vaccinated with inactivated and live attenuated vaccines to control IBD. The choice and timing of vaccination is influenced by environmental IBDV pressure, the level and uniformity of maternally derived antibodies (MDA), and vaccine type, among other factors. Typically, breeder flocks in Australia are vaccinated at around 12 weeks, followed by a second vaccine administered at around 18 weeks, although some flocks may be vaccinated earlier, at between 6–8 weeks. Vaccination with classical serotype 1 IBDV vaccines reportedly provides good protection against hypervirulent IBD, and the stronger live intermediate IBD vaccines are also recommended for protection.
- Chicks under 6 weeks of age are not routinely vaccinated due to the presence of MDA and because of side effects from the virulence of partly attenuated strains.
- While the transfer of MDA to chicks protects against field virus challenges, MDA can inhibit the immune response to vaccination in later chick stages, leading to poor protection, especially if using mild strains for vaccines.
- Young chickens are susceptible to infection while B-cell lymphocytes are actively dividing in the bursa of Fabricius, which reaches its maximum size at 8–10 weeks of age before undergoing atrophy.
- Chickens under 10 weeks are usually clinically affected, with severe acute disease in 3–6-week-old birds. Clinical signs are rarely reported in chickens younger than 2 weeks and those older than 6 weeks, with these ages typically exhibiting subclinical disease.
- The incubation period for hypervirulent IBD is 2–3 days and the acute phase of the disease lasts for about 7–10 days.
- Virus excretion begins around 24 hours after infection, which is generally 1–2 days before clinical signs appear (i.e. spread is possible during the incubation period and before the onset of clinical signs), continuing for up to 2 weeks.
- Mortality is variable, ranging from 5–25 per cent in broilers and 30–60 per cent in layers, and up to 100 per cent in specific-pathogen-free flocks.
- Recovered chickens may continue to excrete and circulate the virus for several weeks.
- Vaccinated chickens can become infected and excrete hypervirulent IBDV and other pathogenic strains.
- Recovery varies with age, breed, virulence and maternal antibodies. Surviving chickens exhibit marked immunosuppression with reduced antibody responses. In chicks aged 0–3 weeks, the virus causes significant permanent atrophy of the developing bursa, leading to lifelong immunosuppression and vulnerability to secondary infections.
Persistence of the agent
Hypervirulent IBDV:
- is highly stable and can persist in the environment under adverse conditions despite thorough cleaning and disinfection
- is reportedly made highly resistant to harsh environmental conditions due to the absence of a lipidic envelope
- can remain infectious in the environment for several months, with the virus reported to be infectious for up to 122 days in chicken sheds and up to 52 days in contaminated feed and water. This increases the likelihood of indirect transmission from reused bedding or ineffectively cleaned and disinfected premises
- is resistant to pH conditions between 2 and 11, heat treatment including normal domestic or commercial cooking processes, ultraviolet light and ether, chloroform, phenolic derivatives and quaternary ammonium compounds
- is inactivated by pH conditions that exceed pH 12, temperatures used in rendering (80–95°C, with steam), and some disinfectants: 0.5% formalin (after 6 hours of contact time), invert soap combined with 0.05% NaOH for alkalisation after 30 minutes, 2% chloramine solution, glutaraldehyde and alkyl dimethyl-benzylammonium chloride
- is partially inactivated by a commercial combination of quaternary ammonia and glutaraldehyde with 10 minutes contact time and in the presence of contaminated organic material.
Diagnosis and pathology
Clinical signs
Signs vary with age, breed and passive immunity and are mostly non-specific. Distinguishing hypervirulent IBDV from other strains based solely on clinical signs alone is challenging because secondary infections (e.g. coccidiosis, inclusion body hepatitis, Marek’s disease) can exacerbate clinical signs in affected birds. Clinical signs associated with hypervirulent IBDV typically include:
- non-specific signs such as prostration or reluctance to move, ruffled feathers, depression, decreased feed and water consumption, watery diarrhoea and marked dehydration
- vent pecking (has been reported)
- sudden death, with mortality peaking on days 3 or 4 of infection
- rapid recovery by days 5–7.
Pathology
Post-mortem findings from hypervirulent IBDV are similar to other strains, except there may be extensive haemorrhaging in the bursae and other tissues.
Gross lesions from hypervirulent IBDV may include:
- severe carcass dehydration
- marked swelling, hyperaemia and pinpoint haemorrhages in the bursa of Fabricius, caecal tonsils, thymus and spleen; swollen bursa that is about twice its normal size in the acute phase of infection, with frank haemorrhages on the mucosa. A yellow, gelatinous exudate may be present on the serosal surface of the bursa.
- petechial haemorrhages on the thigh and pectoral muscles and in the intestinal tract, particularly at the proventriculus–gizzard junction
- pale and swollen kidneys containing urate crystals
- enlarged spleen with small grey foci over the surface
- significantly atrophied bursa and thymus in the post-acute phase of infection (7–10 days after infection).
Differential diagnosis
In chickens, many viral and bacterial pathogens can induce similar clinical signs or cause concurrent infections with hypervirulent IBDV, which may mask its detection. Given the varied and non-specific spectrum of signs associated with the disease, hypervirulent IBD should be considered if corresponding clinical signs and pathology are observed in affected chickens. While classical and variant strains of IBDV are endemic to Australia, hypervirulent IBDV strains are exotic. Differentiating between these strains based on clinical signs alone is not possible although higher mortality is attributed to hypervirulent IBDV; laboratory testing and confirmation, including sequencing, are essential for accurate identification.
In acute cases, the presence of bursal lesions is indicative of a diagnosis of IBD. However, in subclinical or recovered cases, the atrophy of the bursa may be confused with other diseases on the differential list, including Marek’s disease and infectious anaemia. Histopathology will facilitate differentiation between diseases.
Consider the following in the differential diagnosis:
- exotic diseases
- virulent Newcastle disease
- avian influenza
- endemic diseases
- IBD caused by endemic serotype 1 viruses
- coccidiosis
- infectious bronchitis—nephropathogenic forms
- Marek’s disease
- chicken anaemia infectious virus
- non-infectious causes
- stress, water deprivation and intoxication
- acute poisoning
- haemorrhagic syndrome due to sulfa drug intoxication or other causes.
Samples required
Sample collection
Collect the following samples from clinically affected birds:
- fresh bursa, ideally from at least 5 affected young birds aged 2–4 weeks of age or in early stages of disease. Older birds may have less virus present or reduced bursal tissue present. Collect into viral transport media (VTM) or sterile container.
- serum, from at least 20 birds, ideally acute samples taken early in the disease course and convalescent samples collected 3 weeks later.
Transport of samples
- chill blood samples and unpreserved tissue samples at 4°C, or with frozen gel packs
- DO NOT FREEZE SAMPLES at −20°C; it reduces the sensitivity when used for virus isolation and molecular diagnostic tests
- send samples with dry ice if the journey is expected to take several days.
Sample submission
The relevant state or territory laboratory should coordinate sample packaging and consignment for delivery to the Australian Centre for Disease Preparedness.
Diagnostic tests
For hypervirulent IBDV diagnosis:
- nucleic acid detection includes real-time reverse transcription polymerase chain reaction (real-time RT-PCR) and whole genome sequencing for further virus characterisation
- serological tests include enzyme-linked immunosorbent assay (ELISA), virus neutralisation test (VNT) and agar gel immunodiffusion (AGID) for antibody detection. However, serological tests cannot differentiate antibodies from vaccination or infection from IBDV.
- virus isolation is possible, but is often difficult
- histopathological examination and immunohistochemistry of affected bursae.
Reporting requirements
Infection with hypervirulent and exotic antigenic variant strains of IBDV are notifiable in Australia. While IBD is a WOAH-listed disease, it is endemic in Australia; therefore, reporting obligations to WOAH occur every 6 months unless there is a change in status to include hypervirulent IBD. If you suspect hypervirulent IBDV, immediately report the disease by phoning the Emergency Animal Disease Hotline on 1800 675 888 anywhere in Australia. Alternatively, contact a government veterinarian in your state or territory.
Biocontainment and personal protective equipment
There are no public health implications for hypervirulent IBDV, but you should implement biocontainment protocols until advised by government veterinary authorities. This includes isolating suspected cases and using and appropriately disposing of personal protective equipment such as gloves, coveralls and rubber boots (or disposable boots). Thoroughly disinfect and decontaminate clothing, vehicle and equipment before leaving the property.

Image credit: © Lucien Mahin (Lucyin) / Wikimedia Commons / CC-BY-SA 3.0

Image credit: © Lucien Mahin (Lucyin) / Wikimedia Commons / CC-BY-SA 3.0

Image credit: © Lucien Mahin (Lucyin) / Wikimedia Commons / CC-BY-SA 3.0

Image credit: F20494, INFECTIOUS BURSAL DISEASE CHICKEN, submitted by BOOSINGER/CHANG. Accessible at: https://davisthompsonfoundation.org/image-detail?image=F20494
Further information
Aliyu, HB, Hamisu, TM, Bejo, MH, Omar, AR. & Ideris, A (2022) ‘Comparative pathogenicity of Malaysian variant and very virulent infectious bursal disease viruses in chickens’, Avian Pathology, 51:1, 76-86, doi: 10.1080/03079457.2021.2006604.
Alkie, TN & Rautenschlein, S (2016) ‘Infectious bursal disease virus in poultry: current status and future prospects’ , Veterinary Medicine: Research and Reports, 7: 9-18, doi: 10.2147/VMRR.S68905.
Dey, S, Pathak, DC, Ramamurthy, N, Maity, HM & Chellappa, MM (2019) ‘Infectious bursal disease virus in chickens: prevalence, impact, and management strategies’ , Veterinary Medicine: Research and Reports, 10:85-97, doi: 10.2147/VMRR.S185159.
3.20 Influenza A in pigs
Fast facts
Influenza A viruses in pigs are highly contagious and typically present as acute to chronic respiratory disease with low mortality and high morbidity.
Organism
Influenza A virus (IAV):
- replicates primarily in epithelial cells of the respiratory tract
- transfers readily between humans and pigs
- constantly evolves genetically and virulence varies with the strain of the virus
- has three subtypes usually associated with disease in pigs—H1N1, H1N2 and H3N2.
Susceptible species
- pigs, humans, ferrets, turkeys are susceptible to IAVs.
Economic impact
There is potential for severe economic loss due to high morbidity, associated production losses and the potential for secondary bacterial infections, which may result in death.
Epidemiology
- morbidity can reach 100 per cent in herds naïve to the infecting strain
- mortality is usually low but can reach up to 30 per cent due to secondary infection
- incubation period is usually 1–3 days
- peak shedding from the nasal cavity occurs at 48–72 hours with a shedding duration of 7 days.
Transmission
- is by direct contact, usually nasal discharges
- aerosol droplets from sneezing and coughing
- indirect by ingestion of infected slurry and fomites.
Clinical signs
IAV infection typically presents as an acute to chronic respiratory disease with:
- marked pyrexia
- lethargy
- inappetence
- harsh, barking cough
- sneezing
- nasal discharge.
Post-mortem
- cranioventral lung consolidation
- concurrent bacterial bronchopneumonia, if present, will produce more extensive lesions.
Samples
Also refer to the detailed section on sampling for pigs with respiratory diseases. Collect:
- nasal, oral or respiratory swabs, particularly from clinically affected pigs, piglets and pigs aged 10–22 weeks
- blood in EDTA and plain tubes, particularly from sows and older pigs
- trachea and lung tissue (chilled and fixed).
Actions to take
If you suspect a case of IAV:
- call the Emergency Animal Disease Hotline (1800 675 888) immediately or contact a government veterinarian in your state or territory
- isolate suspected cases and implement biocontainment protocols (including farm movement controls) until advised by government veterinary authorities.
Public health considerations
- IAV infection is a zoonotic disease
- people may become infected after close contact with infected pigs. There is also a risk of infection from aerosol droplet and air contamination
- use personal protective equipment such as gloves, disposable coveralls, rubber boots (or disposable boots), and appropriate masks if you are in close contact with infected pigs
- consult the relevant state or territory health authorities if IAV infection is strongly suspected or confirmed.
Introduction
Influenza A viruses (IAVs) are highly transmissible respiratory pathogens that circulate in poultry, wild birds and mammals worldwide. IAVs are constantly evolving, leading to new subtypes and changes in characteristics such as virulence, infectivity and host range. The genetic diversity and extent of IAV infection in Australian piggeries is largely unknown, as is the potential contribution of IAV to porcine respiratory disease outbreaks.
Disease agent and susceptible species
IAVs in pigs are single stranded negative sense RNA viruses from the Orthomyxoviridae family. Note that:
- H1N1, H1N2 and H3N2 are the three subtypes usually associated with disease, with multiple strains recognised within these subtypes
- when established in pig populations, viruses can evolve further by reassortment and genetic mutation
- other subtypes including H2N3, H3N1, H4N6, H6N6, H4N8, H7N6 and H9N2, have occasionally been linked to outbreaks, but have not become established in pig populations
- reverse zoonotic transmission from piggery workers to pigs can result in the exposure of pigs to new viruses
- virus can infect humans in close contact with pigs, with people usually showing symptoms similar to seasonal influenza.
Public health considerations
- IAV infection is a zoonosis
- people may become infected after close contact with infected pigs
- use personal protective equipment such as gloves, disposable coveralls, rubber boots (or disposable boots) and masks when you are in close contact with infected pigs
- seek medical advice if you/others develop influenza-like symptoms or otherwise become unwell
- consult the relevant state or territory health authorities if IAV infection is strongly suspected or confirmed.
Distribution
- influenza has been clinically recognised in pigs since 1918 and IAVs have been isolated from the domestic pig populations of Europe, Asia and the United States since the 1930s
- H3N2, H1N1 and H1N2 viruses circulate in pig herds worldwide
- there are five global lineages of IAVs circulating in swine: classical swine H1, human seasonal H1, human seasonal H3, Eurasian avian-like H1, and triple reassortant internal gene
- in 2009 a novel H1N1 virus (H1N1pdm09) that was made up of genes from classical swine H1, Eurasian avian-like H1 and triple reassortant lineages emerged in humans in North America quickly spreading to become a worldwide pandemic. This virus is now considered endemic in many pig populations around the world due to reverse zoonotic transmission.
- IAVs cause production losses in intensively farmed poultry and pigs and in many countries where vaccine strategies are implemented in order to control outbreaks in naïve animals.
Occurrences in Australia
- before 2009, Australian domestic piggery herds were considered free of influenza A infection, based on serosurveys conducted in 1977 and 1997–1999
- following the outbreak of H1N1pdm09 in people in Australia, the virus was identified as a cause of respiratory disease outbreaks in pigs in New South Wales, Queensland, Victoria and Western Australia as a result of reverse zoonotic transmission
- in 2012, novel reassortant H3N2 and H1N2 viruses were isolated from respiratory disease outbreaks in piggeries in Western Australia and Queensland. The genomes of these viruses were a mixture of human seasonal H1 and human seasonal H3 lineages from the 1970s to the 1990s, as well as H1N1pdm2009. Further detections of these viruses occurred in Western Australia in 2016
- it is possible that IAV with genes from the human seasonal H1, human seasonal H3 and H1N1pdm2009/classical swine lineages are circulating in Australian pigs due to historical and ongoing reverse zoonotic transmission. Viruses from the Eurasian avian-like and triple reassortant lineages are less likely to be present in Australian herds due to restrictions on the importation of live pigs.
Epidemiology
Modes of transmission
Transmission occurs via:
- pig movements—between herds, the main method of spread of swine-origin IAV is through the movement of infected pigs, for example via introduced stock
- direct contact—within herds, IAV are primarily transmitted among pigs in close contact through nasal discharges and aerosols from sneezing and coughing
- airborne spread—between pigs via aerosolised respiratory droplets readily occurs
- fomites, between piggery sheds may occur via fomites such as contaminated equipment, footwear and vehicles in enterprises with poor biosecurity
- other species—humans and birds may be a source of infection and spread of IAVs to pigs. Transmission of IAVs from pigs to humans also occurs. Feral pigs may be sources of infection.
Disease dynamics
- the incubation period for IAV in pigs is usually 1–3 days
- although a distinct seasonality of IAV incidence in pig herds has not been consistently documented, as with seasonal human IAV circulation, outbreaks are more likely to occur during the colder seasons
- pigs begin excreting the virus from the upper respiratory tract within 24 hours of infection, with peak shedding at 48–72 hours and a duration of shedding of up to 7 days
- morbidity can reach 100 per cent in herds naïve to the infecting strain but mortality is usually low
- in endemic herds, pigs aged 10–22 weeks are most likely to be affected by IAV and should be targeted for detection of active infection.
Persistence of the agent
- due to the fragile viral lipid envelope, IAVs are highly susceptible to detergents and most commonly used disinfectants including sodium hypochlorite, 70% ethanol, oxidizing agents, quaternary ammonium compounds, aldehydes (formalin, glutaraldehyde, formaldehyde), phenols, acids, povidone-iodine and lipid solvents
- IAVs can be inactivated by heating at 56 °C for a minimum of 60 minutes (or higher temperatures for shorter periods) and by low pH (pH <2)
- cool, moist conditions contribute to environmental survival of IAVs
- studies have shown that IAVs survive for 24–48 hours on hard, nonporous surfaces such as stainless steel and plastic and for up to 8–12 hours on cloth, paper and tissues
- IAVs survived on hands for up to 5 minutes after transfer from the environmental surfaces
- studies have also reported sustained detection of IAV RNA in air during outbreaks in piggeries.
Diagnosis and pathology
Clinical signs
- a typical outbreak of IAV in a pig herd presents as an acute, high morbidity, low mortality infection that spreads rapidly through groups of pigs
- during the first 1–2 days of infection, there may be a rapid onset of pyrexia up to 41 °C, lethargy and inappetence. Respiratory signs such as serous nasal discharge, slight coughing and laboured abdominal breathing may also be present in this early phase. When pigs are forced to move, the heaves and tachypnea will become more pronounced
- by days 3 and 4, pigs demonstrate a harsh, deep, barking cough which is the hallmark clinical sign of this disease
- in the absence of secondary bacterial infection, pigs usually recover from IAV infection within 6–7 days
- due to pyrexia or transplacental infection, pregnant animals may abort
- in combination with other viruses or bacteria, IAVs may play a role in a severe, multifactorial respiratory disease syndrome known as the porcine respiratory disease complex
- not all pigs will be infected simultaneously, so clinical signs in the herd may last 2 or more weeks before abating, followed by gradual weight gain and return to normal body condition
- many pig herds can become infected with one or more IAV subtypes without showing clinical signs
- mortality rates vary depending on the presence of concurrent bacterial infection.
Pathology
- IAVs are a primary respiratory pathogen whereby infection with the virus alone can induce pathology in respiratory epithelial cells
- pathology relating to IAV infection in pigs is strain dependent but the most common macroscopic manifestation of IAV respiratory infection is a cranioventral consolidation that can affect as much as 40 per cent of the lung
- field cases will often present with a concurrent bacterial bronchopneumonia which results in more extensive lesions
- although the virus infects the epithelial lining of the nasal turbinates and trachea these organs are usually unremarkable
- bronchitis, bronchiolitis and interstitial pneumonia are usually evident to some degree on histopathology.
Differential diagnosis
Consider in the differential diagnosis:
- exotic diseases
- endemic diseases
- Actinobacillus pleuropneumoniae
- atrophic rhinitis (Bordatella bronchiseptica)
- inclusion body rhinitis (porcine cytomegalovirus)
- miscellaneous opportunistic bacterial infections (Haemophilus parasuis, Pasteurella multocida, Streptococcus suis)
- Mycoplasmal pneumonia (Mycoplasma hyopneumoniae, Mycoplasma hyorhinis)
- porcine circovirus type 2 associated diseases
- influenza A viruses (human-origin strains, subtypes H1N1, H1N2 and H3N2).
Samples required
Sample collection
Submit several pigs (at least five) for post-mortem examination, as there may be significant variability in lesions seen. Record a composite picture of all lesions. Older pigs such as sows, boars and finisher pigs are most likely to have serum antibodies against IAVs while piglets and weaned pigs aged 10–22 weeks are more likely to be shedding infectious virus (maternal antibodies wane from 6–12 weeks of age).
Collect:
- nasal swabs from untreated, acutely ill pigs, within 24–72 hours of development of clinical signs
- EDTA blood (7–10 ml per animal) from live, clinically affected animals.
- oral fluids, using cotton ropes hung in pig pens, preferably from weaners and growers
- blood serum samples from 30 suspected chronically infected animals (preferably sows, finishers, boars) to screen for seroconversion
- fresh tissue, from lung, tonsils and trachea and any organ showing gross pathology, chilled and immersed in virus transport media or phosphate buffered saline (PBS).
- fixed tissue, bronchiole and lung tissue and any organ showing gross pathology in neutral-buffered formalin.
Transport of samples
For transport:
- chill blood samples and unpreserved tissue specimens to 4 °C, or with frozen gel packs
- place swab samples in virus transport media containing antibiotics and antifungals (or saline if other media is unavailable)
- DO NOT FREEZE SAMPLES at -20 °C; it reduces the sensitivity when used for virus isolation and molecular diagnostic tests
- send samples with dry ice if the journey is expected to take several days
- formalin fixed tissue can be shipped at room temperature.
Sample submission
The relevant state or territory laboratory should coordinate sample packaging and consignment for delivery to the Australian Centre for Disease Preparedness.
Diagnostic tests
- the most rapid, sensitive and specific diagnostic procedure is the detection of viral nucleic acid in whole blood and/or tissues by PCR
- whole genome sequencing is attempted on samples in order to characterise the virus, which may differ from pig to pig due to propensity for reassortment (even within a single outbreak)
- serology is most useful as a surveillance tool however, due to antigenic diversity in IAVs, detection would require further investigation before an active infection is confirmed
- IAV can also be identified using an ELISA or haemagglutination inhibition (HI) test
- virus isolation can be achieved using embryonated chicken eggs and continuous cell lines
- specialised staining for IAV nucleoprotein can be done on fixed tissues to identify IAV antigen and any associated histopathology.
Reporting requirements
IAV is an WOAH-listed disease and Australia has an international obligation to report cases.
If you suspect IAV, report it immediately. Call the Emergency Animal Disease Hotline on 1800 675 888, wherever you are in Australia. Alternatively, contact a government veterinarian in your state or territory.
Government duty veterinarians monitor the hotline and are available to advise you 24 hours a day, 7 days a week.
Biocontainment and personal protective equipment
IAV infection in pigs is a public health risk. Human infections can occur following close contact with infected pigs; however, it is important to remember that reverse zoonosis can occur, when humans infect pigs. This transmission is probably by fomites and aerosol droplets. It is important that you seek advice from government veterinary authorities, noting:
- biocontainment requires the appropriate use and disposal of personal protective equipment such as gloves, disposable coveralls, rubber boots (or disposable boots) and masks
- personal decontamination is required when leaving infected premises. Thoroughly clean and then disinfect vehicles and equipment before leaving the property
- avoid the spread of infection from premises by contaminated fomites such as personnel clothing, poultry litter, equipment and manure
- discourage staff or visitors to enter the piggery if feeling unwell
- any people participating in the biocontainment of an IAV outbreak must be vaccinated against seasonal influenza.
Further information
Brown, I. H., 2000: The epidemiology and evolution of influenza viruses in pigs. Veterinary microbiology, 74, 29-46.
Janke, B. H., 2013: Clinicopathological features of Swine influenza. Current topics in microbiology and immunology, 370, 69-83.
Vincent, A., L. Awada, I. Brown, H. Chen, F. Claes, G. Dauphin, R. Donis, M. Culhane, K. Hamilton, N. Lewis, E. Mumford, T. Nguyen, S. Parchariyanon, J. Pasick, G. Pavade, A. Pereda, M. Peiris, T. Saito, S. Swenson, K. Van Reeth, R. Webby, F. Wong and J. Ciacci-Zanella, 2014: Review of influenza A virus in swine worldwide: a call for increased surveillance and research. Zoonoses and public health, 61, 4-17.
3.21 Japanese encephalitis
Fast facts
Japanese encephalitis is a mosquito-borne viral disease of humans and animals.
Organism
Japanese encephalitis virus (JEV):
- strains can vary in virulence
- is readily inactivated by heat, photochemical treatment, pasteurisation, treatment with detergents and low pH.
Susceptible species
Humans, horses, donkeys and pigs are susceptible.
Economic impact
There is potential for significant economic loss due to high morbidity and reproductive losses in pigs, as well as restrictions on animal movements and international trade.
Epidemiology
Japanese encephalitis:
- causes morbidity (50 per cent) and mortality (30 per cent ) in humans
- causes low morbidity in horses
- has a case fatality rate in horses of between 5–15 per cent in endemic areas and 30–40 per cent in seasonal epidemics
- can cause high reproductive losses in pig herds (up to 50–70 per cent) and 100 per cent mortality in pig litters
- subclinical infection is most common
- incubation period in horses is 4–14 days and in pigs is 1–3 days.
Transmission
Japanese encephalitis is mosquito-borne and Culex species are the main vectors.
Clinical signs
Clinical signs are:
- mild pyrexia or no overt signs in adult pigs
- reproductive failure in sows or gilts
- encephalitis in horses and humans.
Post-mortem
Typical findings include:
- lesions in the testes of boars
- microscopic lesions typical of non-suppurative meningoencephalitis in horses and adult pigs
- hydrocephalus, subcutaneous oedema, cerebellar hypoplasia and spinal hypomyelinogenesis in aborted foetuses
- gross lesions in horses (including severe congestion of the meninges, hypophysis and cerebral cortex).
Samples
Collect:
- a range of tissues in formalin
- whole blood and serum samples (paired serum samples should be collected 2–4 weeks apart)
- placental tissues from aborted foetuses
- cerebrospinal fluid and a range of brain tissue from animals with neurological signs.
Actions to take
If you suspect a case of Japanese encephalitis:
- call the Emergency Animal Disease Hotline (1800 675 888) immediately or contact a government veterinarian in your state or territory
- isolate suspected cases and implement biocontainment protocols (including farm movement controls) until advised by government veterinary authorities.
Public health considerations
- Japanese encephalitis is a vector-transmitted zoonosis
- use insect repellents or netting to protect against mosquitoes
- consult the relevant state or territory health authorities as soon as Japanese encephalitis is strongly suspected or confirmed.
Introduction
Japanese encephalitis is a mosquito-borne viral disease of humans and animals that occurs throughout much of Asia. Japanese encephalitis virus (JEV) infections are mainly subclinical, but can be associated with abortion in pigs and encephalitis in humans and horses. Although an effective vaccine is available, approximately 67,000 human cases occur annually.
Disease agent and susceptible species
The Japanese encephalitis serogroup comprises antigenically related viruses including West Nile (and the Australian subtype Kunjin), St Louis encephalitis, Murray Valley encephalitis, Alfuy and Usutu.
JEV:
- is enveloped and has a single-stranded RNA genome
- is a member of the Flavivirus genus of the family Flaviviridae
- replicates in various tissues with tropism for neurological and lymphoid tissues
- comprises strains that vary in virulence.
The main species affected include humans, horses, donkeys and pigs. Note that:
- humans, horses and donkeys are dead-end hosts but can develop severe encephalitis following infection
- infection of pregnant sows or gilts can lead to reproductive failure with abortions and stillbirths, while infection of boars has been associated with aspermia. Encephalitis has also been observed in piglets following experimental infection.
Other species that can be infected but do not exhibit disease include:
- cattle, dogs, sheep and goats (also dead-end hosts)
- waterbirds (herons and egrets), which are the main reservoir for spreading JEV
- pigs and waterbirds, which are important amplifying hosts
- several bat species, and fruit bats of the order Microchiroptera, which can develop prolonged viraemia capable of infecting mosquitoes under experimental conditions
- lizards, which have been shown experimentally to become persistently infected and transmit virus to mosquitoes.
- marsupial species, such as wallabies and possums, have also been shown experimentally to become infected and develop viraemia that may be sufficient to infect vector mosquitoes, although this has not been tested.
- The susceptibility of other Australian native fauna is not known.
Public health considerations
- Japanese encephalitis is a vector-transmitted zoonosis
- use insect repellents or netting to protect against mosquitoes
- consult the relevant state or territory health authorities in the case of a Japanese encephalitis outbreak.
Distribution
Japanese encephalitis is widely dispersed throughout Asia as follows:
- its geographic range extends to maritime areas of the north-east Russia, China and Philippines in the east, India and Pakistan at its western limits, and throughout South-East Asia.
- outbreaks of Japanese encephalitis have also been reported in Papua New Guinea (PNG) and northern Australia, as well as in the Western Pacific islands of Guam and Saipan.
- In some Asian countries, pigs are vaccinated as part of control efforts, and horses in endemic areas are vaccinated to protect against disease and for international travel.
Occurrences in Australia
Occurrences in Australia are described:
- Japanese encephalitis emerged in the Torres Strait, northern Australia in 1995 and subsequently spread to northern Queensland where infections of pigs and humans occurred. In 1995, three human cases occurred on Badu Island (in the Torres Strait) and two of these were fatal. A serological survey found further evidence of infection in people (subclinical), pigs, horses and dogs on Badu and other outer islands. Virus was isolated from two subclinical human cases and from Culex annulirostris mosquitoes, which were implicated as the major vector involved in the outbreak
- the first isolate of JEV from mosquitoes in the NPA was made from collections undertaken in 2004 following seroconversions in sentinel pigs. Despite these detections on mainland Australia, JEV does not appear to have become established and no further cases have been detected. The source of the periodic incursions that have occurred are thought to have been infected windblown mosquitoes or migrating water birds from PNG, where the virus is endemic.
Epidemiology
Modes of transmission
Transmission occurs via:
- vectors—mosquitoes primarily transmit JEV. JEV has been isolated from over 30 species of mosquito. In South-East Asia, the major vector is the rice field-breeding Cx. tritaeniorhynchus, whereas in Australia, the principle vector mosquito is Cx. annulirostris. JEV vectors are opportunistic feeders and are zoophilic, preferring animals to humans. While host availability is an important factor influencing feeding, bovine species are a preferred source of blood meals for Cx. tritaeniorhynchus. Since cattle are dead-end hosts, they may dampen JEV transmission. In Australia, Cx. annulirostris preferentially feed on cattle and marsupials
- vertical transmission (transovarial in mosquitoes and transplacental in pigs)
- direct transmission (demonstrated experimentally in pigs via the oronasal route).
Disease dynamics
Pigs are the main amplifying hosts of JEV and can act as maintenance hosts in endemic areas. Water birds, particularly herons and egrets, are important reservoir hosts, but may also act as amplifiers in areas where pigs are absent or in low numbers. Following natural infection, pigs and waterbirds develop a prolonged and high level viraemia capable of infecting mosquito vectors. The high birth rate and rapid turnover of pigs in commercial production systems provide a continual source of susceptible hosts and large epidemics of Japanese encephalitis have occurred when JEV spreads to new areas where susceptible hosts and suitable vectors co-exist.
A basic cyclical pattern of JEV transmission between pigs, mosquitoes and humans is recognised which involves two amplification cycles in pigs as follows:
- the first cycle infects a proportion of the herd, from which vector mosquitoes become infected (virus may be detected in mosquitoes prior to amplification in pigs in some instances)
- after a 1–2 week incubation period, mosquitoes transmit the virus to remaining susceptible pigs
- after a second incubation period, human and equine cases commence.
Japanese encephalitis predominantly affects rural areas where pig-rearing, irrigated agriculture and human habitation are in close proximity. Typically, two epidemiological patterns exist: endemic activity in tropical regions and epidemic activity in temperate and subtropical regions. In tropical areas, the virus is endemic and sporadic cases occur throughout the year, with small outbreaks occurring during monsoonal seasons.
In temperate areas, the disease is epidemic with outbreaks occurring in summer or early autumn. Exceptions to these patterns can occur, such as in tropical northern Australia where peak JEV activity has followed a temperate pattern.
Several overwintering mechanisms have been proposed for JEV in temperate areas. These include survival in dormant mosquito eggs following vertical transmission, survival in hibernating mosquitoes or animals, such as bats or reptiles, or transmission from persistently infected pigs. JEV may also be re-introduced by viraemic migratory birds or from wind-blown infected mosquitoes. One or more of these methods may contribute to Japanese encephalitis epidemiology in different areas.
In addition:
- morbidity and mortality in humans is approximately 50 per cent and 30 per cent, respectively
- Japanese encephalitis in livestock has not been accurately quantified, but mortality rates in horses are estimated at 5–15 per cent in endemic areas and 30–40 per cent in seasonal epidemics
- the incubation period in horses is 4–14 days and in pigs is 1–3 days
- the morbidity rate in horses is low (<1 per cent) and up to 1.4 per cent during epidemics
- reproductive losses in pig herds can be up to 50–70 per cent during epidemics
- mortality in litters of pigs can reach 100 per cent but is rare in adult pigs.
Persistence of the agent
JEV is relatively unstable and can be inactivated by a number of means, including heat inactivation in serum at 37°C for 30 minutes and a wide range of chemicals and disinfectants (e.g. 1% sodium hypochlorite, 70% ethanol, iodophore, quaternary ammonium disinfectants).
Diagnosis and pathology
Clinical signs
In pigs, the most common form of disease is reproductive failure in pregnant sows or gilts infected before 60–70 days gestation, which leads to abortion and litters containing stillborn or mummified foetuses or live, weak piglets. In addition:
- adult pigs do not generally show overt signs of infection
- under experimental conditions, pigs can become pyrexic (40–41 °C) after 24 hours of infection, lasting up to 5 days, with inappetence and depression
- viraemia can be detected experimentally from 1–3 days post-inoculation
- central nervous signs indicative of encephalitis, such as hind limb tremor, have been occasionally reported in piglets
- infected boars may have oedematous, congested testicles resulting in lowered motile sperm counts and abnormal spermatozoa.
In horses, subclinical infection is most common. Note that neurological sequelae can occur in surviving horses, and has manifested as incoordination, paraplegia, ataxia and incontinence.
Three clinical syndromes have been described as:
- transient type—pyrexia of up to 40 °C for 2–4 days, with anorexia, sluggish movement, congested or jaundiced mucous membranes, and rapid and uneventful recovery
- lethargic type—fluctuating pyrexia up to 41 °C, with lethargy, anorexia, stupor, grinding of teeth and chewing motions, difficulty in swallowing, jaundice, petechial haemorrhages in mucous membranes, incoordination, staggering and falling, transient neck rigidity, radial paralysis, impaired vision and recovery within 1 week
- hyperexcitable type—marked pyrexia (>41 °C), with aimless wandering, violent and demented behaviour, blindness, profuse sweating, muscle trembling, bruxism, collapse, coma and death.
Pathology
There are no characteristic gross lesions in infected sows. Otherwise, the following may be seen:
- accumulation of mucous fluid in the cavity of the tunica vaginalis, fibrous thickening of the epididymis and visceral lamina of the connective tissue surrounding the testes (tunica vaginalis)
- hydrocephalus, subcutaneous oedema, cerebellar hypoplasia and spinal hypomyelinogenesis in stillborn foetuses and live, weak piglets
- severe congestion of the meninges, hypophysis and cerebral cortex with foci of malacia and haemorrhage in horses
- lesions throughout the cerebral hemispheres in horses.
Differential diagnosis
In pigs, clinical disease characterised by abortion, foetal mummification or stillbirth, and encephalitis in animals up to 6 months old should be considered in the differential diagnosis Japanese encephalitis in horses must be differentiated from other causes of neurological diseases. In Australia this includes infections with the closely-related subtype Kunjin virus and Murray Valley encephalitis viruses, which have caused outbreaks of equine encephalitis and have very similar epidemiology to Japanese encephalitis.
Consider in the differential diagnosis:
- exotic diseases:
- Aujeszky’s disease (affects pigs)
- blue eye disease (rubulavirus infection) (affects pigs)
- Borna disease (affects horses)
- enteroviral encephalomyelitis (affects pigs)
- equine arboviral encephalitides (e.g. Elsey viruses, eastern equine encephalitis, western equine encephalitis, Venezuelan equine encephalitis viruses) (affects horses)
- Nipah virus infection (affects horses and pigs)
- porcine polioencephalomyelitis (Teschen disease) (affects pigs)
- porcine reproductive and respiratory syndrome (affects pigs)
- rabies (affects horses and pigs)
- swine vesicular disease (affects pigs)
- endemic diseases:
- Australian bat lyssavirus (affects horses)
- bacterial meningoencephalitis (affects horses and pigs)
- botulism (affects horses and pigs)
- haemagglutinating encephalomyelitis (affects pigs)
- Hendra virus infection (affects horses)
- herpes myeloencephalopathy (while the neuropathogenic strain of EHV-1 is considered exotic to Australia, the abortigenic strain is endemic in certain areas) (affects horses)
- Menangle virus infection (not reported in Australia since 1997) (affects pigs)
- porcine brucellosis (infection in feral pigs, with rare occurrence in domestic pigs) (affects pigs)
- porcine parvovirus infection (affects pigs)
- tetanus (affects horses and pigs)
- verminous encephalitis (affects horses)
- non-infectious diseases:
- hepatic encephalopathy (e.g. Crotalaria plant poisoning or post-vaccinal hepatitis) (affects horses)
- indigofera plant poisoning (Birdsville disease) (affects horses)
- mycotoxin poisoning and nigropallidal encephalomalacia (the latter is rare in Australia while mycotoxin poisoning is more common) (affects horses)
- poisons such as arsenic, mercury, monensin and organophosphorus compounds (affects horses and pigs)
- pantothenic acid deficiency (vitamin B) (affects pigs)
- water deprivation or salt poisoning (affects pigs).
Samples required
Sample collection
Collect samples from animals euthanised in the acute stage of the disease or from animals that have been dead for less than 12 hours.
Collect:
- whole blood (EDTA) and serum samples for virus detection and serology (for serum, collect at least 7–10 mL of blood from animals in the acute phase and convalescent stage of the disease). Collect paired serum samples 2–4 weeks apart
- cerebrospinal fluid (CSF) in animals presenting with neurological signs. Place into a sterile container
- fresh brain, spinal cord, tonsils from pigs, placenta from foetuses and neonates. Since viremia only lasts a few days and virus is rarely cultured from blood or CSF, isolation is best achieved from infected brain and post-mortem tissues. Remove the brain aseptically and collect a range of brain tissue samples into sterile containers
- formalin fixed tissues (full range of tissues including brain).
Transport of samples
For transport:
- chill blood samples and unpreserved tissue samples at either 4 °C, or with frozen gel packs
- DO NOT FREEZE SAMPLES at -20 °C; it reduces the sensitivity when used for virus isolation and molecular diagnostic tests
- send samples with dry ice if the journey is expected to take several days
- formalin fixed tissue can be sent at room temperature.
Sample submission
The relevant state or territory laboratory should coordinate sample packaging and consignment for delivery to the Australian Centre for Disease Preparedness.
Diagnostic tests
Laboratory diagnosis for JEV is achieved by virus isolation, molecular detection and serological tests. In addition:
- molecular methods (reverse transcriptase-PCR) are used to detect and identify viral RNA genome in a range of samples, including infected tissues, CSF, sera and whole blood
- infection with JEV can be detected in fixed tissues using immunohistochemistry
- diagnosis of JEV infections is often reliant on detection of antibodies
- as there is a high degree of serological cross-reactivity between flaviviruses, take care in interpreting results in areas where related flaviviruses co-circulate, especially those of the JE serogroup (these viruses should be included in parallel testing)
- a reliable diagnosis may be made where IgM to JEV is detected in the CSF in the absence of IgM to other flaviviruses
- IgG is even more broadly cross-reactive, and identifying virus-specific antibody is generally confirmed using the plaque-reduction neutralisation test; a diagnosis of JEV infection is based on the demonstration seroconversion between paired serum samples (≥ 4 fold rise in antibody titre to JEV compared to related circulating flaviviruses).
Reporting requirements
JEV is an WOAH-listed disease and Australia has an international obligation to report cases.
If you suspect JEV, report it immediately. Call the Emergency Animal Disease Hotline on 1800 675 888, wherever you are in Australia. Alternatively, contact a government veterinarian in your state or territory.
Government duty veterinarians monitor the hotline and are available to advise you 24 hours a day, 7 days a week.
Biocontainment and personal protective equipment
JEV is a public health risk. Human infections can potentially occur via needlestick and mucosal exposure or inhalation of infected samples. Contact with aborted foetuses, bodily fluids and tissues of infected animals (as well as aerosols generated during post-mortem examination) are also potential sources of human infection.
Therefore, keep suspected cases of Japanese encephalitis isolated and on the property (and protected from vectors, if possible) until you seek advice from government veterinary authorities, noting:
- wear appropriate personal protective equipment (coveralls and boots, gloves, mask) when examining animals, performing post-mortem examinations, or handling tissue, carcasses or abortion materials
- isolate sick/dead animals and limit contact with the sick/dead animals
- personal decontamination is required when leaving infected premises. Thoroughly clean and then disinfect vehicles and equipment before leaving the property
- vaccination is recommended for personnel working in Japanese encephalitis endemic areas, such as the Torres Strait.
Further information
Ellis PM, Daniels PW and Banks DJ (2000). Japanese encephalitis. Veterinary Clinics of North America: Equine Practice. 16(3):565-78.
Mansfield KL, Hernández-Triana LM, Banyard AC, Fooks AR, Johnson N. (2017) Japanese encephalitis virus infection, diagnosis and control in domestic animals. Veterinary Microbiology. 201:85-92.
van den Hurk AF, Ritchie SA and Mackenzie JS (2009). Ecology and geographical expansion of Japanese encephalitis virus. Annual Review of Entomology. 54:17-35.
3.22 Lumpy skin disease
Fast facts
Lumpy skin disease (LSD) is a poxvirus disease of cattle, characterised by pyrexia, and nodules on the skin, mucous membranes and internal organs.
Organism
Lumpy skin disease virus (LSDV):
- is closely related antigenically to sheeppox virus and goatpox virus
- may remain viable in environment for prolonged periods.
Susceptible species
Cattle and water buffalo are the only livestock species affected by LSD.
Economic impact
There is potential for significant economic loss due to high morbidity and drop in milk yield in cattle, as well as restrictions on animal movements and international trade.
Epidemiology
- morbidity usually varies between 10 and 20 per cent
- mortality is usually negligible
- incubation period is usually 12 days, but may range from 4–28 days.
Transmission
Transmission occurs:
- mainly by arthropod vector (biting insects)
- less commonly by direct contact with skin lesions, saliva, nasal discharge, milk or semen of infected animals.
Clinical signs
Clinical signs include:
- sudden onset of pyrexia, reluctance to move, nasal and ocular discharges, hypersalivation and lymphadenopathy
- cutaneous nodules of 2–5 cm in diameter, particularly on the head, neck, limbs, udder, genitalia and perineum
- fibrinous plaques eventually form over the top of the larger nodules.
Post-mortem
Typical findings include:
- extensive greyish-pink skin nodules with caseous necrotic centres
- similar nodules may be found in the nasopharynx, trachea, bronchi, lungs, rumen, abomasum, renal cortex, testicles and uterus
- swollen, congested lymph nodes with petechial haemorrhages.
Samples
Collect:
- fresh tissue samples-skin lesion biopsies, scabs, vesicular fluid (if present) and lesions in the respiratory and gastrointestinal tracts
- skin scrapings
- whole blood in EDTA.
Actions to take
If you suspect a case of LSD:
- call the Emergency Animal Disease Hotline (1800 675 888) immediately or contact a government veterinarian in your state or territory
- isolate suspected cases and implement biocontainment protocols (including farm movement controls) until advised by government veterinary authorities.
Introduction
Lumpy skin disease is a generalised viral disease of cattle that is spread by biting insects. The virus, which is closely related to the pox viruses of sheep and goats, causes nodular skin lesions on the animal’s body. It can cause considerable production losses.
Disease agent and susceptible species
Lumpy skin disease is caused by lumpy skin disease virus (LSDV) which is a pox virus. LSDV:
- is an enveloped, double stranded DNA virus in the family Poxviridae, subfamily Chordopoxvirinae, genus Capripoxvirus
- is very closely related to sheep and goat pox
- infects all cattle (Bos taurus are more susceptible than Bos indicus) and water buffalo (Bubalis bubalis)
- can infect a number of wildlife species, including giraffe and impala; however, a wildlife reservoir has not been identified
- does not infect humans.
Distribution
Globally, LSDV:
- is endemic in Africa, being virtually throughout the entire continent, including Madagascar
- spread into the Middle East in the 1990s
- by 2013 spread to Turkey, and from there westwards into Europe including Greece, Russia, Serbia and Georgia
For the latest information on the distribution of LSD, refer to the WAHIS information database website of the World Organisation for Animal Health (WOAH).
Occurrences in Australia
LSD has never been reported in Australia.
Epidemiology
Modes of transmission
Transmission occurs via:
- vectors—most commonly, insects (such as mosquitoes and biting flies) act as mechanical vectors of the virus
- secretions and excretions—less commonly, transmission can be through direct contact with secretions and excretions
- semen—shedding in the semen of clinically affected bulls may be prolonged; viral DNA has been found in the semen of some bulls for at least 5 months after infection, and live virus for up to 42 days; subclinically affected bulls may shed virus for at least 12 days.
Disease dynamics
LSDV:
- may be present in all secretions and excretions (including milk and semen) of infected animals. However, the level of virus shedding from mucosal surfaces is generally low
- is present at high concentrations in skin lesions
- may cause disease ranging from inapparent or mild to severe, depending on age, breed, immunity, and other factors
- usually sees an incubation period of 12 days, but this may vary from 4–28 days
- would likely cause severe disease in Australian cattle populations (which are fully susceptible)
- may cause skin nodules up to 5 cm or more in diameter develop within 1–2 days of the onset of pyrexia, especially around the head, neck, genitalia, limbs, udder and perineum
- has no carrier state and recovered animals develop lifelong immunity.
- Although few adult cattle die from the disease, many become debilitated and can remain in extremely poor body condition for prolonged periods (up to 6 months or longer).
Persistence of the agent
Capripoxviruses are very stable in the environment and can remain viable for long periods, on or off the animal host. LSDV:
- can survive in necrotic skin nodules for up to 33 days or longer, in desiccated crusts for up to 35 days, and at least 18 days in air-dried hides
- in dark environmental conditions, such as contaminated animal sheds, can persist for many months
- is susceptible to sunlight and detergents containing lipid solvents and acids. Therefore, acids combined with detergents (such as Virkon®) are the disinfectants of choice, particularly for areas where organic matter is prevalent. Hypochlorites and aldehydes are useful for disinfecting clean surfaces. Citric acid, alcohols and iodophors are suitable for personal disinfection
- is inactivated after heating for 2 hours at 55 °C.
Diagnosis and pathology
Clinical signs
- Clinical signs may vary widely between individuals within the same herd but typically include:
- ocular and nasal discharge and hypersalivation (usually observed first)
- a sudden onset of pyrexia, which may exceed 41 °C
- sharp drop in milk yield
- highly characteristic, nodular skin lesions of 2–5 cm in diameter, particularly on the head, neck, limbs, udder, genitalia and perineum within 48 hours of onset of pyrexia. These nodules are circumscribed, firm, round and raised, and involve the skin, subcutaneous tissue and sometimes even the underlying muscles
- centres of large nodules may become necrotic and eventually fibrotic and persist for several months
- anorexia
- conjunctivitis
- enlarged superficial lymph nodes
- vesicles, erosions and ulcers may develop in the mucous membranes of the mouth and alimentary tract, and in the trachea and lungs
- acute respiratory distress, and in more severe cases, commonly secondary pneumonia, which can be fatal
- oedema of the limbs, brisket and genitals may occur
- abortion, intrauterine infections and temporary sterility of bulls and cows may also occur.
Pathology
In addition to the lesions described:
- nodular lesions may be scattered through the nasopharynx, trachea, bronchi, lungs and the gastrointestinal tract, including the rumen and abomasum, the renal cortex, testicles and uterus
- there may also be enlarged and haemorrhagic lymph nodes.
Differential diagnosis
Acute cases in naïve populations should be readily diagnosed based on clinical signs. However, clinical signs may vary widely between animals within the same herd some strains of low virulence may produce only mild clinical signs or subclinical disease.
Consider in the differential diagnosis:
- exotic diseases
- cutaneous tuberculosis
- screw-worm fly myiasis
- endemic diseases
- bovine herpes virus 2 (pseudo-lumpy skin disease)
- bovine papular stomatitis
- dermatophilosis
- ectoparasites
- pseudocowpox
- non-infectious causes
- insect and tick bites
- photosensitisation
- skin allergies.
Samples required
Sample collection
Virus isolation will be possible within the first week of clinical signs developing, before neutralising antibodies develop. Collect:
- serum from at least 10 live, clinically affected animals, and from exposed animals (particularly those that are convalescent)
- EDTA blood from live, clinically affected animals (7–10 ml/animal)
- fresh tissue, characteristic skin lesions from skin as well as internal lesions if present, and regional lymph nodes (2 g of each tissue)
- fixed tissue, characteristic skin lesions from skin as well as internal lesions if present, and regional lymph nodes (in neutral-buffered formalin)
- nasal swabs, collected using sterile swabs.
Transport of samples
For transport:
- chill blood samples and unpreserved tissue samples at either 4 °C, or with frozen gel packs
- DO NOT FREEZE SAMPLES at -20 °C; it reduces the sensitivity when used for virus isolation and molecular diagnostic tests
- place swab samples in virus transport media containing antibiotics and antifungals (or saline if other media is unavailable)
- send samples with dry ice if the journey is expected to take several days
- formalin fixed tissue can be sent at room temperature.
Sample submission
The relevant state or territory laboratory should coordinate sample packaging and consignment for delivery to the Australian Centre for Disease Preparedness.
Diagnostic tests
For LSD:
- a rapid, tentative laboratory diagnosis can be made by electron microscopy of tissue samples. Electron microscopic examination of tissue samples reveals typical capripoxvirus particles
- confirmation of the diagnosis is obtained by specifically identifying the virus in tissues from early lesions or in cell culture using virus-specific tests
- the most rapid, sensitive and specific diagnostic procedure is the detection of viral DNA in characteristic pox virus lesions or nasal swabs by real-time or conventional PCR. A positive result can be obtained within 1 day of samples being received at the laboratory.
Reporting requirements
LSD is an WOAH-listed disease and Australia has an international obligation to report cases.
If you suspect LSD, report it immediately. Call the Emergency Animal Disease Hotline on 1800 675 888, wherever you are in Australia. Alternatively, contact a government veterinarian in your state or territory.
Government duty veterinarians monitor the hotline and are available to advise you 24 hours a day, 7 days a week.
Biocontainment and personal protective equipment
There are no public health implications for LSD, but you should implement biocontainment protocols until advised by government veterinary authorities. This includes isolating suspected cases and using and appropriately disposing of personal protective equipment such as gloves, coveralls and rubber boots (or disposable boots). Thoroughly disinfect and decontaminate clothing, vehicle and equipment before leaving the property.






Further information
Annandale CH, Irons PC, Bagla VP, Osuagwuh UI and Venter EH (2010). Sites of persistence of lumpy skin disease virus in the genital tract of experimentally infected bulls. Reproduction in Domestic Animals 45:250–255.
Babiuk, S, Bowden TR, Parkyn G, Dalman B, Manning L, Neufeld J, Embury-Hyatt C, Copps J and Boyle DB (2008). Quantification of lumpy skin disease virus following experimental infection in cattle. Transboundary and Emerging Diseases 55(7):299-307.
Irons PC, Tuppurainen ES and Venter EH (2005). Excretion of lumpy skin disease virus in bull semen. Theriogenology 63:1290-1297.
3.23 Newcastle disease
Fast facts
Newcastle disease (ND) is a highly pathogenic disease of poultry which can cause significant mortalities. Newcastle disease only refers to infection in poultry (not wild birds) with virulent strains of avian avulavirus 1.
Organism
Avian avulavirus 1:
- varies in virulence with strain and host species
- can survive at room temperature for extended periods of time.
Susceptible species
ND replicates in all bird species, including poultry. ND can cause mild infection in humans.
Economic impact
There is potential for significant economic loss associated with poultry morbidity and mortalities, control and eradication costs, as well as restrictions on animal movements international trade.
Epidemiology
Varies with the pathotype of the virus and the species infected. In addition:
- velogenic viruses cause high morbidity and mortality and spread rapidly
- higher pathogenicity viruses usually cause shorter incubation periods
- incubation periods are usually less than 1 week but (2–6 days) can be as long as 15 days.
Transmission
Transmission occurs via:
- the faecal-oral route and inhalation
- vertical transmission
- fomites
- mechanical vectors (rodents, insects and humans).
Clinical signs
Clinical signs vary with virus strain and host species and include:
- mortality
- conjunctivitis
- diarrhoea
- dyspnoea
- ataxia, paresis, paralysis, torticollis
- decreased egg production.
Post-mortem
In young birds, or in infection with a strain causing rapid death, no gross lesions may be present. Otherwise, the following may be found:
- haemorrhage/oedema of conjunctiva, ovaries and diphtheritic membranes overlying tracheal mucosa
- haemorrhage/oedema/ulceration of lymphoid accumulations (in the Peyer’s patches, caecal tonsils, proventriculus and bursa)
- splenomegaly
- swelling of the head.
Samples
Collect:
- serum
- oropharyngeal and cloacal swabs
- fresh tissues (lung, kidney, intestine, spleen, brain, heart)
- formalin fixed tissues (a full range).
Actions to take
If you suspect a case of ND:
- call the Emergency Animal Disease Hotline (1800 675 888) immediately or contact a government veterinarian in your state or territory
- isolate suspected cases and implement biocontainment protocols (including farm movement controls) until advised by government veterinary authorities.
Public health considerations
- ND is a zoonotic disease
- people (predominantly poultry workers and laboratory staff) may become infected after close contact with infected birds or materials.
Introduction
Newcastle disease (ND) is a zoonotic, highly pathogenic disease of birds which can cause significant mortalities, particularly in poultry. The disease varies in pathogenicity and is associated with gastrointestinal, respiratory and/or neurological signs.
Disease agent and susceptible species
ND is caused by virulent forms of avian avulavirus (AAvV-1). Also known as Newcastle disease virus (NDV), and formerly known as avian paramyxovirus 1, AAvV-1:
- is a virus within the genus Avulavirus, family Paramyxoviridae and order Mononegavirales
- can be classified into five pathotypes: 1) viscerotropic velogenic (highly virulent), 2) neurotropic velogenic, 3) mesogenic (intermediate virulence), 4) lentogenic (low virulence), 5) avirulent (only velogenic or mesogenic pathotypes fulfill the WOAH definition of ND)
- is an RNA virus which can be separated into class I and class II viruses. Class I viruses are predominantly found in wild waterfowl and are avirulent. However, class II viruses are found in both wild birds and poultry and contain both avirulent and virulent viruses
- is a zoonotic agent and infections are occasionally seen in people, predominantly in poultry workers and laboratory staff. Clinical signs observed include mild to moderate conjunctivitis and, rarely, flu-like symptoms
- replicates in all bird species but species susceptibility to disease varies
- rarely causes clinical disease in ducks and geese but game birds (including pheasants, partridges, and guinea fowl) are susceptible to disease with the virus being particularly pathogenic in quail.
- Chickens are highly susceptible to virulent forms of NDV but the virus can also be pathogenic for turkeys. Disease in wild bird species is not common but significant outbreaks of disease have been seen in young double-crested cormorants (Phalacrocorax auritus) in the United States and Canada.
Public health considerations
- people may become infected after close contact with infected birds or material
- when in close contact with infected poultry use personal protective equipment such as gloves, disposable coveralls, rubber boots (or disposable boots), safety glasses and mask.
Distribution
ND is endemic in many countries (particularly throughout southern and Central America, Asia, the Middle East and Africa) and sporadic outbreaks of disease regularly occur worldwide. The pigeon-adapted strain of AAvV-1, pigeon paramyxovirus (PPMV-1), is also present worldwide.
For the latest information on the distribution of ND, refer to the WAHIS information database website of the World Organisation for Animal Health (WOAH).
Occurrences in Australia
While avirulent strains of NDV are widespread and have been detected in Australia since the 1960s, Australia is free of virulent ND. In addition:
- there have been no detections of virulent ND since 2002
- Victoria experienced two outbreaks of ND in 1930 and 1932 (both outbreaks were quickly eradicated) and a single outbreak in 2002
- NSW experienced Australia’s largest outbreaks of ND between 1998 and 2000 in the Mangrove Mountain region. In 2002 another outbreak occurred in Greater Western Sydney
- the 1998–2000 and 2002 outbreaks are thought to be a result of mutations in one or more avirulent strains circulating in wild birds
- PPMV-1 was first detected in pigeons in 2011 but the virus has not yet been detected in any poultry species
- vaccination against NDV is available and comprises both live and inactivated vaccines.
Epidemiology
Modes of transmission
Transmission occurs via:
- inhalation of secretions or ingestion via the faecal-oral route (these are the main mode of transmission between birds)
- vertical transmission via embryonated eggs, although virulent strains will typically kill embryos before hatching occurs
- fomites, (clothing, equipment, vehicles, feed and water) as the virus survives in faecal material
- mechanical vectors in the form of rodents, insects and humans.
Disease dynamics
Disease presentation varies with the strain of virus and the host species and immune status.
Typically:
- post-exposure, the incubation period of the virus is 2–15 days (but incubation periods of up to 21 days are possible)
- virus is shed during the incubation period, while clinical signs are present, and until early in the convalescent period
- virus is maintained in the environment by wild birds, gulls, waterfowl and shorebirds, some of which may be reservoir hosts for lentogentic pathotypes, which can become virulent following mutation in domestic poultry.
Persistence of the agent
NDV:
- is able to persist for extended periods of time in faecal material at room temperature and in water
- is inactivated by temperatures of 56 °C for 3 hours or 60 °C for 30 minutes, acid pH 2, and disinfectants such as formalin, chlorhexidine, sodium hypochlorite and oxidizing agents (removal of organic material prior to disinfection is important)
- can remain in eggs laid by infected chickens for months at room temperature, for more than a year at 4 °C, and similar virus survival times have been observed on contaminated feathers and in contaminated premises.
Diagnosis and pathology
Clinical signs
Clinical signs of Newcastle disease are variable, depending on the pathotype. However, there is considerable overlap between pathotypes. Previous vaccination may greatly diminish the severity of clinical signs seen and may mask clinical disease. Poultry affected by the avirulent pathotype may display no clinical signs. Otherwise, clinical signs may include:
- anorexia, lethargy, ruffled feathers, respiratory distress, diarrhoea and conjunctivitis along with high mortality (velogenic viscerotropic pathotype)
- depression, ruffled feathers, increased respiratory effort, torticollis, ataxia and head tremors along with high mortality (velogenic neurotropic pathotype)
- respiratory and neurological disease, particularly in young birds, along with low mortality (mesogenic pathotype)
- mild respiratory disease, often in conjunction with other diseases such as mycoplasmosis (lentogenic pathotype).
Pathology
The most significant gross pathological lesions are seen with velogenic pathotypes.
Lesions may include:
- swelling of the periorbital area or head
- haemorrhagic and oedematous conjunctiva
- haemorrhages of the tracheal mucosa and upper respiratory tract with diphtheritic membranes
- haemorrhage, oedema and/or ulceration throughout the gastrointestinal tract, particularly in the proventriculus and caecal tonsils at sites of lymphoid tissue accumulation
- haemorrhage of the ovaries
- increased opacity of air sacs
- splenomegaly with pale mottling.
Differential diagnosis
Clinical signs of ND are not pathognomonic and therefore other poultry diseases should be considered as part of the diagnostic process. Consider in the differential diagnosis:
- exotic diseases
- duck plague (duck viral enteritis)
- highly pathogenic avian influenza
- endemic diseases
- aspergillosis
- avian chlamydiosis
- bacterial septicaemia (enterococcosis, staphylococcosis, streptococcosis, colibacillosis, pasteurellosis, erysipelas)
- cellulitis of the comb and wattles (Escherichia coli and other bacteria)
- fowl cholera (Pasteurella multocida)
- infectious bronchitis
- infectious coryza
- infectious laryngotracheitis
- mycoplasmosis
- non-infectious causes
- acute poisoning
- dehydration
- heat stress
- poor ventilation
- smothering.
Samples required
Ideally, submit whole birds for post-mortem examination. In particular, examining whole birds may provide information on other differential diagnoses. Documenting gross lesions is also useful in determining the most appropriate samples for laboratory testing.
Sample collection
Collect:
- sera from live birds (to assess exposure to NDV or to determine vaccination titres)
- oral and cloacal swabs from sick and recently dead birds (for large numbers of samples, pools of three swabs may be submitted in viral transport media)
- fresh tissue samples from the trachea, lungs, spleen, caecal tonsils, bursa of multiple dead birds (keep intestinal tract samples separate from other tissue samples to avoid contamination with bacteria during virus isolation)
- fixed tissue, a full range of tissues (including the brain), in particular tissue showing gross pathological changes, fixed in 10% neutral buffered formalin.
Transport of samples
For transport:
- chill blood samples and unpreserved tissue samples at either 4 °C, or with frozen gel packs
- place swab samples in virus transport media containing antibiotics and antifungals (or saline if other media is unavailable)
- DO NOT FREEZE SAMPLES at -20 °C; it reduces the sensitivity when used for virus isolation
- and molecular diagnostic tests
- send samples with dry ice if the journey is expected to take several days
- formalin fixed tissue can be sent at room temperature.
Sample submission
The relevant state or territory laboratory should coordinate sample packaging and consignment for delivery to the Australian Centre for Disease Preparedness.
Diagnostic tests
Laboratory testing is required for the diagnosis of ND and is accomplished by one or more of these procedures: haemagglutination inhibition (more common), ELISA, virus isolation, qPCR, pathotyping PCR, histopathology, immunohistochemistry.
Initial testing for AAvV-1 relies on qRT-PCR due the speed of testing and the high sensitivity and specificity of the test. Results are typically available within 24 hours of samples arriving at the laboratory.
Reporting requirements
ND is an WOAH-listed disease and Australia has an international obligation to report cases.
If you suspect ND, report it immediately. Call the Emergency Animal Disease Hotline on 1800 675 888, wherever you are in Australia. Alternatively, contact a government veterinarian in your state or territory.
Government duty veterinarians monitor the hotline and are available to advise you 24 hours a day, 7 days a week.
Biocontainment and personal protective equipment
ND is a public health risk. It can cause conjunctivitis in humans, but the condition is usually self limiting. It is important to seek advice from government veterinary authorities, noting:
- biocontainment requires the use and appropriate disposal of personal protective equipment such as gloves, coveralls, rubber boots (or disposable boots), safety glasses and masks
- isolate sick birds
- exclude wild birds from the premises
- thoroughly disinfect and decontaminate clothing, vehicle and equipment before leaving the property.



Further information
Falcon, M. D. (2004). Exotic Newcastle Disease. Journal of Exotic Pet Medicine, 13(2):79-85.
Miller, P. J., & Koch, G. (2013). Newcastle disease, other avian paramxyoviruses, and avian metapneumovirus infections; Newcastle disease. In D. E. Swayne, J. R. Glisson, L. R. McDougald, L. K. Nolan, D. L. Suarez, & V. Nair (Eds.), Diseases of Poultry (13th ed., pp. 89-138). Hoboken, New Jersey: Wiley-Blackwell.
Vidanovic, D., Sekler, M., Asanin, R., Milic, N., Nisavic, J., Petrovic, T., & Savic, V. (2011). Characterization of velogenic Newcastle disease viruses isolated from dead wild birds in Luxembourg from 2006 to 2008. Journal of Wildlife Diseases, 47:433-441.
3.24 Nipah virus infection
Fast facts
Nipah virus (NiV) is a highly lethal zoonotic paramyxovirus primarily infecting pigs, horses and people.
Organism
NiV:
- replicates in the nasal cavity or nasopharynx
- is susceptible to drying and desiccation and most disinfectants.
Susceptible species
NiV affects:
- flying foxes
- pigs
- humans
- dogs, cats and horses.
Economic impact
There is potential for minor to moderate economic loss associated with disease control and human health care costs, as well as restrictions on animal movements and international trade.
Epidemiology
NiV:
- has an incubation period of 6–14 days in pigs
- has high rates of pig-to-pig transmission, causing high prevalence of infection on pig farms
- causes high mortality in humans.
Transmission
While data are limited on the role domestic species play in transmission to people, other transmission occurs via:
- the oronasal route (in pigs)
- contact with the secretions and bodily fluids of infected pigs (in pig-to-pig and pig-to-human transmission)
- spillover from flying foxes to pigs and humans (flying foxes can shed the virus in urine, saliva, and uterine fluids).
Clinical signs
Nipah virus can present with a wide range of clinical signs and a definitive diagnosis requires laboratory testing. Clinical signs in pigs include:
- increased body temperature
- respiratory signs (barking cough, laboured respiration, open-mouth breathing)
- neurological signs (behavioural changes, head-pressing, nystagmus, champing, uncoordinated gait, spasms, myoclonus and hindlimb paresis)
- early abortion.
Post-mortem
Post-mortem poses a high health risk for humans and should only be performed if strict biosecurity can be achieved. Field post-mortems should not be attempted. There are no pathognomonic signs on gross pathology (but on histopathology, endothelial syncytia are highly indicative).
Samples
Also refer to the detailed sections on sampling for respiratory and neurological diseases in pigs Collect:
- blood samples (EDTA and plain tubes)
- swabs–nasal, oral, rectal and urogenital swab or urine
- a blood clot from the jugular (if safe to do so).
Actions to take
If you suspect a case of NiV infection:
- call the Emergency Animal Disease Hotline (1800 675 888) immediately or contact a government veterinarian in your state or territory
- minimise contact with suspect animals and wear adequate personal protective equipment
- isolate suspected cases and implement biocontainment protocols (including farm movement controls) until advised by government veterinary authorities.
Public health considerations
- NiV infection is a zoonotic disease
- people may become infected after close contact with infected pigs
- you must consult the relevant state or territory health authorities as soon as NiV infection is strongly suspected or confirmed.
Introduction
Nipah virus (NiV) is an exotic highly lethal zoonotic paramyxovirus. In the largest outbreak to date, it primarily infected pigs but had low mortality, causing either respiratory or neurological signs. It has a broad mammalian host range and can cause severe disease, particularly in humans.
Disease agent and susceptible species
Note that NiV:
- is a nonsegmented negative strand RNA virus and belongs to the genus Henipavirus of the family Paramyxoviridae
- has two identified strains to date—Nipah virus-Malaysia (NiV-MY) and Nipah virus-Bangladesh (NiV-BD)
- infection does not clinically affect flying foxes (Pteropus spp.), the natural reservoir of NiV
- infection (natural cases) has been reported in pigs, cats, dogs, horses and humans.
Public health considerations
- people may become infected after close contact with infected pigs
- when in close contact with infected pigs use personal protective equipment such as gloves, disposable coveralls, rubber boots (or disposable boots), goggles or safety glasses, and P3 respirators or N95 masks
- consult the relevant state or territory health authorities in the case of a NiV infection outbreak.
Distribution
NiV:
- has been recorded in pigs in Malaysia, and in people in Malaysia, Singapore, Bangladesh and India (a number of states including West Bengal, and Kerala)
- has been found in flying fox (Pteropus spp.) populations in multiple locations in South-East and southern Asia
- may have caused an outbreak of disease in horses and people in the Philippines in 2014
- has been isolated from flying foxes in Cambodia but no outbreaks have been reported from that country to date.
For the latest information on the distribution of NiV infection, refer to the WAHIS information database website of the World Organisation for Animal Health (WOAH).
Occurrences in Australia
None recorded.
Epidemiology
Modes of transmission
Transmission occurs through:
- spillover from flying fox populations—infection in pigs most likely occurs after close contact with flying fox urine, faeces, uterine fluids and fruit spats (chewed up fruit). Consuming contaminated date palm sap or contaminated fruit has been linked to recurrent spillovers of NiV into the human population in Bangladesh (flying fox to pig, flying fox to human)
- direct contact between pigs (pig to pig spread)
- direct human contact with excretions (urine, blood) of infected animals. Pig farm workers and abattoir workers have the highest risk of pig-to-human spread. Preparation and consumption of infected horse meat implicated in Philippines outbreak (horse-to-human spread)
- fomites—as NiV may survive on fomites for hours under mild climatic conditions (pig to human, pig to pig spread)
- close contact associated with sick or dead humans (human-to-human spread).
Disease dynamics
NiV is thought to infect susceptible species through the naso-oral route, with local replication in the nasal cavity or nasopharynx followed by systemic spread of the virus. In addition:
- infection of vascular endothelial cells, damage to vascular endothelium and subsequent vasculitis is thought to precipitate disease in the various organ systems (for example, respiratory, neurologic, gastrointestinal). As the disease progresses, you may see predominantly respiratory and/or neurological signs
- pyrexic and clinically-affected pigs shed virus from the nasal secretions and excretions such as urine and blood. Therefore, post-mortem examinations of pigs that have died from acute NiV infection are high-risk for pig-to-human transmission
- viral shedding in respiratory secretions of subclinical pigs has been demonstrated experimentally
- available data suggests incubation period in pigs is between 6–14 days
- while morbidity is high in pigs, mortality is low
- in other species, such as horses and cats, mortality is high.
Persistence of the agent
NiV:
- has a lipid envelope and outside the host is susceptible to desiccation and changes in temperature
- survival in the environment varies from several hours to several days, depending on the environmental conditions (for disease control purposes, 5 days is presumed to be the maximum survival time under optimal environmental conditions)
- disinfectants include soap and detergents, Virkon®, hypochlorites, iodophors/iodine, biguanidines (e.g. chlorhexidine) and quaternary ammonium compounds.
Diagnosis and pathology
Clinical signs
A high incidence of subclinical infection in pigs was reported during the outbreak in Malaysia. The main presenting sign was respiratory disease, with some developing encephalitis. Clinical signs in pigs are:
- pyrexia
- early abortion
- respiratory signs including barking cough, rapid or laboured respiration, open-mouth breathing, pulmonary congestion and oedema on post-mortem examination
- terminal nasal discharge which may be a stable white or blood-stained froth
- neurological signs (including behavioural changes, head-pressing, nystagmus, champing, uncoordinated gait, spasms, myoclonus, and hindlimb paresis.
In humans, NiV causes an influenza-like illness, encephalitis and/or respiratory syndrome.
Pathology
The following are seen:
- generalised vasculitis
- dilated pulmonary lymphatic vessels
- pulmonary oedema
- exudate in airways
- (less frequently) oedema of the mesentery, increased pleural and pericardial fluid and thick stable foam in the airways.
Differential diagnosis
Consider in the differential diagnosis of NiV infection in pigs:
- exotic diseases
- Aujeszky’s disease (in adult animals) (affects pigs)
- classical swine fever (chronic form) (affects pigs)
- Japanese encephalitis (affects horses and pigs)
- porcine reproductive and respiratory syndrome (affects pigs)
- rabies lyssavirus infection (affects horses and pigs)
- post-weaning multisystemic wasting syndrome (in weaned pigs) (affects pigs)
- endemic diseases
- anthrax
- Australian bat lyssavirus infection (affects horses)
- bacterial infection (affects horses and pigs)
- botulism (affects horses and pigs)
- Hendra virus infection (affects horses)
- West Nile virus infection (Kunjin virus) (affects horses and pigs)
- non-infectious causes
- snake bite (affects horses and pigs)
- toxicity (affects horses and pigs)
- trauma (affects horses and pigs).
Samples required
Take stringent precautions during sampling. Personnel must wear full personal protective equipment with P3 respirator when they are in contact with animals strongly suspected to be infected with Nipah virus. Sample susceptible animals that have had close contact with a known infected animal three times—as soon as possible, 12 days post-contact and 20 days post-contact.
Sample collection
Only perform post-mortem and tissue collection if you have appropriate workplace health and safety controls in place. Do not be perform post-mortem and tissue collection in the field.
Collect:
- EDTA blood (7–10ml per animal)
- swabs, nasal, oral, rectal and urogenital swabs or urine
- serum in the form of plain/clotted whole blood.
Transport of samples
For transport:
- chill blood samples and unpreserved tissue samples at either 4 °C, or with frozen gel packs
- place swab samples in virus transport media containing antibiotics and antifungals (or saline if other media is unavailable)
- DO NOT FREEZE SAMPLES at -2 °C; it reduces the sensitivity when used for virus isolation and molecular diagnostic tests
- send samples with dry ice if the journey is expected to take several days
- formalin fixed tissue can be sent at room temperature.
Sample submission
The relevant state or territory laboratory should coordinate sample packaging and consignment for delivery to the Australian Centre for Disease Preparedness.
Diagnostic tests
Laboratory testing is required for the diagnosis of NiV and is accomplished by one or more of the following:
- ELISA
- virus neutralisation test
- PCR.
The most rapid, sensitive and specific diagnostic procedure is the detection of viral nucleic acid in blood or swabs by qRT-PCR.
Reporting requirements
NiV is an WOAH-listed disease and Australia has an international obligation to report cases.
If you suspect NiV, report it immediately. Call the Emergency Animal Disease Hotline on 1800 675 888, wherever you are in Australia. Alternatively, contact a government veterinarian in your state or territory.
Government duty veterinarians monitor the hotline and are available to advise you 24 hours a day, 7 days a week.
Biocontainment and personal protective equipment
NiV infection is a serious public health risk. Post-mortem examinations of animals that have died from acute NiV infection are a high-risk for animal-to-human transmission. Therefore it is important to seek advice from government veterinary authorities, noting:
- stringent biosecurity procedures must be enforced to protect human health
- sick/dead animals should be isolated from people as soon as possible. Limit human contact with the sick/dead animals and other potentially exposed animals on the property until NiV diagnostic testing has been performed. Stop or limit animal and human movements onto and off the property (if possible)
- establish ‘clean’ and ‘dirty’ areas to reduce transmission of disease throughout the property
- wear personal protective equipment in the dirty area, including impervious rubber boots, splash-proof overalls, disposable impermeable gloves, face shield or safety eyewear and a particulate respirator
- on leaving the dirty area, you must remove your personal protective equipment and double bag it in clinical waste bags with Virkon® disinfectant. You must disinfect all equipment thoroughly, and wash your hands and other exposed skin thoroughly. Shower and change your clothes before coming into contact with other animals
- anyone who has had unplanned or accidental close contact with a suspect NiV case must wash with soap and water and seek medical advice as soon as possible
- given the similar epidemiology to Hendra virus infection, for more information see: Guidelines for veterinarians handling potential Hendra virus infection in horses V5.1.
Further information
Ching PK, de los Reyes VC, Sucaldito MN, Tayag E, Columna-Vingno AB, Malbas FF Jr, Bolo GC Jr, Sejvar JJ, Eagles D, Playford G, Dueger E, Kaku Y, Morikawa S, Kuroda M, Marsh GA, McCullough S, Foxwell AR. (2015) Outbreak of henipavirus infection, Philippines, 2014. Emerg Infect Dis. 21(2):328-31.
Halpin K., Hyatt A.D., Fogarty R., Middleton D., Bingham J., Epstein J.H., Rahman S.A., Hughes T., Smith C., Field H.E., Daszak P. (2011) Pteropid bats are confirmed as the reservoir hosts of henipaviruses: a comprehensive experimental study of virus transmission. Am J Trop Med Hyg. 85(5):946-51.
Middleton D.J., Weingartl H.M. (2012) Henipaviruses in their natural animal hosts. Curr Top Microbiol Immunol. 359:105-21.
3.25 Peste des petits ruminants
Fast facts
Peste des petits ruminants (PPR) is a highly contagious exotic acute viral disease of small ruminants which primarily affects sheep and goats.
Organism
Peste des petits ruminants virus (PPRV):
- enters through the upper respiratory tract epithelium
- does not survive long outside the host
- is inactivated by a range of disinfectants.
Susceptible species
PPR affects:
- small ruminants, with goats more severely affected than sheep
- captive and wild ungulates and camels.
Economic impact
There is potential for significant economic loss associated with high morbidity and mortality in small ruminants, as well as restrictions on animal movements and international trade.
Epidemiology
PPR:
- incubation period is usually 4–6 days but this may range from 3–10 days
- results in animals which are infectious during the incubation period and for up to 12 days after clinical signs first appear.
Transmission
Transmission is:
- mainly via close-contact airborne transmission (e.g. respiratory aerosols)
- via all secretions and excretions
- via fomites.
Clinical signs
Affected animals may suffer from peracute, acute or subacute disease.
Signs include:
- pyrexia, depression and sudden death with high mortality (peracute form)
- serous naso-ocular secretions, inappetence, diarrhoea, dysentery and ulcerative and necrotic erosive lesions on mucous membranes, pneumonia (acute form)
- milder signs in the subacute form.
Post-mortem
The following may be found:
- dehydrated carcasses
- inflammatory, necrotic and erosive lesions of the oral and nasal cavities, gastrointestinal tract and less commonly the genital mucous membranes
- ileocecal valve congestion
- splenomegaly and engorgement of mesenteric lymph nodes
- primary and secondary bronchopneumonia.
Samples
Collect:
- swabs of conjunctival discharge, nasal, buccal and rectal mucosa and lymph nodes (especially the mesenteric and bronchial nodes)
- whole blood in EDTA and plain tubes
- full range of tissue including lungs, intestine, spleen, liver and kidneys in 10% neutral-buffered formalin.
Actions to take
If you suspect a case of PPR:
- call the Emergency Animal Disease Hotline (1800 675 888) immediately or contact a government veterinarian in your state or territory
- isolate suspected cases and implement biocontainment protocols (including farm movement controls) until advised by government veterinary authorities.
Introduction
Peste des petits ruminants (PPR) is a highly contagious acute exotic disease of small ruminants caused by the peste des petits ruminants virus (PPRV). The disease is characterised by pyrexia, necrotic stomatitis, enteritis, bronchopneumonia and high morbidity and mortality.
Disease agent and susceptible species
PPRV:
- is a non-segmented, enveloped, negative-sense RNA virus belonging to the genus Morbillivirus in the family Paramyxoviridae
- has four genetic lineages (1–4) and multiple strains
- is antigenically similar to rinderpest virus (which was eradicated globally in 2011)
- hosts are principally sheep and goats, with goats more severely clinically affected
- causes sub-clinical infection and seroconversion in cattle, pigs and buffalo (but these animals are not known to play a role in transmission)
- infects other ungulates (including water buffalo and camels) and cause outbreaks of clinical disease in captive and wild ruminants
- infects deer under experimental conditions
- causes sub-clinical infection in camels or a mild form of the disease characterised by respiratory signs, diarrhoea, weight loss and decreased milk production
- is transmitted from camels to other camels and goats (but not to sheep)
- causes sub-clinical and clinical infection in captive and wild ungulates (including from the families Gazellinae, Tragelaphus, Antilopinae and Caprinaea)
- does not affect humans.
Distribution
PPR:
- occurs in most of sub-Saharan Africa, North Africa, the Arabian Peninsula, the Middle East and South Asia
- has expanded to east Asia (including Vietnam, China and Mongolia) and the European continent, with reports of PPR disease events in the Republic of Georgia in 2016.
For the latest information on the distribution of PPR, refer to the WAHIS information database website of the World Organisation for Animal Health (WOAH).
Occurrences in Australia
None reported.
Epidemiology
Modes of transmission
Transmission occurs via:
- direct contact between small ruminants and inhalation of fine droplets released during coughing and sneezing is considered an important mode of transmission
- indirect contact with infected urine/faeces
- semen and embryos (potentially)—while the ability of PPRV to transmit via artificial breeding is unknown, rinderpest virus (which is a similar virus) can be transmitted in reproductive material. The most likely risk entry pathway to Australia is the illegal importation of infected semen or embryos for artificial breeding purposes
- fomite transmission is possible.
Disease dynamics
- the incubation period lasts from 3–10 days, usually lasting 4–6 days
- PPRV can be shed during the incubation period, and animals often remain infectious for 10–12 days after clinical signs first appear
- often produces prolonged convalescence and surviving animals develop lifelong immunity
- may cause peracute, acute or subacute clinical disease and disease severity depends on factors including species, breed, age and immune status
- can cause morbidity and mortality of 100 per cent in immunologically naïve flocks.
Persistence of the agent
PPRV:
- does not typically survive for long periods in carcasses or the environment
- is rapidly deactivated by UV light and desiccation but can survive for longer periods in chilled and frozen tissues
- is a large, lipid-based, enveloped virus susceptible to a range of disinfectants including alkalis, halogens, phenolic compounds, citric acids, alcohol and ionophores.
Diagnosis and pathology
Clinical signs
Disease may be peracute, acute or subacute. There is no chronic form of this disease. Infections are most commonly seen in animals of all ages in immunologically naïve herds, and in animals older than 4–6 months in endemic regions. This is associated with waning of maternal immunity.
Peracute
Clinical signs include pyrexia, serous nasoocular secretions, mucous membrane congestion, diarrhoea, depression and sudden death.
Acute
Disease duration ranges up to 14 days and signs include:
- pyrexia, depression, inappetence, serous to mucopurulent nasoocular discharge, mucous membrane congestion, particularly in the buccal cavity
- mucopurulent discharge can cause eyelid matting and obstruct nostrils which may result in dyspnoea
- ulcerative and necrotic erosive lesions on the hard palate and other mucous membranes (appearing approximately 5 days after initial clinical signs), with gums becoming hyperaemic
- caseous fibrin deposits found on the tongue with associated hypersalivation and halitosis
- primary or secondary respiratory infections, including pneumonia
- profuse watery or haemorrhagic diarrhoea which may contain flecks of intestinal epithelium
- dehydration and emaciation
- abortion
- erosion and crusting of the lips, eyes, nose and vagina or vulva
- death, which may occur within 5–10 days of the onset of clinical signs.
Sub-acute
Sub-acute cases are more likely to occur in sheep in endemic regions and sub-clinical animals can act as viral shedders (but there is no long-term carrier state). Severe immunosuppression in sub-clinical animals may result in secondary infections such as pasteurellosis and Mannheimia haemolytica pneumonia.
Pathology
Findings may include:
- emaciated and dehydrated carcass
- well-demarcated, inflammatory, necrotic and erosive lesions of the oral and nasal epithelium, gastrointestinal tract and (less commonly) the genital mucous membranes
- linear engorgement and blackening of folds in the abomasum, caecum, proximal colon and rectum
- congestion of the ileocecal valve
- congestion and villi sloughing of the intestinal tract with mucosal haemorrhage, well-demarcated areas of ulceration or necrosis (erosive lesions are common in the abomasum)
- gastrointestinal necrosis of the mucosa and necrosis and collapse of Peyer’s patches
- hypertrophy, necrosis and haemorrhage of mesenteric lymph nodes and splenic atrophy and congestion
- enlarged spleen with petechial haemorrhages, red hepatisation, oedema of lymph nodes, especially the mesenteric lymph nodes
- pulmonary congestion, consolidation, and raised patches of emphysema on the lung
- erosions and petechiation of the nasal mucosa, turbinates, larynx, trachea and bronchopneumonia.
Differential diagnosis
Consider in the differential diagnosis of PPR in small ruminants:
- exotic diseases
- bluetongue disease (infection present in Australia but without clinical disease) (affects goats and sheep)
- foot-and-mouth disease (affects goats and sheep)
- contagious caprine pleuropneumonia (affects goats)
- heartwater (infection with Ehrlichia ruminantium) (affects goats and sheep)
- rinderpest (now recognised as globally eradicated by the WOAH) (affects goats and sheep)
- sheep and goat pox (affect sheep and goats)
- endemic diseases
- contagious ecthyma (orf) (affects sheep)
- malignant catarrhal fever (bovine herpesvirus 2 is present in sheep Australia) (affects sheep)
- coccidiosis (affects goats and sheep)
- pasteurellosis (affects goats and sheep)
- Mannheimia haemolytica (affects goats and sheep)
- non-infectious causes
- mineral poisoning (affects goats and sheep).
Samples required
Sample collection
Collect samples from clinically affected animals, ideally during the pyrexic stage, before the onset of diarrhoea. Alternatively, collect samples from animals that have recently died, or immediately after euthanised for post-mortem.
Samples to collect for diagnostic testing are:
- serum, from at least 10 animals (if possible) towards the end of the acute phase or from recovered animals
- EDTA blood, from live, clinically affected animals (7–10 ml/animal) during the acute phase (preferably from pyrexic animals)
- fresh tissue, including lymph node (especially the mesenteric and bronchial nodes), lungs, spleen, tonsils, tongue, affected areas of the alimentary tract (2 g of each tissue)
- fixed tissue, comprising a full range of tissues including lungs, intestine, spleen, mesenteric lymph nodes, liver and kidneys (in 10% neutral-buffered formalin)
- swabs, of conjunctival discharge as well as nasal, buccal and rectal mucosa. Collect from live, clinically affected animals (early during the acute phase) and preferably from pyrexic animals.
Transport of samples
For transport:
- chill blood samples and unpreserved tissue samples at either 4 °C, or with frozen gel packs
- place swab samples in virus transport media containing antibiotics and antifungals (or saline if other media is unavailable)
- DO NOT FREEZE SAMPLES at -20 °C; it reduces the sensitivity when used for virus isolation and molecular diagnostic tests
- send samples with dry ice if the journey is expected to take several days
- formalin fixed tissue can be sent at room temperature.
Sample submission
The relevant state or territory laboratory should coordinate sample packaging and consignment for delivery to the Australian Centre for Disease Preparedness.
Diagnostic tests
For PPR:
- available serological tests include competitive ELISA, indirect ELISA and viral neutralisation
- antigen detection tests include agar gel immunodiffusion test and an ELISA
- nucleic acid detection includes real-time reverse transcription polymerase chain reaction (real-time RT-PCR). These tests can differentiate the lineages of PPRV from the vaccination lineage
- viral isolates can only be detected during acute infection which is usually within days from the onset of clinical signs. Tests include viral isolation, antigen capture ELISA and lateral flow immunoassay.
Reporting requirements
PPR is an WOAH-listed disease and Australia has an international obligation to report cases.
If you suspect PPR, report it immediately. Call the Emergency Animal Disease Hotline on 1800 675 888, wherever you are in Australia. Alternatively, contact a government veterinarian in your state or territory.
Government duty veterinarians monitor the hotline and are available to advise you 24 hours a day, 7 days a week.
Biocontainment and personal protective equipment
There are no public health implications for PPR, but you should implement biocontainment protocols until advised by government veterinary authorities. This includes isolating suspected cases and using and appropriately disposing of personal protective equipment such as gloves, coveralls and rubber boots (or disposable boots). Thoroughly disinfect and decontaminate clothing, vehicle and equipment before leaving the property.
Further information
Baron, M. D., Diallo, A., Lancelot, R., & Libeau, G. (2016). Peste des Petits Ruminants Virus. Adv Virus Res, 95, 1-42.
Parida, S., Muniraju, M., Mahapatra, M., Muthuchelvan, D., Buczkowski, H., & Banyard, A. C. (2015). Peste des petits ruminants. Veterinary Microbiology, 181(1–2), 90-106.
Torsson, E., Kgotlele, T., Berg, M., Mtui-Malamsha, N., Swai, E.S., Wensman, J.J., Misinzo, G. (2016). History and current status of peste des petits ruminants virus in Tanzania. Infection Ecology & Epidemiology. 6. 32701.
3.26 Porcine epidemic diarrhoea
Fast facts
Porcine epidemic diarrhoea (PED) is an exotic viral disease of pigs characterised by diarrhoea and weight loss, and high piglet mortality.
Organism
PED virus (PEDV):
- replicates primarily in the small intestine, in villous enterocytes
- virulence varies with the strain of virus
- survives for 28 days at 4 °C and 7 days at 25 °C, and will not survive for longer than 7 days at room temperature
- is inactivated by most disinfectants.
Susceptible species
Only pigs are affected.
Economic impact
There is potential for significant economic loss due to the high number of mortalities in young animals, as well as restrictions on animal movements and international trade.
Epidemiology
PED:
- has an incubation period ranging from 1–4 days
- causes morbidity of up to 100 per cent, (particularly in a naïve herd)
- causes mortality of up to 100 per cent in neonatal piglets, and 5 per cent in adult pigs.
Transmission
Transmission occurs:
- via the faecal-oral route
- via fomites
- via contaminated pig blood products.
Clinical signs
Signs include:
- diarrhoea, often watery
- vomiting
- anorexia
- dehydration
- depression.
Post-mortem
You may see thinning of the intestines and fluid intestinal contents.
Samples
Also refer to the detailed section on sampling for pigs with diarrhoea.
- whole blood in EDTA and plain tubes
- faeces in sterile tubes
- full range of tissue including lungs, intestine, spleen, liver and kidneys fresh and in 10% neutral-buffered formalin.
Actions to take
If you suspect a case of PED:
- call the Emergency Animal Disease Hotline (1800 675 888) immediately or contact a government veterinarian in your state or territory
- isolate suspected cases and implement biocontainment protocols (including farm movement controls) until advised by government veterinary authorities.
Introduction
Porcine epidemic diarrhoea (PED) is an exotic viral disease of pigs which predominantly affects neonatal pigs. The disease is of particular concern in naïve herds (such as those in Australia) in which the disease may cause large outbreaks with near 100 per cent mortality in younger animals. Significant outbreaks have recently been seen in previously unaffected countries (such as the United States) resulting in 80 per cent mortality in suckling pigs and declines in pork production of 6–7 per cent.
Disease agent and susceptible species
PED virus (PEDV)
- is an enveloped, single-stranded RNA virus in the Alphacoronavirus genus within the family Coronaviridae
- can affect pigs already exposed to other porcine coronaviruses (transmissible gastroenteritis coronavirus and hemagglutinating encephalomyelitis virus) as exposure to these viruses does not provide cross protection to PED
- only affect pigs (Sus scrofa) and disease has only been detected in domestic pigs (the susceptibility of wild pigs is unknown).
Distribution
PED:
- was first detected in 1971 in the United Kingdom and subsequently caused epidemics of disease throughout Europe and Asia in the 1970s and 1980s
- causes occasional epidemics in Europe (where the disease is endemic), with disease usually manifesting as diarrhoea in weaned and grower pigs
- continues to cause significant disease in piglets in Asia
- was reported for the first time in 2013 in the United States, and then spread throughout the United States and Canada causing large numbers of mortalities in young pigs.
Occurrences in Australia
None recorded.
Epidemiology
Modes of transmission
Transmission occurs via:
- faeco-oral contamination is the most important mode of transmission
- fomites, as a result of faecal contamination of inappropriately decontaminated vehicles and farm equipment, has been an important transmission route between farms in the North American epidemics.
Disease dynamics
After ingestion of viral particles in faeces:
- PEDV replicates in the intestinal epithelial cells within the small intestine and (to a lesser extent) in the large intestine. This leads to exfoliation of the enterocytes and blunting of intestinal villi and an osmotic and malabsorptive diarrhoea
- the incubation period of the virus is estimated at between 1–4 days
- PEDV may be excreted for up to 35 days after clinical signs are noted.
Persistence of the agent
PEDV persistence in the environment is dependent on the temperature, humidity and substrate, with cooler temperatures and moist conditions allowing the virus to persist for longer periods of time. PEDV:
- has been shown to survive for 7 days at 25 °C in dry feed, and up to 14 days at 25 °C in wet feed
- is inactivated at temperatures above 60 °C
- is susceptible to inactivation by a range of disinfectants—formalin (1%), anhydrous sodium carbonate (4%), lipid solvents, iodophores in phosphoric acid (1%) and sodium hydroxide (2%).
Diagnosis and pathology
Clinical signs
Clinical signs vary with age and immune status, with younger pigs exhibiting more severe clinical signs. Signs include:
- watery diarrhoea
- vomiting
- anorexia
- depression.
Laboratory testing is required to exclude other causes of diarrhoea in pigs.
Pathology
Gross pathological lesions are usually confined to the gastrointestinal tract and may include:
- thinning of the intestine
- watery intestinal contents
- dilated intestinal loops
- undigested milk in the stomach and intestines of piglets
- faecal staining of the perineum.
Differential diagnosis
Differential diagnoses for PED are those which include diarrhoea as part of the clinical syndrome. Consider these diseases:
- exotic diseases
- African swine fever
- classical swine fever (hog cholera)
- porcine deltacoronavirus
- post-weaning multisystemic wasting syndrome
- transmissible gastroenteritis
- endemic diseases
- Clostridium spp.
- coccidiosis
- colibacillosis
- internal parasites
- porcine circovirus 2 infection
- proliferative enteropathy (ileitis)
- rotavirus infection
- salmonellosis
- swine dysentery
- yersiniosis
- non-infectious causes
- copper poisoning
- fluoride toxicity
- fungal/toxic mould poisoning
- iron toxicity in piglets
- lead poisoning
- mercury toxicity
- organochlorine toxicity
- organophosphate toxicity
- overfeeding
- pantothenic acid deficiency
- paraquat poisoning
- phosphorus toxicity
- salt poisoning
- zinc deficiency.
Samples required
Sample collection
Collect samples to investigate suspected endemic and exotic causes of gastroenteritis. Collect:
- formalin fixed tissues—a full range of tissues including the small and large intestine
- fresh faeces and tissues—small and large intestine
- serum, in the form of whole blood.
Transport of samples
For transport:
- chill blood samples and unpreserved tissue samples at either 4 °C, or with frozen gel packs
- DO NOT FREEZE SAMPLES at -20 °C; it reduces the sensitivity when used for virus isolation and molecular diagnostic tests
- send samples with dry ice if the journey is expected to take several days
- formalin fixed tissue can be sent at room temperature.
Sample submission
The relevant state or territory laboratory should coordinate sample packaging and consignment for delivery to the Australian Centre for Disease Preparedness.
Diagnostic tests
Laboratory testing is required to differentiate PEDV from other causes of diarrhoea in pigs. Real-time PCR is the preferred method for detecting viral nucleic acid, with a range of serological tests available for antibody detection. Other tests available include ELISA, virus isolation, immunohistochemistry, immunofluorescence and virus neutralisation.
Reporting requirements
PEDV is an WOAH-listed disease and Australia has an international obligation to report cases.
If you suspect PEDV, report it immediately. Call the Emergency Animal Disease Hotline on 1800 675 888, wherever you are in Australia. Alternatively, contact a government veterinarian in your state or territory.
Government duty veterinarians monitor the hotline and are available to advise you 24 hours a day, 7 days a week.
Biocontainment and personal protective equipment
There are no public health implications for PED, but you should implement biocontainment protocols until advised by government veterinary authorities. This includes isolating suspected cases and using and appropriately disposing of personal protective equipment such as gloves, coveralls and rubber boots (or disposable boots). Thoroughly disinfect and decontaminate clothing, vehicle and equipment before leaving the property.
Further information
Alvarez, J., Sarradell, J., Morrison, R., & Perez, A. (2015). Impact of Porcine Epidemic Diarrhea on Performance of Growing Pigs. PLoS ONE, 10(3), e0120532.
Dee S, Neill C, Singrey A, Clement T, Cochrane R, Jones C, Patterson G, Spronk G, Christopher-Hennings J, Nelson E. (2016) Modeling the transboundary risk of feed ingredients contaminated with porcine epidemic diarrhea virus. BMC Vet Res. 12:51.
Stevenson, G. W., Hoang, H., Schwartz, K.J. et al.. (2013) Emergence of Porcine epidemic diarrhea virus in the United States: clinical signs, lesions, and viral genomic sequences. Journal of Veterinary Diagnostic Investigation. 25(5), 649-654.
3.27 Porcine reproductive and respiratory syndrome
Fast facts
Porcine reproductive and respiratory syndrome (PRRS) is a highly contagious exotic viral disease of pigs.
Organism
PRRS virus (PRRSV):
- is present in most pig-producing countries
- is found in all tissues and body fluids
- is readily inactivated by heat and chemical disinfection and its environmental stability is poor.
Susceptible species
Only pigs are susceptible.
Economic impact
There is potential for significant economic loss associated with production losses, as well as restrictions on animal movements and international trade.
Epidemiology
- mortality varies with virulence of the virus isolate but is typically low
- the incubation period is 4–8 days but it may take longer to see signs in a herd
- prolonged (persistent) infection occurs.
Transmission
Transmission occurs via:
- direct contact, usually oronasal contact with infected fluid (e.g. saliva, oropharyngeal mucus, urine)
- contaminated fomites
- artificial insemination
- aerosol transmission.
Clinical signs
There are two syndromes: reproductive failure in sows and respiratory disease in young pigs. In boars and unbred replacement gilts and sows, transient pyrexia and anorexia may be observed.
Post-mortem
- the most common lesions are interstitial pneumonia and generalised lymphadenopathy
- lesions are more pronounced in younger animals and may be exacerbated by concurrent bacterial infection
- gross lesions are typically absent or nonspecific in aborted foetuses.
Samples
Also refer to the detailed section on sampling for pigs with reproductive problems. Samples from younger pigs are preferred. Collect:
- blood (EDTA and plain tubes)
- semen, oral swabs
- tissue from tonsils, heart, spleen, lymph nodes, kidney, lung.
Actions to take
If you suspect a case of PRRS:
- call the Emergency Animal Disease Hotline (1800 675 888) immediately or contact a government veterinarian in your state or territory
- isolate suspected cases and implement biocontainment protocols (including farm movement controls) until advised by government veterinary authorities.
Introduction
Porcine reproductive and respiratory syndrome (PRRS) is a highly contagious exotic viral disease (arterivirus) of pigs characterised by reproductive failure (abortions), death in piglets (stillborn and weak animals) and respiratory disease in all age groups. Other names applied to the syndrome include blue ear, swine infertility and respiratory syndrome, and pig high-fever disease
Disease agent and susceptible species
PRRS virus (PRRSV) has only one known host species—domestic and feral pigs (Sus scrofa).
PRRSV:
- is an enveloped RNA virus (genus Arterivirus, family Arteriviridae)
- has two related but antigenically distinguishable genotypes: type 1 (European genotype) and type 2 (American genotype). The latter predominates in North America and Asia. Within the two genotypes are multiple distinct variants that differ in infectivity, pathogenicity and epidemiology, and rapid genetic change and emergence of further novel strains is expected in the future.
Distribution
PRRS is reportedly the most prevalent disease of pigs in the world and:
- is endemic in most major pig-producing countries, with the highest economic impact in North America
- has been successfully eradicated a number of countries but has since recurred in some of these
- severe outbreaks (attributed to highly pathogenic PRRSV) have had a dramatic effect on pig health in China and Vietnam.
For the latest information on the distribution of PRRS, refer to the WAHIS information database website of the World Organisation for Animal Health (WOAH).
Occurrences in Australia
None reported.
Epidemiology
Modes of transmission
Transmission occurs via:
- direct contact with infected pigs (oral or intranasal) and their saliva, nasal secretions, urine, milk, colostrum and faeces
- vectors—insects such as biting flies and mosquitos can play a role in the transmission of the virus
- reproduction involving infective semen and vaginal secretions
- vertical transmission from viraemic dams to foetuses, resulting in foetal death or birth of infected pigs that are weak or appear to be normal. The virus crosses the placenta efficiently only in the last trimester of pregnancy
- airborne spread—aerosol transmission has been reported.
Disease dynamics
The maintenance of infection within herds is facilitated by persistent infection and the virus:
- infects macrophages at the site of infection (mucosal surfaces), followed by extension to regional lymphoid tissue and rapid viremia. Within 12 hours of experimental intranasal inoculation, virus is detectable within macrophages within the nasal mucosa, tonsils and lungs, as well as respiratory epithelial cells
- impairs host immunity, resulting in increased susceptibility to opportunistic pathogens
- incubation period is 4–8 days but clinical signs may take longer to emerge in a herd
- has been detected in serum and oropharyngeal mucus for 3 and 22 weeks, respectively
- is shed for an extended period in saliva (42 days), urine (14 days) and semen (43 days)
- has been recovered from the oropharyngeal area 157 days after experimental infection.
- Pigs have transmitted disease to commingled susceptible sentinel pigs 22 weeks after originally being infected and viral RNA has been demonstrated as late as 210 days after birth in the serum of pigs infected in utero.
Persistence of the agent
PRRSV:
- cannot withstand drying, so does not persist on equipment or other fomites beyond 1 day
- is most stable between pH 5.5 and pH 6.5; infectivity is reduced by over 90 per cent at a pH lower than 5 or higher than 7
- is unstable in low concentrations of detergents and is rapidly inactivated by lipid solvents and chlorine based disinfectants
- can survive in water for 11 days
- has been isolated from muscle and lymphoid tissue
- survives freezing in cell culture for a prolonged period and has been isolated after 1 month from muscle frozen at –20 °C, but levels of virus decrease with cooling, hardening and freezing
- can be recovered from muscle tissues 0–24 hours after slaughter but not from muscle held at 4 °C for 48 hours
- will survive in bone marrow for several weeks when stored at 4 °C
- is inactivated by heat.
Diagnosis and pathology
Clinical signs
PRRS is a severe systemic disease characterised by profound viraemia (often prolonged), and virus dissemination and replication in multiple organs. The clinical presentation of PRRS is highly variable with subclinical, mild or severe disease which may be associated with secondary infections. Diagnosis is strongly reliant on recovery and identification of the infective agent. In addition:
- in the field, the incubation period is variable, ranging from 3–37 days but commonly is between 4–8 days
- clinical manifestations vary greatly and depend on the strain of virus, the age and immune status of the pigs affected, the presence of co-infection, and husbandry factors
- clinical syndromes associated with PRRSV infection can be broadly divided into late-term reproductive failure and respiratory disease
- in endemically infected herds, PRRS presentation varies from asymptomatic infection to endemic respiratory disease, ongoing foetal loss or failure to thrive in weaners and grower-finished pigs
- highly pathogenic PRRSV causes more severe disease characterised by a persistent marked pyrexia and anorexia with red cutaneous discolouration and blue ears
- infection with PRRSV is a predisposing factor for bacterial pneumonia and septicaemia, and the clinical scope of disease may be complicated by co-infection with one or more concurrent pathogens.
Clinical signs in naïve herds include:
- anorexia and lethargy in all age groups
- reproductive losses including sporadic abortions or abortion storms, stillbirth, mummified foetuses and weak neonatal piglets
- high pre-weaning mortality in neonatal piglets, which are listless, weak and dyspnoeic
- pneumonia characterised by dyspnoea and respiratory distress in nursery and grower/finisher pigs
- ‘sow abortion and mortality syndrome’ resulting in up to 10 per cent sow mortality.
Pathology
As with clinical presentation, gross and histologic changes are poorly defined, and tend to vary with the strain of the virus and age of the affected animal. In addition:
- post-natal PRRSV infection is characterised by interstitial pneumonia and generalised lymphadenopathy
- post-mortem changes consistent with interstitial pneumonia include failure of the lungs to collapse, and a firm and rubbery texture with rib impressions
- lymph nodes are variably enlarged and white or tan coloured, consistent with lymphoid hyperplasia
Differential diagnosis
The clinical picture of PRRS is not specific and varies with PRRSV strain. In the field, suspicion of PRRS is based on clinical signs of reproductive failure and high levels of neonatal mortality. Analysis of farm records will provide helpful information.
Consider in the differential diagnosis:
- exotic diseases
- African swine fever
- Aujeszky’s disease
- classical swine fever
- foot-and-mouth disease
- influenza A viruses in pigs (exotic strains)
- Nipah virus infection
- porcine enterovirus infection
- postweaning multisystemic wasting syndrome
- endemic diseases
- enzootic pneumonia
- haemagglutinating encephalomyelitis virus infection
- haemophilus parasuis infection (Glässers disease)
- influenza A viruses in pigs (human-origin strains, subtypes H1N1, H1N2 and H3N2)
- leptospirosis
- porcine parvovirus infection
- porcine respiratory coronavirus infection
- proliferative and necrotising pneumonia
- syncytial pneumonia and myocarditis
- non-infectious causes
- carbon monoxide poisoning
- ingested toxins (e.g. pyrrolizidine alkaloids, paraquat)
- poor air quality such as high levels of dust and ammonia
- poor management
- poor nutrition
- zearalenone poisoning.
Samples required
Samples from younger rather than older animals are preferred as the virus is generally detected in higher amounts and for a longer time in younger pigs.
Sample collection
Collect:
- EDTA blood—7–10 ml/animal from live, clinically affected animals
- serum from at least 20 exposed animals in the herd. You can also detect antibody in oral fluid from ropes, though this method is not as sensitive
- fixed tissues in neutral-buffered formalin taken from recently euthanased affected pigs and from pigs that have recently died. Include cranioventral lung, tonsil, lymph nodes, heart, brain, thymus, spleen and kidney tissue and any lesions detected on post-mortem examination. Process tissues within 48 hours of fixation to avoid degradation of PRRSV antigens and loss of immunohistochemical positive cells
- fresh tissue from spleen, gastro-hepatic lymph node, mesenteric lymph node, tonsils, lung, kidney, ileum (2 g of each tissue)
- other samples—oral swab, semen, umbilical cords and umbilical cord blood, tonsils, lung, thymus, bronchial lymph nodes, heart, kidney, spleen, muscle transudate. Samples from live born pigs are preferred, as samples from mummified or aborted litters are unlikely to yield virus for agent detection.
Transport of samples
For transport:
- chill blood samples and unpreserved tissue samples at either 4 °C, or with frozen gel packs
- place swab samples in virus transport media containing antibiotics and antifungals (or saline if other media is unavailable)
- DO NOT FREEZE SAMPLES at -20 °C; it reduces the sensitivity when used for virus isolation and molecular diagnostic tests
- send samples with dry ice if the journey is expected to take several days
- formalin fixed tissue can be sent at room temperature.
Sample submission
The relevant state or territory laboratory should coordinate sample packaging and consignment for delivery to the Australian Centre for Disease Preparedness.
Diagnostic tests
Confirm the diagnosis by laboratory testing as there is considerable overlap in the clinical and pathological signs seen in PRRS with those of a number of other diseases (see differential diagnosis). For PRRS diagnosis the tests available are:
- screening by real-time PCR (qPCR) using a multiplexed real-time PCR that detects both type 1 and type 2 viruses
- an indirect enzyme-linked immunosorbent assay (ELISA) is used for serological screening
- immunoperoxidase detection on virus-infected cells is used as a confirmatory test
- histopathology and immunohistochemical staining.
Reporting requirements
PRRS is an WOAH-listed disease and Australia has an international obligation to report cases.
If you suspect PRRS, report it immediately. Call the Emergency Animal Disease Hotline on 1800 675 888, wherever you are in Australia. Alternatively, contact a government veterinarian in your state or territory.
Government duty veterinarians monitor the hotline and are available to advise you 24 hours a day, 7 days a week.
Biocontainment and personal protective equipment
There are no public health implications for PRRS, but you should implement biocontainment protocols until advised by government veterinary authorities. This includes isolating suspected cases and using and appropriately disposing of personal protective equipment such as gloves, coveralls and rubber boots (or disposable boots). Thoroughly disinfect and decontaminate clothing, vehicle and equipment before leaving the property.
Further information
Huong Giang NT, Lan NT, Nam NH, Hirai T, Yamaguchi R. (2016) Pathological Characterization of an Outbreak of Porcine Reproductive and Respiratory Syndrome in Northern Vietnam. Comp Pathol. 154(2-3):135-49.
Lunney JK, Benfield DA and Rowland RR (2010). Porcine reproductive and respiratory syndrome virus: an update on an emerging and re-emerging viral disease of swine. Virus Research 154:1–6.
Rossow KD (1998). Porcine reproductive and respiratory syndrome. Veterinary Pathology 35:1–20.
3.28 Rabies lyssavirus and infection with other lyssaviruses
Fast facts
Rabies is a zoonotic neurological disease almost invariably fatal to its hosts. Non-bat variants of lyssavirus (including rabies lyssavirus) are exotic to Australia and their introduction would have major public health implications.
Organism
Rabies lyssavirus belongs to the genus Lyssavirus, family Rhabdoviridae. In addition:
- the Lyssavirus genus includes 14 other recognised species and other proposed variants, including Australian bat lyssavirus (ABLV)
- lyssaviruses are readily inactivated by all main disinfectants and by ultraviolet light and heat treatment.
Susceptible species
Lyssaviruses infect all mammals, including humans (infections are almost invariably fatal).
Economic impact
An incursion of rabies lyssavirus would result in moderate to severe economic costs associated with intensive vaccination campaigns, as well as restrictions on animal movements.
Epidemiology
Rabies lyssavirus:
- is shed from saliva during clinical stages and can be shed for a short period before clinical signs are seen
- has a case fatality close to 100 per cent in humans and other mammals
- has an incubation period of normally around 2–6 weeks.
Transmission
Rabies lyssavirus is transmitted by the bite of an infected animal during clinical disease. Other lyssaviruses may be transmitted in a similar manner.
Clinical signs
Clinical signs of rabies lyssavirus and other lyssavirus infections are highly variable but all are attributable to the neurological effects of infection. Signs in animals fall into six main categories:
- excitation (aggression, hyperaesthesia, wandering, restlessness, self-inflicted trauma)
- paralysis (ataxia, paresis, dysphagia, facial asymmetry)
- loss of normal social and behavioural responses (personality changes and unusual tameness of wild animals)
- unusual vocalisation
- pica
- coma.
Post-mortem
There are no specific gross post-mortem changes.
Samples
- brain tissue (or entire head)
- (if brain is not available) spinal cord, ganglia, peripheral nerves and salivary gland.
Keep samples cold for storage and transport. If there is no cold chain, place samples in formalin.
Actions to take
If you suspect a case of rabies due to rabies lyssavirus or other lyssaviruses such as ABLV:
- call the Emergency Animal Disease Hotline (1800 675 888) immediately or contact a government veterinarian in your state or territory
- confine and isolate suspected animal cases where it is safe to do so. Alternatively, destroy the suspected cases and submit the brain material (or entire head) for laboratory confirmation. Implement biocontainment protocols (including farm movement controls) until advised by government veterinary authorities.
Public health considerations
- rabies caused by rabies lyssavirus and other lyssaviruses is a zoonotic disease
- people may become infected after being bitten or scratched by an infected animal or through close contact with saliva from an infected animal
- if a person is bitten, scratched or has close exposure to saliva from an infected animal, the bite or scratch wound should be washed thoroughly with soap and running water for 15 minutes and contact human health authorities immediately to ensure post-exposure prophylaxis is provided
- consult the relevant state or territory health authorities as soon as rabies is strongly suspected or confirmed.
Introduction
Rabies is a zoonotic neurological disease, which is almost invariably fatal to its hosts. Non-bat variants of lyssavirus (including rabies lyssavirus) do not occur in Australia and their introduction would have major public health implications.
Disease agent and susceptible species
Rabies is caused by infection with rabies lyssavirus and related lyssaviruses. Rabies lyssavirus:
- belongs to the genus Lyssavirus, family Rhabdoviridae
- affects mammals, including humans (infections are almost invariably fatal)
- is maintained by various carnivore species (particularly domestic dogs) and bats.
Bats are the natural hosts of most lyssavirus species and many species of lyssavirus are maintained in insectivorous bat species as well as in fruit bats. As little is understood of the virus transmission cycles, all bats should be considered capable of supporting lyssavirus replication and shedding.
Lyssaviruses:
- cause similar acute, fatal, neurological disease in mammals
- can infect all mammals, however; different viruses appear adapted to a particular host species (hence, dog rabies lyssaviruses are optimally adapted to dogs, and although other mammals can become infected, the transmission of infection in these species is less efficient)
- have 14 virus species in the lyssavirus genus (as of 2018).
Public health considerations
- people may become infected after being bitten or scratched by an infected animal, or through close contact with saliva from an infected animal
- people in close contact with infected animals should be vaccinated against rabies
- when in close contact with infected animals use personal protective equipment such as bite resistant gloves and coveralls, rubber boots (or disposable boots), safety glasses and mask
- if personnel are bitten or scratched by a potentially infected animal that they thoroughly wash the wound with soap and running water for 15 minutes and immediately seek medical advice
- consult the relevant state or territory health authorities in the case of a rabies outbreak.
Distribution
Rabies lyssavirus:
- occurs throughout most of the world except in Antarctica, Australia, New Zealand, Papua New Guinea, Japan, much of western Europe and many of the small islands
- has persisted in wildlife species in many areas of the world where dog rabies has been controlled
- in wildlife has been eradicated over large areas of Europe and North America by distributing baits with oral vaccines
- has been eradicated (in dog-cycle rabies) in Europe, North America and Japan by using injectable vaccines, which have also reduced its frequency in many other regions.
Other lyssaviruses have been reported in Europe and Asia, Africa and Australia. Antibodies to ABLV have been reported from bats from the Philippines. It is possible that bat lyssaviruses occur wherever bats are present.
For the latest information on the distribution of rabies lyssavirus and other lyssaviruses, refer to the WAHIS information database website of the World Organisation for Animal Health (WOAH).
Occurrences in Australia
In Australia:
- Rabies lyssavirus was suspected in several related cases in Tasmania in 1867. There have been a number of confirmed human cases in returning travellers from rabies endemic countries
- ABLV is present in flying-fox (Pteropus spp.) populations (Pteropus variant virus) and has been reported in a small number of insectivorous yellow-bellied sheathtailed bats (Saccolaimus flaviventris), (insectivorous variant virus)
- ABLV infection has been reported in three humans and two horses. The insectivorous variant virus was involved in one of the human cases and in the two horse cases. The Pteropus variant virus was involved in two of the human cases.
Epidemiology
Modes of transmission
Transmission occurs through:
- inoculation of saliva into bites, scratches and wounds—rabies lyssavirus is shed in saliva so bites (the most frequent means of transmission) and contact with saliva from infectious animals pose a risk of transmission. Two cases of human infection (leading to death from a disease indistinguishable from rabies) with ABLV have occurred following bites and scratches from infected bats
- ingesting carcasses of animals affected by lyssavirus. Animal products, and byproducts from an animal affected by lyssavirus should be regarded as potentially infectious and not permitted to enter the food chain
- inhalation of aerosol is also a potential route of transmission.
Disease dynamics
Current knowledge indicates that rabies lyssavirus and other lyssaviruses have essentially the same pathogenesis. After the inoculation of virus into a wound:
- the virus replicates in local tissues and within hours to days after a bite and soon afterwards invades the peripheral nerves. During the incubation period, the virus is transmitted by axons to the central nervous system (CNS). The CNS is invaded by virus, clinical signs become apparent, and the disease course becomes irreversible
- the incubation period (from bite to initial neurological signs) in all animals is rarely less than 10 days and is normally around 2–6 weeks (and in rare cases may exceed 6 months)
- the duration of the incubation period varies according to virus strain and dose, the distance of the bite site from the CNS, and the richness of the sensory innervation at the site of virus entry into the body
- no clinical, pathological or immunological signs are apparent during the incubation period
- the virus is shed in saliva from about the time of onset of clinical signs
- viral shedding coincides with behavioural changes that lead to biting of other animals
- disease, once it appears, is acute and progressive, invariably causing death
- there is a typical progression of excitatory to paralytic disease.
The following is known about lyssavirus hosts.
- ecological factors determine epidemiology in different host species.
- dog rabies lyssavirus (urban rabies) is dominant in areas (urban and rural) where there is a high proportion of unvaccinated and semi-owned or stray dogs.
- for rabies lyssavirus in wildlife species (sylvatic rabies), it is usually one wildlife species (e.g. foxes, raccoons, skunks or bats) in the ecosystem that is responsible for perpetuation of the disease.
- in dogs and other reservoir hosts, outbreaks of rabies can occur in local epidemics that last for several months.
- cattle, sheep and other herbivores (spillover hosts) are usually infected with rabies lyssavirus following attacks by a reservoir host animal showing clinical signs of rabies. These spillover host animals do not play a role in perpetuation of virus transmission cycles.
- vaccination markedly reduces the frequency of rabies lyssavirus in reservoir and spillover hosts. In reservoir hosts, an immunisation coverage of over 50 per cent of the population can result in a significant decline and if coverage exceeds 70 per cent this can lead to eradication of the disease.
- the transmission of ABLV to individual animals of other species is considered unlikely to result in the establishment of persistent transmission cycles in these species, as this would require adaptation of the virus strain to a new host species other than bats.
Persistence of the agent
Lyssaviruses:
- are comparatively fragile and do not retain infectivity for long outside the host
- are readily inactivated by all the main disinfectants (detergents, ethanol and iodine preparations) and by ultraviolet light and heat treatment.
Diagnosis and pathology
Clinical signs
CNS infection patterns, and therefore clinical signs, are varied but often include behaviour changes that lead to biting of other animals. The clinical signs of rabies caused by rabies lyssavirus can often be subtle and change rapidly. ABLV infection causes similar clinical signs in affected people and animals.
Clinical signs of disease in infected animals fall into six main categories:
- excitation—includes unprovoked aggression, over-reaction to external or perceived stimuli, aimless wandering, restlessness, self-inflicted trauma (scratching, biting)
- paralysis—can affect any of the motor systems, causing ataxia, knuckling of distal limbs, paresis, oral dysphagia and facial paralysis
- loss of normal social and behavioural responses—as wild animals ignore territoriality and encroach on urban areas, and nocturnal species become active by day. In companion animals, owners usually report personality change
- unusual vocalisation—whereby animals vocalise relentlessly. In dogs, muscular incoordination of the larynx causes a characteristic howling
- pica—can cause animals, particularly carnivores, to chew and swallow anything in their environment (such as soil, plants and bedding)
- coma—at the terminal stage of disease.
In addition, signs include: dehydration, red eyes, salivation, poor condition, unkempt pelage and signs of trauma. Cases of sudden death with few, if any, preceding signs have been reported.
Pathology
No remarkable gross pathological signs are usually evident, and when they are present are secondary to neurological effects. The following may be found in cases of rabies lyssavirus:
- dehydrated carcasses in poor physical condition, with signs of trauma (for example, broken teeth)
- signs of pica in carnivores (such as soil and plant material in the mouth and stomach).
Differential diagnosis
You should consider any other causes of neurological dysfunction as differential diagnoses for rabies lyssavirus or other lyssavirus infection. In all mammals the disease is acute, progressive and fatal. Where this is not the case, rabies generally can be excluded.
Consider in the differential diagnosis:
- exotic diseases
- Aujeszky’s disease (affects pigs)
- Borna disease (affects horses and sheep)
- bovine spongiform encephalopathy (affects cattle)
- eastern, western and Venezuelan equine encephalomyelitis viruses (affects horses)
- Japanese encephalitis virus and other flaviviruses (affects horses and pigs)
- scrapie (affects goats and sheep)
- endemic diseases
- bacterial and mycotic diseases of the central nervous system, including listeriosis and cryptococcosis (affects cattle, deer, dogs, goats, horses, pigs and sheep)
- canine distemper and infectious canine hepatitis (affects dogs)
- protozoal infections (such as babesiosis and toxoplasmosis) (affects cattle, deer, dogs and goats)
- West Nile-Kunjin virus infection (affects horses)
- non-infectious causes
- foreign bodies in the oropharynx or oesophagus and other traumatic injuries (affects cattle, deer, dogs, goats, horses, pigs and sheep)
- poisons, including ‘1080’ (sodium fluoroacetate), heavy metals (such as lead), chlorinated hydrocarbon and organophosphate pesticides, urea and nitrogen trichloride (affects cattle, deer, dogs, goats, horses, pigs and sheep).
Samples required
Take stringent precautions when collecting samples (including wearing full personal protective equipment) due to the zoonotic risk. A current rabies vaccination is necessary when working with bats. Likewise, submit whole bats rather than attempting to remove the head or brain. Unvaccinated persons must not remove animal heads or brains.
For the laboratory confirmation of lyssavirus:
- the brain is the most important sample
- the brain stem is the most consistently reliable sample for detection of infectious virus or viral antigen (other regions of the brain, including the hippocampus, are negative in up to 5 per cent of rabid animals)
- if the brain is not present, other suitable tissues include spinal cord, ganglia, peripheral nerves (taken from points close to the CNS) and salivary gland.
Sample collection
Collect:
- fresh composite brain samples—including several different parts (the preferred samples) of the brain for diagnosis. Do not store in formalin as a fluorescent antibody test cannot be performed reliably on formalin-fixed samples
- fixed composite brain samples—particularly if there will be a delay in the samples reaching the laboratory
- serum—serological tests are useful for confirming vaccine responses in animals and humans and for epidemiological studies in wildlife species, including bats.
Transport of samples
For transport:
- chill blood samples and unpreserved tissue samples at either 4 °C, or with frozen gel packs
- DO NOT FREEZE SAMPLES at -20 °C; it reduces the sensitivity when used for virus isolation and molecular diagnostic tests
- send samples with dry ice if the journey is expected to take several days
- formalin fixed tissue can be sent at room temperature.
Sample submission
The relevant state or territory laboratory should coordinate sample packaging and consignment for delivery to the Australian Centre for Disease Preparedness.
Diagnostic tests
Laboratory testing is required for the diagnosis of lyssavirus infection and is accomplished by one or more of the following procedures: PCR, immunohistochemistry and fluorescent antibody test.
Reporting requirements
ABLV is an WOAH-listed disease and Australia has an international obligation to report cases.
If you suspect ABLV, report it immediately. Call the Emergency Animal Disease Hotline on 1800 675 888, wherever you are in Australia. Alternatively, contact a government veterinarian in your state or territory.
Government duty veterinarians monitor the hotline and are available to advise you 24 hours a day, 7 days a week.
Biocontainment and personal protective equipment
Rabies caused by rabies lyssavirus and other lyssaviruses including ABLV, is a public health risk. You must implement stringent biosecurity procedures to protect human health:
- isolate and confine suspect animal cases (where it is safe to do so) or destroy animals and submit the brain material (or entire head or whole bat) for laboratory confirmation of lyssavirus infection
- wear protective (bite resistant) gloves, glasses, mask and coveralls, and avoid animal bites, aerosols and scratches when handling potentially infected animals
- if working with potentially infected animals, personnel must be vaccinated against rabies virus
- immediately seek medical advice if personnel are bitten or scratched by a potentially infected animal
- post-exposure prophylaxis must be rapidly initiated before the virus can replicate in the central nervous system. This consists of three components—washing and disinfection of the exposure site for at least 15 minutes, immunisation with vaccine, and immunoglobulin administration
- refer to guidelines on the pre- and post-exposure treatment of rabies compiled by the Australian federal and state government departments and the World Health Organization and, for PET, consult the Australian Immunisation Handbook.
Further information
Banyard, A. C., Fooks, A. R. (2017) The impact of novel lyssavirus discovery. Microbiology Australia. 38, 18–21.
Fooks AR, Banyard AC, Horton DL, Johnson N, McElhinney LM, Jackson AC. (2014) Current status of rabies and prospects for elimination. Lancet. 384(9951):1389-99.
Rupprecht CE, Hanlon CA, Hemachudha T. (2002) Rabies re-examined. Lancet Infectious Diseases. 2(6):327-43.
3.29 Rift Valley fever
Fast facts
Rift Valley fever (RVF) is an exotic acute, arthropod-borne zoonotic viral disease principally affecting domestic ruminants and people.
Organism
RVF virus (RVFV):
- has some isolates which differ in virulence
- is killed by strong sunlight and a range of disinfectants.
Susceptible species
RVF affects sheep and goats (highly susceptible), cattle, camels and humans.
Economic impact
There is potential for significant economic loss due to high morbidity and mortality in ruminants, as well as restrictions on animal movements and international trade.
Epidemiology
RVF:
- outbreaks occur over large areas following heavy rains and flooding
- incubation period ranges from 1–30 days
- morbidity depends on which species are affected.
Transmission
Transmission occurs:
- mainly from mosquitoes to vertebrate hosts
- via direct or indirect contact (by humans) with the blood or organs of infected animals, or from mosquito bites.
Clinical signs
In mature sheep, RVF may manifest as acute, subacute, chronic or convalescent disease. Disease is less severe in cattle but can cause abortion, and calf mortality may be high.
Signs include:
- high mortality and abortion storms (in sheep)
- rapid onset pyrexia, anorexia and haemorrhagic diathesis leading to death (in neonatal lambs)
- pyrexia, vomiting, anorexia, haemorrhagic diarrhoea and mucopurulent nasal discharge (mature sheep with acute disease)
- infertility in sheep and cattle.
Post-mortem
Post-mortem poses a health risk for humans and should only be performed if good biosecurity can be achieved. The most characteristic post-mortem lesions involve the liver and aborted foetuses have swollen, yellow livers.
Samples
Collect:
- blood samples (EDTA and plain tubes)
- liver, lymph nodes, spleen, foetal membranes (viral titres are high in aborted foetuses and foetal membranes)
- fresh tissue.
Actions to take
If you suspect a case of RVF:
- call the Emergency Animal Disease Hotline (1800 675 888) immediately or contact a government veterinarian in your state or territory
- isolate suspected cases and implement biocontainment protocols (including farm movement controls) until advised by government veterinary authorities.
Public health considerations
RVF is a zoonotic disease and:
- people may become infected after close contact with blood, body fluids or tissues of RVFV-infected animals
- less commonly, people can be infected with RVFV from bites of infected mosquitoes.
- Consult the relevant state or territory health authorities as soon as RVF is strongly suspected or confirmed.
Rift Valley fever (RVF) is an acute, arthropod-borne, zoonotic viral disease mainly affecting domestic ruminants. In ruminants the disease is characterised by abortion, high mortality in young animals and hepatopathy. People are also susceptible to the disease.
Disease agent and susceptible species
RVF:
- is caused by Rift Valley fever virus (RVFV), an enveloped RNA virus belonging to the family Bunyaviridae, genus Phlebovirus
- can cause severe disease in ruminants. Ruminants indigenous to regions in Africa where RVFV circulates endemically are relatively resistant to RVF, particularly Bos indicus cattle, but the susceptibility of Australian Bos indicus cattle is unknown
- causes significant disease in goats, and in sheep the virus is highly pathogenic
- affects camels and buffalo, which may become infected and develop mild disease
- causes influenza-like illness in humans, with severe complications in a minority of cases
- causes subclinical infection in cats and dogs (kittens and puppies are highly susceptible), horses, pigs and various wild species (for example, monkeys and rodents) but these species do not represent a major source of virus for vectors.
Public health considerations
- people may become infected after close contact with blood, body fluids, or tissues of RVFV-infected animals or from infected mosquitoes
- wear personal protective equipment such as gloves, disposable coveralls, rubber boots (or disposable boots) and masks when working with potentially infected animals to avoid any exposure to blood or tissues of RVFV-infected animals
- use insect repellents or netting to protect against mosquitoes and other bloodsucking insects
- consult the relevant public health authorities in the case of a RVF outbreak.
Distribution
RVF occurs throughout the African continent, with significant outbreaks in the last 30 years occurring in Egypt, southern and eastern African countries and Madagascar. RVF has been reported sporadically in Saudi Arabia and Yemen since 2000. A large outbreak occurred in Somalia and Kenya in 2006.
For the latest information on the distribution of RVF, refer to the WAHIS information database website of the World Organisation for Animal Health (WOAH).
Occurrences in Australia
None recorded.
Epidemiology
Large epidemics of RVF have occurred across a variety of ecological zones throughout Africa and the Arabian Peninsula at irregular intervals of 5–40 years, often in association with periods of above-average rainfall increasing mosquito vector breeding. Other risk factors include the presence of wetlands or waterlogged areas, large populations of arthropod vectors and susceptible livestock, large-scale irrigation projects and the transboundary movement of infectious livestock and their products.
Modes of transmission
Transmitting the disease via byproducts such as wool and hides is not well understood, and although semen collected from infectious animals is likely to contain the virus, the main mode of transmission is via vectors (from mosquito to animal). What is known is that:
- RVF is transmitted between animals by biting arthropods
- once RVFV is circulating and amplified in ruminants, it has the potential to infect a large number of arthropod vectors, including ticks and a variety of biting flies
- infected adult mosquitoes are likely to remain infectious for life and may transmit RVFV for the duration of their lifespan (up to 4 weeks)
- vertical (trans-ovarial) transmission occurs within Aedine spp. vectors, enabling agent survival and persistence between seasons between inter-epidemic periods.
To date, no human-to-human transmission of RVF has been documented. Human infections:
- mostly result from exposure to blood and fresh tissues (organs, carcasses, aborted materials) from infected animals, either via aerosol transmission or skin abrasions, or by biting mosquitoes (or, less commonly, flies)
- occur among farmers, herders, abattoir workers, veterinarians and laboratory personnel, who are at higher risk of infection through direct or indirect contact with the blood or organs of infected animals
- may result from drinking unpasteurised milk from infected animals (especially while animals are viraemic).
Disease dynamics
RVF:
- incubation period ranges from 1–30 days
- may be mild or sub-clinical in endemic areas
- epidemics cause abortion storms, devastating neonatal mortality and variably severe disease in mature animals with mortality rates up to 30 per cent
- virus is highly pathogenic in sheep and goats, but disease is relatively less severe in cattle
- is characterised (particularly following periods of above average rainfall) by the simultaneous occurrence of numerous cases of abortion and disease in ruminants, together with human illness.
Persistence of the agent
RVF:
- virus is stable in aerosol form and may persist in dried blood for up to 3 months (but survival times of up to 4 months and 21 days have been observed at 25 °C and 27 °C respectively)
- viral particles are susceptible to a range of disinfectants including chlorine-based disinfectant and detergents
- viral particles are destroyed by strong sunlight
- virus in milk is inactivated by pasteurisation
- viral titres in meat decline rapidly following slaughter and chilled meat is not likely to represent a hazard to human health.
Diagnosis and pathology
Clinical signs
RVF:
- disease in mature ruminants manifests as peracute, acute, subacute, chronic or convalescent forms
- disease is most severe in young sheep, goats and cattle
- commonly causes abortion in both sheep and cattle, and infertility may follow retention of foetal membranes and subsequent endometritis. Abortion may occur at any gestational age. Foetal death occurs rapidly in utero and the foetus may be aborted in an autolyzed state
- common haematology and clinical chemistry findings include leukopenia, thrombocytopenia and elevated liver enzymes.
Sheep are particularly susceptible to RVF and mortalities may exceed 90 per cent in neonatal lambs, 40–60 per cent in weaner lambs and up to 30 per cent in adults. In addition:
- adults commonly suffer subacute disease, with animals pyrexic for 24–96 hours
- lamb death may be sudden
- lambs may be viraemic within 8–12 hours following infection with RVFV, followed by a pyrexia at 24–36 hours preceding a rapidly progressive clinical course including anorexia, diarrhoea, jaundice and death within 24 hours.
Cattle mortality is usually less than 10 per cent (in adults) and may be accompanied by subacute diarrhoea and jaundice. Although RVF is less pathogenic in cattle, calf mortality may reach 70 per cent and is accompanied by pyrexia, anorexia and weakness.
Human infection with RVFV may result in mild or (less often) severe disease. In addition:
- disease is most commonly subclinical or mild, and associated with non-specific flu-like symptoms (including fever, muscle and joint pain and appetite loss lasting 4–7 days)
- a small proportion of people develop severe complications which fall into three syndromes: viral haemorrhagic fever, ocular disease or meningoencephalitis
- human mortalities are rare and tend to occur in patients who develop haemorrhagic fever.
Pathology
In aborted foetuses:
- foetal lesions are most consistently localised to the liver which is swollen and discoloured yellow to dark red
- gross lesions reflect viral tropism for hepatocytes.
In young animals, lesions are typically more acute and:
- the liver is swollen, friable and discoloured a yellow-tan, and generalised icterus may be present
- widespread petechiae and ecchymoses may be present on the serosal surfaces of abdominal viscera, including the liver, kidneys, gastrointestinal tract and lymph nodes.
In older animals:
- lesions may reflect an acute to subacute time course
- the liver is darker with scattered 1–2 mm areas of pallor throughout the liver indicative of necrosis.
Differential diagnosis
RVF should be highly suspected in ruminant disease outbreaks characterised by acute abortion storms and peracute neonatal death accompanied, by hepatic necrosis and haemorrhagic diathesis. This is particularly the case when acute febrile illness is also reported in people handling sick animals.
Consider in ruminants presenting with the clinical signs and gross lesions:
- exotic diseases
- bluetongue disease (affects cattle, goats and sheep)
- ovine enzootic abortion (Chlamydophila abortus) (affects sheep)
- peste des petits ruminants (affects goats and sheep)
- Wesselsbron virus (affects cattle, goats and sheep)
- Brucella abortus and B. melitensis (affects cattle, goats and sheep)
- endemic diseases
- Akabane virus (affects cattle, goats and sheep)
- any cause of septicaemia (affects cattle, goats and sheep)
- Brucella suis (affects cattle)
- Campylobacter foetus (affects cattle and sheep)
- enterotoxaemia (Clostridium perfringens type C or D) (affects cattle, goats and sheep)
- leptospirosis (affects cattle, goats and sheep)
- Listeria monocytogenes (affects cattle, goats and sheep)
- malignant catarrhal fever (only sheep-associated malignant catarrhal fever is endemic) (affects cattle)
- Neospora caninum (affects cattle)
- Q fever (Coxiella burnetti) (affects cattle, goats and sheep)
- Toxoplasma gondii (affects sheep)
- non-infectious causes
- hepatotoxins (such as aflatoxin and phytotoxins) (affects cattle, goats and sheep)
- copper toxicoses (affects cattle and sheep)
- anticoagulant toxicosis (for example from a pesticide such as Brodifacoum) (affects cattle, goats and sheep).
Samples required
Sample collection
Collect:
- fresh tissue samples of liver, spleen, lymph nodes and foetal membranes aseptically and place in sterile containers. Where possible, collect tissue for virus isolation from recently deceased animals or aborted foetuses
- whole blood from pyrexic animals using EDTA tubes
- fixed tissue samples for histopathology from the liver, spleen, lymph nodes, foetal membranes and brain (fixed in 10% neutral buffered formalin).
Transport of samples
For transport:
- chill blood samples and unpreserved tissue samples at either 4°C, or with frozen gel packs
- DO NOT FREEZE SAMPLES at -20°C; it reduces the sensitivity when used for virus isolation and molecular diagnostic tests
- send samples with dry ice if the journey is expected to take several days
- formalin fixed tissue can be sent at room temperature.
Sample submission
The relevant state or territory laboratory should coordinate sample packaging and consignment for delivery to the Australian Centre for Disease Preparedness.
Diagnostic tests
When RVF is suspected, undertake diagnostic tests at a biocontainment laboratory where the risk of exposure to highly infectious material can be appropriately managed. Characteristic histopathology findings (such as acute hepatocellular necrosis with eosinophilic intranuclear inclusion bodies) may increase suspicion of RVF. However, definitive diagnosis requires identification of the virus through one or a combination of the following tests: PCR, virus isolation, immunofluorescence, ELISA or virus neutralisation.
Reporting requirements
RVF is an WOAH-listed disease and Australia has an international obligation to report cases.
If you suspect RVF, report it immediately. Call the Emergency Animal Disease Hotline on 1800 675 888, wherever you are in Australia. Alternatively, contact a government veterinarian in your state or territory.
Government duty veterinarians monitor the hotline and are available to advise you 24 hours a day, 7 days a week.
Biocontainment and personal protective equipment
RVF infection is a public health risk. Human infections may result from contact with aborted foetuses, bodily fluids and tissues of infected animals (as well as aerosols generated during slaughter or post-mortem examination). Post-mortem examinations of animals that have died from RVFV infection pose a risk for animal-to-human transmission. Therefore, isolate and keep suspected cases of RVF on the property (and protected from vectors, if possible) until advised by government veterinary authorities and:
- wear appropriate personal protective equipment (coveralls and boots, gloves, mask) when examining animals, performing post-mortem examinations, or handling tissue, carcasses or abortion materials
- isolate sick/dead animals and limit contact with the sick/dead animals
- perform personal decontamination when leaving infected premises. You must also thoroughly clean and then disinfect vehicles and equipment before leaving the property.



Further information
Himeidan YE, Kweka EJ, Mahgoub MM, El Rayah el A, Ouma JO. (2015) Recent outbreaks of rift valley Fever in East Africa and the middle East. Frontiers in Public Health. 2:169.
Paweska JT. (2015) Rift Valley fever. Rev Sci Tech. 34(2):375-89.
Pepin M, Bouloy M, Bird BH, Kemp A, Paweska J. (2010) Rift Valley fever Virus (Bunyaviridae: Phlebovirus): an update on pathogenesis, molecular epidemiology, vectors, diagnostics and prevention. The Veterinary Record. 41(6): 61.
3.30 Scrapie
Fast facts
Scrapie is due to a prion that results in a fatal neurodegenerative disease.
Agent
- scrapie is due to a structurally-altered, protease-resistant form of prion protein (known as PrPSc)
- atypical scrapie (Nor98) is caused by spontaneous folding of prion protein
- prions are resistant to physical and chemical inactivation procedures.
Susceptible species
- sheep and goats (but with sheep, the host genotype influences susceptibility to both forms of scrapie).
Economic impact
There is potential for significant economic loss associated with restrictions on animal movements and international trade.
Epidemiology
- incubation period is protracted, typically 2–5 years (disease therefore manifests in adult animals)
- disease is always fatal.
Transmission
- horizontal transmission between animals likely occurs via ingestion
- vertical transmission may occur with classical scrapie in sheep
- natural transmission has not been observed with atypical forms of scrapie.
Clinical signs
Clinical signs include:
- changes in mentation, behaviour and posture or gait
- pruritis and self-trauma
- neurological disease accompanied by weight loss and emaciation.
Post-mortem
No gross lesions are detectable on post-mortem examination.
Samples
If safe to do so, and while wearing personal protective equipment, conduct a post-mortem and collect:
- whole brain fixed in 10% neutral buffered formalin
- 1–2 cm segment of fresh cervical spinal cord and/or caudal medulla (caudal to the obex).
Actions to take
If you suspect a case of scrapie:
- call the Emergency Animal Disease Hotline (1800 675 888) immediately or contact a government veterinarian in your state or territory
- isolate suspected cases and implement biocontainment protocols (including farm movement controls) until advised by government veterinary authorities.
Introduction
Scrapie is a progressive, fatal neurodegenerative disease of adult sheep, goats and mouflons. It may occur due to sporadic or heritable polymorphisms in the prion protein gene, or due to transmission of infectious prion between animals.
Disease agent and susceptible species
A structurally-altered, protease-resistant form (known as PrPSc) of the prion protein is the infectious agent transmitted between animals and is central to the pathogenesis of classical scrapie. Sheep and goats are susceptible and:
- susceptibility to disease varies between sheep breeds. Sheep with the ARR variant of the PrP gene are most resistant to disease whereas sheep homozygous for the variant VRQ/VRQ are most susceptible to scrapie
- in 1998, a variant form (‘atypical scrapie’ or ‘Nor98’) was found in a sheep in Norway
- the atypical form causes spontaneous disease in older animals and is distinguished from classical scrapie by distinct clinicopathological characteristics.
Distribution
Classical scrapie occurs in the United States, Canada, the United Kingdom, several European countries, Israel, India, Japan and Brazil. For the latest information on the distribution of scrapie, refer to the WAHIS information database website of the World Organisation for Animal Health (WOAH).
Occurrences in Australia
Following importation of affected animals from the United Kingdom, an isolated case of classical scrapie occurred on a single property in Victoria in 1952 and was successfully eradicated. Australia is free from classical scrapie.
Isolated cases of atypical scrapie have been detected globally, including in Australia.
Epidemiology
Modes of transmission
The precise mechanisms of scrapie transmission are not well understood, but what is known is that:
- animals are usually infected early in life, likely via oral exposure although vertical transmission may occur
- the prospect of maternal transmission is significant as affected ewes are likely to have several affected lambs before developing clinical signs
- scrapie spreads laterally among sheep grazing the same pasture and persists in affected flocks for prolonged periods
- foetal membranes, milk and contaminated materials, equipment, structures and vaccines are known sources of infection.
Disease dynamics
Disease presentation and progression is highly variable and may occur over a period of weeks to months. In addition:
- the agent initially proliferates in lymphoid tissue and the intestinal tract, and may take as long as 2 years to enter the CNS (potentially via splanchnic nerves)
- an additional 2 years may lapse before the onset of clinical signs
- due to the protracted incubation period, affected animals typically develop clinical disease at 2–5 years of age. With atypical scrapie, clinical disease usually appears in animals over 5 years of age and affects only single animals in a herd.
Persistence of the agent
Prion strains vary greatly in resistance to inactivation, and some are over a thousand times more resistant than others. In addition:
- PrPSc is resistant to physical and chemical inactivation procedures, including freezing, desiccation, ultraviolet radiation, degradation by various proteolytic enzymes, burial, and common methods of chemical and heat disinfection that destroy bacteria and viruses
- some organic acids can inactivate infectious prion proteins
- prions can adhere very strongly to stainless steel which may require special chemical disinfection.
Diagnosis and pathology
Clinical signs
The clinical course of scrapie is variable and protracted, and neurological signs may be slowly progressive over a period of weeks to months. In addition:
- the onset of clinical disease is typically characterised by mild changes in behaviour and gait
- affected sheep present with paraesthesia which manifests as pruritus, giving rise to the name ‘scrapie’
- animals may rub against fences or compulsively nibble at their legs and flanks resulting in self trauma and wool damage
- neurological signs are accompanied by weight loss, and eventually emaciation and death.
Pathology
No gross abnormalities are present in the brain.
Differential diagnosis
Differential diagnoses include disorders that affect the neurological function and locomotion, which includes:
- exotic diseases
- louping ill
- maedi-visna
- rabies
- endemic diseases
- botulism
- brain or spinal cord abscess
- Clostridium perfringens type D (focal symmetrical encephalomalacia)
- ectoparasites
- Listeria monocytogenes
- non-infectious causes
- brain or spinal cord trauma
- lead or plant toxicosis
- metabolic disease (hypomagnesemia, hypocalcaemia, polioencephalomalacia)
- neoplasia
- nutritional myopathy (white muscle disease).
Samples required
Sample collection
There is currently no validated diagnostic test available in Australia for detecting scrapie in live animals. Diagnostic tests require brain and spinal cord obtained at post-mortem examination. Although scrapie is not considered to be a zoonosis, note that you should:
- take precautions during sampling, including wearing full personal protective equipment
- take care when disposing or decontaminating equipment used for the post-mortem removal of brain tissue from suspected scrapie cases.
In addition:
- where scrapie is strongly suspected, direct efforts at collecting the brain and cervical spinal cord samples with minimal damage
- it may be possible to recover diagnostic material following mechanical injury to the brain (e.g. euthanasia by captive bolt)
- for suspected cases of scrapie, collect whole brain fixed in 10% neutral buffered formalin, and a 1–2 cm segment of unfixed (fresh) cervical spinal cord and/or caudal medulla (caudal to the obex).
Transport of samples
For transport:
- chill blood samples and unpreserved tissue samples at either 4 °C, or with frozen gel packs
- DO NOT FREEZE SAMPLES at -20 °C; it reduces the sensitivity when used for virus isolation and molecular diagnostic tests
- send samples with dry ice if the journey is expected to take several days
- formalin fixed tissue can be sent at room temperature.
Sample submission
Sample packaging and consignment for delivery to the Australian Centre for Disease Preparedness should be coordinated by the relevant state or territory laboratory.
Diagnostic tests
Histologic examination is required to identify characteristic lesions within relevant areas of the CNS (which differ from atypical scrapie), and to exclude differential diagnoses. In addition:
- immunohistochemistry (IHC) detects PrPSc aggregates in formalin-fixed brain sections and can be evaluated in conjunction with histological changes
- detection by western blotting of PrPSc in unfixed tissue homogenates has similar diagnostic sensitivity to IHC
- rapid ELISAs on unfixed tissue are typically used as a screening strategy in surveillance programs.
Reporting requirements
Scrapie is an WOAH-listed disease and Australia has an international obligation to report cases.
If you suspect Scrapie, report it immediately. Call the Emergency Animal Disease Hotline on 1800 675 888, wherever you are in Australia. Alternatively, contact a government veterinarian in your state or territory.
Government duty veterinarians monitor the hotline and are available to advise you 24 hours a day, 7 days a week.
Biocontainment and personal protective equipment
There are no known public health implications for scrapie, but you should implement biocontainment protocols until advised by government veterinary authorities. This includes isolating suspected cases and using and appropriately disposing of personal protective equipment.
During a post-mortem examination:
- minimise environmental contamination during post-mortem examination
- protect eyes and mucous membranes with safety spectacles and masks or a full face visor
- use a protective respirator
- minimise the use of sharps and where possible use single-use disposable items (e.g. scalpels)
- use suitable hand protection such as armoured or cut resistant gloves, especially during collection of the brain or spinal cord
- minimise the creation of contaminated bone dust by using hacksaws or bone forceps (rather than reciprocating or oscillating saws) for removal of the brain or spinal cord.
Further information
Australian and New Zealand Standard Diagnostic Procedure. Transmissible spongiform encephalopathies (pdf 2.29MB). 2010.
Cantile C & Youssef S: Nervous System. In: Jubb, Kennedy, and Palmer’s Pathology of Domestic Animals, ed. Maxie MG, 6th, vol. 1, pp. 347-350. Elsevier Saunders. Philadelphia, PA, 2016.
Protocol for the Management of Designated Zoo Animals Imported from Countries at Risk for Transmissible Spongiform Encephalopathies (TSES), Version 2016-17.
3.31 Screw worm fly
Fast facts
The Old World screw worm fly (Chrysomya bezziana) (OWS) and New World screw worm fly (Cochliomyia hominivorax) (NWS) are obligate parasites of warm-blooded animals, including humans. Infestation of and damage to animal tissues caused by screw worm fly (SWF) larvae is called myiasis.
Organism
- OWS and NWS belong to the family Calliphoridae (blowflies) of the order Diptera (true flies).
- OWS is typically found in the eastern hemisphere and NWS is found in the western hemisphere. The movement of infested animals or people and the warming climate can extend SWF ranges.
- SWF is susceptible to a wide range of insecticidal chemicals, with most targeting the larval stage.
Susceptible species
All warm-blooded animals, including humans, can be affected by SWF myiasis. Birds may be rarely affected.
Economic impact
There is potential for significant economic loss associated with production loss (especially cattle and sheep), control and eradication costs and restrictions on domestic and international trade.
Epidemiology
- SWF species are adapted to tropical and subtropical environments, with an optimal temperature range of 20–30°C.
- SWF species only lay eggs on live animals.
- Adult females lay eggs at the border of wounds or at the edge of body orifices.
- The SWF life cycle length is influenced by ambient temperature, with cooler climates resulting in extended durations of up to 2–3 months.
Transmission
SWF is transmitted by female flies that lay eggs on superficial wounds or mucocutaneous junctions of a live host animal.
Clinical signs
Clinical signs in animals affected by either OWS or NWS are similar:
- Maggots may be present in wounds.
- Wounds may exude a pungent, rotting smell.
- Non-specific signs include fever, lethargy, loss of appetite, debilitation, reduced growth rate and restricted movements.
- Animals may exhibit irritated behaviour, including restlessness, head shaking and constant licking of the lesion.
- Lesions may expand into body cavities, causing peritonitis, sinusitis or pleuritis, depending on the wound location.
- In a heavily infested herd, 10–15% of cattle may be struck at any one time. Heavier losses, which may be as high as 30–50%, are seen in newborn calves.
Post-mortem
- SWF feeds on live tissue; therefore, larvae are only ever found on recently dead animals.
- Gross and microscopic lesions are not helpful when diagnosing SWF infestation.
Samples
- Collect 10–20 larvae, suspected adult flies and eggs from animals with infested wounds.
- Place samples in 70–80% ethanol, methylated spirits or isopropyl alcohol.
- DO NOT use formalin.
Actions to take
If you suspect SWF infestation:
- call the Emergency Animal Disease Hotline (1800 675 888) immediately or contact a government veterinarian in your state or territory
- isolate suspected cases and implement biocontainment protocols (including farm movement controls) until advised by government veterinary authorities.
Public health considerations
- SWF myiasis can be a significant public health issue, especially in babies, the elderly and the immunocompromised.
- In people, myiasis typically occurs on the neck or scalp, but may be found on other parts of the body. It can quickly become debilitating if the eyes, mouth, sinuses or ears become infested.
- Consult the relevant state or territory health authorities as soon as human cases of SWF are strongly suspected or confirmed.
Introduction
The Old World screw worm fly (Chrysomya bezziana) (OWS) and New World screw worm fly (Cochliomyia hominivorax) (NWS) are parasitic pests of warm-blooded animals, including humans. Infestation by screw worm fly (SWF) larvae, known as myiasis, causes serious livestock production losses and public health issues.
Disease agent and susceptible species
- OWS and NWS belong to the family Calliphoridae (blowflies) of the order Diptera. They are considered the primary screw worm species.
- Adult flies of both species resemble other blowflies, with shiny blue-green bodies and yellow-orange faces. Adult size varies, but body length is up to 10 mm and head width up to 4.1 mm.
- SWF larvae require the soft tissue of live warm-blooded animals for development.
- If OWS enters the Torres Strait or Cape York Peninsula, feral animals, including pigs and deer, will likely serve as important hosts.
- Myiasis in feral pigs has been reported in North, Central and South Americas, with infested pigs generally affected by superficial myiasis, in contrast to cattle, which suffer from deep myiasis.
- Australian native fauna have been demonstrated to be susceptible, with OWS found in a red kangaroo and agile wallabies in a Malaysian zoo, and in tree kangaroos in New Guinea.
- Some species of deer may also act as effective hosts should OWS enter Australia.
Public health considerations
- Humans can be hosts for SWF larvae, resulting in SWF myiasis.
- SWF myiasis can be a significant public health issue, especially in babies, the elderly and the immunocompromised.
- Consult the relevant state or territory health authorities as soon as human cases of SWF are strongly suspected or confirmed.
Distribution
- The geographic ranges of the OWS and NWS flies do not currently overlap. However, they share similar ecological niches, so their potential distributions could overlap with warming temperatures or the movement of infested animals or humans.
- OWS occurs throughout the Indian subcontinent, the Middle East, tropical and sub-Saharan Africa, South-East Asia, East Asia, and parts of the Pacific, including areas of Papua New Guinea that border the Torres Strait.
- NWS is endemic in the Caribbean and parts of Central and South America, as far south as Argentina.
- NWS was eradicated from the United States, Mexico and some Central American countries using an area-wide integrated pest management approach that included Sterile Insect Technique (SIT). A permanent barrier of sterile insects is maintained in eastern Panama to protect NWS-free areas.
- Periodic outbreaks of NWS still occur in North America. In 2016, an outbreak of SWF myiasis in deer in Florida was reported, with successful eradication using SIT containment and livestock movement checks.
- Climate change is predicted to significantly expand the potential range of SWF.
For the latest information on the distribution of SWF, refer to the WAHIS information database website of the World Organisation for Animal Health (WOAH) or the FAO EMPRESi Global Animal Disease Information System.
Occurrences in Australia
SWF has never become established in Australia. However, there have been three reported incursions. In 1988, OWS was detected in Darwin Harbour on an empty livestock vessel from Brunei, and in 1992 and 2012, NWS larvae were found in lesions on travellers from South America. In all cases, SWF was eradicated before establishment by removing the larvae before they had a chance to pupate.
The Torres Strait, Cape York Peninsula and the Northern Territory are considered high-risk areas for entry of OWS. The movement of animals within South-East Asia and PNG has also been identified as a risk factor for Australia.
Epidemiology
Factors influencing transmission
- The occurrence of SWF is temperature-dependent. In some areas, SWF can be a seasonal parasite, spreading into comparatively cooler areas in the warmer months. It can survive in hotter conditions, provided there is adequate vegetation and humidity.
- Transmission of SWF is influenced by environmental conditions, the distribution and dispersal of flies (e.g. transport or movement of infested animals, contaminated soil containing viable pupae and winds) and availability of suitable hosts (e.g. those having undergone routine husbandry procedures such as castration and dehorning).
- Mated female flies may disperse widely in search of wounded hosts. The median distance is approximately 10 km, with reports of movements of over 100 kilometres.
- Screw worm myiasis is not easily transmitted from host to host.
Disease dynamics
- Infestations of SWF maggots occur when an adult female fly lays eggs on a superficial wound or mucous membrane of a live host animal. The maggots burrow into the flesh and feed until mature, then drop off the host to pupate on the ground.
- Eggs typically hatch approximately 12–20 hours after being laid on a live animal host. Larval development then occurs over 5–8 days. After this time, the larvae evacuate the wound then drop to the ground and burrow into the soil to a depth of approximately 2 to 3 cm and pupate within 24 hours. Adult flies emerge after 7 days under optimal conditions (e.g. 28°C), but it may be longer in cooler temperatures.
- Time of day is important to the life cycle, with oviposition and larval evacuation occurring at dusk or during the night to avoid sunlight and diurnal predators.
- Females are attracted to the putrid odour from wounds.
- Other flies may also be attracted, which can lead to secondary fly infestations and secondary bacterial wound infections.
Persistence of the agent
- SWF are cold intolerant—they are unlikely to mate in temperatures less than 16°C and will not move readily below 10°C. SWFs do not survive over winter in locations where frosts occur, as all life stages are susceptible to freezing and will die.
- Ambient temperatures over 38.5°C are likely to result in 100% mortality in adults.
- SWF are sensitive to various insecticidal chemicals, including organophosphate insecticides, carbamate and pyrethroid compounds.
- Most insecticides target the larval stages of SWF, while others act as repellents against adult flies.
Diagnosis and pathology
Clinical signs
Consider SWF in the event of any myiasis. The clinical signs in animals affected by either OWS or NWS are similar and include:
- putrid erosive to ulcerative wounds with maggots or eggs present (myiasis)—note that it may be hard to see maggots as they burrow deep into the wound
- progressive liquefaction, necrosis and haemorrhage of wounds
- lesions expanding into body cavities, causing peritonitis, sinusitis or pleuritis, depending on the wound location
- secondary bacterial infection of the wounds
- non-specific signs including fever, lethargy, loss of appetite, debilitation, weight loss, reduced milk yield and restricted movement
- behaviours suggestive of discomfort, pain or irritation including restlessness, head shaking or constant licking of a lesion
- increased morbidity and mortality in newborns, and occasional deaths in other ages. If untreated, animals may die within one to 2 weeks due to toxicity and/or secondary bacterial infections.
Wounds do not need to be enlarged for it to be caused by SWF, although there does need to be evidence of fly life stages present in the wound.
Pathology
- Gross and microscopic lesions do not help with diagnosis of SWF infestation.
- SWF only feed on live tissue, so larvae will only be found on a recently dead animal.
- Secondary infection from another blowfly species is possible, which may confuse diagnosis.
Differential diagnosis
Other myiasis-causing flies endemic or exotic to Australia should be considered.
- Exotic flies to Australia include:
- Cochliomyia macellaria (secondary screw worm fly)
- Phormia regina
- Booponus intonsus
- Chrysomya albiceps (banded blowfly)
- Cordylobia anthrophaga (Tumbu fly or human warble fly or skin maggot fly)
- Hypoderma bovis and H. lineatum (cattle warble flies)
- Tunga penetrans (sandflea)
- Wohlfahrtia magnifica (Wohlfahrt’s wound myiasis fly)
- Wohlfahrtia nuba (chequerspot fly)
- Wohlfahrtia vigil.
- Endemic flies to Australia include:
- Lucilia cuprina (Australian sheep blowfly)
- Chrysomya rufifacies (hairy maggot blowfly)
- Chrysomya megacephala (Oriental latrine fly)
- Chrysomya saffranea (steel-blue blowfly)
- Chrysomya varipes (small hairy maggot blowfly)
- Lucilia sericata (English sheep blowfly or common green bottle fly)
- Sarcophagidae (flesh flies)
- Australophyra rostrata (black carrion fly)
- Calliphora stygia (brown blowfly)
- Chrysomya nigripes.
- SWF should be a considered a possible differential in cases of flystrike in cattle, particularly in northern Australia.
Samples required
Sample collection
Collect these samples from animals with infected wounds, taking care to avoid damaging the specimens during handling:
- 10–20 larvae using forceps:
- flush the wound with clean water and collect from the deepest areas of the wound, to avoid collecting superficial larvae from non screw worm species
- ideally collect mature, third instar larvae
- immerse larvae in boiling water for 15–30 seconds or pour freshly boiled water over the larvae and wait for 2 minutes, for optimal preservation before placing in a collection container
- suspected adult screwworm flies
- suspected screwworm eggs (scrape off wound using a scalpel).
Collection containers:
- Adult flies, larvae and eggs should be placed in 70–80% ethanol, methylated spirits or isopropyl alcohol—use separate specimen containers for each life stage if possible.
- DO NOT use formalin.
- Maggot collection kits can also be sourced from your relevant state or territory agriculture department, or through Animal Health Australia.
Transport of samples
For transport:
- ensure samples are packaged safely to keep specimens whole and intact
- if larvae will be used for PCR testing, samples can be prepared as above then stored at −20°C.
Sample submission
Samples should be submitted to the relevant state or territory laboratory.
Diagnostic tests
- morphological examination under microscopy of:
- larvae (third instar most common)
- adult flies
- eggs, other larval stages and pupae—examination is still possible, but more difficult
- real-time PCR detection.
Reporting requirements
Infestation of SWF is reportable in Australia. SWF is a WOAH-listed disease and Australia has an international obligation to report cases. If you suspect SWF infestation, immediately report the disease by phoning the Emergency Animal Disease Hotline on 1800 675 888 anywhere in Australia. Alternatively, contact a government veterinarian in your state or territory.
Biocontainment and personal protective equipment
SWF is a public health risk. Any wound is susceptible to infestation and immunocompromised individuals are at higher risk. You must take this risk into consideration when investigating myiasis in animals. Therefore, it is important to seek advice from government veterinary authorities, noting:
- Ensure the appropriate use and disposal of personal protective equipment such as gloves, disposable coveralls and rubber boots (or disposable boots).
- Measures should be taken to manage the risk of SWF exposure to people, including keeping wounds clean and covered and using insecticides and repellents.
- Preventing the spread of fertile adult flies from an infested host requires the manual removal of active larvae in open wound tissues (with forceps), followed by the application of a topical insecticide to prevent a recurrence of the myiasis. Any delay in treatment increases the possibility that larvae could emerge and fertile adult flies could escape to surrounding areas.
- Treatment of the environment may be necessary.
- Personal decontamination is required when leaving an infected premises. Thoroughly clean and then disinfect vehicles and equipment to remove gross contamination with soil and wastes that may contain different life stages of SWF before leaving the property.

Image credits: Skye Fruean, Department of Agriculture, Fisheries and Forestry
Further information
Fruean S and East I (2014) ‘Spatial analysis of targeted surveillance for screw-worm fly (Chrysomya bezziana or Cochliomyia hominivorax) in Australia’, Australian Veterinary Journal, 92(7):254–262, doi:10.1111/avj.12197.
Gutierrez AP, Ponti L and Arias PA (2019) ‘Deconstructing the eradication of new world screwworm in North America: retrospective analysis and climate warming effects’, Medical and Veterinary Entomology, 33(2):282–295, doi:10.1111/mve.12362.
3.32 Senecavirus A
Fast facts
Senecavirus A (SVA) is a contagious vesicular disease of pigs that is clinically indistinguishable from other vesicular diseases of pigs, such as FMD.
Organism
SVA:
- is also known as Seneca Valley virus
- is a picornavirus of the same family that includes foot-and-mouth disease (FMD) and swine vesicular disease (SVD)
- is likely capable of replicating in multiple organs
- is highly sensitive to bleach.
Susceptible species
Only pigs are clinically susceptible.
Economic impact
There is potential for significant economic loss due to the high morbidity in infected pigs, as well as additional losses resulting from restrictions on animal movements, control and eradication efforts and disruption to international trade.
Epidemiology
SVA:
- outbreaks have been reported globally, in North America, South America, South-East Asia, China and the United Kingdom
- outbreaks are reported to be seasonal, with most cases occurring between spring and autumn
- causes mortality rates up to 70% in piglets
- has an incubation period of 3–5 days following experimental infection
- can produce persistent infection and a carrier status
- infection can be subclinical.
Transmission
Transmission routes are not well understood, but SVA is generally thought to spread via:
- direct contact from nasal secretions and excretions of infected pigs
- fomites such as contaminated feed and equipment
- mechanical vectors (e.g. biting house flies).
Clinical signs
SVA can cause subclinical, mild or severe vesicular disease. Clinical signs are transient and similar to those seen in other vesicular diseases of pigs. The main clinical signs are:
- vesicles and ulcers on the snout, lips, tongue, coronary band and interdigital areas
- cutaneous hyperaemia
- lameness
- pyrexia
- anorexia
- diarrhoea
- death in neonatal piglets, often not associated with vesicular lesions.
Post-mortem
- post-mortem lesions of SVA are generally restricted to vesicle formation and resolution
- lesions typically resolve 8–10 days after infection.
Samples
Collect:
- serum, 7–10 ml/animal in plain tubes
- vesicular fluid
- fresh tissue, epithelium, epithelial tags; oral, nasal and tonsillar swabs; and oropharyngeal fluid and submit in phosphate buffered saline (PBS) or virus transport medium (VTM), if available.
Actions to take
If you suspect a case of SVA:
- call the Emergency Animal Disease Hotline (1800 675 888) immediately or contact a government veterinarian in your state or territory
- implement biocontainment protocols (including farm movement controls) until advised by government veterinary authorities.
Introduction
Senecavirus A (SVA) is an acute, highly contagious but rarely fatal, exotic vesicular disease of pigs. SVA is considered an emerging infectious disease due to its rapid increase in incidence and geographic range since 2015. Rapid differentiation from FMD is essential.
Disease agent and susceptible species
- Senecavirus A (SVA):
- belongs to the genus Senecavirus in the family Picornaviridae, which also contains FMD virus (FMDV) and swine vesicular disease virus (SVDV)
- has only one serotype and is the only single species in the genus Senecavirus
- is a single-stranded, non-enveloped, positive-sense RNA virus
- is associated with a syndrome known as epidemic transient neonatal losses in piglets.
- SVA neutralising antibodies have been detected in swine, cattle and mice. However, it is not known whether cattle, wild-cloven-hoofed animals or mice are directly infected or what their epidemiological role is.
- Mink have been experimentally infected.
Public health considerations
SVA is not considered a zoonotic disease risk.
Distribution
- SVA has circulated in pig herds in the USA since 1988, but was not formally identified until 2002.
- Since 2015, outbreaks have been reported in Canada, England, Brazil, China, Thailand, Colombia, Chile and Vietnam.
However, because SVA is not a notifiable disease to WOAH and countries are not obligated to report cases, its distribution may be wider than currently documented.
Occurrences in Australia
SVA has never been detected in Australia.
Epidemiology
Modes of transmission
Transmission routes for SVA are not well understood, but are thought to occur via:
- direct contact with infected pigs. The virus is shed in nasal and oral secretions and faeces. Movement of infected pigs is considered the most important means of spread.
- indirect contact with fomites such as contaminated feed and equipment. The importation of contaminated feed has been implicated in the transport of SVA between countries, but further research is needed to assess this risk.
- mechanical vectors—SVA has been detected in mice and biting houseflies and their faeces, and it is thought that these species may play a minor role in the spread between farms.
Urine and semen should also be considered as possible routes for viral dissemination, with further research needed.
Disease dynamics
- Sows and finisher pigs typically experience high morbidity (80–90%) with low mortality.
- Neonates in the first week of life may experience higher morbidity (up to 70%), with mortality rates ranging from 5 to 60%. This is often referred to as epidemic transient neonatal loss and is associated with high viral load in the tissues.
- Experimental studies have demonstrated an early serological response in finisher pigs with clinical signs being observed from 4 days post-inoculation, which then persist for approximately 2–10 days.
- Detection of high viral loads in a range of tissues suggests SVA is capable of replicating in multiple organs.
- Virus shedding commences on day 1 of inoculation and can continue up to 28 days in oral and nasal secretions and faeces. Virus can still be detected in the tonsils at 38 days post-inoculation.
- Vesicles typically rupture around 5–6 days post-infection and the lesions are resolved by 12–16 days post-infection.
- Persistently infected carrier animals can shed SVA in oral and nasal secretions or faeces and provide a reservoir of infection for other susceptible animals. Intermittent viraemia and viral shedding have been detected up to 60 days post-infection.
Persistence of the agent
The survival of SVA in the environment has not been reported but it is considered to be relatively robust given other picornaviruses such as FMDV and SVDV are highly stable in the environment.
- SVA can survive up to 91 days at 4°C in contaminated feed, such as soybean meal and grains. Temperatures ≥ 30C may result in inactivation of contaminated feed, depending on the feed matrix.
- The efficacy of many disinfectants against SVA remains unknown; therefore, disinfection protocols for FMDV should be followed if SVA is suspected. This includes sodium hydroxide, sodium carbonate, 3.0% citric acid, aldehydes and oxidising disinfectants such as sodium hypochlorite.
- SVA is destroyed by disinfectants including bleach (sodium hypochlorite) (5.25%, 1:20 dilution).
- Ultraviolet C light can inactivate SVA on plastic in the absence of organic material. This is not the case for permeable surfaces such as cloth and cardboard.
Diagnosis and pathology
Suspect SVA and other vesicular diseases when vesicles or erosions are found on the mouth and or feet of pigs. Other vesicular diseases must be ruled out with laboratory tests.
Clinical signs
SVA can cause a subclinical, mild or severe vesicular condition, although it is not well described why some animals have worse pathology than others. Clinical signs, when present, are indistinguishable from other vesicular diseases including FMDV, SVDV, vesicular stomatitis virus (VSV), or vesicular exanthema of swine virus (VESV). Infected animals can have transient viremia and shedding without clinical disease.
In grower and finisher pigs, clinical signs may include:
- vesicular lesions on the snout, lips, tongue, coronary bands and interdigital spaces
- lesions beginning with erythematous or blanched areas of the skin progressing to vesicles with varying levels of fluid that rupture leaving an erosion on the skin that crusts over and resolves, usually 8–10 days after infection
- crusting and sloughing of the hoof
- lameness, typically associated with broken vesicles along the coronary band
- transient pyrexia
- lethargy
- anorexia.
In neonates, clinical signs typically last for 3–10 days, followed by a full recovery in piglets that survive. Signs may include:
- weakness
- lethargy
- hypersalivation
- cutaneous hyperaemia
- ulcerative lesions of the tongue and coronary band
- neurological signs
- diarrhoea
- death.
Pathology
In adults, post-mortem lesions are generally restricted to vesicle formation and resolution. In neonates, vesicular lesions are not often observed. However, as SVA is a pantropic virus that results in multisystemic disease, the following gross lesions may be seen on post-mortem:
- petechial haemorrhages of the kidney
- ulcerative lesions on the tongue, coronary band
- subcutaneous and mesenteric oedema
- interstitial pneumonia.
Differential diagnosis
SVA is clinically undistinguishable from other exotic viral vesicular diseases.
Consider in the differential diagnosis:
- exotic diseases
- foot-and-mouth disease
- swine vesicular disease
- vesicular exanthema of swine (not seen globally since 1956)
- vesicular stomatitis
- swine enteric coronavirus diseases such as porcine epidemic diarrhoea virus in piglets
- transmissible gastroenteritis in piglets
- porcine epidemic diarrhoea
- porcine deltacoronavirus in piglets
- porcine reproductive and respiratory syndrome in piglets
- endemic diseases
- Glässers disease (Haemophilus parasuis)
- colibaciollosis (Escherichia coli) in piglets
- porcine rotavirus infection in piglets
- enterotoxaemia (Clostridium perfringens) in piglets
- non-infectious causes
- chemical or thermal burns
- trauma to the mouth and feet
- lameness due to poor flooring
- idiopathic vesicular disease in pigs
- dermatophilus
- mycotic stomatitis
- phototoxic dermatitis with vesicle formations from contact with the leaves of plants of the Umbelliferae family (parsley, parsnips, celery)
- insect bite hypersensitivity.
Samples required
Sample collection
Note that sample collection is recommended for the detection of FMD. Collect these samples from clinically affected animals:
- serum - 7–10 ml/animal in plain tubes
- vesicular fluid—carefully use a syringe and needle to aspirate the vesicular fluid from unruptured vesicles, and place in a sterile container. Alternatively, collect fluid from ruptured vesicles onto a swab and place the swab in 500μl of buffer, such as phosphate-buffered saline or virus transport medium
- fresh tissue, epithelium, epithelial tags; oral, nasal and tonsillar swabs; and oropharyngeal fluid and submit in phosphate-buffered saline (PBS) or virus transport medium (VTM), if available.
In addition, if a post-mortem is conducted:
- fresh and fixed tissues of any lesions, regional lymph nodes, tonsils, spleen, liver, lungs, kidney, heart, intestines, brain and spinal cord.
Transport of samples
- Chill blood samples and unpreserved tissue samples at 4°C or with frozen gel packs.
- DO NOT FREEZE SAMPLES at −20°C; it reduces the sensitivity when used for virus isolation and molecular diagnostic tests.
- Send samples with dry ice if the journey is expected to take several days.
Sample submission
The relevant state or territory laboratory should coordinate sample packaging and consignment for delivery to the Australian Centre for Disease Preparedness.
Diagnostic tests
For SVA diagnosis:
- nucleic acid detection by real-time reverse transcription polymerase chain reaction (real-time RT-PCR)
- virus isolation
- immunohistochemistry (IHC) of affected tissues
- serological tests include enzyme-linked immunosorbent assays (ELISA) and virus neutralisation tests (VNT).
Reporting requirements
Infection with SVA is reportable in Australia. If you suspect SVA, immediately report the disease by phoning the Emergency Animal Disease Hotline on 1800 675 888, wherever you are in Australia. Alternatively, contact a government veterinarian in your state or territory.
Biocontainment and personal protective equipment
There are no public health implications for SVA, but you should implement biocontainment protocols until advised by government veterinary authorities. This includes isolating suspected cases and using and appropriately disposing of personal protective equipment such as gloves, coveralls and rubber boots (or disposable boots). Thoroughly disinfect and decontaminate clothing, vehicles and equipment before leaving the property.

Image credits: Dr Fabio Vannucci, University of Minnesota Veterinary Diagnostic Laboratory, USA

Image credits: Dr Fabio Vannucci, University of Minnesota Veterinary Diagnostic Laboratory, USA

Image credits: Dr Fabio Vannucci, University of Minnesota Veterinary Diagnostic Laboratory, USA

Image credits: Dr Fabio Vannucci, University of Minnesota Veterinary Diagnostic Laboratory, USA

Image credits: Dr Fabio Vannucci, University of Minnesota Veterinary Diagnostic Laboratory, USA

Image credits: Dr Fabio Vannucci, University of Minnesota Veterinary Diagnostic Laboratory, USA
Further information
Leme, RA, Alfieri, AF & Alfieri, AA (2017) ‘Update on Senecavirus infection in pigs ’, Viruses, 9:7, 170-185, doi: 10.3390/v9070170.
Maggiolo, MF, Fernandes, MHV, Joshi, LR, Sharma, B, Tweet, MM, Noll, JCG, Bauermann, FV & Diel, DG (2019), ‘Persistent infection and transmission of Senecavirus A from carrier sows to contact piglets’ , Journal of Virology, 91:21, doi: 10.1128/JVI.00819-19.
Zhang, X, Zixiang, Z, Fan, Y, Weijun, C, Hong, T, Zhang, K, Zheng, H & Xiangtao, L (2018) Review of Seneca Valley Virus: A call for increased surveillance and research’ , Frontiers in Microbiology, 9, doi: 10.3389/fmicb.2018.00940.
3.33 Sheep pox and goat pox
Fast facts
Sheep pox and goat pox are clinically indistinguishable, contagious, generalised exotic viral diseases of small ruminants.
Organism
Sheep pox virus (SPV) and goat pox virus (GPV):
- strains may vary considerably in host specificity and virulence
- are very stable viruses in the environment.
Susceptible species
SPV and GPV affect sheep and goats and strains are mostly host-specific, but some have equal virulence in both species.
Economic impact
There is potential for significant economic loss associated with high morbidity and mortality in small ruminants, as well as restrictions on animal movements and international trade.
Epidemiology
SPV and GPV:
- peak mortality usually occurs about 2 weeks after the development of lesions
- may cause morbidity approaching 100 per cent and mortality reaching 50 per cent in adults
- may cause morbidity and mortality approaching 100 per cent in young animals
- usually has an incubation period of 12 days but this may range from 2–14 days.
Transmission
Transmission occurs:
- mainly by direct contact via respiratory aerosols
- via skin abrasions
- via all secretions and excretions
- via insects (over short distances)
- via fomites.
Clinical signs
Signs include:
- sudden onset of pyrexia, nasal and ocular discharges, hypersalivation and lymphadenopathy
- laboured breathing (secondary pneumonia is common)
- classical pox lesions all over the skin
- lesions on the mucous membranes of the mouth, nostrils and vulva.
Post-mortem
You may see:
- lung lesions consisting of grey-white or red nodules
- swollen, congested lymph nodes with petechial haemorrhages
- skin lesions and haemorrhagic ulcerations in the linings of the trachea and gastrointestinal tract.
Samples
Collect:
- fresh tissue samples—skin lesion biopsies, scabs, vesicular fluid (if present) and from lesions in the respiratory and gastrointestinal tracts
- skin scrapings
- whole blood in EDTA.
Actions to take
If you suspect a case of sheep or goat pox:
- call the Emergency Animal Disease Hotline (1800 675 888) immediately or contact a government veterinarian in your state or territory
- isolate suspected cases and implement biocontainment protocols (including farm movement controls) until advised by government veterinary authorities.
Introduction
Sheep and goat pox are contagious, generalised viral diseases of small ruminants. Clinically indistinguishable, the two diseases are the most serious poxvirus diseases of livestock and may cause considerable production losses and mortalities.
Disease agent and susceptible species
Sheep and goat pox are caused by sheep pox virus (SPV) and goat pox virus (GPV).
SPV and GPV:
- are enveloped, double stranded DNA viruses in the family Poxviridae, subfamily Chordopoxvirinae, genus Capripoxvirus
- have strains which may vary considerably in host specificity and virulence
- share the same serotype and are morphologically and serologically indistinguishable from each other
- are closely related to lumpy skin disease virus (which affects cattle)
- can recombine and produce a spectrum of strains with intermediate host specificity and virulence across species
- usually demonstrate host specificity and cause clinical disease in either sheep or goats; however, some strains have equal virulence in both species
- infect sheep (merino and European breeds of sheep are more susceptible to SPV than other breeds)
- infect goats, although breeds vary in susceptibility to GPV and breeds exotic to the source area are more severely affected
- have no known wildlife reservoir
- do not infect humans.
Distribution
Globally, SPV and GPV:
- are endemic in Africa (north of the equator), the Middle East, Central Asia, including southern Russia and western China, and the Indian subcontinent
- spread into south-eastern Europe causing outbreaks in Turkey, Greece and Bulgaria in 2013–2015.
For the latest information on the distribution of sheep and goat pox, refer to the WAHIS information database website of the World Organisation for Animal Health (WOAH).
Occurrences in Australia
SPV and GPV have never been reported in Australia.
Epidemiology
Modes of transmission
Transmission occurs via:
- secretions and excretions—sheep and goats with acute disease shed virus in all secretions and excretions. Infection is mainly via respiratory aerosols but may also occur through cuts and abrasions in the skin or mucosal membranes
- fomites—the viruses are readily transported on fomites, including clothing and equipment. Due to the stability of the viruses in the environment, indirect contact by means of contaminated yards, vehicles and other fomites (such as hypodermic needles) is an important means of spread of the diseases
- vectors—less commonly, insects (such as biting flies) can act as mechanical vectors of the viruses over short distances
- contact with the carcasses of infected sheep and goats
- semen and embryos—while no information is available on the transmission of SPV or GPV in semen and embryos, you should assume that semen and embryos would contain the viruses during the viraemic period. The closely related lumpy skin disease virus of cattle is shed in the semen of clinically affected bulls for up to 22 days, and for at least 12 days in subclinically affected bulls.
Disease dynamics
Sheep and goat pox:
- viruses are present in all secretions and excretions (including milk and scabs from skin lesions) of infected animals at every stage of the disease, but scabs are not considered to be important sources of transmission
- viruses may cause disease ranging from inapparent or mild to severe, depending on age, breed, immunity, virus strain and other factors
- have a peracute form (usually seen in initial outbreaks in an area) characterised by pyrexia, death and (in some European goat breeds) flat haemorrhagic papules that coalesce to form widespread cutaneous ulceration
- viral incubation usually lasts 12 days but may vary from 4–14 days
- would likely cause severe disease in Australian sheep and goat populations (which are fully susceptible)
- lesions follow the classical pox cycle (over about 2 weeks) of macule (skin erythema), papule (0.5–1.5 cm diameter), vesicle (rare), pustule with exudation, encrustation and scab formation (exudate from ruptured pustules can cause the fleece to matt)
- skin lesions heal slowly, taking 5–6 weeks with secondary skin infections and fly strike being common complications
- may cause death at any stage of the disease, with peak mortality occurring about 2 weeks after lesions appear
- have no carrier state and recovered animals develop lifelong immunity.
In addition:
- in experimentally infected sheep and goats, a cell-associated viremia occurs from days 4–6 post-inoculation, and clears within 2–3 weeks
- shedding of virus in nasal, conjunctival and oral secretions occurs from as early as day 6–8 post-inoculation, peaks between days 10–14, and may persist at low levels for up to an additional 3–6 weeks
- infectious virus has also been detected between days 8–15 post-inoculation (at low levels) in the faeces of experimentally infected sheep and goats, and the urine of sheep
- movement of infected sheep and goats is the most important means of spreading the diseases to new areas
- feral goats could potentially become an important reservoir of the viruses in Australia.
Persistence of the agent
Capripoxviruses are very stable in the environment and can remain viable for long periods, on or off the animal host. SPV and GPV:
- can persist for up to 3 months in wool and hair from infected animals, for up to 6 months in a cool, dark environment (such as in shaded animal pens) and for many years in dried scabs at ambient temperatures
- are susceptible to lipid solvents and acids. Therefore, acids combined with detergents (such as Virkon®) are the disinfectants of choice, particularly for areas where organic matter is prevalent. Hypochlorites and aldehydes are useful for disinfecting clean surfaces. Citric acid, alcohols and iodophors are suitable for personal disinfection
- are inactivated after heating for 1 hour at 55 °C.
Diagnosis and pathology
Clinical signs
For both sheep and goat pox:
- disease may vary from inapparent or mild to severe, with severe disease typically seen in fully susceptible flocks
- mild disease (typically seen in partially immune animals or in resistant breeds in endemic regions) is often missed clinically because skin lesions are mild, few in number and often restricted to certain areas such as the ears and around the tail.
Peracute disease
Peracute cases may die before lesions become very obvious.
Acute disease
Clinical signs for both sheep and goat pox include:
- anorexia
- conjunctivitis
- lesions within the mouth, nostrils and vulva
- reluctance to move, standing with arched backs
- a sudden onset of pyrexia, which peaks at 40–42 °C, with ocular and nasal discharge and hypersalivation
- lymphadenopathy which may be particularly prominent in prescapular nodes
- typical pox lesions in the gastrointestinal tract, trachea and lungs
- acute respiratory distress and commonly secondary pneumonia
- mortality, which may reach 50 per cent in adults and approach 100 per cent in young animals
- flat haemorrhagic papules which in some European goat breeds which coalesce to form widespread cutaneous ulceration
- death, which may occur at any stage of the disease, with peak mortality occurring about 2 weeks after lesions appear
- formation of erythematous macules in the skin within 1–2 days of onset of pyrexia. Macules progress to papules within 1–2 days and are most readily detected by palpation, particularly in animals with hairy fleeces. They may extend all over the skin, but are most obvious where wool or hair is shortest, such as on the face, ears, axillae, groin, perineum and under the tail. Encrustation of papules and scab formation occurs within the following 1–2 weeks.
Nodular disease
A nodular form of sheep and goat pox—known as stonepox—is also described. Stonepox resembles lumpy skin disease (of cattle), with skin lesions of 0.5–3 cm in diameter hyperaemic, thickened and raised above the surrounding skin.
Pathology
In addition to the lesions described, internal lesions are usually present in the acute disease. Findings include:
- ulcerations or nodules in the mucous membranes of the oral cavity, trachea and the gastrointestinal tract, including the rumen, abomasum and reticulum
- pulmonary lesions in about 40 per cent of cases. These consist of grey-white or red nodules that are generally sub-pleural but may be readily palpated as hard nodules throughout the lungs
- nodules in the omentum, kidneys and liver
- enlarged and haemorrhagic lymph nodes.
Differential diagnosis
Acute cases in naïve populations should be readily diagnosed based on clinical signs. However, some strains of low virulence may produce only mild clinical signs. Consider in the differential diagnosis:
- exotic diseases
- bluetongue disease (infection present in Australia but without clinical disease) (affects goats and sheep)
- endemic diseases
- contagious pustular dermatitis (scabby mouth or orf) (affects sheep)
- ectoparasites (affects goats and sheep)
- mycotic dermatitis (affects goats and sheep)
- non-infectious causes
- insect bites (affects goats and sheep)
- photosensitisation (affects goats and sheep).
Samples required
Sample collection
You will be able to isolate the virus within the first week of clinical signs developing, before neutralising antibodies develop. Collect:
- serum from at least 10 live, clinically affected animals, and from exposed animals (particularly those that are convalescent)
- EDTA blood from live, clinically affected animals (7–10 ml/animal)
- fresh tissue—characteristic pox lesions from skin as well as respiratory and gastrointestinal tracts (2 g of each tissue)
- nasal swabs from live, clinically affected animals
- fixed tissue—characteristic pox lesions from skin as well as respiratory and gastrointestinal tracts (in neutral-buffered formalin).
Transport of samples
For transport:
- chill blood samples and unpreserved tissue samples at either 4 °C, or with frozen gel packs
- DO NOT FREEZE SAMPLES at -20 °C; it reduces the sensitivity when used for virus isolation and molecular diagnostic tests
- place swab samples in virus transport media containing antibiotics and antifungals (or saline if other media is unavailable)
- send samples with dry ice if the journey is expected to take several days
- formalin fixed tissue can be sent at room temperature.
Sample submission
The relevant state or territory laboratory should coordinate sample packaging and consignment for delivery to the Australian Centre for Disease Preparedness.
Diagnostic tests
For both sheep and goat pox:
- a rapid, tentative laboratory diagnosis can be made by electron microscopy of tissue samples. Electron microscopic examination of tissue samples reveals typical capripoxvirus particles, which are readily differentiated morphologically from those of contagious pustular dermatitis (orf) virus
- confirmation of the diagnosis is obtained by specifically identifying the virus in tissues from early lesions or in cell culture using virus-specific tests
- the most rapid, sensitive and specific diagnostic procedure is the detection of viral DNA in characteristic poxvirus lesions or nasal swabs by real-time or conventional PCR. A positive result can be obtained within 1 day of the laboratory receiving samples.
Reporting requirements
Sheep and goat pox are WOAH-listed disease and Australia has an international obligation to report cases.
If you suspect Sheep and goat pox, report it immediately. Call the Emergency Animal Disease Hotline on 1800 675 888, wherever you are in Australia. Alternatively, contact a government veterinarian in your state or territory.
Government duty veterinarians monitor the hotline and are available to advise you 24 hours a day, 7 days a week.
Biocontainment and personal protective equipment
There are no public health implications for sheep and goat pox, but you should implement biocontainment protocols until advised by government veterinary authorities. This includes isolating suspected cases and using and appropriately disposing of personal protective equipment such as gloves, coveralls and rubber boots (or disposable boots). Thoroughly disinfect and decontaminate clothing, vehicle and equipment before leaving the property.





Further information
Babiuk S, Bowden TR, Parkyn G, Dalman B, Hoa DM, Long NT, Vu PP, Bieu DX, Copps J and Boyle DB (2009). Yemen and Vietnam capripoxviruses demonstrate a distinct host preference for goats compared with sheep. Journal of General Virology 90(1):105-114.
Ben Chehida F, Ayari-Fakhfakh E, Caufour P, Amdouni J, Nasr J, Messaoudi L, Haj Ammar H, Sghaier S, Bernard C, Ghram A, Cêtre-Sossah C. (2018) Sheep pox in Tunisia: Current status and perspectives. Transboundary Emerging Diseases, 65(1):50-63.
Bowden TR, Babiuk SL, Parkyn GR, Copps JS and Boyle DB (2008). Capripoxvirus tissue tropism and shedding: A quantitative study in experimentally infected sheep and goats. Virology 371(2):380-393.
3.34 Surra
Fast facts
Surra is a blood-borne parasitic disease caused by Trypanosoma evansi that is often chronic and leads to wasting of infected animals. It has a wide host range and is mechanically transmitted by biting flies.
Organism
Trypanosoma evansi:
- is a protozoan parasite that causes the disease known as surra
- does not require a developmental stage within an insect vector for its lifecycle, unlike many other Trypanosoma species
- is morphologically indistinguishable from T. brucei, which causes African sleeping sickness in humans
- is a blood-borne infection.
Susceptible species
T. evansi can infect a wide range of host species, including:
- equids (horses, donkeys and mules)
- wild and domestic ungulates (cattle, buffalo, deer, camels, llamas, sheep, goats and pigs)
- dogs and cats
- elephants.
Under experimental conditions, it is thought that almost all mammalian species can be infected with T. evansi.
Epidemiology
- Target species vary from region to region. For example, camels are most affected in the Middle East and northern Africa, equids and deer in China, horses, cattle and buffalo in South-East Asia and horses in South America.
- Surra is primarily transmitted mechanically by biting flies after feeding on blood from infected animals.
- The disease is primarily spread by movement of infected animals into new areas.
- Morbidity and mortality rates vary depending on the species and region. For example, in camels in northeastern Africa, infection ranges from 20–70% with mortalities for untreated horses and camels reaching 100%. Cattle and buffalo may develop a chronic infection, which results in lower mortalities.
Transmission
Surra is primarily transmitted mechanically via vectors, particularly by biting flies from the genera Tabanus, Stomoxys, Haematopoda, Chrypsos and Lyperosia, with no intermediate host requirements.
Clinical signs
Affected animals may suffer from acute, subacute or chronic disease. Clinical signs may vary depending on the species and form of disease. They may include:
- fever
- emaciation
- stiffness of the limbs
- nasal and ocular bleeding
- anaemia
- abortion
- death within weeks or months when left without treatment.
Post-mortem
Gross lesions are generally non-specific. Findings may include:
- emaciated carcass
- subcutaneous oedema
- anaemia
- enlargement of the spleen, liver (icterus may be present) and lymph nodes
- petechiae on internal organs.
Samples
Collect these samples from clinically affected animals:
- serum and whole blood
- fresh tissue from lymph nodes (especially the prescapular or precrural/subiliac lymph nodes) and oedematous tissue
- smears from blood, lymph nodes or oedema fluid
- formalin-fixed tissues—a full range of tissues, including the brain and heart.
Actions to take
If you suspect a case of surra:
- call the Emergency Animal Disease Hotline (1800 675 888) immediately or contact a government veterinarian in your state or territory
- isolate suspected cases and implement biocontainment protocols, including farm movement controls and protection of animals from potential vectors until advised by government veterinary authorities.
Introduction
Surra is a blood-borne parasitic disease that has a wide host range. It may present in an acute, subacute or chronic form which varies depending on host species and geographical location. The chronic form leads to wasting and the disease is invariably fatal.
Disease agent and susceptible species
- Surra:
- is caused by Trypanosoma evansi, a protozoal parasite in the genus Trypanosoma, family Trypansosmatidae
- has several variants including T. equinum, which is considered a dyskinetoplastic variant of T. evansi found in South America and is not classified as a separate species.
- While biting flies are considered mechanical vectors in South America, vampire bats (Desmodus rotundus) are suspected to be the reservoir host and vector.
- Susceptibility to infection is highly variable between species, and within species depending on the geographical area.
- Camels, including Bactrian and dromedaries, are suspected to be the original principal host.
- other susceptible species that are severely infected include horses, buffalo, cattle, donkeys, mules, deer, llamas, dogs and cats
- Species that tend to develop milder or chronic forms of the disease include sheep, goats, pigs and elephants.
- Nearly all mammals are experimentally susceptible to infection with T. evansi.
Public health considerations
Surra is not currently considered a zoonotic disease risk due to humans producing apolipoproteins that provide innate protection against most trypanosomes. However:
- cases in humans have been detected in India, Sri Lanka, Vietnam and Egypt
- it is unclear whether the disease is truly zoonotic as seroconversion in humans has primarily been detected in the absence of clinical disease.
Distribution
Surra:
- is present in northern Africa, the Middle East, Asia, Central and South America
- is found in some of Australia’s neighbouring countries such as Indonesia including Irian Jaya, the province bordering Papua New Guinea, and Timor-Leste. Serological evidence has been found in Papua New Guinea in animals imported from Indonesia, but results suggest it is not endemic.
- outbreaks occasionally occur in France and Spain—particularly the Canary Islands but appear to be contained to a small region due to control programs.
For the latest information on the distribution of surra, please refer to the WAHIS information database website of the World Organisation for Animal Health (WOAH) or the FAO EMPRESi Global Animal Disease Information System.
Occurrences in Australia
Surra was detected in Australia in 1907 in a consignment of imported camels at Port Hedland, Western Australia. These camels were destroyed and no further evidence of the disease has ever been detected in Australia. Surra is a target disease regularly included in Northern Australia Quarantine Strategy (NAQS) surveillance activities due to northern Australia’s proximity to infected neighbours.
Epidemiology
T. evansi has a direct lifecycle and does not require an intermediate host. The epidemiology can be complex due to the disease presenting differently based on the individual host, species and geographical location. Surra is typically introduced to new areas by the movement of infected animals and subsequently spreads to other animals via the modes of transmission listed below.
Modes of transmission
Transmission occurs via:
- mechanical transmission by biting flies including those in the genus Tabanus, Stomoxys, Atylotus and Lyperosia. This also includes sucking flies (e.g. Musca domestica) if they feed from a contaminated wound
- fomites through contaminated needles or surgical equipment
- ingestion of infected tissue or consumption of milk
- sexual transmission via mucous membranes
- transplacental infection in equids—has been documented.
Disease dynamics
- The pathogenesis of surra is complex and is still not completely understood.
- T. evansi is not capable of cyclical development in tsetse Glossina spp., the tsetse flies responsible for transmitting African sleeping sickness.
- T. evansi has a wide host range, and clinical disease may appear differently depending on host species and geographic location. Animals that are nutritionally or immunologically stressed are more susceptible.
- Vampire bats can become infected after feeding on infected prey; some will die within 1 month of infection, and those that survive can become a reservoir host. The parasite multiplies within the bat and can be found in its saliva, enabling it to infect other bats or prey. Therefore, Desmodus rotundus can act as a reservoir, host and biological vector in South America.
- Parasitaemia is intermittent in chronically infected animals and the organism may be difficult to find in mild or subclinical cases. In acutely infected animals, parasitaemia is associated with periods of fever.
- The disease may exhibit seasonal occurrences, with cases increasing during the rainy season when biting fly populations expand.
Persistence of the agent
- Trypanosomes do not survive for long periods outside a host and have minimal viability after 14 hours following host death.
- T. evansi can be found on the mouth parts and in the crop of biting flies following consumption of blood from infected animals. It can survive for up to 30 minutes on mouth parts and up to 72 hours within the crop from Tabanus and Stomoxys flies. More research is still needed in this area.
- T. evansi can evade and suppress the host immune system, which can lead to increased susceptibility to other infectious diseases and vaccine failure.
- Disinfection alone does not prevent the spread of the disease due to its blood-borne nature. Controlling fly populations and restricting access to host species are control strategies to limit new infections.
Diagnosis and pathology
Clinical signs
Surra may present as a subacute, acute or chronic disease depending on host factors such as species, immunological status and geographical location of the host. The clinical course and severity of signs can differ between individual animals and species. Death can occur rapidly in horses and camels.
- Anaemia, predominantly haemolytic anaemia, is a common clinical sign across the susceptible species.
- Chronic illness can occur in less susceptible animals such as cattle, with clinical signs persisting for months to years.
In camels:
- disease may affect multiple body systems
- presentation of the disease is typically acute. Common clinical signs include high fever (41.5–44°C), anaemia, weakness and death.
- the disease may be fatal within a few months after infection but may also present chronically, with the disease lasting 2 to 3 years. All ages can be infected, but cases tend to appear post-weaning around the age of 1 to 2 years.
- in chronic cases, common clinical signs include intermittent fever (41°C) over the course of 1 week, dull mentation, progressive weakness, inappetence and wasting, abortion, ventral oedema, anaemia, petechial or ecchymotic haemorrhages of the mucous membranes and periodic convulsions.
In horses:
- the incubation period is between 1 and 4 weeks, but this can extend up to 8 weeks
- the clinical course is generally acute, with death occurring within 2 to 8 weeks following infection. Donkeys, asses and mules are less susceptible so may display a more chronic course of the disease.
- common clinical signs for horses and other susceptible equids include fever (may be intermittent 41.5–44°C), weakness and lethargy, anaemia, severe weight loss, transient local or general cutaneous eruptions, altered locomotion with neurological signs, dependent oedema and abortion
- due to the vascular nature of the disease, petechial haemorrhaging of the eyelids, nictitating membrane and vulvar and vaginal mucosa will also be seen along with ocular anterior chamber haemorrhage.
In cattle and buffalo:
- mild, chronic or asymptomatic disease may present—but this may depend on the geographical location. For example, cattle and water buffalo appear more severely affected in South-East Asia, but appear mildly impacted in Africa, the Middle East and South America.
- common clinical signs include fever, anaemia, weight loss leading to chronic wasting, milk and meat production losses
Buffalo in South-East Asia show more severe clinical signs than in other endemic areas. Surra has been identified as a significant issue in the Philippines. In addition to common clinical signs of cattle and buffalo, the following have been reported: generalised stiffness, conjunctivitis, emaciation, oedema of the limbs, inappetence, dyspnoea, anaemia, recumbency, diarrhoea, abortion, neurological signs and death.
In sheep and goats:
- infections are generally asymptomatic or mild
- experimental infections have resulted in clinical signs including fever, inappetence and anaemia.
In pigs:
- infections may be chronic, very mild or subclinical
- clinical signs include fever, anorexia, emaciation, abortion, cutaneous rash and hind limb paralysis.
In carnivores such as dogs and cats:
- infection is typically caused by consumption of fresh infected meat
- dogs exhibit severe clinical signs resulting in death within 1 week to 1 month
- clinical signs in dogs may include intermittent fever (39–41°C), oedema of the head including the larynx and dependent oedema, weakness, inappetence leading to emaciation and paresis of the hind limbs, myocarditis and ocular signs including conjunctivitis, lachrymation, keratitis, corneal opacity and haemorrhagic signs
- experimental infection in cats has induced mild disease including fever, hyporexia, vomiting and muscular pain with haematology often showing hyperproteinaemia, hyperglobulinaemia and hypoalbuminaemia.
Pathology
Post-mortem findings may vary due to the duration of clinical disease. They may include:
- non-specific changes
- emaciated carcass due to inappetence
- subcutaneous oedema
- anaemia
- enlargement of the spleen, liver (icterus may be present) and lymph nodes
- petechiae on internal organs
- nephritis
- ascites or hydrothorax may be present
- cardiac lesions including hydropericardium, pericarditis, cardiomyopathy and myocarditis
- respiratory lesions including congestion, consolidation, oedema, emphysema, haemorrhages and pneumonia
- neurological lesions, likely more common in chronic cases, include swollen cerebral hemispheres, flattened gyri, severe oedema and malacia, and subpial haemorrhages.
Differential diagnosis
Differential diagnoses will depend on the species infected.
- Exotic diseases
- African horse sickness (horses)
- equine viral arteritis (horses)
- equine infectious anaemia (horses)
- dourine (horses)
- tsetse-transmitted trypanosomosis (camels)
- theileriosis (East Coast fever) (cattle)
- haemorrhagic septicaemia (cattle)
- rabies (dogs)
- Endemic diseases
- anthrax (camels, cattle)
- babesiosis (cattle)
- anaplasmosis (cattle)
- Non-infectious
- malnutrition (cattle)
- chronic parasitism (horses, camels, cattle).
Samples required
Sample collection
Collect these samples from clinically affected animals:
- serum
- whole blood (EDTA)
- fresh tissues of prescapular or precrural/ subiliac lymph nodes (especially if enlarged), and oedematous tissue
- impression, thin and thick smears from peripheral blood, lymph node aspirates or oedema fluid
- formalin-fixed tissues from brain (transversely sectioned), cardiac muscle, heart valve, lung, spleen and bone marrow.
Note: the organism may be difficult to detect in mild or subclinical cases, and parasitaemia may be intermittent in chronic infections. Blood samples should ideally be collected from peripheral veins (eg. ear or tail vein) during a febrile period. Multiple samples collected over time may be required.
Transport of samples
For transport:
- chill blood samples and unpreserved tissue samples at 4°C, or with frozen gel packs. DO NOT FREEZE SAMPLES at −20°C; it reduces the sensitivity when used for molecular diagnostic tests
- send fresh samples with dry ice if the journey is expected to take several days
- formalin-fixed tissue can be sent at room temperature. Formalin samples must be packaged in a sealed bag or container separate to other samples.
Sample submission
The relevant state or territory laboratory should coordinate sample packaging and consignment for delivery to the Australian Centre for Disease Preparedness.
Diagnostic tests
For surra diagnosis:
- serological tests available include ELISA and card agglutination tests (CATT)
- nucleic acid detection includes real-time reverse transcription polymerase chain reaction (real-time RT-PCR)
- microscopic examination of smears may detect the presence of parasites.
Note: Parasite concentration techniques to improve sensitivity of organism detection are also available, such as microhaematocrit centrifugation technique (HCT/Woo method), buffy coat techniques (BCT/Murray method) and mini-anion exchange chromatography technique (mAECT).
Reporting requirements
Surra is a notifiable disease Australia. Surra is a WOAH-listed disease and Australia has an international obligation to report confirmed cases. If you suspect surra, report the disease immediately by phoning the Emergency Animal Disease Hotline on 1800 675 888, wherever you are in Australia. Alternatively, contact a government veterinarian in your state or territory.
Biocontainment and personal protective equipment
There are no known public health implications for surra, but you should implement biocontainment protocols until advised by government authorities. This includes isolating suspected cases and advising livestock managers to enact a vector management plan to protect any susceptible animals remaining on the property. As there is a possibility that T. evansi can be transmitted via mucous membranes, personal protective equipment such as gloves should be worn during physical examination and changed between animals and disposed of appropriately. Any equipment used should be thoroughly decontaminated and disinfected before leaving the property.
Clothing and vehicles should be decontaminated as per usual biosecurity protocols before leaving the property.

Image credits: M. Desquesnes / https://doi.org/10.1155/2013/194176 / CC BY 3.0

Image credits: M. Desquesnes / https://doi.org/10.1155/2013/194176 / CC BY 3.0

Image credits: M. Desquesnes / https://doi.org/10.1155/2013/194176 / CC BY 3.0

Image credits: M. Desquesnes / https://doi.org/10.1155/2013/194176 / CC BY 3.0
Further information
Aregawi, W.G., Agga, G.E., Abdi, R.D., Büscher, P., 2019. Systematic review and meta-analysis on the global distribution, host range, and prevalence of Trypanosoma evansi. Parasites & Vectors 12, 67. https://doi.org/10.1186/s13071-019-3311-4
Desquesnes, M., Dargantes, A., Lai, D.-H., Lun, Z.-R., Holzmuller, P., Jittapalapong, S., 2013a. Trypanosoma evansi and Surra: A Review and Perspectives on Transmission, Epidemiology and Control, Impact, and Zoonotic Aspects. BioMed Research International 2013, e321237. https://doi.org/10.1155/2013/321237
Habila, N., Inuwa, M.H., Aimola, I.A., Udeh, M.U., Haruna, E., 2012. Pathogenic mechanisms of Trypanosoma evansi infections. Res Vet Sci 93, 13–17. https://doi.org/10.1016/j.rvsc.2011.08.011
3.35 Swine vesicular disease
Fast facts
Swine vesicular disease (SVD) is a highly contagious, exotic viral disease of pigs clinically indistinguishable from foot-and-mouth disease (FMD).
Organism
SVD virus (SVDV):
- primarily replicates in the endothelial cells of the gastrointestinal tract
- can survive in the environment for long periods and is highly resistant to heat and a wide pH range. The most effective disinfectants are strong alkalis.
Susceptible species
Only pigs are susceptible.
Economic impact
There is potential for significant economic loss resulting from difficulty of eradication, as well as restrictions on animal movements and international trade.
Epidemiology
SVD:
- causes high morbidity which can reach 100 per cent but very low (zero) mortality
- has an incubation period of 2–7 days; longer if dose is small
- infection can be subclinical.
Transmission
Swill feeding has been responsible for most primary outbreaks. In addition:
- virus is shed in nasal secretions and excretions of infected pigs
- pigs can excrete the virus in faeces up to 48 hours before clinical signs are seen, and for up to 3 months following infection.
Clinical signs
SVD can be a subclinical, mild or severe vesicular condition depending on the virus strain, route and dose of infection. Housing on damp concrete may exacerbate clinical signs, with younger animals more severely affected. The main clinical signs are:
- vesicles and ulcers on the snout, mammary glands, coronary band, interdigital areas and on the skin of the lower legs, particularly at pressure points such as the knees
- pyrexia
- lameness
- salivation.
Post-mortem
Post-mortem lesions of SVD are restricted to vesicle formation and resolution.
Samples required
Also refer to the detailed section on sampling for animals with vesicular disease.
- blood (EDTA and plain tubes)
- vesicular fluid, oropharyngeal fluid, oral, nasal and tonsillar swabs, epithelium, and epithelial tags (in buffer or virus transport medium).
Actions to take
If you suspect a case of SVD:
- call the Emergency Animal Disease Hotline (1800 675 888) immediately or contact a government veterinarian in your state or territory
- isolate suspected cases and implement biocontainment protocols (including farm movement controls) until advised by government veterinary authorities.
Introduction
Swine vesicular disease (SVD) is an acute, highly contagious but rarely fatal, exotic vesicular viral disease of pigs. SVD is of international concern because it is clinically indistinguishable from foot-and-mouth disease (FMD). Rapid differentiation from FMD is essential.
Disease agent and susceptible species
Pigs are the only species susceptible to SVD virus (SVDV). SVDV:
- is a member of the Enterovirus genus of the family Picornaviridae
- has two serotypes (SVDV-1 and SVDV-2) within the species Enterovirus B
- is a non-enveloped virus with a single-stranded RNA genome (non-enveloped viruses are
- in general more stable than enveloped viruses)
- strains vary in virulence, with subclinical infection the most frequent condition observed during recent years.
Distribution
Since the 1970s, the disease appears to have been eradicated from most countries. However, as the disease is no longer WOAH-listed, countries are not obligated to report cases, which makes it difficult to determine distribution. SVD is endemic in southern Italy and possibly in parts of Asia.
Occurrences in Australia
None reported.
Epidemiology
Modes of transmission
Transmission occurs via:
- direct contact with infected pigs, as the virus is shed in secretions and excretions (including faeces) of infected pigs. Movement of infected pigs is the most important means of spread
- contact with faeces, an important means of spread as the virus can be shed in the faeces for up to 3 months following infection
- ingestion of pig meat or pig meat products infected with the virus. Swill feeding is an important means of spread. In Australia, strict import conditions are in place to address the risk of a SVD incursion and swill feeding is illegal
- fomites, because of the stability of SVDV in the environment, contaminated pig pens, water, vehicles and other fomites (such as hypodermic needles) can spread disease
- contact with the carcasses of pigs affected by SVD
- mechanical spread by people, rodents, insects and birds (but this plays a minor role in transmission).
Disease dynamics
SVDV is considered to be highly contagious, but mortality is low. Dynamics are as follows:
- virus enters host pigs through damaged epithelia and multiplies in epithelial cells
- pigs can secrete the virus from the nose or mouth, and excrete the virus in faeces up to 48 hours before clinical signs are seen
- the incubation period in natural outbreaks is 2–7 days. The incubation period for SVD varies by route of transmission, with 2–5 days incubation more common if the virus is ingested in contaminated meat, and 2–7 days more common if acquired through contact with infected animals or faecal material)
- subclinical infection may occur if pigs are exposed to small amounts of virus, particularly by inhalation or ingestion
- no persistent infections have been reported, and infected pigs develop protective antibody against SVDV upon recovery
- there is no evidence of a carrier state and no reservoir hosts are known
- on some properties, the disease apparently runs its course and, once all animals are infected, dies out. On other properties, two waves of disease approximately 3 months apart have been observed.
Persistence of the agent
SVDV is highly stable in the environment, which complicates eradication and makes prompt recognition essential for control. SVDV:
- can persist for many months in a range of pork products and frozen carcasses but has not been detected in cooked, canned ham
- is resistant to heat up to 69 °C, pH ranging from 2–12 and many common detergents and disinfectants
- is protected by manure, fats and other organic matter, which must be completely removed during cleaning
- can survive in pig faeces for at least 138 days
- is most effectively inactivated with strong alkalis (for example, sodium hydroxide), although hypochlorites or acid-containing iodophors can be used when organic material is not present.
Diagnosis and pathology
Suspect SVD and other vesicular diseases when vesicles or erosions are found on the mouth and/or feet of pigs. Other vesicular diseases must be ruled out with laboratory tests.
Clinical signs
SVD can be a subclinical, mild or severe vesicular condition depending on the strain of virus involved, the route and dose of infection, and the husbandry conditions under which the pigs are kept. Clinical signs can be more severe in animals housed on damp concrete, with younger animals more severely affected. Clinical signs are often mild and overlooked (particularly in muddy yards or where the animals are infrequently observed), and affected pigs recover rapidly (usually occur within 2–3 weeks) with little permanent damage. A dark, horizontal line on the hoof may appear where growth has been temporarily interrupted. Clinical signs are:
- very similar to FMD (including pyrexia, salivation and lameness) but with lower morbidity and less severe lesions
- a transient pyrexia (following incubation) of up to 41 °C, after which vesicles develop on the coronary band, typically at the junction with the heel (these may affect the whole coronary band resulting in loss of the hoof)
- vesicles and ulcers on the snout, mammary glands, coronary band, interdigital areas and on the skin of the lower legs, particularly at pressure points such as the knees, but vesicles in the oral cavity are rarely seen
- anorexia
- shivering, unsteady gait, and chorea (rhythmic jerking) of the legs.
Pathology
Post-mortem lesions of SVD are restricted to vesicle formation and resolution.
Differential diagnosis
SVD is clinically undistinguishable from the other exotic viral vesicular diseases, namely:
- foot-and-mouth disease
- Senecavirus A (Seneca Valley virus) infection.
- vesicular exanthema of swine (not seen globally since 1956)
- vesicular stomatitis.
A number of other diseases cause similar clinical signs to the viral vesicular diseases, particularly during their more advanced clinical stages. Although mouth and muzzle lesions in these diseases are not vesicular, they could be confused with FMD lesions.
Non-infectious causes of lesions include:
- chemical or thermal burns
- phototoxic dermatitis with vesicle formations from contact with the leaves of plants of the family Umbelliferae (parsley, parsnips and celery)
- chemical irritants and scalding.
Differential diagnoses of lameness include bad/hard floors and Glässers disease (Haemophilus parasuis).
Samples required
Take samples from at least five affected pigs in the group and from lesions in the mouth or the feet, or at other sites with suitable lesions. Because SVD may circulate unnoticed, you will need to look for seroconversion to SVDV in apparently healthy animals to ascertain how long infection has been present.
Sample collection
FMD virus (an important differential diagnosis for SVD) is extremely sensitive to both acid and alkaline conditions. Inappropriate buffer conditions can inactivate the virus making virus isolation difficult or impossible. To maximise chances of virus isolation:
- use phosphate buffered saline or virus transport media with a pH of 7.6
- if a sample is to be submitted after 24 hours or more, add glycerol to the phosphate buffered saline
- dilute oropharyngeal fluid collected with a probang in an equal volume of phosphate buffered saline pH 7.6, and mix vigorously for 1 minute.
Note that samples collection in these buffers is optimal (for the growth of FMD virus), but not essential for RNA or antigen detection assays.
Take samples from at least 10 live, clinically affected animals. Collect:
- serum, 7–10 ml/animal in plain tubes
- vesicular fluid—carefully use a syringe and needle to aspirate the vesicular fluid from unruptured vesicles, and place in a sterile container. Alternatively, collect fluid from small vesicles onto a swab and place the swab in 500 μl of buffer, such as phosphate buffered saline or virus transport medium
- fresh tissue, epithelium, epithelial tags, oral, nasal and tonsillar swabs and oropharyngeal fluid and submit in phosphate buffered saline or virus transport medium, if available.
Transport of samples
For transport:
- chill blood samples and unpreserved tissue samples at either 4 °C, or with frozen gel packs
- DO NOT FREEZE SAMPLES at -20 °C; it reduces the sensitivity when used for virus isolation and molecular diagnostic tests
- send samples with dry ice if the journey is expected to take several days
- formalin fixed tissue can be sent at room temperature.
Sample submission
The relevant state or territory laboratory should coordinate sample packaging and consignment for delivery to the Australian Centre for Disease Preparedness.
Diagnostic tests
SVDV is identified using an antigen enzyme-linked immunosorbent assay (ELISA), the direct complement fixation test, virus isolation in pig-derived cell cultures and PCR. Virus neutralisation is the definitive serological test. Serological ELISAs are used for surveillance.
Reporting requirements
SVD is an WOAH-listed disease and Australia has an international obligation to report cases.
If you suspect SVD, report it immediately. Call the Emergency Animal Disease Hotline on 1800 675 888, wherever you are in Australia. Alternatively, contact a government veterinarian in your state or territory.
Government duty veterinarians monitor the hotline and are available to advise you 24 hours a day, 7 days a week.
Biocontainment and personal protective equipment
There are no public health implications for SVD, but you should implement biocontainment protocols until advised by government veterinary authorities. This includes isolating suspected cases and using and appropriately disposing of personal protective equipment such as gloves, coveralls and rubber boots (or disposable boots). Thoroughly disinfect and decontaminate clothing, vehicle and equipment before leaving the property.


Further information
Amass, S.F., Schneider, J.L., Miller, C.A., Shawky, S.A., Stevenson, G.W., Woodruff, M.E. (2004) Idiopathic vesicular disease in a swine herd in Indiana. Journal of Swine Health and Production. 12(4):192–196.
Dekker A. (2000) Swine vesicular disease, studies on pathogenesis, diagnosis, and epizootiology: A review. Veterinary Quarterly, 22:4, 189-192.
Escribano-Romero E, Jiménez-Clavero MA, Ley V. (2000) Swine vesicular disease virus. Pathology of the disease and molecular characteristics of the virion. Anim Health Res Rev. 1(2):119-26.
3.36 Transmissible gastroenteritis
Fast facts
Transmissible gastroenteritis (TGE) is a highly contagious exotic disease of pigs characterised by diarrhoea and transient vomiting with associated high mortality in piglets under 5 weeks of age.
Organism
TGE virus (TGEV):
- replicates primarily in the small intestine causing cell lysis and damage to villus epithelium
- is rapidly inactivated at temperatures above 37 °C and considered highly sensitive to sunlight
- is inactivated by the use of formalin (0.03%), sodium hypochlorite, NaOH, iodine, ether and quaternary ammonium compounds.
Susceptible species
TGE primarily affects pigs but cats, dogs and foxes are all are considered carriers.
Economic impact
There is potential for significant economic loss associated with high mortality in young pigs in a naïve herd, as well as restrictions on animal movements and international trade.
Epidemiology
TGE:
- has a higher transmission in herds during winter months
- may cause mortality of 100 per cent in piglets less than 2–3 weeks of age
- incubation lasts 18 hours to 3 days.
Transmission
Transmission occurs:
- typically via faecal-oral route
- via nasal secretions and milk during acute infections
- via fomites (during colder months).
Clinical signs
Signs include:
- watery diarrhoea
- vomiting
- rapid weight loss/wasting
- anorexia
- dehydration.
Post-mortem
The following may be found:
- small intestine distention with foamy, yellow fluid and undigested/curdled milk
- +/- gastric petechial haemorrhage.
Samples
Refer to the detailed section on sampling for pigs with diarrhoea.
- whole blood in EDTA and plain tubes
- faeces in sterile tubes
- full range of tissue including lungs, intestine, spleen, liver and kidneys fresh and in 10% neutral-buffered formalin.
Actions to take
If you suspect a case of TGE:
- call the Emergency Animal Disease Hotline (1800 675 888) immediately or contact a government veterinarian in your state or territory
- isolate suspected cases and implement biocontainment protocols (including farm movement controls) until advised by government veterinary authorities.
Introduction
Transmissible gastroenteritis (TGE) is an acute, highly contagious exotic disease of pigs with a high mortality case rate in piglets aged under 5 weeks.
Disease agent and susceptible species
TGE:
- is caused by the TGE virus (TGEV), an enteropathogenic coronavirus belonging to the Alphacoronavirus genus within the family Coronaviridae
- is related to other porcine coronaviruses, including porcine epidemic diarrhoea virus (PEDV), porcine deltacoronavirus (PDCoV), porcine respiratory coronavirus (PRCV) and porcine hemagglutinating encephalomyelitis virus (HEV)
- virus has only one serotype; however, the virus is closely related to PRCV which will cross-react serologically
- causes clinical disease in pigs (Sus scrofa)
- can be carried by cats, dogs, foxes and possibly mink (which do not display clinical signs).
Distribution
TGEV is present in most parts of Europe, the Americas (North, South and Central), South-East Asia, China, Japan and South Korea and West Africa. For the latest information on the distribution of TGE, refer to the WAHIS information database website of the World Organisation for Animal Health (WOAH).
Occurrences in Australia
TGE has not been reported in Australia.
Epidemiology
Modes of transmission
While the exact mechanism is unclear, faeco-oral contamination is considered the most likely mode of transmission. Transmission via fomites is possible but the virus is rapidly deactivated in warm environmental conditions (in sunlight and at room temperature or above). Otherwise, transmission occurs via:
- direct contact with the faeces or nasal secretions of infected pigs
- ingestion of litter, feed or water contaminated by the faeces or nasal secretions of infected pigs
- virus shed in the milk of sows during the acute stage of the disease (piglets may become infected from milk in this way)
- contact with reservoirs/carriers, which includes wild carnivores such as dogs, cats and foxes
- swill feeding of contaminated swill
- mechanical vectors in the form of wild birds and flies.
Disease dynamics
TGEV infection is associated with high case morbidity and high case mortality (up to 100 per cent) in piglets less than 2–3 weeks of age, and:
- the incubation period is extremely short, estimated at between 18 hours and 3 days
- infection usually spreads very rapidly through a susceptible population (but spread may be slower in warmer environments)
- faecal shedding may persist for up to 2 weeks after recovery from infection
- pigs that recover from enteric infections develop immunity, but the longer-term carrier status of recovered animals is difficult to assess.
Persistence of the agent
Freezing and post-slaughter tissue acidification to not reduce the infectivity of TGE virus in pig products. TEGV:
- can persist in the environment for up to 72 hours (but is rapidly inactivated at temperatures above 37 °C)
- can survive for up to 2 weeks in manure slurry at 20°C
- is susceptible to sunlight and most chemical disinfectants
- can be inactivated with 1% phenol, 0.01% betapropiolactone, sodium hypochlorite, 1 mM binary ethylenamine, sodium hydroxide, iodines, quaternary ammonium compounds, ether and chloroform.
Diagnosis and pathology
Clinical signs
The incubation period varies from between 18 hours and 3 days. Typical clinical signs in young pigs include:
- watery foul smelling yellow diarrhoea
- transient vomiting
- rapid weight loss
- anorexia
- depression
- rapid dehydration
- death within 2–7 days
- high mortality of pigs under 2–3 weeks of age (can be as high as 100 per cent).
The disease in grower and breeding herds can be clinically indistinguishable from porcine epidemic diarrhoea (PED), with typically watery diarrhoea, inappetence, ill-thrift and agalactia in lactating sows.
Laboratory testing is required to exclude other causes of diarrhoea in pigs.
Pathology
Typically, gross pathological lesions indicative of enteritis are found (usually confined to the gastrointestinal tract). Other gross lesions found may include:
- stomach distention with undigested/curdled milk
- +/- gastric petechial haemorrhage
- stomach congestion with regional haemorrhage on diaphragmatic surface (in 50 per cent of cases)
- small intestine distention with foam yellow fluid and milk
- thinning of intestinal wall (which may appear almost transparent due to villus atrophy).
Differential diagnosis
Differential diagnoses for TGE are those which involve atrophic enteritis, which includes:
- exotic diseases
- porcine epidemic diarrhoea (PED)
- porcine deltacoronavirus
- Senecavirus A (Seneca Valley virus) infection (this would be a differential for neonates <2–3 weeks)
- endemic diseases
- colibacillosis
- enterotoxaemia (Clostridium perfringens type C)
- haemagglutinating encephalomyelitis virus (HEV)
- porcine circovirus type 2–associated diarrhoea
- porcine rotavirus infection
- proliferative enteritis
- salmonellosis
- swine dysentery
- non-infectious causes
- arsenic poisoning.
Samples required
Viral antigen is best detected in piglets sacrificed at a very early stage of disease. Collect enough samples (from at least five animals) to investigate suspected endemic causes of gastroenteritis, as you can frequently observe clinical signs of TGEV in other enteric infections.
Sample collection
Collect:
- serum from acute and convalescent animals (at least 10 animals)
- fresh tissue in the form of loops of affected ileum from acutely ill cases and preferably collected within 24 hours of the onset of clinical signs (tie off ileum and store in sterile containers on ice, and if transit is likely to take more than 24 hours, add glycerol buffer— pH 7.4—to the samples)
- fixed tissue in the form of sections of small intestine (both unpreserved and in neutral buffered formalin) from different parts of the small intestine.
Transport of samples
For transport:
- chill blood samples and unpreserved tissue samples at either 4 °C, or with frozen gel packs
- DO NOT FREEZE SAMPLES at -20 °C; it reduces the sensitivity when used for virus isolation and molecular diagnostic tests
- send samples with dry ice if the journey is expected to take several days
- formalin fixed tissue can be sent at room temperature.
Sample submission
The relevant state or territory laboratory should coordinate sample packaging and consignment for delivery to the Australian Centre for Disease Preparedness.
Diagnostic tests
Laboratory testing is required for the diagnosis of TGE and is accomplished by virus neutralisation and isolation, electron microscopy and immuno-electron microscopy, and immunofluorescence. A PCR test is also available and can be used to differentiate TGE virus from other porcine coronaviruses.
Reporting requirements
TGE is an WOAH-listed disease and Australia has an international obligation to report cases.
If you suspect TGE, report it immediately. Call the Emergency Animal Disease Hotline on 1800 675 888, wherever you are in Australia. Alternatively, contact a government veterinarian in your state or territory.
Government duty veterinarians monitor the hotline and are available to advise you 24 hours a day, 7 days a week.
Biocontainment and personal protective equipment
There are no public health implications for TGE, but you should implement biocontainment protocols until advised by government veterinary authorities. This includes isolating suspected cases and using and appropriately disposing of personal protective equipment such as gloves, coveralls and rubber boots (or disposable boots). Thoroughly disinfect and decontaminate clothing, vehicle and equipment before leaving the property.
Further information
Mullan BP, Davies GT, Cutler RS. (1994) Simulation of the economic impact of transmissible gastroenteritis on commercial pig production in Australia. Australian Veterinary Journal. 71(5):151-4.
Underdahl NR, Mebus CA and Torres-Medina A (1975). Recovery of transmissible gastroenteritis virus from chronically infected experimental pigs. American Journal of Veterinary Research 36:1473–1476.
Xia L, Yang Y, Wang J, Jing Y, Yang Q. (2018) Impact of TGEV infection on the pig small intestine. Virology Journal 15(1):102.
3.37 Vesicular stomatitis
Fast facts
Vesicular stomatitis (VS) is an exotic zoonotic, vesicular viral disease of livestock, clinically indistinguishable from other important livestock vesicular diseases, such as foot-and-mouth disease (FMD).
Organism
VS is caused by a number of vesiculoviruses:
- viral antigens localise in keratinocytes in the coronary band
- virus can retain infectivity in the environment for several days but is sensitive to a wide range of disinfectants (e.g. 1% chlorine bleach, quaternary ammonium).
Susceptible species
Susceptible species include:
- cattle, horses and pigs
- South American camelids, sheep and goats occasionally have clinical signs
- people.
Economic impact
There is potential for significant economic loss resulting from restrictions on animal movements and international trade.
Epidemiology
VS:
- incubation period is usually 2–8 days
- causes morbidity ranging from 5–90 per cent but many infections in livestock are subclinical
- mortality is rare in cattle and horses but higher mortality rates have been seen in some pigs.
Transmission
Transmission of VS is incompletely understood. Insect vectors, mechanical transmission and movement of animals may transmit infection.
Clinical signs
Signs include:
- pyrexia
- hypersalivation (often the first sign)
- vesicles that progress to erosions in the mouth, nares, muzzle, teats and feet.
Post-mortem
Gross lesions at post-mortem are restricted to erosive ulcerative lesions.
Samples required
Also refer to the detailed section on sampling for animals with vesicular disease; collect:
- blood (EDTA and plain tubes)
- vesicular fluid, oropharyngeal fluid, oral, nasal and tonsillar swabs, epithelium, and epithelial tags (in buffer or virus transport medium).
Actions to take
If you suspect a case of VS:
- call the Emergency Animal Disease Hotline (1800 675 888) immediately or contact a government veterinarian in your state or territory. Isolate animals until a definitive diagnosis is determined
- isolate suspected cases and implement biocontainment protocols (including farm movement controls) until advised by government veterinary authorities.
Public health considerations
- VS is a zoonotic disease
- humans can become infected with VSV when having direct contact with infected animals
- VS causes flu-like symptoms and rarely causes oral blisters in people.
Introduction
Vesicular stomatitis (VS) is an important exotic vesicular viral disease which produces significant economic losses in livestock, and poses a zoonotic risk to people. As with all vesicular diseases, rapid differentiation from FMD is essential.
Disease agent and susceptible species
VS is caused by a number of viruses belonging to the Vesiculovirus genus in the family Rhabdoviridae (vesicular stomatitis New Jersey (VSNJV) and vesicular stomatitis Indiana subtypes 1, 2 and 3). In addition:
- VS primarily affects equids (horses, donkeys, mules) and cattle and, occasionally, pigs, sheep, goats, llamas and alpacas
- most cases occur in adults and young cattle; horses under a year of age are rarely affected
- humans can also become infected, producing influenza-like symptoms
- South American camelids, sheep and goats occasionally display clinical signs
- serological evidence of infection is found in many other animals including deer, bats, raccoons, skunk, monkeys, sloths, rodents and wild pigs, but there is a noticeable absence of a viremic mammalian host, which is an unusual feature for an arbovirus.
Public health considerations
- VS is a zoonosis
- use appropriate personal protective equipment as humans (in particular veterinarians and animal handlers) become infected after direct contact with infected animals
- symptoms include flu-like signs and oral blisters (rarely).
Distribution
VS:
- is limited to the Americas
- is known to be an endemic disease in the warmer regions of North, Central and South America, but outbreaks of the disease in other temperate geographic parts of the Americas occur sporadically
- outbreaks have occurred in a number of states in the United States throughout the 21st century.
Occurrences in Australia
None reported.
Epidemiology
Modes of transmission
The mechanism of transmission of VSV is unclear, but it is thought to involve:
- direct contact between animals, as infected animals shed VSV in vesicular material, saliva and to a lesser extent, in nasal secretions and broken skin or mucous membranes may facilitate entry of the virus. Faecal shedding has been reported occasionally in pigs. VSV does not appear to be shed in milk
- insect vectors, which introduce VSV into populations of domesticated animals. Vesiculoviruses are transmitted to cattle, horses and pigs by various blood-sucking insects found to be infected during epidemics, including sandflies (Lutzomyia spp), blackflies (family Simuliidae) and biting midges (Culicoides)
- fomites—animals can be infected by contaminated food, water, milking machines and tack
- mechanical spread by human hands
- semen and embryos—in bovines transmission via semen is thought to be possible. Transmission is considered unlikely via embryos, but has not been ruled out definitively. In pigs and horses, the virus is present in and can be transmitted via semen contaminated with vesicular fluid. Virus is known to be present in ova.
While vector-borne transmission to humans is possible, it is most likely to occur through inhaling infective aerosols or contact with infective fluids when handling infected livestock.
Disease dynamics
Much remains unknown about disease dynamics as outbreaks in other countries have proven to be erratic and unpredictable. It is thought that domestic animals are probably not the primary hosts of VS virus. What is known is that:
- the incubation period ranges from 2–8 days
- most cases occur in adults, and young cattle and horses under a year of age are uncommonly affected
- typically, 5–20 per cent of the animals in a herd show clinical signs, but up to 100 per cent seroconvert
- infectivity diminishes rapidly and may be lost within a week after the vesicles rupture (thus, virus is shed in vesicular fluids and saliva for a few days only)
- mortality is low and morbidity is very variable, ranging from 5 per cent to more than 90 per cent
- deaths are very rare in cattle and horses, but higher mortality is seen in some pigs.
Persistence of the agent
VSV:
- is relatively unstable and readily inactivated by sunlight, and therefore does not survive for long periods in the environment except in cool, dark places
- can remain infectious for 3–4 days on fomites
- can be inactivated with a wide range of disinfectants (e.g. 1% sodium hypochlorite, 70% ethanol, iodophore, quaternary ammonium disinfectants).
Diagnosis and pathology
Clinical signs
VS causes clinical signs resembling foot-and-mouth disease (FMD) in cattle and pigs, and less often in sheep and goats. However, the disease occurs in horses, which is not the case with other vesicular diseases.
VS can significantly affect production in dairy cattle and performance in horses.
In addition:
- many infections with VS are subclinical
- excessive salivation is often the first sign of the disease
- VS is characterised by vesicles, papules, erosions and ulcers and these lesions are found particularly around the mouth but also may be present on the nares, muzzle, feet, udder and prepuce. Vesicles vary widely in size, with some as small as a pea while others can cover the entire surface of the tongue. In addition, vesicles rupture to become erosions or ulcers. are Frequently this happens before any vesicles are seen. In some animals, the vesicles may go unnoticed and the disease may appear as crusting scabs on the muzzle and lips
- VS lesions are painful and can cause anorexia, refusal to drink and lameness
- some animals can have a catarrhal nasal discharge, bleeding from ulcers, or a foetid mouth odour
- transient pyrexia usually develops when lesions appear.
Horses appear to be most contagious for the first 6 days after infection and:
- vesicles occur most often on the upper surface of the tongue, the gums and lips, and around the nostrils and corners of the mouth
- lesions may develop on the teats or prepuce, and on the coronary band and interdigital space of the hooves
- the turbinates, nasopharynx and larynx may be affected, resulting in nose bleeding and difficulty in eating and breathing.
In cattle:
- vesicles are usually found on the hard palate, tongue, lips and gums, sometimes extending to the nostrils and muzzle
- some papules do not become vesiculated
- lesions may develop on the teats or prepuce, and on the coronary band and interdigital space of the hooves
- lesions on the teats can cause mastitis from secondary bacterial infections (particularly in dairy cattle) and weight loss may be severe, reducing milk production
- reduction in milk production can be permanent
- some animals may appear to be normal, but only eat approximately half their normal feed ration.
In pigs, vesicles usually appear first on the feet and the first sign may be lameness. The muzzle and lips are also frequently affected (though the predominant sites of lesions can vary by outbreak).
In humans:
- symptoms resemble influenza
- the incubation period is usually 3–4 days, but may be as short as 24 hours or as long as 6 days
- most recover without complications in 4–7 days.
Pathology
Gross lesions at post-mortem are restricted to the vesicles described. There are no disease-specific histopathological changes.
Differential diagnosis
Although VS may be suspected when horses are involved as well as pigs and cattle, VS is clinically undistinguishable from the other exotic viral vesicular diseases, namely:
- foot-and-mouth disease (affects cattle and pigs)
- swine vesicular disease (affects pigs)
- vesicular exanthema of swine (not seen since 1956) (affects pigs)
- Senecavirus A (Seneca Valley virus) infection (affects pigs)
- other exotic diseases
- bluetongue disease (infection present in Australia but without clinical disease) (affects cattle)
- rinderpest (now recognised by WOAH as eradicated from all countries with susceptible populations) (affects cattle)
- endemic diseases
- bovine papular stomatitis (affects cattle)
- dermatophilus and other types of mycotic stomatitis (affects cattle and horse)
- footrot (affects cattle)
- infectious bovine rhinotracheitis (affects cattle)
- mucosal disease (BVDV-1 only) (affects cattle)
- non-infectious causes
- phototoxic dermatitis with vesicle formations from contact with the leaves of plants of the family Umbelliferae (parsley, parsnips and celery) (affects cattle, horses and pigs)
- chemical irritants and scalding (affects cattle, horses and pigs)
- traumatic lesions of the mouth and feet (affects cattle, horses and pigs).
Samples required
Because VS may be mild or subclinical, you will need to look for seroconversion to VS in apparently healthy animals to ascertain the length of infection.
Sample collection
Take samples from several affected animals in the herd, flock or group (take these from lesions in the mouth or the feet, or at other sites with suitable lesions).
FMD virus (an important differential diagnosis for VS) is very sensitive to both acid and alkaline conditions. Inappropriate buffer conditions can inactivate the virus making virus isolation difficult or impossible. To maximise chances of virus isolation:
- use phosphate buffered saline or virus transport media with a pH of 7.6
- if submitting a sample after 24 hours or more, add glycerol to the phosphate buffered saline
- dilute oropharyngeal fluid collected with a probang in an equal volume of phosphate buffered saline pH 7.6, and mix vigorously for 1 minute.
Note that sample collection in these buffers is optimal (for the growth of FMD virus) but not essential for RNA or antigen detection assays.
Take samples from at least 10 live, clinically affected animals. Collect:
- serum—7–10 ml/animal in plain tubes
- vesicular fluid—carefully use a syringe and needle to aspirate the vesicular fluid from unruptured vesicles, and place in a sterile container. Alternatively, collect fluid from small vesicles onto a swab and place the swab in 500 μl of buffer, such as phosphate buffered saline or virus transport medium
- fresh tissue—epithelium, epithelial tags, oral, nasal and tonsillar swabs and oropharyngeal fluid and submit in phosphate buffered saline or virus transport medium, if available.
Collect fresh and formalin fixed samples from several tissues (lymph nodes, thyroid and adrenal glands, kidney, spleen and heart) from dead animals. If neurological signs are present, submit the brain.
Transport of samples
For transport:
- chill blood samples and unpreserved tissue samples at either 4 °C, or with frozen gel packs
- DO NOT FREEZE SAMPLES at -20 °C; it reduces the sensitivity when used for virus isolation and molecular diagnostic tests
- send samples with dry ice if the journey is expected to take several days
- formalin fixed tissue can be sent at room temperature.
Sample submission
The relevant state or territory laboratory should coordinate sample packaging and consignment for delivery to the Australian Centre for Disease Preparedness.
Diagnostic tests
VS or other vesicular diseases should be suspected when vesicles or erosions are found on the mouth and/or feet of livestock. Other vesicular diseases must be ruled out with laboratory tests.
VS can be identified using an antigen enzyme-linked immunosorbent assay (ELISA), polymerase chain reaction (PCR), virus isolation, and serological assays for the detection of antibodies. Testing strategies are based on samples submitted and clinical and epidemiological information provided.
Reporting requirements
VS is no longer an WOAH-listed disease; however, Australia has an international obligation to report cases.
If you suspect VS, report it immediately. Call the Emergency Animal Disease Hotline on 1800 675 888, wherever you are in Australia. Alternatively, contact a government veterinarian in your state or territory.
Government duty veterinarians monitor the hotline and are available to advise you 24 hours a day, 7 days a week.
Biocontainment and personal protective equipment
VSV infection is a public health risk. Human infections may result from direct contact with infected animals. Isolate suspected cases of VS and keep them on the property until advised by government veterinary authorities, noting:
- wear appropriate personal protective equipment (coveralls and boots, gloves, mask) when examining animals, performing post-mortem examinations, or handling tissue, carcasses or abortion materials
- personal decontamination is required when leaving infected premises. Thoroughly clean and then disinfect vehicles and equipment before leaving the property.




Further information
Cargnelutti JF, Olinda RG, Maia LA, de Aguiar GM, Neto EG, Simões SV, de Lima TG, Dantas AF, Weiblen R, Flores EF, Riet-Correa F. (2014) Outbreaks of Vesicular stomatitis Alagoas virus in horses and cattle in northeastern Brazil. Journal of Veterinary Diagnostic Investigation 26(6):788-94.
McCluskey BJ, Pelzel-McCluskey AM, Creekmore L, Schiltz J. (2013) Vesicular stomatitis outbreak in the southwestern United States, 2012. Journal of Veterinary Diagnostic Investigation 25(5):608-13.
John Allen
Australian Centre for Disease Preparedness
CSIRO
Geelong VIC 3220
Malcolm Anderson
Little Kingfisher Group
Hackney SA 5069
Hannah Bender
Australian Centre for Disease Preparedness
CSIRO
Geelong VIC 3220
Jemma Bergfeld
Australian Centre for Disease Preparedness
CSIRO
Geelong VIC 3220
John Bingham
Australian Centre for Disease Preparedness
CSIRO
Geelong VIC 3220
Stuart Blacksell
Mahidol Oxford Tropical Medicine
Research Unit
Mahidol University
Bangkok Thailand 10400
Tim Bowden
Australian Centre for Disease Preparedness
CSIRO
Geelong VIC 3220
Andrew Breed
Animal Health Policy
Department of Agriculture, Forestry and Fisheries
Canberra ACT 2601
Amy Burroughs
Animal Biosecurity
Department of Agriculture, Forestry and Fisheries
Canberra ACT 2601
Hendrik Camphor
Animal Health Policy
Department of Agriculture, Forestry and Fisheries
Canberra ACT 2601
Patrick Cass
Animal Health Policy
Department of Agriculture, Forestry and Fisheries
Canberra ACT 2601
Bronwyn Clayton
Australian Centre for Disease Preparedness
CSIRO
Geelong VIC 3220
Axel Colling
Australian Centre for Disease Preparedness
CSIRO
Geelong VIC 3220
Kerry Daly
Animal Biosecurity
Department of Agriculture, Forestry and Fisheries
Canberra ACT 2601
Debbie Eagles
Australian Centre for Disease Preparedness
CSIRO
Geelong VIC 3220
Iain East
Animal Health Policy
Department of Agriculture, Forestry and Fisheries
Canberra ACT 2601
Daniel Edson
Animal Health Policy
Department of Agriculture, Forestry and Fisheries
Canberra ACT 2601
Mark Ford
Australian Centre for Disease Preparedness
CSIRO
Geelong VIC 3220
Skye Fruean
Northern Australia Quarantine Strategy
Department of Agriculture, Forestry and Fisheries
Canberra ACT 2601
Mahala Gunther
School of Animal and Veterinary Sciences
Charles Sturt University
Wagga Wagga NSW 2650
Kim Halpin
Australian Centre for Disease Preparedness
CSIRO
Geelong VIC 3220
Sam Hamilton
Animal Health Policy
Department of Agriculture, Forestry and Fisheries
Canberra ACT 2601
Nick Harris
Animal Health Policy
Department of Agriculture, Forestry and Fisheries
Canberra ACT 2601
Jacquelyn Horsington
Australian Centre for Disease Preparedness
CSIRO
Geelong VIC 3220
Clare Jones
Animal Health Policy
Department of Agriculture, Forestry and Fisheries
Canberra ACT 2601
Ashley Jordan
Animal Biosecurity
Department of Agriculture, Forestry and Fisheries
Canberra ACT 2601
Anna Kabaila
Animal Biosecurity
Department of Agriculture, Forestry and Fisheries
Canberra ACT 2601
Louise Kench
Animal Biosecurity
Department of Agriculture, Forestry and Fisheries
Canberra ACT 2601
Janene Kingston
Animal Health Policy
Department of Agriculture, Forestry and Fisheries
Canberra ACT 2601
Ross Lunt
Australian Centre for Disease Preparedness
CSIRO
Geelong VIC 3220
Heather McKimm
School of Animal and Veterinary Sciences
Charles Sturt University
Wagga Wagga NSW 2650
Corissa Miller
Animal Health Policy
Department of Agriculture, Forestry and Fisheries
Canberra ACT 2601
Pat Mitchell
Australian Pork Limited
Barton ACT 2600
Andrew Moss
Animal Biosecurity
Department of Agriculture, Forestry and Fisheries
Canberra ACT 2601
Kelly Porter
Animal Biosecurity
Department of Agriculture, Forestry and Fisheries
Canberra ACT 2601
Louise Sharp
Animal Biosecurity
Department of Agriculture, Forestry and Fisheries
Canberra ACT 2601
Nagendra Singanallur
Australian Centre for Disease Preparedness
CSIRO
Geelong VIC 3220
Joanne Taylor
Australian Centre for Disease Preparedness
CSIRO
Geelong VIC 3220
Sally Thomson
Animal Health Policy
Department of Agriculture, Forestry and Fisheries
Canberra ACT 2601
Wilna Vosloo
Australian Centre for Disease Preparedness
CSIRO
Geelong VIC 3220
Jianning Wang
Australian Centre for Disease Preparedness
CSIRO
Geelong VIC 3220
Natasha Webb
Animal Biosecurity
Department of Agriculture, Forestry and Fisheries
Canberra ACT 2601
John White
Australian Centre for Disease Preparedness
CSIRO
Geelong VIC 3220
Nicole Whitehouse
School of Animal and Veterinary Sciences
Charles Sturt University
Wagga Wagga NSW 2650
David Williams
Australian Centre for Disease Preparedness
CSIRO
Geelong VIC 3220
Frank Wong
Australian Centre for Disease Preparedness
CSIRO
Geelong VIC 3220
Edwina Leslie, Brendan Cowled, Isabel MacPhillamy, Skye Badger, Alison Hillman and Emma Zalcman
Ausvet
Fremantle WA 6160
Download the template
Taking a history requires the collection of accurate, quality information. Preparing a standard history collection template can help with gathering evidence.
Biosecurity gear
- Sets of clean overalls
- +/- disposable overalls
- Disposable gloves
- Box of surgical masks
- Safety glasses/goggles +/- disposable
- P2 masks/ respirator
- Sharps container
- Detergent
- Water
- General purpose disinfectant
- Boot cleaning container and brush
- Equipment washing container and brushes
- Alcohol-based hand wash
- Plastic groundsheet (and tent pegs)
- Large heavy-duty plastic bags and ties
Clinical equipment
- Clinical thermometers
- Stethoscope
Lab sampling gear
- Plain blood tubes
- EDTA tubes
- Lithium heparin tubes
- Sterile containers ‘yellow tops’
- Large histopathology pots
- Formalin 10%
- Bacterial swabs
- Viral swabs
- Saline bottle
- Slides and holders
- Ziplock bags
- Marker pens
- Lab submission forms
- Eskies and icepacks
- pH test kit
- Urine glucose test strips
- Needles and syringes
Post-mortem equipment
- Knives and sharpener
- Rib cutters (pruning shears)
- Scalpel handles and scalpel blades
- Rat tooth forceps
- Scissors
- Axe and mallet (for brains)
Other
- Digital camera/ phone in ziplock bag
- Checklists, standard operating procedures (SOPs), guidelines folder
- Hendra advice sheet
- This field guide

